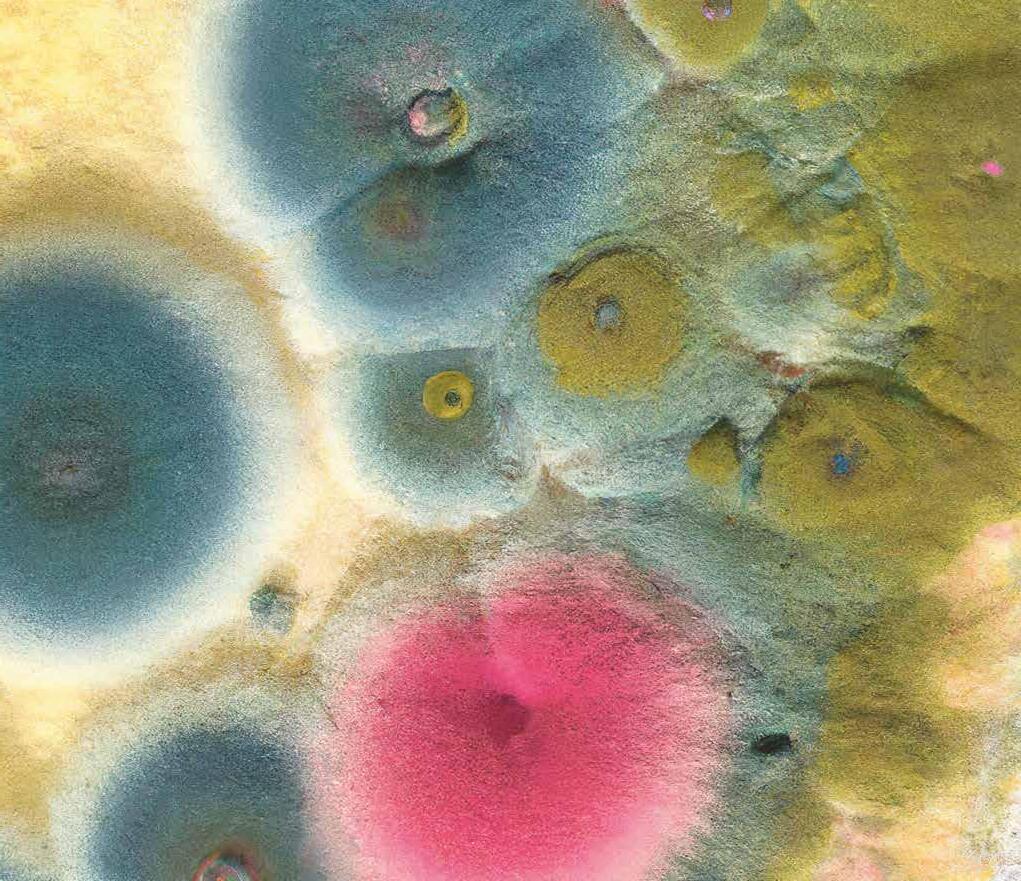
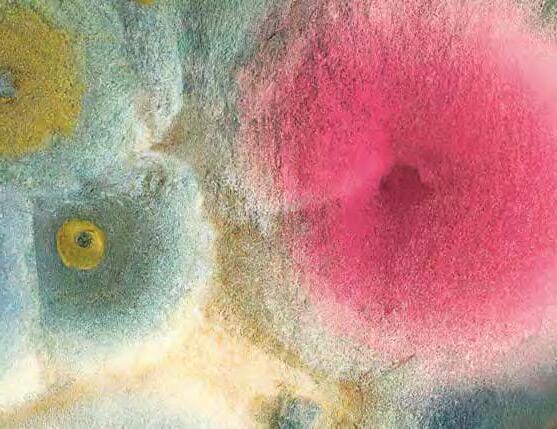
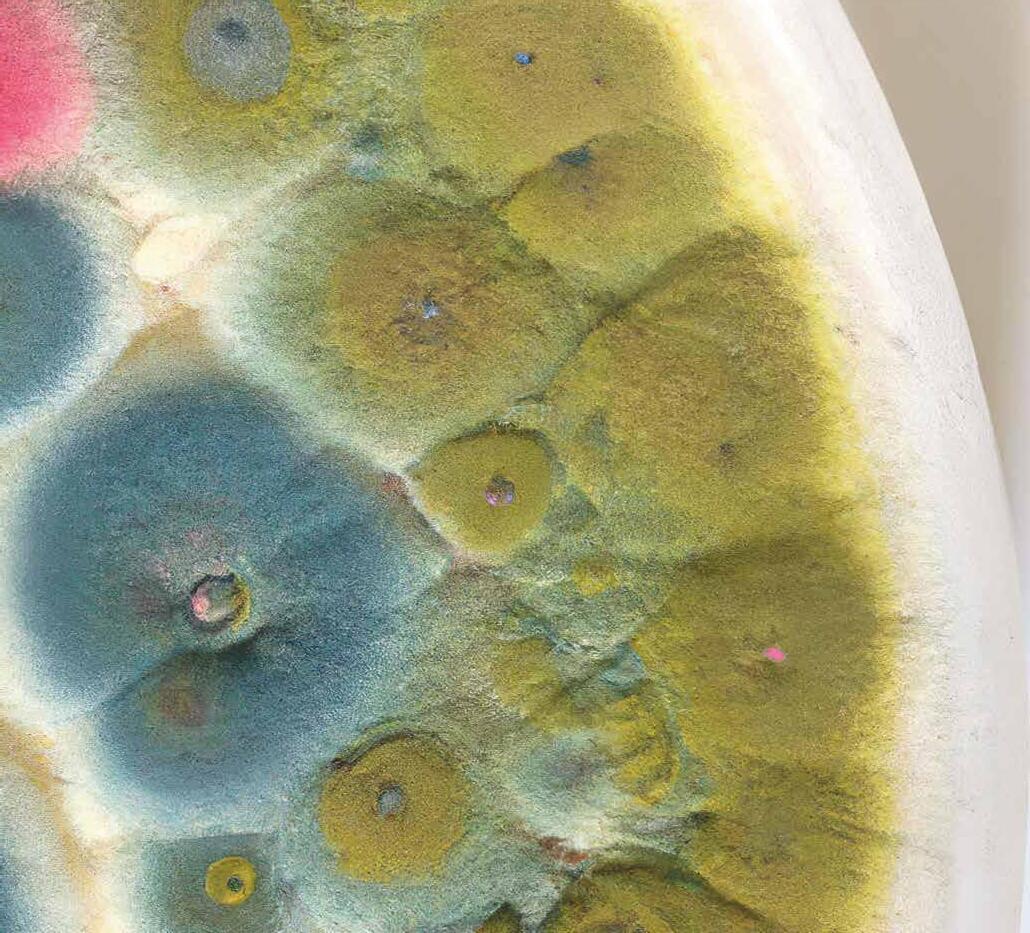
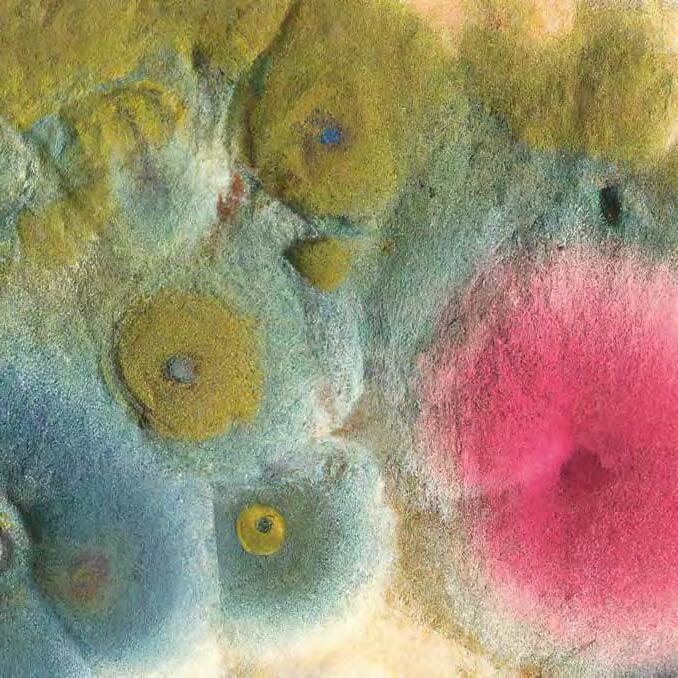
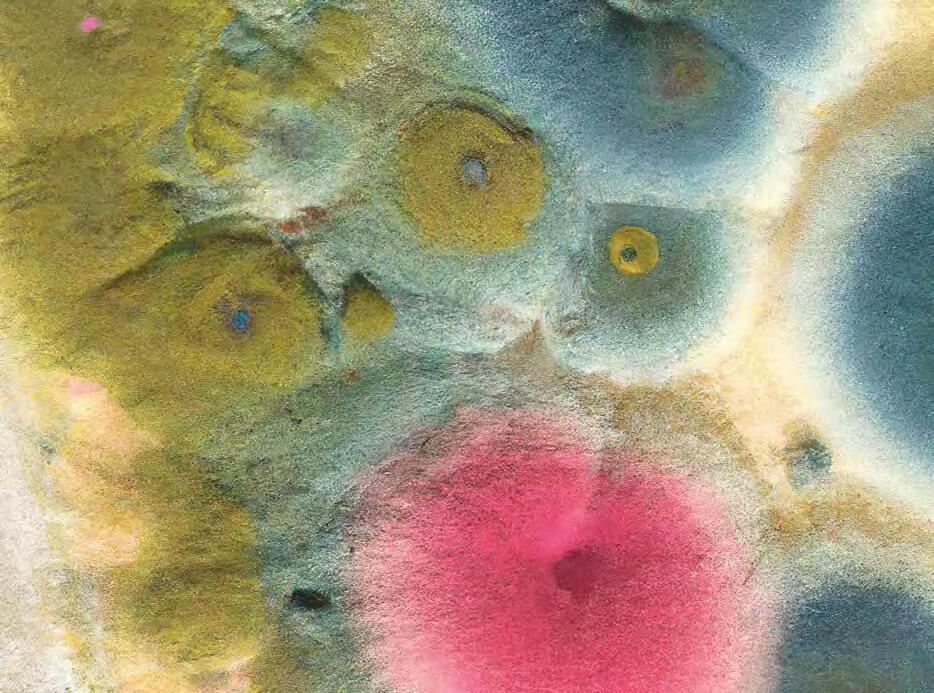
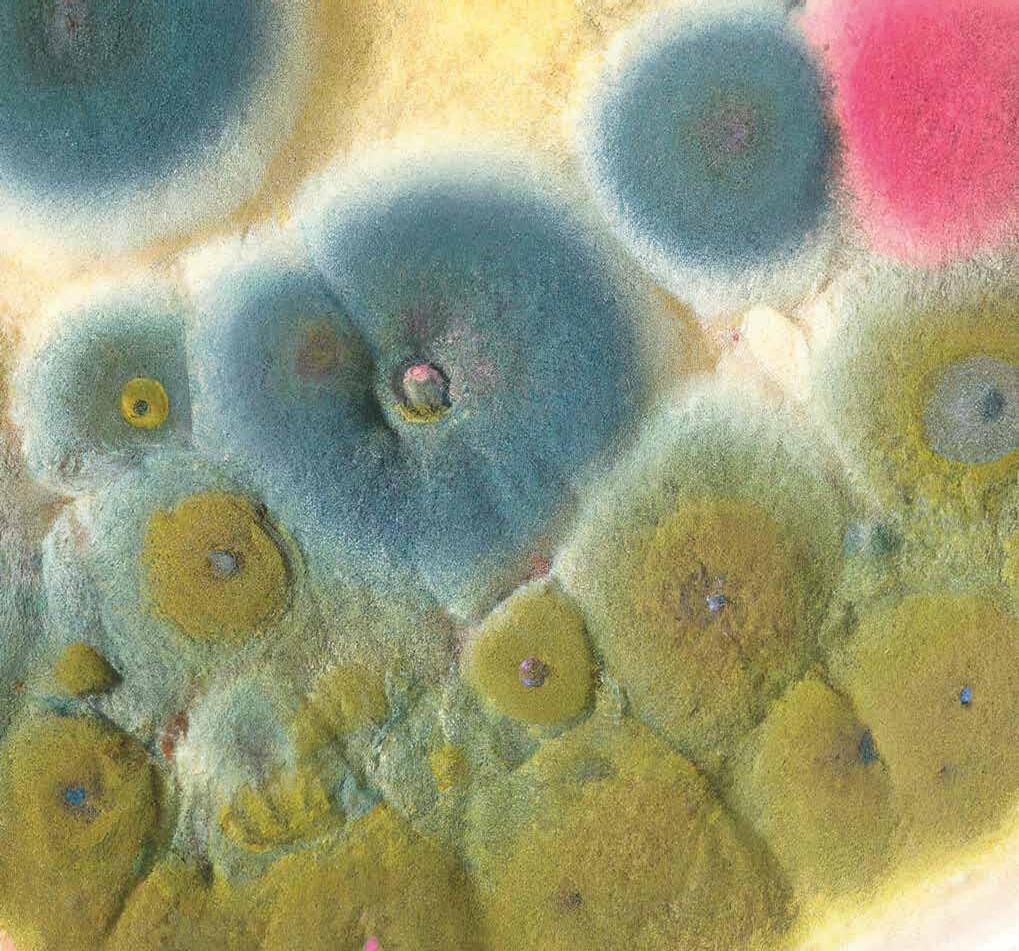

Josef Albers / James Lee Byars / Maurizio Cattelan / Étienne Chambaud / Edith Dekyndt
Sergej Eisenstein / Lucio Fontana / Theaster Gates / David Hammons / Arthur Jafa / Donald Judd
On Kawara / Kimsooja / Joseph Kosuth / Sherrie Levine / Francesco Lo Savio / Agnes Martin
Paulo Nazareth / Camille Norment / Roman Opałka / Lygia Pape / Michel Parmentier
Philippe Parreno / Robert Ryman / Dineo Seshee Bopape / Dayanita Singh / Rudolf Stingel
Andrej Tarkovskij / Lee Ufan / Danh Vo / Chen Zhen

The sixth edition of Time Space Existence draws attention to the emerging expressions of sustainability in its numerous forms, ranging from a focus on the environment and urban landscape to the unfolding conversations on innovation, reuse and community.
Palazzo Mora
Palazzo Bembo
Marinaressa Gardens
Download the catalogue:
www.ecc-italy.eu
www.timespaceexistence.com
Exhibition venues: youtube @europeanculturalcentre facebook @europeanculturalcentre instagram @ecc_italy

20.5 —
26.11.2023

editoriale (p. 12 ) Identità nomadi incontri (p. 14 ) Wayne McGregor | Maria Manetti Shrem storie (p. 22 ) Pietro Casola, in viaggio verso Gerusalemme architettura (p. 30 ) Biennale Architettura 2023, il Catalogo | The Laboratory of the Future views | V&A Tropical Modernism | I Leoni della 18. Biennale Architettura | Partecipazioni Nazionali: Spagna, Italia, Ucraina, Lettonia, Cile | Eventi Collaterali: EUmies Awards, Scotland + Venice, Catalonia in Venice | Not Only Biennale: Intervista a Rachele De Stefano, European Cultural Centre, DoorScape, Kengo Kuma, PRIX W 2023, MAXXI – Biogrounds, Radials, Umbau, In Context arte (p. 56 ) Intervista Alberto Craievich, Ca’ Rezzonico – Museo del Settecento Veneziano | Lino Tagliapietra | Sam Baron | Vetro Boemo | ICÔNES | Donazione Gemma De Angelis Testa | Edmondo Bacci | Everybody Talks About The Weather | Bernardo Bellotto a Palazzo | Arthur Duff | Vedova | Gallerie dell’Accademia | CHRONORAMA | Ugo Mulas | Ocean Space | | Nicolò Manucci | Ego | Galleries | Carpaccio alla Scuola Dalmata | Not Only Venice biennale danza festival guide (p. 86 ) Simone Forti, Leone d’Oro | Intervista TAO Dance Theater Leone d’Argento | Oona Doherty | Luna Cenere | Intervista Andrea Peña | Michael Keegan-Dolan | Pontus Lidberg | Acosta Danza | Andrea Salustri | Lucy Guerin | Rachid Ouramdane | Botis Seva | College | Film, Workshop & Conversations musica (p. 108 ) Paolo Conte | Nilza Costa 4et | Jaques Morelenbaum | MOOG Summer Camp | Women For Freedom In Jazz | Damien Rice | Intervista Gerardo Balestrieri | Tiziano Ferro | Placebo | Kendrick Lamar | Festival Boato | Julie Campiche | Sexto ‘Nplugged | Festival del Vittoriale | Sherwood Festival | Overjam International Festival | No Borders Music Festival | AMA Music Festival | Crocodiles in Venice | Punta Conterie Terrazza classical (p. 124 ) La Nona in Piazza | Cavalleria rusticana | 100. Arena Opera Festival | Peggy Guggenheim Birthday | Teatro La Fenice 2023/24 | Palazzetto Bru Zane 2023/24 theatro (p. 130 ) Venice Open Stage | Verde Groggia | Alonso. Don Chisciotte tra realtà e virtuale | Scene di Paglia | Estate Teatrale Veronese | Operaestate Festival special cinema (p. 140 ) Barbie | Edipo Re | Cinemoving | Cinema Barch-in | Supervisioni | Cinefacts etcc... (p. 146 ) Premio Campiello, Intervista finalisti | Sono Solo Parole menu (p. 154 ) Festa del Redentore | Il sogno del Prosecco | Pietra Rossa | Racconti d’estate in città | Nolinski Venezia citydiary (p. 163 )
L esley Lokko’s Biennale is a declaration of intents and a call to action, a plurality of voices, and an invitation for the public to join a laboratory of ideas and imagine the future of deloconized architecture.
a rchitettura p. 30
A s ymbol of Venice reopens after restoration works repaired the damage of the flood of 2019. Alberto Craievich takes us on a tour across old and new spaces as well as the splendour of the Venetian 1700s. arte p. 56


P iazza San Marco and great music are at the centre of the global village: Beethoven’s Ninth and a live concert by Paolo Conte are Fenice Theatre’s and Veneto Jazz’s gifts to Venice.
musica p. 108 | classica l p. 124

Meeting the five nominees for the Campiello literary prize. The jury studied the authors’ works, vivid portraits of modernity.



etcc... p. 146

When we dance or experience incredible dance performances, our body’s inner sensations are provoked into states of change as chemical reactions inside us transform our perceptions in real time. We breathe faster, our eyes dart, our heart rate increases and our chest tightens; or we quieten, relax back, eyes wide, the hairs on our skin standing tall. The connections between our brain, body, mind and the world reshape and, sometimes, when we are lucky, metamorphosise. We can feel elated, challenged, energised, infuriated, surprised, adrenalised, transported or, quite simply, we sit there with tears streaming down our faces. This is the power of dance. The greater one’s new affinity with the artwork, the more radical the altered states as we are moved from the prosaic to the profound. Dance changing, then, our very state of being.
Wayne McGregorPalazzo Ducale and St. Mark’s Basilica floodlit in the summer night everybody is looking forward to, the climax of the most popular festival in Venice. A miracle that loyally comes back every year as we jointly wait under the same sky.
menu p. 154

Stranieri ovunque. Asciutto, semplice, pieno. Di presa viva sul presente, di tensione emotiva, di vissuto quotidiano. Un titolo, quello che il curatore brasiliano Adriano Pedrosa, primo direttore della massima esposizione d’arte contemporanea mondiale proveniente dall’emisfero sud del pianeta, ha dato alla Biennale Arte 2024, che ha la forza lucida e stringente di attribuire un nome e un cognome chiari a una condizione esistenziale atavica dell’homo sapiens che solo i giochini demagogici e infami assai di sovranisti e populisti vari, ahinoi sempre più incombenti un po’ ovunque anche nel nostro Vecchio Continente, tentano di destrutturare additandola a uno stato di confusione, di caos disturbante la quiete domestica dei vari orticelli nazionali. Viviamo tempi di laceranti contraddizioni, in cui la forza positivamente crescente e dirompente dell’onda dei diritti, della valorizzazione della arricchente teoria di diversità di genere e di stili di vita che caratterizza sempre più apertamente la nostra società, produce un’onda di risucchio altrettanto impetuosa che con una violenta controcorrente reazionaria pretenderebbe di riportarci al sacro ordine patriarcale dell’ordinata società provinciale. È tipico dei momenti di scarto, di accelerazione verso un progresso aperto e inclusivo, dover registrare una reazione ostinata e contraria (Faber ci scuserà, spero, per l’inopinata citazione…) al servizio del ripristino dell’ordine, della conservazione più oscura. Eppure è proprio in questi tempi, in questi snodi storici che bisogna avere la forza di vedere il colore intenso del bicchiere mezzo pieno, assaporandoselo con tutte le papille gustative in assetata azione. Quando mai il consolidare conquiste sociali e di costume radicalmente libertarie non è costato un prezzo almeno alto? Direi anzi che oggi, grazie alle precedenti, fondamentali conquiste delle generazioni passate conseguite su questo terreno, il punto di frizione con la reazione trova chi spinge nell’acceleratore delle varie emancipazioni sociali e civili in compagnia di robuste schiere di cittadini, potremmo dire, senza timore di gelida smentita, della maggioranza dei cittadini delle nostre società, perlomeno quelle dell’Europa occidentale, ma non solo. Già, perché mai come oggi su questi temi la realtà viva e complessa del nostro quotidiano spinge le persone a doversi confrontare con quella che solo fino a ieri o a ieri l’altro era una diversità incomprensibile, se non pure incontemplabile. E mai come oggi la maggioranza dei cittadini è nettamente più libera e pronta ad accettare questa diversità rispetto a molte maggioranze che governano politicamente più di un Paese nel cuore pieno dell’Europa, vedi il nostro ad esempio.
L’arte in tutte le sue molteplici declinazioni, che come poche altre istituzioni la Biennale rappresenta insieme pienamente nel loro infinito delta espressivo, ha sempre rappresentato un’avanguardia elitaria anche per quel che riguarda le istanze civili. Lo ha fatto autenticamente, lo ha fatto conformisticamente, lo ha fatto convintamente, l’ha fatto talvolta pelosamente. Però l’ha fatto. Certo, chiusa quasi sempre nella sua ridotta per pochi alfabetizzati nella lettura dei linguaggi contemporanei, eppure c’era, eccome. Oggi continua ad esserci, ma il dato nuovo, relativamente nuovo s’intende, è che, almeno nei suoi intenti programmatici, pare essere scesa decisa dal suo piedistallo autoreferenziale per aprirsi al più ampio mondo possibile, chiamando a gran voce a sé pubblici i più diversi. Per quanto consapevoli che di una lunga, complessa sfida si tratti, e che mai sarà possibile vincere fino in fondo, perché per quanto ci si preoccupi di provare a parlare una lingua intelligibile ai più sappiamo poi quanto i linguaggi contemporanei siano, per propria cifra costitutiva, ardui nella loro inedita semantica contemporanea, i curatori, tutti!, delle varie mostre e dei vari festival delle arti contemporanee, quindi in primis quelli a capo dei settori della Biennale, sono da tempo impegnati a sottolineare quanto la percezione emotiva, empatica, debba considerarsi di valore almeno pari alla capacità interpretativa profonda delle opere o delle azioni performative verso cui ci si dispone. Come dire: basta avvitarsi tra eterni simili, critici operatori artisti intellettuali; apriamo i nostri teatri, le nostre sale espositive alla società nella sua variegata interezza, perché questo non solo è possibile, ma auspicabile e salutare.
C’è anche dell’oggettiva retorica in questo, va bene, lo sappiamo. Eppure vi è al contempo una viva tensione, un trasporto credibile che tende proprio a erodere confini stantii, inservibili in una società in così tumultuoso, aperto divenire. Sì, perché anche il dirsi e farsi avanguardia aveva, e ha ancora intendiamoci, un suo buon risvolto di solida conservazione. Però ecco, più o meno autentico esso sia, questo richiamo aperto a tutti i pubblici del mondo è una disposizione che entra in viva sintonia col bicchiere mezzo pieno di cui sopra. Che le differenze, l’essere fluido, queer, nero, giallo, immigrato, clandestino, divengano un qualcosa di quasi mainstream, talvolta irritantemente cool, à la page, è anche un segnale ottimo, vitale per la permeabilità che la diversità può avere nelle maglie sempre meno strette della società. Insomma, è quando l’avanguardia flirta con il pop che il mondo si fa più largo e migliore, David Bowie ci avrà pure insegnato qualcosa, o no?

Sta affrontando il suo terzo anno alla guida di Biennale Danza, ha creato i movimenti dei film Harry Potter e de La leggenda di Tarzan (2016) tra gli altri, la coreografia dell’ultimo show degli Abba, in partnership con l’americana Niantic e la britannica Digital Catapult sviluppa progetti per la realizzazione di un “realworld metaverse”. Nel 1992 ha fondato Random Dance, poi divenuto lo Studio che porta il suo nome. Professore di coreografia al Trinity Laban Conservatoire, è in procinto di pubblicare il suo nuovo saggio Physical Thinking Insomma, uno dei più acclamati coreografi di tutto il mondo: Wayne McGregor. Su di lui e sul suo pensiero andrebbe veramente scritto un libro, ma difficilmente a scriverlo saranno critici di danza…
Dalla ammirevole e innovativa biomeccanica di Mejerchol’d sembra passato ben più di un secolo. «Danza è tecnologia, i corpi sentono le cose», ma senza mai dimenticare però di essere un uomo del suo tempo, «la danza è sempre un atto politico». Come non ricordare Live Fire Exercise, 2011, in cui McGregor e John Gerrard portarono in scena con il Royal Ballet la riproduzione dei movimenti dei soldati durante una esercitazione?
Mentre scriviamo debutta al Royal Opera di Londra con Universe: A Dark Crystal Odyssey sulla crisi climatica e la distruzione del Pianeta da parte dell’uomo, ed è già in cartellone per il 2024 Edipo Re/Antigone alla Dutch National Opera and Ballet di Amsterdam. Lo scorso 8 maggio con i tre mesi di residenza dei giovani di Biennale
College Danza è già iniziato il suo 17. Festival Internazionale di Danza Contemporanea intitolato Altered States : il potere della danza, capace di cambiare il nostro stesso stato d’animo. Cerchiamo di capire meglio il suo pensiero. Lo incontriamo a Ca’ Giustinian ed è per noi un’emozione unica.
Al centro del suo interesse pare vi sia il corpo e i suoi movimenti, il corpo che impara dai sensi e incorpora il passato. Psicologia cognitiva quindi? Stiamo parlando di conoscenza incorporata, del modo in cui corpo e cervello comunicano l’un l’altro e formano il nostro sistema di abitudini, le nostre abitudini cognitive. È così per ognuno di noi come lo è anche per il danzatore. Lavoriamo con un gruppo di scienziati di Cambridge che ci hanno aiutato a capire come il danzatore acquisisca una forte impronta abitudinaria nei propri movimenti, mentre danza. Ora però siamo in grado di farlo lavorare in modo diverso, contravvenendo alle proprie abitudini. Questo cambiamento, questa alterazione nel suo modo di agire gli permette di riprendere contatto col corpo in modo diverso. È molto interessante. È una nuova lingua che si costituisce. In che modo il cervello normalizza e crea degli schemi derivati da certi comportamenti e come possiamo cambiare questi atteggiamenti per creare nuove possibilità e nuovi algoritmi di movimento fisico? Possiamo insegnare qualcosa di radicalmente diverso rispetto al vissuto di ogni danzatore. Abbiamo chiamato questa didattica creata con studiosi e scienziati Mente e Movimento Il progetto è una modalità di insegnamento. Ad esem-
pio, quando pensiamo alla danza pensiamo a qualcosa di visivo, giusto? Ma se invece ci concentriamo in modo diverso e cerchiamo di creare una immagine acustica o un’immagine cinestetica? Che proprietà hanno e come possiamo lavorarci se veniamo da abitudini visive? Adesso proviamo a pensare ad immagini acustiche, immagini di suono. Come possiamo costruire una teoria di tecniche per accedervi e allo stesso tempo durante l’improvvisazione evitare il visivo? È un modo molto affascinante di esplorare un territorio diverso. Naturalmente l’apporto della neuroscienza è fondamentale e stiamo solo ora incominciando ad intravedere l’inizio di infinite possibilità.
Ci piacerebbe assistere a queste sessioni di insegnamento ai danzatori…
Non solo con danzatori; ne abbiamo fatte a Londra con architetti, designers, insegnanti. Non è solo danza, è un processo che permette di ricollegarsi al proprio corpo in modo diverso e di usarlo come strumento di pensiero. Ma, prima di tutto, bisogna conoscere le abitudini di pensiero preesistenti, per quanto possibile, e una volta fatto questo possiamo finalmente capire che ci sono possibilità di pensiero e atteggiamento a cui non attingiamo mai. Quando ci riusciamo, produciamo un evento straordinario.
Come avviene in lei il processo di creazione di un nuovo lavoro? Come nasce una nuova coreografia?
Non è un processo molto lineare, questo è certo. Ci vogliono anni per ogni lavoro; molte sono le idee che si mettono in campo e ciascuna offre uno spunto nello sviluppo creativo. Ad un certo punto accade che un’idea diviene dominante e progressivamente imprescindibile. È lo stesso processo della scrittura. Bisogna assicurarsi che queste idee vengano alimentate ed è così che ad un tratto il progetto prende forma. Prendo appunti costantemente, ora in modo digitalizzato. Ho condiviso i miei appunti con i nostri scienziati per capire in che modo questa abitudine influisca sul mio pensiero. In che modo penso con il mio quaderno, in che modo lo uso. La loro risposta è stata: «non c’è nessun pensiero coreografico
Now at his third year at the helm of the Dance Biennale, Wayne McGregor is the author of the choreographies for the Harry Potter film series and The Legend of Tarzan, among others. He also designed choreographies for the latest Abba show and projects for a ‘real-world metaverse’. In 1992, he founded Random Dance, later renamed after himself, and is a professor at the Trinity Laban Conservatoire. At time of writing, McGregor is at the London Royal Opera with A Dark Crystal Odyssey, a piece on climate crisis and environmental destruction. On the last May 8, his 17th International Dance Festival, titled Altered States, began. We’ll try to understand his way of thinking a bit better.

You seem to be interested in body and motion, the body learning from the senses and incorporating the past. Does cognitive psychology play a role in this?
What you talking about is embodied cognition, right? How the feedback loop between the body and the brain works, and how our cognitive habits are formed. The dancer is a performer, but also, performers have cognitive habits. They solve creative problems, often in the same kind of way anyone else does. We worked with cognitive neuroscientists from Cambridge who helped us understand how the individual dancers were forming habits, and offered them an opportunity to work in a different way. This kind of perturbation, this kind of disruption of normal cognitive pathways allow us to reengage with the body in a different way, which is really interesting. Right now, you’re solving a physical problem in a different way: a new language emerges. I’m really fascinated by this: how is it that the brain normalises and makes patterns from certain behaviours? And how might we be able to disrupt those behaviours to get new patterns, and therefore get new modes of physical moving?
So, for example, we’ve built this system with those neuroscientists, it’s called mind and movement and it’s a project that was supported by the Welcome Trust in London. This project is a

nel quaderno, perché quell’abilità la utilizzi in studio, non hai bisogno di scriverlo. Ogni altro appunto è un’idea, un concetto, una lista di informazioni. Sono cose importanti, ma non sono strutture coreografiche». Un commento interessante. Quando ci chiediamo da dove prendiamo le nostre idee non sempre ci rendiamo conto che partono da molto lontano, assai prima di approdare in studio. Quali informazioni perdiamo, quali invece aggiungiamo? Nel mio studio londinese catturo il processo creativo con sei telecamere e i filmati vengono poi analizzati dai nostri neuroscienziati a San Diego, cercando di focalizzare il punto/momento in cui cambiano le decisioni. Non è tanto importante cosa uno stia facendo, quanto come le idee si trasformino. Chi di noi ricorda l’informazione iniziale? Ad un danzatore assegno un movimento, ad un altro una intenzione? Ciascun danzatore ha il suo personale modo di sentirsi parte del processo. C’è bisogno di persone diverse con talenti diversi per attivare questo processo di ricordi. Registriamo tutto quando creiamo un pezzo, la fisicità e l’intenzione. In questo periodo, ad esempio, all’Opera di Parigi è in scena il nostro spettacolo su Dante e le notazioni sono lette come se fossero musica.
I suoi lavori sembrano non avere limiti. Lei ha lavorato non solo con movimento, suoni e colori, ma anche con i profumi! Prima abbiamo parlato di immagini visive, acustiche, cinestetiche, olfattive: concetti molto potenti. Ho condotto un esperimento con la maison britannica Jo Malone per una rappresentazione de Il Lago dei Cigni all’Opera di Londra dove ho usato solo profumi, un peculiarissimo percorso coreografico il cui compito era anche quello di costruire una immagine. Molto difficile. A Londra vi sarà un nuovo teatro, l’MSG Sphere, con un sistema acustico incredibile: in un orecchio si sente italiano e nell’altro giapponese, oppure in uno Bach e nell’altro Mozart. Ventimila spettatori, ma ognuno con una fruizione diversa del suono. Ora stanno sperimentando lo stesso processo con gli odori. Potremo in un futuro non lontano creare un
ambiente diverso per ogni persona. Spesso parliamo di danza come di una esperienza collettiva; lo è ovviamente, ma ciascuno ha una esperienza diversa dello stesso processo. Sono molto curioso sui possibili sviluppi che la tecnologia ci potrà offrire.
Secondo lei è importante che il pubblico possa capire il significato di una coreografia?
Ottima domanda. Siamo troppo abituati a descrivere il significato di qualcosa usando le parole, analizzandola retrospettivamente. Io penso invece sia necessario interagire e avere coscienza dei nostri sensi. Così facendo il significato emerge in modo diverso, non come una spiegazione razionale: questo significa X, quindi devi cercare X in ciò che vedi. Sono entrambi approcci sensati, ma decisamente diversi. Penso che nella danza vi sia una particolare ossessione di trovare significati razionali e concreti, ma si tratta di una disciplina ambigua e costitutivamente sfuggente a stringenti definizioni. Perché vincolarsi all’idea che X debba essere uguale a X, a meno che questa non sia una precisa idea del coreografo? Quando creiamo uno spettacolo aggiungiamo sempre qualcosa di personale, ma questo non significa che debba dire tutto della mia ricerca in modo che anche gli altri possano comprenderla. Assistere ad uno spettacolo significa partecipare, fare un’esperienza. Come mi fa sentire? Cosa mi ricorda? Ciascuno di noi attribuisce un significato a ciò che vede. Credo che molte persone che si avvicinino alla danza temano di non capirla. È un po’ colpa nostra, perché troppo spesso sosteniamo che qualcosa da capire c’è. È come affermare con gesto di superiorità: «il balletto significa questo, dovreste saperlo e se non lo sapete non potete accedere a questa arte». Dovremmo invece dire: «andate a vedere Il Lago dei Cigni. Cosa vedete? Cosa notate?». Quando il pubblico ad esempio è costituito da bambini, è bellissimo vedere come essi colgano così tanti particolari. È questa gioiosa curiosità che vorrei vedere in tutti gli spettatori. Spero che il pubblico del Festival sia proprio così, sì.
teaching tool, effectively. For example, when you’re thinking about dance, you think about visual images, right? We know some people solve physical problems visually, but is there such a thing as an acoustic image? What is a kinaesthetic image? What are the properties of those and how do we practise them if we’re more used to working in a visual domain? If we now think about acoustic images, so these sound images, how do you build a whole range of techniques to access them bypassing our visual system? It’s a different way to navigate a different kind of territory. Obviously, we need some brilliant cognitive neuroscientists to help us do that, but we’re scratching the surface of this possibility. We understand there’s a whole range of options that we never access, and if we can access them, that’s extraordinary.
Well, it’s not very linear, that’s the first thing. I start projects many, many years in advance, so it feels like I have a lot of ideas, all percolating at the. time, and then, all of a sudden, one takes off or becomes essential. You can probably draw a parallel with writing. It’s the same right. I take notes. I’ve just digitised all of my archive, which includes all my choreographic notebooks, and I had them analysed by cognitive neuroscientists at Cambridge, again to see what are the ways in which I use my notebook for thinking. How do I think with a notebook, what do I use it for? What was interesting is that they came back to me to say: you don’t think anything choreographic with the notebook, because that’s your skill in the studio. You don’t need to write that down, anything else you write in the notebooks is rather conceptual ideas or strains of information. They’re essential to the process, but they’re not choreographic structures, and that’s interesting. Therefore, when you think about where an idea starts, you’ll know an idea starts way, way before you get into the studio. I have a system in London. It’s called the smart studio, which captures my process with six cameras. Again, we’ve had that analysed by cognitive neuroscientists in San Diego, where they were looking at where the decisions change. Which is to say, not analysing what is the thing that you’re making, but where does an idea move from one to the other.




Dancers perhaps have different biases in terms of what it is that they contribute to a process. And you need a range of people with certain kinds of talent to make that remembering process effective. That is super interesting to me. We capture all of that and then when I’m making a ballet, I have a notator. We’re just restaging our Dante project now for the Paris Opera, which will also be drafted by a notator. In combination, these things build a rich picture. In isolation, they do have lots of limitations; cumulatively, they have more power.
Your work seems to have very few limits, as it stands. You worked with motion as well as sound, colour, and perfumes. I mentioned visual images, acoustic image, kinaesthetic images, olfactory image earlier. Those really powerful, right? I did a little experiment with Joe Malone. We made a Swan Lake exhibition in London at the Opera House, through smell only. We have the choreographic journey as to olfactory image. That was a really lovely experiment, but it’s very difficult. It’s very difficult to work
in that way. There’s a new venue in London called the Sphere, which is a brilliant system that can send different audio streams to each visitor. 20,000 people can have different sound relationships with the show. They’re pioneering that same technology for smell, so that you can direct an olfactory stimulant to one person and a different one to another. You might smell cut grass and you might smell burning fire. And that’s very interesting. How we can build an environment where visual, sonic, and olfactory experience are opposed to the person next to you? We always talk about dance being a collective experience, which of course it is, but we don’t experience the same things in the same way, anyway! This just highlights that, and I’m very interested to see what that technology will be.
Good question. I think we’ve been pushed into describing meaning in words and retrospectively analysing work, looking back and saying ‘this word means this’ and therefore you should see this. I’m very much more of a believer in the need to interact and notice your senses, and in doing that, when you audit your senses, meaning emerges rather than the other way, where you have a rational idea about what the meaning is. ‘This means X and you try and find it in the work’. They’re both valid ways, they’re just different, and I just think there’s too much obsession in dance with concreteness, with specificity, in terms of meaning, whereas we know that dance is slippery and ambiguous, and it connects with us in lots of different ways. And we should celebrate that. You know, why do we have to pin it down by going X = X I don’t need to tell you all of my research unless you’re interested in it, for you to look for that specific thing in there. What I want you to do is to experience the work and think: this is how this moves me or makes me feel or reminds me of, and you build the meaning for it.
I think a lot of early audiences who don’t see a lot of dance worry that they’re not going to get it. “We don’t get it”. And I think it’s partly our fault that we kind of say to them “You should get it”. This expert language in ballet means this, and you should know it. And if you don’t know, that excludes you and actually, what we should be saying is: “Go see Swan Lake. What do you see? What do you notice?”. When you do that with eight-year-olds, they’re so freer, they see so much, and that’s the kind of playful curiosity you want to encourage an audience. I hope in this festival the audiences will look with that playful curiosity.
Venezia, troppo spesso volutamente relegata a palcoscenico di eventi nazional-popolari, perfettamente aderenti a quell’idea di città contenitore vittima di un eccessivo turismo di qualità non elevata, sa ancora stupire per le sorprese che riserva, sapendo volgere lo sguardo e l’attenzione oltre il nulla in termini di progetti e di prospettive in cui pare ingabbiata. Ci sono, per fortuna, ancora un numero sufficiente di persone che amano la città e i suoi infiniti risvolti e la frequentano sommessamente, senza clamore, dimostrando amore e rispetto verso un luogo senza pari. Le occasioni di poter incrociare personaggi straordinari ancora sussistono e l’intervista che segue, in realtà un dialogo senza rete, favorito da una comune e preziosa amica, testimonia la forza attrattiva di Venezia che ancora accoglie i suoi ammiratori sinceri, oltre ogni irragionevole selfie.
Ampio risalto era stato dato sulla stampa nazionale e internazionale nello scorso mese di maggio a un’importante asta di opere d’arte tenutasi da Sotheby’s a New York, il cui ricavato sarebbe andato in beneficenza. Tra queste spiccavano un Picasso, Femme nue couchée jouant avec un chat, e un Fontana, Concetto Spaziale, Attese del 1968, ultimo anno in vita dell’artista, dal colore azzurro vivido. La collezionista-filantropa in questione, Maria Manetti Shrem, si trovava a Venezia a fine maggio per una serie di visite artistiche. Ci siamo incontrati all’hotel Centurion, seduti ad un tavolo a conversare. Fiorentina, nata sotto le bombe della Seconda Guerra mondiale, appassionata sin da bambina di arte, cultura e musica, questa straordinaria signora dell’arte ha saputo mantenere intatto il fascino di un’età matura con la vivacità di uno sguardo sempre attento e curioso. La sua eleganza, armoniosa e non priva di vezzosità, con quegli eccessi che spettano solo a chi è in grado di reggerli con totale naturalezza, oltre al suo garbo e la grande passione con cui parla della sua vita, che sembra la sceneggiatura di un film, hanno reso piacevolissimo l’ascolto. Ha iniziato molto presto a lavorare e ha dato vita poco più che ventenne ad una azienda di confezioni per donna. Ha esportato il marchio in tutta Europa e specialmente negli Stati Uniti, Paese che negli anni Sessanta ha esplorato coast-to-coast. Viaggiare è sempre stato il suo ossigeno; una forma di apertura profonda che l’ha condotta oggi a dedicarsi con amore al sostegno di diverse forme d’arte e della ricerca medico-scientifica. Ha costruito una vita e una carriera di grande successo a San Francisco, dove si trasferì per amore del primo marito, all’età di trent’anni. Negli anni Settanta e Ottanta ha messo in atto un’idea imprenditoriale risultata vincente con cui ha presentato il meglio della moda italiana con la società di distribuzione Manetti Farrow, che ha collaborato in modo decisivo al posizionamento negli States delle grandi firme italiane

ed europee, tra cui Gucci, Fendi, Mark Cross. E sempre ad accompagnarla c’era, parallelo e però centrale nel suo vissuto, l’universo dell’arte, della musica, dell’opera, che è poi stato anche il motore di un costante impegno filantropico e come mecenate. Maria Manetti Shrem ha costruito infatti nel tempo solidi legami di amicizia con i più importanti artisti del mondo, da Jeff Koons a Olafur Eliasson, da Peter Gelb a Renée Fleming, ma anche con Placido Domingo, Andrea Bocelli e Nadine Sierra, solo per citarne alcuni, forte della sua innata capacità di mettere insieme reti, contatti e persone di mondi differenti per dar vita a nuove e concrete idee quasi sempre sfocianti in riusciti progetti.
Da dove nasce in lei l’amore per il prossimo che le fa dire che «l’arte della vita è l’arte di saper donare», soprattutto al fine di poter supportare i talenti e i più bisognosi?
Credo fermamente che l’arte di vivere coincida con l’arte di saper donare. Non sono mai stata così felice nella mia vita da quando, più
di dodici anni fa, ho scelto di dedicarmi alla filantropia, letteralmente intesa come “amore per l’umanità”, supportando in maniera continua diverse fondazioni con i profitti delle opere d’arte della nostra collezione e di proprietà personali che ho messo in vendita. Il mio sostegno va particolarmente ai talenti nel campo dell’istruzione, della musica, dell’arte e della ricerca medico-scientifica in soccorso dei più bisognosi, quali le persone anziane con malattie neurodegenerative, e dei più piccoli e indifesi. Sono nata a Firenze il giorno in cui Mussolini ha siglato il Patto d’Acciaio con Hitler, trascinando il Bel Paese nella Seconda Guerra mondiale e un intero popolo in un clima di povertà, morte, paura e incertezza. Ho vissuto sin da bambina, per merito della mia famiglia, l’empatia e l’amore per il prossimo, ma solo molto più tardi nella mia vita, in seguito a grandi dolori personali, ho conosciuto il buddismo, avviandomi verso un progressivo percorso dedicato alla “compassione” e al “distacco” dalle cose materiali. Sono determinata a dare indietro con la mano calda, e non dopo morta, tutto quello che sono riuscita a creare con le mie forze, reinventandomi anche più volte nella mia vita. Per questo la mia più alta missione adesso è raggiungere il “distacco” dalle cose materiali. I have already enjoyed art; con mio marito Jan Shrem, un self-made man come me, avevamo una proprietà meravigliosa, Villa Mille Rose a Oakville, la più bella forse di tutta Napa Valley, creata pensando alla mia Toscana, piena di opere d’arte. Ho visto spesso il lavoro svolto dai trustee dopo la morte di miei amici, perciò per me è sempre più vero pensare a: the joy of living from the joy of giving.
Con suo marito avete creato il Manetti Shrem Museum of Contemporary Art di UC Davis, una sorta di “bottega dell’arte” rinascimentale nel cuore della California. Ci parli un po’ di questo intrigante progetto.
A cinque anni dall’inaugurazione del nostro Museo nel campus di UC Davis «Artnews» ci ha incluso nella lista dei 25 migliori edifici museali al mondo degli ultimi cento anni.
Devo il mio coinvolgimento con UC Davis all’artista e filantropa Margrit Mondavi, che nel 2011 mi propose l’opportunità di trasformare un campo abbandonato a erbacce da oltre vent’anni in un monumento per l’avvenire: il Manetti Shrem Museum of Contemporary Art. Oggi di fatto il Museo sigilla l’eredità artistica di questa università, che dagli anni ‘50 ha visto qui impegnati artisti-insegnanti del calibro di Wayne Thiebaud, William T. Wiley, Robert Arneson, Manuel Neri, Roland Petersen, Ruth Horsting, Mike Henderson, facendone il più importante “teaching museum” d’America. Il Museo, definito da Gary May, rettore dell’Università di Davis, “il gioiello della corona” dell’ateneo californiano, funge da vera e propria “bottega dell’arte”, dove gli studenti, grazie al fatto che il trenta per cento degli spazi è adibito all’insegnamento, imparano creando, potendosi confrontare direttamente con opere contemporanee e artisti internazionali ancora viventi che vengono qui ad insegnare durante l’anno. Dal 2020 finanzio il celebre California Art Studio del College of the Arts di UC Davis, permettendo ad artisti e curatori di livello internazionale di venire a insegnare tenendo delle masterclass. Negli anni Sessanta le migliori università d’arte in America erano Yale e UC Davis. Vogliamo riportare l’Università di Davis in testa e direi che siamo sulla buona strada. Ogni anno quattro artisti laureati vengono selezionati per uno scambio con la Royal Drawing School. Abbiamo di recente

All too often, Venice is relegated to the role of stage and little more, a container city for mass tourism, though in fact, there’s no limit to how much it can surprise us if we know where to look. There’s enough people around that love Venice for what it is, and show it respectfully. Take last May’s auction at Sotheby’s New York, for example, a charity auction held on a Picasso, Femme nue couchée jouant avec un chat, and a Fontana, Concetto Spaziale, Attese of 1968. The collector and philanthropist in question is Maria Manetti Shrem. Born in Florence during World War II, Manetti Shrem developed an early interest for art, culture, and music. She worked in fashion throughout her life and established her own brand in Europe first, and in the Unites States after, where she moved to in her thirties. Her import business, Manetti Farrow, was essential in establishing the presence of Gucci, Fendi, Mark Cross in America. Parallel to her business, Maria Manetti Shrem always nurtured her interest for art, music, opera and befriended Jeff Koons, Olafur Eliasson, Peter Gelb, Renée Fleming, Plácido Domingo, Andrea Bocelli, and Nadine Sierra, to name a few.
I firmly believe that the art of living is the same as the art of giving. Never in my life have I been happier than the moment when, twelve years ago, I decided to dedicate to philanthropy, literally ‘love for mankind’. I love to support talent in the fields of education, music, art, and medical and scientific research, especially concerning geriatric medicine and neuro-degenerative disease, as well as initiatives to help children and those in need. I was born in Florence on the day Mussolini signed the Pact of Steel with
ospitato anche la curatrice Cecilia Alemani e in autunno abbiamo in programma un ciclo di lezioni di Catherine Goodman, artista e founding-director della Royal Drawing School. Stiamo anche valutando progetti dedicati con il dipartimento di moda, design e tessile. Il 18 giugno, in occasione della cerimonia di laurea degli studenti di UC Davis, mi è stata assegnata la maggiore onorificenza accademica, la “UC Davis Medal”, per essere diventata la maggiore filantropa dell’arte e della cultura nella prestigiosa università californiana. Al mio fianco i miei carissimi amici filantropi Robert e Margrit Mondavi, il grande pittore Wayne Thiebaud, l’ex presidente Bill Clinton, il premio Nobel per la medicina 2020 Charles Rice. I miei genitori sarebbero oggi molto felici e orgogliosi della loro Maria: ora il mio nome campeggia anche nei segnali stradali per indicare l’uscita per l’omonimo museo a UC Davis!
Dalle sue parole emerge chiaramente l’importanza e il valore assoluto dell’arte e della cultura, che per lei e suo marito hanno svolto e svolgono un ruolo a dir poco nevralgico nelle vostre esistenze. Da dove nasce questo amore “radicale”? Il valore della cultura è la base di tutto per me e mio marito. La mia vita nello specifico è cambiata radicalmente per via dell’istruzione scolastica che ho ricevuto da bambina grazie a un mio zio siciliano, Marcello, il quale suggerì a mia mamma di farmi studiare piuttosto che mandarmi a lavorare come tutte le altre ragazzine, perché aveva visto in me un qualcosa di speciale da dover coltivare. Mia madre Tosca, andando in controtendenza rispetto alle abitudini delle famiglie modeste negli anni ‘50, decise così di “investire” nel talento di uno dei suoi quattro figli, fornendomi le basi culturali che hanno alimentato la mia curiosità per il sapere, i viaggi, la scoperta e la vita. Essendo però l’anno scolastico già cominciato, l’opzione restava solo quella di un tutor privato. Fu allora un privilegio assoluto avere una maestra tutta per me: Flora Cascio, anche lei siciliana – non la dimenticherò mai! –, la quale mi costruì delle basi eccezionali per inserirmi presto a scuola e per poter subito dopo entrare nel mondo del lavoro con un’impresa di moda da me stessa creata agli inizi degli anni ‘60 per esportare le creazioni italiane in Europa e in America.
Altra sua grande passione è l’opera lirica. Mi sono innamorata dell’opera a quindici anni ascoltando Renata Tebaldi nel ruolo di Mimì nella Bohème al Maggio Musicale Fiorentino. Da quella sera l’opera è entrata nella mia vita per sempre, alimentando le mie emozioni e la mia passione romantica per la vita. Lo scorso 3 dicembre la San Francisco Opera, in occasione del mio cinquantenario in America, mi ha tributato sul palcoscenico, mano nella mano con gli artisti alla fine dell’ultima replica de La Traviata, la sua più grande onorificenza: The Spirit of the Opera per il mio continuo e sempre crescente contributo a questa ammirevole organizzazione culturale creata cento anni fa dall’italiano Gaetano Merola e da altri amanti dell’opera. Quella sera ho provato una delle emozioni più forti della mia vita. Niente male considerando che cintquant’anni prima stavo in piedi in fondo al teatro, pagando pochi dollari pur di vedere e ascoltare un’opera. La città e la Contea di San Francisco, oltre ad aver proclamato in nome mio e di mio marito il 22 giugno quale giorno dedicato alla filantropia, ha anche illuminato con il Tricolore la cupola del Comune per onorare la mia attività filantropica. Un fatto unico, che accade solo per i capi di stato in visita in città!
Lei è un’icona di stile. Come potrebbe definire la sua relazione con la moda?
La culla del Rinascimento e del made in Italy è Firenze. Personalmente vedo nella memorabile sfilata di Giovanni Battista Giorgini alla Sala Bianca di Palazzo Pitti l’origine della moda in Italia. Era il 12 febbraio 1951. A Firenze negli anni Sessanta ho costruito la mia prima azienda di moda, nutrendomi della bellezza architettonica di una città unica. Negli anni Settanta, a San Francisco, ho cominciato a lavorare per gli specialty stores dei Magnin. Negli anni Ottanta sono diventata un’esperta di internazionalizzazione del made in Italy, in particolare per gli accessori di Gucci, Fendi e Mark Cross. L’Italia ha un patrimonio immenso nell’artigianato ed è un valore universalmente riconosciuto. Anche il Re Carlo, della cui amicizia mi onoro – sono una delle poche persone che lo possono abbracciare e baciare senza infrangere le rigide regole del protocollo di Corte –, mi ripete sempre che le nostre eccellenze dell’artigianato devono essere mantenute e supportate perché sono espressioni fantastiche di saperi antichi e abilità manuali uniche. Quando Dolce & Gabbana nel 2020 decisero di organizzare la loro sfilata di haute couture a Firenze, mi telefonò Domenico (ndr: Dolce) invitandomi in Italia per l’occasione, dicendomi che ero stata io la ragione, la suggestione di fondo della loro scelta di Firenze. Pur avendo il doppio passaporto, ero riluttante a muovermi dagli Stati Uniti in quell’anno di piena pandemia. Tuttavia, quando Domenico mi disse che avevano coinvolto ben 35 artigiani per questo grande progetto, non ebbi esitazione nell’accettare l’invito e corsi a Firenze. A quel punto davvero non avrei potuto che condividere entusiasticamente una simile scelta.
C’è in lavorazione un biopic sulla sua vita. A chi è maggiormente indirizzato questo documentario?
Ho chiesto anni fa a Mauro Aprile Zanetti, siciliano che vive a San Francisco, di scrivere e creare un biopic sulla mia vita, avendo lui una duplice ottima conoscenza della cultura italiana e di quella americana. La mia vita si incastona perfettamente tra il sentimento del Rinascimento, cioè la mia Firenze e il profondo “cultural background” che mi ha donato, e il “California dreaming”, incarnato dalla mia San Francisco e dal sogno americano, che sono riuscita a creare, vivere e condividere con più persone possibili, sostenendo la meritocrazia. L’idea è di raccontare come io mi sia sempre dovuta reinventare sin da ragazzina; successivamente da giovane donna rinunciando a tutto quanto avevo creato nella mia adorata Firenze, consapevole di dover ripartire da zero pur di seguire il mio cuore nel nuovo mondo; e infine da donna adulta, dovendo imparare di gran corsa e nelle difficoltà di un cuore infranto a saper gestire i miei asset
Ho sempre continuato a sognare con determinazione e resilienza, vivendo la vita nella sua meravigliosa pienezza, illuminata dalla bellezza dell’opera lirica e dell’arte, dall’amicizia e dall’amore. Pertanto vorrei poter motivare i giovani e più persone possibili a vivere la vita da protagonisti: sognando in grande, senza avere paura, incoraggiandoli a non mollare mai e a reinventarsi. Vorrei inoltre mostrare ad altri benestanti quanto bene si possa fare per l’umanità condividendo anche solo una piccola parte della propria fortuna da vivi, per rendere il mondo un posto un po’ migliore. Qui e ora, non domani.
Hitler, pushing Italy and a whole people into World War II: poverty, death, fear, uncertainty. Since childhood, and thanks to my family, I understood the importance of empathy and love for our fellow human beings, though only later in life did I meet Buddhism, and I worked on compassion and detachment from materiality. I want to give back what I had while I’m still here, not after I’m gone. I have already enjoyed art with my husband, Jan Shrem, who is as much a self-made man as I am a self-made woman. We used to maintain a wonderful estate, Villa Mille Rose in Oakville, I’d say the most beautiful of the whole Napa Valley. I designed it with Tuscany in mind, and filled it with art. I took notice of how some trustees worked after the death of some friends, and it made me think of the joy of living, and of the joy of giving.
Five years into the life of our Museum at UC Davis, Artnews included us as one of the 25 best museums of the last 100 years. I owe my connection to UC Davis thanks to artist and philanthropist Margrit Mondavi, who in 2011, offered me the chance to turn a barren, abandoned lot into a monument to the future: the Manetti Shrem Museum of Contemporary Art. Today, the Museum embodies the art heritage of a university that employed artists such as Wayne Thiebaud, William T. Wiley, Robert Arneson, Manuel Neri, Roland Petersen, Ruth Horsting, Mike Henderson. This is, in fact, the most important teaching museum of America. Since 2020, I have also been supporting the California Art Studio at the College of Arts, allowing artists and curators to hold their master classes here. In the 1960s, the best art colleges in America were Yale and UC Davis. We want UC Davis to be back where it belongs, and we are right on track to do that. every year, four graduates are picked for an exchange with the Royal Drawing School. We recently hosted curator Cecilia Alemani and for the next fall, we programmed a series of classes with Catherine Goodman, artist and founding director of the Royal Drawing School. We are also evaluating other projects with the department of fashion, design, and textile art. On June 18, for graduation day at UC Davis, I have been given the UC
Davis Medal for my philanthropy. Beside me were my dear friends and fellow philanthropists Robert and Margrit Mondavi, painter Wayne Thiebaud, Bill Clinton, and the 2020 Nobel laureate Charles Rice. My parents would have been proud, wouldn’t they?

Where does love for the arts come from
The value of culture means the world to my husband and me. Specifically, my life changed because of the education I received, as a child, thanks to an uncle of mine, Marcello, who encouraged my mother to leave me in school, and not make me work like other girls had to. Uncle Marcello saw something in me. My mother took his advice, contrary to what basically every other family did, and invested in the talents of one of his four children, which gave me the education that fed my passion for knowledge, travel, discovery, and so on. I had a private tutor: Flora Cascio, also a Sicilian. Flora gave me an excellent education, which meant I could easily transition to school, and to the workforce later.
Opera
I fell in love with opera at 15, when I saw Renata Tebaldi starring as Mimì in Florence. That night, opera entered my life forever. On the last December 3, I celebrated my fifty years in America with the San Francisco Opera, who performed the Traviata and honoured me with the Spirit of the Opera for my ongoing contributions to this admirable cultural organization, founded a hundred years ago by an Italian, Gaetano Merola, and other opera lovers. That night, San Francisco City Hall was illuminated in red, white, and green!
The birthplace of Italian Renaissance is Florence. I identify the origin of the modern Italian fashion industry with the memorable show by Giovani Battista Giorgini at Palazzo Pitti. It was February 12, 1951. In the 1960s, I founded my first fashion business in Florence, and in nourished it with the beauty of a unique city. Italy has an immense craftsmanship heritage, everybody acknowledges this. Even King Charles, a personal friend, maintains that these centres of excellence must be supported for their uniqueness and abilities. For their 2020 runway show in Florence, Dolce & Gabbana invited me, as well. They said I was the reason for their choice of holding the show in Florence in the first place. I was a bit scared because of the pandemic, but when Dolce told me that thirty-five craftsmen contributed to their project, I had no doubt. I flew straight to Florence. I was that enthusiastic about their choice.
Years ago, I asked Mauro Aprile Zanetti, also an Italian-born San Franciscan, to write a biopic on my life, which built upon a Renaissance sentiment – my very Florence and the cultural background it gave me – and California dreaming – my San Francisco and the American dream, which I was able to live and share with many, many people. I’d like to tell the story of how often I reinvented myself since childhood, and how I left it all in Florence and started anew in a new country.
I have always kept on dreaming with determination and resilience. I have always lived life in its wonderful fullness, illuminated by the beauty of opera, art, friendship, and love. In fact, I want to motivate the younger generations to live their lives as protagonists: dream big, have no fear, never quit, and know how to reinvent yourself. I would also like to show other wealthy people how much good can one do for mankind by sharing even a little amount of what you have. You can make the world a better place right here, right now. No need to wait.
Una cosa sola appare a me dura in questa citade, che siando posti in l’aqua fin a la bocha, spesse volte moreno de sete, e mendicano la bona acqua per poter bevere e per cuxinare, maxime al tempo de la estate. Vero è che hanno de molte cisterne per ricogliere l’aqua pluviale, et anche se ne vende in belle barcate; aqua del fiume che vene verso Padua, chiamato la Brenta, e con questa via pur provedono a li loro bisogni, pur con dificoltà e con spesa, e non pono fare tanta derrata de lavare panni de aqua dolce come se fa altrove

Il cinque giugno 1494 Pietro Casola, Canonico del Duomo di Milano d’anni sessantasei, s’imbarcava sulla Galeazza del Zaffo, quella diretta a Giaffa ormeggiata davanti Palazzo Ducale, per intraprendere il viaggio per mare verso la Terra Santa. Il pellegrino Pietro era giunto a Venezia venti giorni prima – il ventuno maggio – ma bisognava attendere prima della partenza fintanto che fosse completato il carico dei viaggiatori “ultramontani” che avrebbero affrontato assieme a lui con non poca trepidazione la lunga navigazione verso Gerusalemme:
…fui presentato per alcuni Mercadanti al Magnifico D. Augustino Contareno patritio Veneziano e capitaneo de la Galeazza del Zaffo: cosi se dice a la Galea de li peregrini che vanno in Jerusalem: et me feci scrivere in el libro de li peregrini. Et stando così intendeva che era stato troppo solicito al partirme de caxa et che bisognava stare li più giorni prima che se partisse dicta Galea.
Per il presule milanese non v’era alcun motivo d’impazienza; anzi, l’imprevista sosta nell’attesa della partenza sarebbe diventata per lui, uomo colto e interessato, un’insperata occasione per visitare Venezia, una delle città più famose al mondo per i commerci, per i suoi ricchi monumenti, per i noti artisti che l’avevano abbellita e per la sua esatta e solida forma di governo. Tutto a Venezia era stupefacente e diverso e non ci sarebbe stato modo di annoiarsi a scoprire la città sorta in mezzo alle acque che la delimitavano all’esterno e che si insinuavano nel suo tessuto urbano con mille canali. Valeva la pena, dunque, cogliere senza indugi l’opportunità e spendere il tempo a disposizione per tentare di fissare nella memoria e annotare in un diario, che oggi si conserva nella Biblioteca Trivulziana di Milano, le cose viste e vissute per la soddisfazione della propria curiosità e per la salvezza della propria anima.
…non è possibile dire nè scrivere pienamente la belleza, la magnificentia, nè la riccheza della città de Venezia; ma se ne po’ dire e scrivere qualche cosa per passare tempo come facio io, ma da non credere da chi non la vede […]. Io ho veduto questa citade essere posta tutta in aqua e palude; et parme si possa tutta per ambulare a pede chi vole, siando ben netta e pulita: chi anco non vole durare la fatica, po’ per aqua, e pregato, e con poca spesa, e manco che non farebbe altrove andare a cavallo.
Casola si rende conto che la città è grande e che ci sarebbe voluto molto tempo per girarla tutta, con tante piazze, chiese e palazzi meravigliosi. Primo fra tutti il Palazzo Ducale che, proprio in quegli anni della fine del Quattrocento, mostrava la sua nuova facciata verso la Piazzetta appena completata con la stessa partizione architettonica e con lo stesso decoro lapideo colorato che era stato usato quasi un secolo prima per la facciata gotica verso il bacino lagunare.
Io ho veduto tanti belli palacii comenzando al palacio de sancto Marco, dove de continuo sta el Duce con la sua famiglia, el quale parte è rinovato in la sua faciata, e con grande
pompa de auro, e se li fa di nuovo una scala per ascendere dicto palacio dal lato de la Giesia de santo Marco, cosa stupenda e de grande spexa. El suo portico de soto è con tanto ordine che non si po’ dire più. Vero è che lo guasta le carceri, che invero non li stanno bene. Poi el portico intorno di sopra parte guarda sopra la piazza, parte sopra el canale grande, parte sopra uno canale picolo et una parte verso la Giesia de sancto Marco; et tutto questo portico con le sue columme de marmoro, e altri belli ornamenti.
Agli occhi del pellegrino Pietro, quella del doge appare come, una dimora “stupenda e de grande spexa”. All’esterno, a formare loggiati, due file di colonne marmoree sovrapposte che, come tronchi d’albero, si ramificano nei capitelli con rigoglioso e aggettante fogliame dai quali spuntano le raffigurazioni di un realistico bestiario con fiere, animali domestici, rapaci predatori e indifese prede, piccoli uccelli dai teneri piumaggi, pesci e volatili acquatici dai lunghi colli e dalle zampe palmate. Nei capitelli anche frutti raccolti – fichi, ciliegie, pere, pesche, zucche, meloni e cetrioli – disposti in canestri di vimini intrecciati come se ne trovano al mercato e tanta uva che spunta dalle mani di putti gioiosi e che tracima dai tini come al tempo della vendemmia. Generosi grappoli pendono anche dalla vigorosa vigna alla quale Noè ebbro cerca di sorreggersi, oramai vinto da quei frutti dei quali non conosce gli effetti. La percezione complessiva di questo insieme naturale scolpito nel bianco abbacinante della pietra d’Istria, sembra suggerire al pellegrino l’immagine di un favoloso giardino, una sorta di paradiso terrestre che circonda la dimora del doge. Ma il Palazzo riserva altre sorprese all’acuto pellegrino che egli annota diligentemente nella cronaca del suo soggiorno veneziano. Pochi anni prima del suo arrivo nella città lagunare, per esaltare i riti solenni delle feste dogali era stata innalzata nel cortile interno una nuova scala monumentale – la Scala dei Giganti – rivestita da marmi a bassorilievo, questa volta con le nuove delicate figurazioni portate dallo stile rinascimentale.
In questi marmi, i soggetti della natura non erano replicati in modo realistico come era stato nelle logge e nei capitelli esterni, ma prendevano forme rielaborate e allusive, spesso fantastiche, combinandosi in raffinati disegni di piante e di animali che assumevano anche aspetti fantastici, a volte mostruosi; oppure si armonizzavano entro vasi e panoplie con l’andamento morbido di fogliami stilizzati, di spighe di grano e di teneri tralci intrecciati a sinuosi nastri; o ancora venivano composti in esuberanti corolle di fiori, legati in opulenti trofei dai turgidi frutti e profusi in una lussureggiante abbondanza d’uva, quasi a suggerire l’idea di una continua primavera o di una vendemmia perpetua. Anche negli stemmi dogali posti sulla facciata del cortile interno comparivano fiori di loto e i tre grappoli, d’uva. I primi a distinguere il casato di Giovanni Mocenigo, i secondi quello di Cristoforo Moro, due dei dogi che di recente avevano contribuito a creare quel meraviglioso giardino di pietra e che forse intesero con la molteplicità e l’intensità di queste raffigurazioni allietare la vita della massima autorità dello Stato veneziano, costretta nella sua città e obbligata come un prigioniero a rimanere confinata nel suo palazzo. Casola prosegue la sua cronaca soffermandosi a descrivere gli interni monumentali del Palazzo dove viene attirato e stupefatto dalla
quantità d’oro che abbaglia il visitatore. Passa quindi a descrivere quello che egli incontra fuori da quelle mura, dentro il cuore della città, dove invece rimane affascinato dall’abbondanza della natura viva e colorata dei cibi, da quelli esposti sui banchi e nelle botteghe di Piazza San Marco a quelli che si potevano trovare al mercato di Rialto «in tanta quantitade chel pariva che tutti li zardini del mondo sorgessero li». Qui Casola inserisce una gustosa relazione che indugia a lungo e con ricchezza di particolari nell’enumerare tutti quegli appetitosi alimenti – pane, carne, pesci, formaggi – che si potevano trovare in città e che egli con determinazione vuole bene fissare nella propria mente prima di affrontare i digiuni imposti dalla fede e dagli imminenti, inevitabili stenti della navigazione verso il Levante.
Andai al locho dove si vendono le farine in genere; el mondo non ha al presente così singolare cosa. Vedendo tanta abundanzia e bellezza da me sono confuso. De la grande quantitate de’ paneteri aliter dicti poste de pane, e in uno locho solo videlicet alla piazza de sancto Marco, e per tutta la citade, dico sono senza numero e de belleza incredibile: pane che vedendolo l’homo etiam ben stomachato se invita a reficiarsi […]. Con la carne li danno un grande pezo de osso. […] De Polli e altre generationi di uccelli per mangiare, secondo lo tempo li sono stato, a me pare abundantissima ma alquanto cari. De formagi o caxi, e butiri abundantissima, e dico più che Milano, che deve essere el fondaco di
ciò, e che soleva essere. Di pesci è superfluo volere recitare l’abundantia quotidiana: maxime in due loghi, a S. Marco e in Rialto, così se chiama vulgariter; mai non li mancano pesci.
Ma la più grande meraviglia dell’accorto pellegrino era quella di vedere ogni mattina arrivare i battelli che dagli orti delle vicine isole lagunari e dalla limitrofa terraferma rifornivano la città di grande quantità di frutti di stagione, di legumi e di verdure fresche d’ogni genere.
De li fructi, quanto al tempo li sono stato aspectando la partita de la Galea, per non aver che altro a fare, più giorni a la mattina solicitai andare a S. Marco, e cosi in Rialto per vedere scaricare le barche che giungevano de hora in hora. Vedere tante barche de fave grosse, ardiglione [piselli], cirese, non tamen de ogni condicione como è a Milano, ma ogni giorno in tanta quantitade chel pariva che tutti li zardini del mondo sorgessero li. Et dico che erano in tanta quantitade che vedendole et voltando le spalle apena el credeva. L’abundantia de le verdure al parlare nostro, e bone de ogni conditione, è migliore mercato che in loco abbia mai veduto. E per quello che ho potuto intendere vengono da XXV miglia oltre. Sono stato più volte a la mattina per vederle scarigare da le barche; a me pariva che alhora fosseno tolte dagli orti, e bene adaquate.

Per quanto riguarda i vini, questi provenivano da paesi d’oltremare in grande quantità e di tutte le qualità, cari nel prezzo, ma non per questo sempre buoni; sicuramente innumerevoli erano in città i luoghi dove si poteva berli o acquistarli.

L’abundantia de li vini de ogni condizione la posso ricordare; ma quasi da non credere, tante malvasie, tanti vini moscatelli, vini di Romania, vini bianchi de ogni mano, e così de vini rossi; e ben che non siano de quella perfectione sono li nostri, tamen sono boni, parlo de’ vini rossi; e per le grande gabelle sono cari. Me sono misso a volere numerare li magazini del vino de ogni conditione; ma quanto più ho numerato, tanto più me sono confuso. Sono invero innumerabili.
Con il buon ricordo delle osterie veneziane finalmente Casola si imbarca sulla galera Contarina lunga 50 metri, assieme ad altri 170 pellegrini e con 140 uomini di equipaggio. Il prezzo convenuto per il trasporto era di 60 ducati d’oro “tutto compreso” con il sovraprezzo di altri 30 per essere ammesso alla tavola del capitano della galea.
In una sua nota dedicata alla Serenissima prima della partenza, Casola coglie il drammatico paradosso che turbava la magnifica esistenza di Venezia: una città sorta dall’acqua, che sull’acqua aveva fondato la sua potenza e ricchezza e che dall’acqua traeva abbondanti e variati nutrimenti per le mense dei suoi abitanti e dei suoi ospiti, rischiava ad ogni stagione secca di svigorire e morire di sete, nonostante gli ingegnosi sistemi di raccolta pluviale e di approvvigionamento con barconi che attingevano il vitale elemento dai fiumi vicini.
Una cosa sola appare a me dura in questa citade, che siando posti in l’aqua fin a la bocha, spesse volte moreno de sete, e mendicano la bona acqua per poter bevere e per cuxinare, maxime al tempo de la estate. Vero è che hanno de molte cisterne per ricogliere l’aqua pluviale, et anche se ne vende in belle barcate; aqua del fiume che vene verso Padua, chiamato la Brenta, e con questa via pur provedono a li loro bisogni, pur con dificoltà e con spesa, e non pono fare tanta derrata de lavare panni de aqua dolce come se fa altrove.
La galera dei pellegrini nella sua abituale rotta verso Levante, tocca i porti di Parenzo, Zara, Ragusa, Corfù, Modone, Candia, Rodi, Cipro e dopo 47 giorni di navigazione, il 17 luglio, arriva a Giaffa. Di qui a dorso di mulo Casola raggiunge Gerusalemme dove rimane 15 giorni, tenendo sempre aggiornato il suo diario con osservazioni storiche, artistiche, religiose e annotazioni sui luoghi della Terra Santa e sugli usi e i costumi delle genti che incontrava. Fra venti contrari, bonacce, fortunali il ritorno a Venezia dura più di due mesi e Casola, appagato per le nuove esperienze e confortato per la salvezza della sua anima, finalmente rientra a Milano che aveva lasciato sei mesi prima sotto il governo di Ludovico Sforza e che ritrova occupata da una avanguardia dell’esercito francese di Carlo VIII. Da allora per le belle terre d’Italia comincia tutta un’altra storia.
La trascrizione del manoscritto Viaggio a Gerusalemme di Pietro Casola, conservato nella Biblioteca Trivulziana di Milano, è tratta dall’edizione a stampa curata da G. Porro, Milano, Tipografia Paolo Ripamonti Carpano, 1855. Cfr. anche Viaggio a Gerusalemme di Pietro Casola, a cura di Anna Paoletti, Edizioni dell’Orso, Alessandria, 2001








L’architettura è una pratica di pensiero e costruire non è la miglior risposta per confrontarsi con il presente

La narrazione di una mostra non è quasi mai un quaderno di viaggio. Più spesso, assume pose culturaliste con l’obiettivo di promuovere posizioni o ideologie, o modelli didascalici, utili per affiancare una visita o archiviarne la memoria. Altre volte – quasi sempre, in realtà – i cataloghi ricordano gli stucchevoli “fiori in cornice” di Gozzano, con la sua Venezia ritratta a mosaici e gli acquerelli un po’ scialbi. Lesley Lokko, invece, abilissima narratrice tra le più popolari voci della “diaspora africana”, per la sua Biennale dedicata al presente inteso come laboratorio del futuro, fa tre scelte molto precise rispetto a cosa debba essere questo catalogo: un quaderno di viaggio, un ascolto plurale, una mostra esso stesso. Il viaggio, in particolare, non ha nulla a che vedere con le incursioni orientali dello sguardo veneziano di Marco Polo, non ha la forma intima dei pellegrinaggi d’arte di Bernard Berenson, non ha neppure il tono disincantato dei reportage di Arbasino in Cambogia. Il viaggio di questo catalogo è anzi inteso come pratica di ascolto e invito alla riflessione, non come esperienza di osservazione e neppure come deposito di giudizi. A parlare, per l’appunto, sono un ampio e inaspettato numero di voci, nella forma di testi brevi stampati in grande, o di citazioni sintetiche e incisive, affiancate da una sequenza di grandi immagini autoriali di luoghi e pratiche dell’Africa contemporanea, ma anche dalle tracce del dialogo curatoriale, riportate attraverso i frammenti delle lettere della Lokko usate come invito per i practitioners, che sono definiti così invece che “architetti”, non solo in ordine a una maggior inclusività ma anche per dare maggior conto di che cosa significhi oggi occuparsi di produzione dello spazio. Coerentemente con l’intenzione di fare del catalogo, a un tempo, un viaggio e una mostra, il volume principale non ha un indice. Esiste piuttosto un sommario, che è poi una approssimativa scorsa delle parti, che inquadra alcuni nodi concettuali, fondanti per la Lokko. In ultimo, le sezioni dedicate ai diversi progetti speciali, al public program – un “Carnevale” nel senso inteso da Bachtin, peraltro citato, al College, esperienza educativa nuova per la Biennale Architettura ma già sperimentata in altre sezioni dell’Istituzione Veneziana. Va certamente detto che il catalogo prevede tradizionalmente un comune canone: due volumetti, uno più ampio dedicato alla mostra principale – che è poi anche quello più corposo, in cui emergono le scelte curatoriali, e uno che si occupa dei Padiglioni nazionali, raccogliendo come da tradizione la sequenza delle schede fornite dagli Stati partecipanti, quest’anno 64. Il catalogo accoglie poi due contributi testuali, uno del Presidente e uno del Curatore, infine si compone delle sezioni della mostra e di tante schede quanti partecipanti. Poiché questa struttura è pressoché identica a sé stessa da molti anni, quel che conta, più che il canone, è l’eccezione.
L’anomalia di questo catalogo sta nel fatto che invece di trovarci tra le mani il pacificato precipitato di una mostra rassicurante, abbiamo invece un volume solido e stimolante che esprime due movimenti: da una parte uno statico, il posizionarsi preciso di una scelta, che emerge tanto nella mostra quanto nel catalogo attraverso una pluralità di voci non coincidenti; dall’altra uno dinamico, ovvero un invito all’azione che non è il tradizionale affanno futurista di accelerazione del progresso e dell’innovazione, ma un ricorsivo concentrarsi su forze di riproduzione i cui strumenti sono l’ascolto, il fallimento,
la narrazione. La consistenza della scelta curatoriale è, anche, la miglior risposta alla moltitudine delle critiche troppo spesso banalizzanti e miopi che sono venute, e mi pare si possa sintetizzare in questo modo: l’architettura è una pratica di pensiero e costruire non è la miglior risposta per confrontarsi con il presente. Per evidenziarlo, il catalogo raccoglie posizioni e brevi saggi di voci di politici, filosofi, scrittrici, fondatori e fondatrici di istituzioni di svolta, sociologi e reporter: sono, ad esempio, quelle di Michail Bachtin, Thomas Sankara o Barack Obama. Ma anche quelle di Tosin Oshinowo, Mpho Matsipa o Bianca Manu, voci poco conosciute nel dibattito italiano ma che hanno grande rilievo sul piano internazionale.
L’altro movimento che il catalogo suggerisce è quello a perdersi. Uno smarrimento necessario, che è già – esso stesso – un laboratorio: si tratta di non procedere affatto in senso consecutivo, raggranellando un repertorio delle case del futuro, standardizzato bazar di soluzioni fai da te da portarsi a casa in scatole piatte. Il catalogo e la Biennale, anche quando offrono lo sguardo di architetti famosissimi che hanno costruito un po’ ovunque nel mondo, preferiscono concentrarsi su quali idee sottendano le architetture, piuttosto che sulle soluzioni che offrono. L’invito a perdersi ha, piuttosto, una logica ricorsiva e tentativa: se è vero che le notti del mondo sono tante e dense ( habet mundus iste noctas suas, et non paucas, si direbbe), quel che serve non è correre verso il giorno, ma scavare nella notte, rovesciando l’urgenza del trovare una efficace soluzione nel pensare invece a come abitare in modo radicale il problema, scoprendo le possibilità del darsi del tempo di fare degli errori: fail, fail again, fail better

Nell’analisi dell’impostazione e della realizzazione della Biennale Architettura di Lesley Lokko molti hanno riconosciuto, pur all’interno dell’infinito dibattito tra teoria e prassi della disciplina, il valore della visione della curatrice attraverso la visibilità data al continente africano e alle motivazioni di questa scelta. Grazie all’impegno di Lesley Lokko, l’intenzione di catturare l’attenzione di un pubblico multidisciplinare è stata considerata da molti riuscita e la ricerca della completezza della visione dell’architettura può essere ritenuta fonte di ispirazione in grado di influenzare le pratiche dell’architettura più di quanto si possa intuire ad una prima analisi. Sta, dunque, agli architetti, e non solo, raccogliere la sfida e svolgere il ruolo di “agenti del (necessario) cambiamento”.
“Noi” e la storia della nostra cultura
A partire dalla considerazione che la cultura sia la somma delle storie che raccontiamo a noi stessi e di noi stessi, la Biennale 2023 è soprattutto una storia, una narrazione che si sviluppa nello spazio, purché avvenga il riconoscimento di chi sia il “noi” in questione.
della narrazione architettonica
Lesley Lokko parte da un assunto tutt’altro che scontato e che forse meriterebbe maggiore riflessione da parte di tutti: in architettura in particolare è stata storicamente dominante una voce singolare ed esclusiva, la cui portata e il cui potere ignorano enormi fasce di umanità – finanziariamente, creativamente, concettualmente –, come se avessimo ascoltato e parlato in una sola lingua determinando l’incompletezza della storia dell’architettura. Quest’aspetto non può essere trascurato in ogni valutazione sulla sua Mostra, come nemmeno il rispetto dell’intenzione di ampliare, cambiare o raccontare una nuova storia, il cui impatto si fa sentire ben oltre le mura fisiche e gli spazi che la ospitano.
È la denuncia orgogliosa di un punto di vista ben rappresentato dall’assegnazione del Leone d’Oro alla Carriera a Demas Nwoko, nigeriano, schierato nel criticare la dipendenza della Nigeria in merito all’importazione di materiali e beni dall’Occidente oltre che di idee, e impegnato nell’utilizzo di risorse locali.
Da Nkowo partirono parole semplici e inconfutabili sulla gestione ragionevole delle risorse naturali da cui anche il mondo occidentale avrebbe potuto imparare, intento invece a usare troppa energia rispetto ai risultati ottenuti.
Anche il Leone d’Oro assegnato al Padiglione del Brasile come migliore Partecipazione Nazionale è coerente con le intenzioni di Lesley Lokko nell’evidenziare una Mostra di ricerca e un intervento architettonico che centrano le filosofie e gli immaginari della popolazione indigena e nera verso modi di riparazione.
The Laboratory of the Future è il titolo della Mostra, da molti criticato come semplicistico e ritenuto non totalmente rispondente ai contenuti dell’Esposizione Internazionale di Architettura. La Mostra è un insieme di parti e alcune sezioni, dai titoli più azzeccati ma ugualmente in linea con il principale, quali in particolare Dangerous Liaisons e Force Majeure, inducono a intense riflessioni, saggi se non proprio dichiarazioni d’intenti sull’architettura nella sua accezione più estesa.
In questo senso il lavoro di DAAR (Arsenale) – è sembrato emblematico nella narrazione della Mostra. Alessandro Petti e Sandi Hilal sono stati premiati per il loro impegno di lunga data teso a un profondo coinvolgimento politico con pratiche architettoniche e di apprendimento della decolonizzazione e decarbonizzazione in Palestina e in Europa.

La novità della narrazione si esprime anche attraverso messaggi che catturano l’attenzione nell’allestimento. Come quello di Mass Design Group (Christian Benimana, Rwanda, 1982), uno dei partecipanti alla sezione Force Majeure nel Padiglione Centrale ai Giardini, che afferma: «L’idea che l’architetto sia l’unico autore del processo di creazione architettonica non è più valida». Con la sua Afritect, “ridefinizione” ampliata della parola “architetto”, Benimana presenta una nuova generazione di architetti africani che operano in base a soluzioni e idee che sono genuinamente africane e allo stesso tempo di ispirazione globale.
Le installazioni della Mostra sono attraversate con più o meno potenza dai temi complessi e spesso dolorosi della decolonizzazione e della decarbonizzazione, proposti attraverso tecniche di rappresentazione materiali e olfattive, riutilizzando e adattando la struttura
cambiamento Lesley Lokko, l’architettura oltre l’architetturaRhael ‘LionHeart’ Cape, The Laboratory of the Future, Arsenale Photo Marco Zorzanello - Courtesy La Biennale di Venezia
ereditata dalla Biennale Arte di Cecilia Alemani, principio sposato appieno, per esempio, anche dal Padiglione della Germania.
Degna di nota la scelta di Lesley Lokko di puntare i riflettori «sull’Africa e sulla diaspora africana, quella cultura fluida e ingarbugliata di persone di origine africana che oggi attraversa il globo».
«[…] Perché il passato, per loro (i popoli un tempo assoggettati dall’Occidente), era la giungla del capitalismo occidentale, non la luce che i missionari pensavano di aver portato con sé», sottolinea lo scritto di Nadine Gordimer che accoglie i visitatori nel Padiglione Centrale ai Giardini. E ancora, Lokko porta in Mostra, ad esempio, le proposte del designer nigeriano Chidirim Nwaubani (Arsenale), una rivoluzionaria operazione di “rimpatrio digitale” di opere d’arte africane trafugate, custodite in prestigiose istituzioni situate principalmente nel Nord del mondo. Per la generazione più giovane di studenti, artisti, architetti e creativi africani di oggi l’accesso alla produzione culturale ancestrale è limitato. Non potendo viaggiare e visitare queste istituzioni diventa sempre più difficile essere in contatto con la legittima eredità. La piattaforma di Nwaubani, Looty, le registra digitalmente e le mette a disposizione sulla blockchain come NFT, offrendo una soluzione inaspettata alle dispute sulla restituzione di opere d’arte africana.
Il Grande sforzo della storia umana: catturare il carbonio
Con il cortometraggio The Great Endeavor ( Il grande sforzo ) di Liam Young (Arsenale) la narrazione di Lokko si completa di un utopico ottimismo: l’impresa di rimuovere dall’atmosfera l’anidride carbonica e di immagazzinarla sottoterra è a portata di mano. “Il grande sforzo” per catturare tutto questo carbonio comporterà la costruzione del più grande progetto ingegneristico della storia umana e lo sviluppo di una nuova infrastruttura equivalente per dimensioni a quella dell’intera industria globale dei combustibili fossili.
Paolo LucchettaPer la settima volta consecutiva il Victoria&Albert Museum di Londra è presente alla Biennale con un progetto speciale che quest’anno si concentra sull’influenza che il Modernismo tropicale ebbe sui paesi dell’Africa occidentale. Un’installazione cinematografica multicanale riflette criticamente sulla storia imperiale del Modernismo tropicale, un distintivo stile architettonico inizialmente sviluppato e impiegato come strumento per sostenere il dominio coloniale, poi adattato localmente all’indomani dell’indipendenza del Ghana – il primo paese dell’Africa sub-sahariana ad affrancarsi dal dominio coloniale nel 1957. La mostra si concentra in particolare sulle figure di Maxwell Fry e Jane Drew, due architetti inglesi che dopo la Seconda guerra mondiale lavorarono in Paesi quali Gambia, Sierra Leone, Nigeria, Ghana. In particolare, Maxwell Fry, che ebbe l’occasione di lavorare con Walter Gropius durante una breve visita di quest’ultimo a Londra, riuscì a perfezionare lo stile internazionale appreso dall’architetto e urbanista tedesco adattandolo alle condizioni calde e umide del clima tropicale. La mostra offre un quadro del contesto politico dell’epoca, un momento di grandi spinte anticoloniali: boicottaggi, rivolte e scioperi si stavano moltiplicando ovunque in Africa occidentale. Nelle parole del curatore Christopher Turner, direttore del Dipartimento d’arte, architettura, fotografia e design del V&A, «molti degli edifici disegnati da Fry e Drew furono costruiti proprio in seguito ad alcuni degli avvenimenti più cruenti in atto allora nel Paese. Il Community Centre di Accra, ad esempio, venne eretto dopo che il quartiere generale della United Africa Company era andato distrutto dal fuoco durante una rivolta particolarmente violenta». Il Modernismo tropicale resistette a questa transizione, agendo come simbolo della nuova Nazione africana, internazionale e progressista che stava per irrompere sul proscenio mondiale. L’opera di diffusione attuata da Maxwell Fry, Jane Drew e un gruppo di altri architetti modernisti, fra cui James Cubitt e Kenneth Scott, rappresentò dunque solo la prima fase dell’influenza che il Modernismo tropicale ebbe nei paesi dell’Africa occidentale. Da lì in poi il nuovo stile architettonico si radicò e venne assorbito entusiasticamente nel lavoro progettuale degli architetti ghanesi, lasciando un’eredità che prosegue tutt’oggi. Marisa Santin


Tropical Modernism: Architecture and Power in West Africa
Padiglione delle Arti Applicate A rsenale, Sale d’Armi
LEONI 2023
a cura di Marisa Santin

Alessandro
Petti and Sandi Hilal«Per il loro impegno di lunga data teso a un profondo coinvolgimento politico con pratiche architettoniche e di apprendimento della decolonizzazione in Palestina e in Europa».
ENG For their long-standing commitment to deep political engagement with architectural and learning practices of decolonization in Palestine and Europe.
Il Collettivo con base a Stoccolma e a Betlemme si occupa della decolonizzazione dell’architettura con una pratica impegnata socialmente a cavallo tra arte, spazio, ricerca, lavorando essenzialmente sul terreno della giustizia sociale. Progetti come l’Ente di Decolonizzazione di Borgo Rizza (Siracusa), la Concrete Tent, la Tree School, Campus in Campus definiscono immaginari, forme di apprendimento, spazi critici di riflessione e scambio sulla pratica concreta della democrazia, della condivisione esistenziale, sociale in luoghi di frizione, aprendo strade di ripensamento su temi nodali del vivere in uno spazio urbano comune quale quelli della mobilità, dell’identità, del bene comune e dell’eredità della condizione di rifugiati.
ENG A collective based in Stockholm and Bethlehem, Palestine that works on decolonization of architecture with a socially engaged practice combining art, space and research, DAAR focuses mainly on social justice. Projects like the Decolonization Institution of Borgo Rizza (Siracusa, Italy), the Concrete Tent, the Tree School, and Campus in Campus define images, educational philosophies and spaces for reflection and exchange on the material practice of democracy and on existential and social sharing in inhabited friction points, promoting a re-thinking of crucial themes of inhabiting shared urban spaces such as those related to mobility, identity, and the legacy of the status of refugee.
Arsenale,
Corderie«Per una installazione multimediale che esplora una pratica di costruzione del mondo capace di allargare le prospettive e l’immaginazione del pubblico, offrendo visioni di un futuro decolonizzato e decarbonizzato».

ENG For a multimedia installation that explores a worldbuilding practice that expands public perspectives and imaginations, offering visions of a decolonized and decarbonized future.
Ripensare al rapporto tra architettura, contesto e comunità ha portato Olalekan Jeyifous (Ibadan, Nigeria, 1977; vive e lavora a Brooklyn) ad approfondire il ruolo che lo spazio gioca nella costruzione di uguaglianza all’interno delle comunità afroamericane e della diaspora africana. Al loro interno, infatti, la percezione del mondo secondo Jeyifous è essenzialmente futurista, considerata l’innata loro capacità di reinvenzione nella costante lotta per creare un nuovo rifugio dal nulla. L’artista rappresenta la propria visione attraverso una grande varietà di tecniche quali la modellazione 3D, il fotomontaggio, la scultura o le grandi installazioni, in cui sono frequenti i richiami alla tecnologia e all’estetica sci-fi.
ENG Re-thinking the relationship between architecture, context, and community led Olalekan Jeyifous to investigate the role that space plays in the building of equality in African-American communities and those of the African diaspora. The perception of the world within them is, according to Jeyifous, essentially futuristic, considering their innate ability to reinvent themselves in their constant struggle to build shelters out of nothing. The artist represents his vision through a wide range of techniques including 3D modelling, photo montage, sculptures, or large-scale installations that evoke hi-tech or sci-fi aesthetics.
Giardini, Padiglione Centrale Photo Andrea AvezzùCourtesy La Biennale di Venezia«Per un’installazione in tre parti che interroga il passato, il presente e il futuro della Repubblica Democratica del Congo, attraverso uno scavo di archivi architettonici coloniali».

ENG For a three parts installation that interrogates the past, present, and future of the Democratic Republic of Congo, through an excavation of colonial architectural archives.
Fondato nel 2017 da Rosa Spaliviero e Sammy Baloji, lo studio con sede a Bruxelles lavora sul terreno dello scambio tra le arti visive e multimediali e in particolar modo sul campo della produzione di film e documentari, attività quest’ultima sviluppata grazie all’impegno diretto di Sammy Baloji (Lubumbashi, Congo, 1978), capace altresì di promuovere progetti di coproduzione a cura di giovani filmmaker della diaspora africana. È soprattutto sul Congo, in particolare per quel che riguarda più nello specifico l’attività di Baloji, che si concentrano maggiormente questi lavori. Partendo dalla ricerca sul patrimonio culturale, architettonico e industriale di questo grande Paese si esplorano i modi attraverso cui le pratiche coloniali possano plasmare, trasformare, deformare e reinventare le identità, incluse quelle contemporanee.

ENG Founded in 2017 by Rosa Spaliviero and Sammy Baloji, the studio works in the terrain between visual and multimedia art, in particular on film and documentary production. Thanks especially to the work of Sammy Baloji, their work focuses especially on the Congo. Starting with research into the cultural, architectural, and industrial heritage of Congo, they explore the ways colonial practices may have shaped, transformed, deformed, and reinvented identities – including modern ones.
Arsenale, Corderie
«Per un’installazione che riflette una pratica progettuale collaborativa e multimodale, nonché un approccio articolato e immaginativo alle risorse, alla ricerca e alla rappresentazione».
ENG For an installation that reflects a collaborative and multimodal design practice as well as a nuanced and imaginative approach to resources, research, and representation.
Il design, la ricerca e l’attivismo sono gli strumenti che permettono allo studio Wolff (Cape Town, Sudafrica) di approcciare il passato in una chiave il cui fine ultimo è quello di intervenire in modo riparativo nel presente, attraverso quella che viene definita una “architettura di conseguenza”. Questo approccio, basato sullo sviluppo di una pratica spaziale inclusiva e non egemonica, si ispira ad atteggiamenti quali la giustizia riparativa e la ricerca integrata, accompagnate da un’estetica accattivante. In questo modo lo studio si propone di creare un’architettura che tenga ben presente il peso delle conseguenze prodotte dalle decisioni passate al fine di creare spazi inclusivi ed equi. ENG D esign, research, and activism are the tools that enable Wolff to approach the past in a way that will help to heal the present, using what is called ‘consequential architecture’. This approach, based on the development of inclusive, non-hegemonic spatial practice, takes inspiration from reparative justice and integrated research, accompanied by an intriguing aesthetic. In this way, Wolff Architects create architecture that is fully aware of the weight and consequences of past decisions with an end goal of creating equitable, inclusive spaces.
Arsenale, Corderie

«Per una pratica di ricerca militante che materializza storie di spazi di lotte per la terra, estrazione e liberazione attraverso il mezzo della grafite e della scrittura speculativa come strumenti di progettazione».
ENG For a militant research practice that materializes spatial histories of land struggles, extraction, and liberation through the medium of graphite and speculative writing as design tools.
Il programma Race, Space & Architecture è solo uno dei polisemici e articolati progetti di Thandi Loewenson (Harare, Zimbabwe, 1989; lavora a Londra), artista, progettista e ricercatrice che lavora con la transmedialità per catalizzare la cultura dell’emancipazione e dare voce ad “altrimenti possibili”, riflettendo in particolare sui territori dell’Africa del sud. Lo spazio è una delle sue principali chiavi di lettura: talvolta lente di osservazione delle dinamiche di disuguaglianza e segregazione razziale, talaltra (come in BREAK//LINE ) soglia da indagare per scoprire le materializzazioni del capitale o le frontiere dell’oppressione. Una pratica all’intersezione tra design, performance, grafica, produzione musicale e video.
ENG The Race, Space & Architecture programme is only one of the polysemic projects of Thandi Loewenson, artist, designer, and researcher who works to catalyze emancipation culture and to give voice to the ‘possible otherwise’ focusing in particular on southern African territories. Space is one of the many keys to understanding her work: at times a magnifier of inequality and racial segregation dynamics, at others (as in BREAK//LINE ) a threshold to investigate to discover the materialization of capital or the borders of oppression. A practice at the intersection of design, performance, graphic art and music and video production.
Giardini, Padiglione Centralelo Spazio oltre la Soglia the Space beyond the Threshold
18 maggio - 26 novembre 2023
Mostra a cura di | Exhibition curated by AMDL CIRCLE e Michele De Lucchi
Esposizione dei 10 progetti finalisti del Concorso Internazionale per l’Architettura d’Ingresso DoorScape Exhibition of the 10 finalist projects of the Entrance Architecture International Contest DoorScape


Il richiamo ctonio è certamente un tratto comune di questa Biennale, così intrisa di quella ancestrale cultura femminile per cui non è il Cielo, ma la Terra, a raccogliere il tutto, quale viscerale Madre del tempo, dell’umano e del non-umano, caverna sorgiva che genera e inghiotte. Secondo avvicendamenti più circolari che lineari, contando più sulle forze di riproduzione collettiva che su quelle della affermazione individuale, la terra è quel che calpestiamo, il suolo che fa crescere e sostiene, ma è anche il deposito delle forme di convivenza, ed è il Pianeta nella sua interezza.
È tutto questo (almeno) il centro della riflessione del padiglione del Brasile, curato da Paulo Tavares, architetto e ricercatore che da anni lavora sui diritti del non-umano esplorando le lezioni che si possono imparare dalla foresta amazzonica, e da Gabriela de Matos, architetta afro-brasiliana da sempre impegnata su un progetto che sia capace di occuparsi della differenza di genere, e dell’architettura prodotta da donne della diaspora africana in Brasile (Arquitetas Negras).
Il Padiglione che ha vinto il Leone d’Oro, «una mostra di ricerca e un intervento architettonico che centrano le filosofie e gli immaginari della popolazione indigena e nera verso modi di riparazione» (così il giudizio della Giuria), ha due parti e un numero molto ampio di autori. Nella prima si tenta, attraverso una ricerca fine e fondata, di mostrare come Brasilia, la immaginifica “città di nuova fondazione” di Lucio Costa, non sia stata costruita sul nulla ma su una Terra da sempre abitata. Nella luminosa e polverosa seconda parte, ricoperta di terre, si alternano invece esperienze ancestrali di pratiche dell’abitare di comunità indigene (anch’esse autori del Padiglione), elementi architettonici, temporalità non lineari: un modo non tanto per progettare il domani ma per destrutturare il nostro modo di pensare il tempo oggi.
Il Leone d’Oro va al Brasile per la chiarezza e la forza attraverso cui, nel Padiglione, questa terra amazzonica diventa la Terra di tutti. Ma dentro al premio, inevitabilmente, c’è anche la straordinaria ricerca che Tavares e de Matos hanno costruito con umiltà e passione in tanti anni. Come il fondamentale lavoro sui Diritti della Foresta, cui Tavares aveva lavorato insieme alla bravissima Ursula Biemann (peraltro anche lei è presente nella mostra principale, con un lavoro su alcune comunità indigene), e poi tradotta e pubblicata in molti paesi. O, ancora come il suo contributo alla mostra principale, “autonoma”, che racconta come questo patrimonio unico al mondo che è la foresta amazzonica sia in realtà probabilmente un giardino, frutto dell’interazione consapevole tra umano e non umano. Questo Padiglione e questo premio sono ricchissimi di stimoli: anzitutto, emerge una architettura come ricerca, più radicale di una città e più necessaria di un edificio. In secondo luogo, l’urgenza di prendersi cura dell’essenziale, che è tanto materiale – la Terra – quanto connesso alla memoria, una memoria che non si occupa dei ricordi ma delle tracce segnate sulla nostra stessa Cultura. In ultimo, il padiglione del Brasile straborda dall’architettura per fare un invito trasversale: tornare a pensare il pre-moderno, a cosa fosse il Pianeta prima della colonizzazione, prima della carbonizzazione. Nella necessità di ripensarci, tornare alla Terra non è la nostalgia del passato, piuttosto l’attualizzazione di un altro, sempre possibile, futuro. Michele Cerruti But
«Per la strategia curatoriale e le proposte progettuali che celebrano la potenza dei rituali quotidiani come forme di resistenza e come pratiche spaziali nelle comunità della diaspora.»
Negli intenti dei curatori, la rappresentazione di azioni quali la coltivazione, la preparazione del cibo, il gioco e la danza, svolte quotidianamente da gruppi sociali di disparate provenienze geografiche, ha come finalità quella di creare specifici spazi di condivisione che diventano al contempo stimoli per immaginare nuovi approcci alla pratica architettonica e all’ambiente costruito, promuovendo uno scenario più sostenibile basato su principi di cura ed equità piuttosto che di sfruttamento. Attraverso una serie di installazioni, un gruppo di artisti e architetti con sede nel Regno Unito ha trasformato il Padiglione cercando di immaginare un futuro in cui le pratiche sociali vengano celebrate per saldare legami tra comunità.


Ispirato dal monito “mangiando digeriamo territori”, il Padiglione spagnolo alla 18. Biennale Architettura presenta un focus sulle architetture che nutrono il mondo, dalle nostre cucine casalinghe alle grandi aree funzionali che alimentano le città. Il progetto, curato da Eduardo Castillo-Vinuesa e Manuel Ocaña, esplora in particolare il contesto agro-architettonico spagnolo, allargando l’indagine al passato e al presente dei sistemi alimentari globali per immaginare un futuro in cui il sostentamento dell’Uomo non vada a discapito del Pianeta. La ricerca si concretizza attraverso una piattaforma di ricerca collettiva che rimarrà attiva da luglio fino alla chiusura della Biennale, cinque mesi durante i quali un collettivo di ricercatori sarà alla guida di iniziative dinamiche volte a proporre soluzioni innovative. Il programma si avvale del sostegno della European Climate Foundation (ECF) ed è stato ideato in collaborazione con diverse importanti università spagnole (ETSAM-UPM, EAT-UCLM, ETSAB-UPC) e con Università Ca’ Foscari e IUAV di Venezia. La collaborazione si estende anche a TBA21, la fondazione per la promozione dell’arte contemporanea creata nel 2002 dalla filantropa e collezionista Francesca Thyssen-Bornemisza, una realtà che da anni ha ampliato la propria rete di attività anche a Venezia presso la sede di Ocean Space. Ogni settimana esperti di diverse discipline – scienziati, storici ambientali, policymaker, artisti, architetti, chef, coltivatori – si uniranno all’unità di ricerca per formare un laboratorio pubblico di idee, un luogo dove confrontare conoscenze ed esperienze al fine di analizzare le intricate connessioni che plasmano il nostro modo di mangiare. Il programma si sviluppa attorno a conferenze, discussioni, workshop, escursioni a Venezia e nelle regioni circostanti del nord Italia e visite a laboratori, giardini, istituzioni e altri luoghi pubblici. Fra i nomi attesi vi sono Marina Otero Verzier, figura di spicco nel campo della progettazione urbana; Marta de Marchi, ricercatrice impegnata nell’esplorare le connessioni tra cibo, cultura e società; Manijeh Verghese, architetta attenta alle pratiche sostenibili; Elena Longhin, urbanista del paesaggio; Roberta Raffaetà, ricercatrice nel campo dell’antropologia socio-culturale; Barenas Collective, gruppo di artisti e designer attenti alle relazioni tra arte, cibo e ambiente; Nomeda e Gediminas Urbonas, attivi in interventi di collaborazione tra professionalità differenti sul territorio lagunare; Jan Boelen, curatore e designer noto per il suo impegno nel promuovere la partecipazione del pubblico e l’innovazione sociale; Laura Tripaldi, esperta in scienza e nanotecnologia dei materiali; Territorial Agency, studio di progettazione che esplora le interazioni tra territorio, ambiente e società. Il programma culminerà nella creazione del Future Foodscapes Compendium, una piattaforma web che ospiterà una raccolta di strumenti, risorse operative e casi studio di realtà che offrono proposte per un sistema alimentare futuro più equo e resiliente. Man mano che il programma giunge alla conclusione, i casi studio più promettenti passeranno alla fase di implementazione, dove saranno prototipati in collaborazione con istituzioni e stakeholder di supporto. Infine, in autunno, presso Ocean Space e in altri spazi a Venezia le università spagnole partecipanti cureranno ciascuna un evento della durata di una settimana in collaborazione con TBA21, fra cui un simposio sperimentale organizzato da ETSAM-UPM con New European Bauhaus. Marisa Santin
The Spanish Pavilion at the Biennale 2023 showcases the architectures that sustain our global food systems – from humble home kitchens to the vast operational landscapes that feed our cities. The project delves into Spain’s agro-architectural context, expanding its focus on the historical and contemporary aspects of the global food supply chain. Through a collective research platform, this exploration will come to life, remaining active until the conclusion of the Biennale. Each week, experts from diverse disciplines – scientists, environmental historians, policymakers, artists, architects, chefs, and farmers – will join the research unit, transforming it into a vibrant public laboratory of ideas. The program unfolds with a rich array of lectures, discussions, workshops, excursions in and around Venice, and visits to laboratories, gardens, and institutions. Ultimately, the program reaches its pinnacle with the creation of the Future Foodscapes Compendium, a web platform hosting a comprehensive collection of tools, operational resources, and case studies that propose more equitable and resilient food systems. Furthermore, in autumn, the participating Spanish universities will each curate a week-long event in collaboration with TBA21, taking place at Ocean Space and other locations in Venice.
Foodscapes Giardini foodscapes.es

Ai nove siti rappresentativi di condizioni di fragilità o trasformazione del nostro Paese – raccontati da altrettanti gruppi di architetti under 40 attivi in Italia e all’estero – Fosbury Architecture sta affiancando un programma di attività che permette al progetto ideato per la Biennale Architettura 2023 di uscire dal perimetro fisico del Padiglione Italia. Il calendario di Fosbury si è dilatato lungo la Penisola, raggiungendo i luoghi interessati da Spaziale. Ognuno appartiene a tutti gli altri con eventi radicati nella realtà del territorio, come la performance su un tetto della città vecchia di Taranto, fulcro di una rassegna nata dall’idea del collettivo Post Disaster di creare un ponte tra design, arte contemporanea e comunità locale. O come SirenLand, un progetto di Terraforma Festival con BB (Alessandro Bava e Fabrizio Ballabio) che ha trasformato la Baia di Ieranto in Campania in un teatro archeoacustico, alla ricerca di suoni incontaminati di epoche passate. A Venezia Fosbury ha attivato Mondo Novo, un public program in collaborazione con Palazzo Grassi – Punta della Dogana, Pinault Collection, con il sostegno di Bottega Veneta. Dopo i primi due appuntamenti di maggio e giugno – Paradigms, una discussione sulle possibilità di un’architettura alternativa, che ha visto confrontarsi, fra gli altri, Markus Bader, Scott Lloyd e Anna Puigjaner, e Buildings, un dialogo fra Bianca Felicori e Ghali attorno alle interazioni tra cultura musicale italiana e i temi dell’architettura – il programma al Teatrino di Palazzo Grassi riprenderà con altri tre appuntamenti il 22 settembre ( Ecologies ), il 20 ottobre ( Economies ) e il 24 novembre ( Masters ).
Marisa SantinENG Fosbury’s project for the Architecture Biennale is extending beyond the physical perimeter of the Italian Pavilion with a rich calendar of events expanding throughout the peninsula, reaching the locations involved in Spaziale. In Venice, Fosbury started Mondo Novo, a public program in collaboration with Pinault Collection, with the support of Bottega Veneta. After Paradigms, a discussion on the possibilities of alternative architecture featuring Markus Bader, Scott Lloyd, Anna Puigjaner, among others, and Buildings, a dialogue between Bianca Felicori and Ghali exploring the interactions between Italian music culture and architectural themes, the program at Teatrino Grassi will continue with three more events on September 22nd (Ecologies), October 20th (Economies), and November 24th (Masters).
Dopo più di quattrocento giorni di guerra come è possibile trovare un nuovo sistema di coordinate che permetta alla bellezza di manifestarsi? Sviluppato in due aree, il progetto ucraino guarda al domani. Il Padiglione all’Arsenale presenta uno spazio claustrofobico e buio come simbolo di un luogo abbandonato che diventa vitale per progettare piani di sopravvivenza. L’installazione presso lo Spazio Esedra ai Giardini, costituita da cumuli di terra ricoperti d’erba al cui centro si delinea uno spazio percorribile, riproduce il sistema di fortificazioni di Kiev del X secolo, riattivate in seguito all’aggressione russa. Di fronte ad un presente di distruzione il Paese si chiede se e come sia possibile salvaguardare una visione di speranza trovando già oggi un posto sicuro in cui liberare una pulsione creativa rivolta alla ricostruzione. Il ruolo fondamentale svolto dalla narrazione nel delineare i confini di uno spazio protetto è perciò al centro del progetto. Ovunque ci sia una storia da raccontare, occorre che ci sia sempre qualcosa o qualcuno che permetta a quella voce di essere ascoltata in modo relativamente sicuro. Persino in situazioni di coesistenza con la costante minaccia ci si può riunire sotto un tetto di un edificio semidistrutto o dietro un bastione improvvisato per discutere le questioni più urgenti, fra cui i limiti ma anche le possibilità per gli architetti di immaginare il futuro. M.S.
ENG A fter more than four hundred days of war, how is it possible to find a new system of coordinates that allows beauty to manifest itself? Developed in two areas, the Ukrainian project looks towards the future. The Pavilion at the Arsenale presents a claustrophobic and dark space as a symbol of an abandoned place that becomes vital for designing survival plans. The installation at the Esedra Space in the Giardini consists of mounds of earth covered in grass, with passable paths outlined at its center, reproducing the fortification system of 10th-century Kiev, reactivated following the Russian aggression. Faced with a present of destruction, the country wonders if and how it is possible to safeguard a vision of hope by already finding a safe place today to unleash a creative impulse aimed at reconstruction.

Narrazioni da un paese in guerra© Mondo Novo - Buildings
Una vaschetta di funghi trifolati per LisboScopio (Padiglione portoghese, 2006), un sacchetto di chips al formaggio per Hotel Polonia (Padiglione polacco, 2008), una busta di salviettine umidificate per The Problem of Space Travel (Padiglione sloveno, 2014), una bottiglia di birra per Freeingspace (Padiglione macedone, 2018)… La Lettonia celebra la sua decima partecipazione alla Biennale Architettura con l’inaugurazione di un “supermercato delle idee”, uno spazio democratico dove prodotti di varie origini si incontrano sugli stessi scaffali. Anche il sito del progetto è strutturato come un vero e-commerce, con tanto di carrello per gli acquisti e catalogo recapitabile direttamente a casa o scaricabile digitalmente. I nomi, gli ingredienti e i dati di provenienza che distinguono i 506 prodotti attingono ai contenuti delle ultime dieci edizioni della Biennale Architettura, dalla prima partecipazione della Lettonia a NEXT (2002) fino a How will we live together? (2021), al fine di mettere in risalto le connessioni tra La Biennale (‘il supermercato’) e i padiglioni nazionali (‘i prodotti’). Scegliere fra diversi prodotti comporta una riflessione basata su convinzioni individuali e sociali ed è per questo che quello che conta non sono i prodotti ma il processo decisionale. Spazio immersivo in cui tutte le istanze convergono e trovano posto, T/C Latvija (TCL) si pone come un innovativo laboratorio del futuro in cui è possibile partecipare, interagire e prendere posizione sul domani dell’architettura. M.S.
ENG A t ray of sautéed mushrooms for LisboScopio (Portuguese Pavilion, 2006), a packet of wet wipes for The Problem of Space Travel (Slovenian Pavilion, 2014), a bottle of beer for Freeingspace (Macedonian Pavilion, 2018)... Latvia celebrates its tenth participation in the Architecture Biennale with the inauguration of a “supermarket of ideas,” a democratic space where products from various origins come together on the same shelves. The names, ingredients, and origin data that distinguish the 506 products draw from the contents of the last ten editions of the Architecture Biennale, from Latvia’s first participation in NEXT (2002) to How will we live together? (2021), in order to highlight the connections between La Biennale (the “supermarket”) and the national pavilions (the “products”). What matters is not the products themselves but the decision-making process.


Partendo dall’inventario delle specie endemiche e autoctone custodito nella banca dei semi nella città di Vicuña, il progetto cileno propone di guardare al futuro in un’ottica di ‘riparazione ecologica’ dei danni inferti alla natura dall’uomo. L’impianto espositivo è costituito da 250 sfere piene di semi che raccontano storie di speranza e di cura. Si tratta di semenze che possono colonizzare suoli altamente degradati, ripristinare lo stato di terreni contaminati, migliorare la qualità l’aria nelle città, ripristinare ecosistemi dopo catastrofi naturali, ricostruire paesaggi devastati da incendi. Questi semi entrano a far parte di progetti architettonici per affrontare le principali sfide architettoniche e urbane attuali, in un’ottica non più di progresso e produzione, ma di protezione e ripristino ecologico. Il progetto è strutturato sulla base di tre diversi campi di attenzione: il Campo delle contingenze, dove l’architettura, in collaborazione con altre specie, dà forma a nuove relazioni di interdipendenza; il Campo delle esperienze, che impone di archiviare, raccogliere e custodire il semi; e infine il Campo delle situazioni, in cui il futuro, in termini di possibilità di immaginare architetture e città in grado di sostenere sia la vita umana che quella non umana, emerge dalla condizione stanziale per trasformarsi in ecologia in movimento. Il futuro, ci stanno dicendo gli architetti cileni, va non solo progettato e costruito ma anche seminato, coltivato e protetto nella speranza di rimediare agli errori fatti. M.S.
ENG T he Chilean project worked on the endemic species stored in the seed vault in Vicuña to look at the future from the point of view of ‘ecological remedy’ of the damage man did to nature. The exhibition is presented through a collection of 250 seed-full spheres, mostly with low or no germination capacity – that tell stories of hope and care. These seeds will be used by Chilean architects to face the main urban challenges of the future. In particular, they are using species that can colonize highly degraded damaged soils and restore ecosystems that have been damaged by natural disasters as well as landscapes devastated by anthropogenic fires.
La creatività segue la capacità, pertanto la padronanza delle abilità è la priorità per i giovani talenti. Questo il pensiero al centro dello European Prize for Contemporary Architecture – EUmies Awards, un premio annuale che la Fondazione Mies van der Rohe, con il sostegno del programma di supporto alla creatività dell’Unione Europea, ha istituito per valorizzare le professioni dell’architettura. La categoria Young Talent, in particolare, ha l’obiettivo di sostenere il talento di architetti, urbanisti ed esperti paesaggisti neolaureati, che saranno responsabili della trasformazione dell’ambiente nel prossimo futuro. Il progetto della Fondazione, The Laboratory of Education, Evento Collaterale ufficiale della Biennale Architettura 2023, prevede un fitto calendario di eventi di disseminazione con l’intento di mantenere viva e dinamica l’attenzione sul divenire del fare architettura. La programmazione ha visto il suo momento cruciale il 29 giugno scorso con la cerimonia di premiazione dei giovani vincitori, fra cui Dinko Jelecevic (Graz University of Technology) per Valter, una proposta architettonica che attiva le preesistenze di un luogo, in contrapposizione all’oblio; Laura Hurley (University College Cork & Munster Technological University) per Peripheral Cartographies, un metodo di riconoscimento di un territorio e della sua identità attuato attraverso la localizzazione cartografica di manufatti incompiuti; María de la O Molina Pérez-Tomé per Eden Archipelago, una proposta di spazio urbano per la conservazione e la crescita delle specie vegetali autosufficienti e autorigeneranti. I loro lavori insieme a quelli degli altri candidati al Premio sono esposti presso gli spazi di Palazzo Mora, nell’ambito della mostra Time Space Existence di European Cultural Centre. Marisa Santin

ENG “Creativity follows mastery, so mastery of skills is the first priority for young talent.” This is the central idea behind the European Prize for Contemporary Architecture - EUmies Awards, an annual prize established by the Mies van der Rohe Foundation with the support of the European Union’s creativity support program, aimed at promoting the architectural professions. The Young Talent category, in particular, aims to support recent graduates in architecture, urban planning, and landscape design, who will be responsible for shaping the environment in the near future. The Foundation’s project includes a packed schedule of events, culminating in the award ceremony for the young winners. Their works, along with those of the other candidates, are showcased at Palazzo Mora alongside the Time Space Existence exhibition by the European Cultural Centre.
Due Eventi Collaterali di Biennale Architettura condividono la collocazione geografica presso i suggestivi Docks dell’Arsenale, oltre a trovarsi accomunati dalla ricerca di un’identità specifica che trascenda il concetto di appartenenza nazionale. In A Fragile Correspondence (Scotland + Venice), le foreste che circondano Loch Ness nelle Highlands, i relitti industriali delle acciaierie di Ravenscraig nelle Lowlands e le rive dell’arcipelago delle Orcadi sono le tappe di un immaginifico viaggio attraverso il paesaggio scozzese. La mostra esplora la possibilità di approcci alternativi alle sfide poste dall’emergenza climatica globale, proponendo un nuovo lessico e nuove modalità di esplorazione creativa dell’ambiente. Con Following the Fish, Catalonia in Venice dà voce a Top Manta, il Sindacato Popolare di Venditori Ambulanti di Barcellona, un movimento fondato da una comunità di senegalesi – ora diventato anche marchio di moda – che difende i diritti dei migranti e denuncia il razzismo delle istituzioni. L’installazione, che assume la forma di un mercato ambulante dove sono esposti i contenuti del viaggio compiuto dai migranti, suscita una riflessione urgente sui rapporti tra Nord e Sud del mondo e sulle conseguenze della diaspora africana. Marisa Santin

ENG T wo collateral events of the Architecture Biennale share the same geographical location at the scenic Docks next to the Venice Arsenal, as well as a common search for a specific identity that goes beyond the concept of national belonging. Through the stages of an imaginative journey through the Scottish landscape, A Fragile Correspondence (Scotland + Venice) explores the possibility of alternative approaches to the challenges posed by the global climate emergency. With Following the Fish by Catalonia in Venice, the spotlight is on Top Manta, a movement founded by a Senegalese community in Barcelona that advocates for the rights of migrants and denounces institutional racism.
Sc otland + Venice / Catalonia in Venice
Fino 26 novembre Docks Cantieri Cucchini, Arsenale w ww.llull.cat | IG: @cataloniainvenice

I premi EUMies agli architetti del futuroScotland + Venice Catalonia in Venice The 2023 EUmies Awards Young Talent winner: Valter from Dinko Jelecevic courtesy Fundació Mies van der Rohe

Intervista Rachele De Stefano di Mariachiara Marzari
Architetti, designer, ricercatori, accademici, creativi, fotografi, provenienti da 52 Paesi e che lavorano in diverse discipline, offrono un dialogo coinvolgente attraverso il quale restituire voci e prospettive differenti ad ampio spettro, focalizzando l’attenzione internazionale sulle questioni fondamentali dell’architettura contemporanea. Time Space Existence, ampia e composita mostra collettiva, è frutto di un lavoro costante e puntuale di un dinamico team di persone che compongono l’European Cultural Centre. Progettare una mostra di architettura non è una sfida facile, perché all’aspetto espositivo puro è necessario associare la parte fattuale, operativa, dove i progetti esposti devono entrare in un circuito di idee, dialogando e confrontandosi tra loro. Time Space Existence, giunta alla sesta edizione, ha conquistato una sua propria, precisa identità espositiva: non mero contenitore, ma contenuto capace di captare le istanze attive del contemporaneo proprio per la sua visione a campo largo.
Sono 217 i progetti internazionali presentati quest’anno nelle tre sedi dell’European Cultural Centre, Palazzo Bembo, Palazzo Mora e Giardini della Marinaressa, che nel loro insieme disegnano una mappa delle proposte più innovative ed espressioni emergenti nell’ambito della sostenibilità nelle sue molteplici forme e declinazioni, dall’attenzione all’ambiente e al paesaggio urbano, con metodi di costruzione e materiali che riducono il consumo energetico, alle proposte in discussione su innovazione, riuso, design circolare, comunità e convivenza, giustizia sociale e inclusione.
Una mostra, anzi tre mostre che diventano luogo di incontro capace di coinvolgere target diversi di pubblico, invitando ogni singolo visitatore ad allargare il proprio sguardo attraverso una lettura inedita e sapiente delle sfide della contemporaneità al fine di restituirne una visione complessa e multiforme, in cui ognuno possa trovare spunti per nuove riflessioni e prospettive.
Rachele De Stefano, responsabile del settore Architettura dell’European Cultural Centre, racconta il lavoro di squadra, le idee, la visione comune, la community costruita negli anni, elementi fondamentali che hanno concorso a costituire una nuova idea espositiva nell’ambito della disciplina architettonica, contribuendo al successo di Time Space Existence.


Architects, designers, researchers, academics, creative professionals, photographers from 52 countries for a large-scope conversation to hear and understand different voices and perspectives, focusing on modern architecture. Time Space Existence is a large, composite collective exhibition produced by the European Cultural Centre. Now at its sixth edition, Time Space Existence acquired an identity all of its own: more than a container, a true vision on modernity. 217 designs draw a map of the most innovative emerging offers of sustainability in all its forms, from attention to the environment to building technology and material with low energy footprint, to innovation, re-use, circular design, community and coexistence, social justice and inclusion. Rachele De Stefano is the manager of the architecture section at the European Cultural Centre. She spoke with us about teamwork, ideas, visions, and communities, which are the essential elements that contribute to shaping new ideas on how architecture may be popularized. This vision is at the core of Time Space Existence’s success.
Since its inception, Time Space Existence has been an open space to international audiences and a space for professionals to put their ideas together. Every two years, it offers a platform for documentation, confrontation, and exchange of ideas. It seemed natural for us to show not only architecture, but also creations by artists and designers. We believe every discipline can offer a different point of view on the world, and this plurality of ideas and perspectives is what we want to show, hopefully as a source of inspiration and reflection.
This is not an exhibit of ready-made solutions. We act as a tool for the sharing of ideas, research, designs developed in different regions by the many people that are looking for a shared solution against global problems. Some designs are experimental, other utopian, others more concrete. No perfect solution exists, and the whole world is a workshop that, day in day out, cranks out ideas, materials, people, animals… and builds a piece of our future. We think what matters is to let the world know what’s going on in architecture today, trying to cover the largest visual horizon. We are open to input from global businesses as well as from architecture studios, students, and universities. All can make a difference.
Since 2012, TSE has been showing more, and more diverse designs. While earlier architects thought and communicated about his work using the shared language of their profession, now they look for different solutions elsewhere, like robotics or digital technology, and discover new ways to communicate. The projects we have been showing at TSE offer visitors virtual experiences, too, using augmented reality, interactive installations, and screenings.

Certainly, one of the most interesting projects in the exhibition is Adrian Parr’s, who researched trans-species design to create a new perspective on existence, a reflection on the world we share with other living beings. Another project on carbon neutrality and responsible resource exploitation is Marinaressa Coral Tree, a project on minimalism, circularity, regeneration the University of Stuttgart developed for the Giardini della Marinaressa, here in Venice. A project based on responsible management of natural resources and on the creative potential of architectural design.

Lo spirito laboratoriale ha sempre caratterizzato negli anni l’impianto dei vostri progetti espositivi. Prima di entrare in mostra, ci interesserebbe capire bene che cosa contraddistingue il vostro approccio all’architettura e al design. E quindi quali sono state le basi da cui si è sviluppata questa nuova edizione di Time Space Existence. Time Space Existence è una rassegna che ormai ha compiuto più di dieci anni. Fin da subito, con la prima mostra di architettura presentata a Palazzo Bembo nel 2012, l’intento del nostro progetto è stato quello di aprire al pubblico internazionale uno spazio riservato al dialogo proficuo tra individui e discipline. Time Space Existence ogni due anni offre un momento per la documentazione, il confronto e lo scambio di culture, idee ed esperienze diverse. Per noi è sempre stata una scelta naturale quella di presentare non solo progetti di architettura, ma anche il lavoro di designer e di artisti, in quanto crediamo che ogni disciplina possa offrire uno sguardo diverso sul mondo in cui viviamo ed è proprio questa pluralità di idee e prospettive che vogliamo mostrare, nella speranza che possa essere fonte di ispirazione e riflessione per tutti.
Palazzo Mora, Palazzo Bembo e i Giardini della Marinaressa offrono una visione composita, eterogenea e vasta sulle questioni fondamentali dell’architettura contemporanea, progetti e ricerche che indagano il campo a 360 gradi. C’è una qualche linea prevalente che lega questo percorso progettuale articolato?
La mostra non vuole offrire soluzioni pronte all’uso. Ci limitiamo ad essere uno strumento di condivisione di idee, ricerche e progetti sviluppate in ogni dove da persone, tante, che oggi stanno cercando di trovare soluzioni condivise ai problemi globali che ci affliggono. Alcuni progetti esposti sono sperimentali, altri utopici, altri ancora più concreti; non offrono ancora soluzioni perfette, cercando di mitigare gli effetti nocivi che il sistema di vita contemporaneo produce sul pianeta navigando attraverso realtà difficili e futuri incerti. Tutto il mondo è un laboratorio che ogni giorno sforna idee, materiali, persone, animali, costruendo un pezzo del nostro futuro. Pensiamo sia importante far conoscere al mondo cosa succede sul fronte dell’architettura oggi cercando di coprire un orizzonte visivo il più ampio possibile. Lo facciamo aprendo le porte ad aziende globali, così come a studi di architettura composti da due o tre persone, a studenti e università, perché chiunque di noi nel suo specifico ha un ruolo importante da svolgere, piccolo o grande che sia. Tutti possiamo fare la differenza.
Nel corso delle sei edizioni di TSE, anche proprio da un punto di vista delle modalità allestitive, ma direi più estesamente da quelle propriamente espressive, tutto si è andato via via mutando a velocità impensabili solo fino a un decennio fa, passando rapidamente dal modello plastico al 3D e all’AI. Come vengono restituite in mostra queste trasformazioni, se così si può dire, linguistiche?
Dal 2012 a oggi la mostra ha presentato progetti sempre più numerosi ed eterogenei.
Se prima l’architetto pensava e comunicava il suo lavoro attraverso un linguaggio condiviso dalla sua professione, utilizzando quindi gli strumenti canonici di disegno e modello, ora l’architetto alla ricerca
di soluzioni in altri ambiti, come la scienza, la robotica e le tecnologie digitali, ha scoperto nuovi modi di comunicare. I progetti esposti in mostra negli ultimi anni offrono quindi al visitatore anche esperienze virtuali attraverso la realtà aumentata, installazioni interattive e proiezioni. Un’accelerazione di modalità espressive e percettive a dir poco intriganti.
Il cambiamento climatico, la decarbonizzazione, la natura e il suo rispetto, la sostenibilità e l’evoluzione ecologica e tecnologica sono tutti temi che con approcci e scale diverse caratterizzano una macro area nel percorso espositivo di TSE. Quali i progetti e le evidenze più significative a riguardo presenti in mostra?
Sicuramente uno dei progetti più interessanti in mostra è quello presentato da Adrian Parr del College of Design della University of Oregon a Palazzo Bembo, che attraverso il lavoro di ricerca sul design trans species offre la possibilità di un cambio di prospettiva e di riflessione profonda sulla nostra esistenza, invitandoci a vivere e condividere il mondo in cui viviamo con tutti gli esseri viventi. Un altro progetto che guarda alle tematiche della decarbonizzazione e all’uso responsabile delle risorse naturali è il Marinaressa Coral Tree pensato dall’Università di Stoccarda per i Giardini della Marinaressa. Il progetto segue tre principi – minimalità, circolarità e rigenerabilità – andando a richiamare l’attenzione sulla gestione responsabile delle risorse naturali e sul potenziale creativo che essa può presentare nella progettazione dell’ambiente costruito.
Migrazioni, emergenza sociale, casa e città compongono nel loro composito insieme l’altro filone di indagine offerto dalla mostra. Quali possibili scenari futuri e quali progetti offrono nuove prospettive a questi problemi?
Uno dei progetti che cerca di trovare soluzioni per l’emergenza sociale e delle migrazioni è sicuramente Essential Homes Research Project, presentato dalla Norman Foster Foundation con Holcim. In questa collaborazione la Norman Foster Foundation ha progettato alloggi essenziali per fornire sicurezza, comfort e benessere alle comunità sfollate, le quali trovano in queste funzionali abitazioni la possibilità di vivere in maniera dignitosa in insediamenti temporanei anche per vent’anni. Holcim ha costruito queste abitazioni essenziali con una serie di soluzioni ecologiche, dal calcestruzzo a basse emissioni di carbonio ECOPact ai pannelli isolanti Elevate, rendendo così l’edilizia sostenibile e accessibile a tutti. Il prototipo in scala reale è visibile ai Giardini della Marinaressa, mentre la ricerca e i bozzetti si trovano a Palazzo Mora.
Un’altra collaborazione di straordinaria rilevanza è quella tra il Civic Data Design Lab at the Massachusetts Institute of Technology (MIT) con the United Nations World Food Programme (WFP), i quali presentano a Palazzo Bembo Distance Unknown, un progetto che guarda ai dati della migrazione centroamericana per contribuire a migliorare il dibattito politico, e le conseguenti proposte, sul tema. Il pezzo principale della mostra è un arazzo che illustra i fattori che spingono le famiglie vulnerabili del Centro America a migrare e i costi associati ai loro viaggi. Il progetto diventa quindi personale e quasi intimo, in quanto il visitatore può conoscere veramente da vicino, chiaramente, le esperienze concrete dei migranti che sono stati costretti a lasciare la terra natia.
Altro elemento caratteristico di TSE è la totale apertura ai diversi linguaggi, offrendo un percorso futuribile, digitale, tecnologico, ma al contempo anche analogico, visivo, letterario, poetico e artistico. L’inclusività pare essere il tratto distintivo e direi quasi esclusivo della mostra.

È fondamentale che il progetto sia accessibile a tutti, per questo non chiediamo un biglietto di ingresso. La mostra è quindi fruibile gratuitamente. Questo fa sì che la proposta espositiva non sia elitaria, ma il più democratica possibile: non solo per quello che presentiamo, ma anche per come viene vissuta dal visitatore. Con le nostre mostre speriamo di poter stimolare dialoghi e discussioni, invitando i visitatori ad interrogarsi sulle problematiche del presente grazie ad una molteplicità di linguaggi e metodologie che contraddistinguono nel loro dinamico insieme la linea curatoriale di tutti i nostri progetti espositivi.


One of the projects that looks for solutions to problems in the areas of social emergency and migration is Essential Homes Research Project, presented by Norman Foster Foundation and Holcim. These essential dwellings offer safety, comfort, and well-being to displaced people, who can live decently in these home for as long as twenty years. Holcim built these dwellings using ecological solutions, like ECOPact low-carbon concrete or Elevate insulating panels. We also collaborate with the Civic Data Design Lab at MIT together with the United Nations World Food Programme – the two will present Distance Unknown, whose main exhibit is a piece of tapestry that illustrates what factors push vulnerable families in Central America to migrate, and what costs they face.
It is essential that our project is accessible to everybody, which is also why there’s no ticket to pay to see the exhibition – it’s free. This makes the exhibition as democratic as possible, not only for what we show, but for the way it is experienced by visitors. With our exhibitions, we hope to stimulate conversation and discussion. We invite our visitors to question the issues of modernity using the many languages and methods that belong in our vision and in our projects.

Un concorso internazionale, dieci progetti selezionati, una mostra, una giuria, un vincitore: questi gli ingredienti fondamentali di DoorScape 2023, prima edizione di un contest di progettazione promosso da Oikos Venezia e Fondazione Querini Stampalia, che ospita la mostra dei progetti nell’area Scarpa. Tema progettuale, una riflessione sullo spazio d’ingresso nei suoi molteplici collegamenti, accezioni e funzioni. «Siamo sulla porta – ha dichiarato l’architetto Michele De Lucchi, che con il suo studio AMDL CIRCLE ha presieduto la giuria e curato la mostra –, nel luogo che filtra l’incontro tra l’interno e l’esterno. È un confine, un passaggio attraverso due aree che proprio in quel punto si combinano e si avvolgono tra loro». I giovani architetti, progettisti e designer hanno avuto modo di riflettere sull’atto di oltrepassare una soglia e di esprimere la loro creatività per ideare scenografici varchi e lo spazio che li precede e li segue attraverso combinazioni di forme, elementi e materiali. Oltre 100 progetti sono stati selezionati fornendo una varietà di idee originali, tra questi dieci sono ora in mostra: The Portal di Setion Branko, vincitore del Concorso, The Cut di Matheus Cartocci, Il giardino dell’Utopia di Emanuele Cipolla, Soglia da Segno a Luogo di Filippo Garau, Prélude di Isabelle Gomez, Viride di Anna Loggia e Alice Fantino, Instrument Door di Sara Simoska, Doorscape di Maria Grazia Spirito, Hypostyle di Victor Catalin Tanasa, La soglia come approdo di Antonella Trusgnach.
The Portal, ideato da Setion Branko, ha convinto la giuria per la proposta molto chiara e ben concepita, che interpreta le finalità di DoorScape. Il progetto riunisce molti aspetti che insieme creano il “paesaggio” di una soglia senza tempo: l’uso di una forma classica come l’arco, l’invito a esplorare l’interno grazie al gioco prospettico dei portali, la creazione di uno spazio intermedio che mette in dialogo pubblico e privato, la calibrata combinazione dei colori e della matericità del legno, della pietra e del vetro. M.M.
ENG A n international competition, a line-up of ten designs, one exhibition, one jury, one winner: DoorScape 2023, promoted by Oikos Venezia and Fondazione Querini Stampalia, is a reflection on the entryway in its several functions and acceptations. The young architects and designers reflected on the act of walking past a threshold and express their creativity to create spectacular portals, with the space around them following suit with different shapes, elements, and materials. Over one hundred projects have been chosen to display a wide array of original ideas, ten of which now make up the exhibition. The Portal by Section Branko won the competition with its clever design of liminal space.
Nell’annosa querelle che contrappone gli architetti nel concepire una disciplina sospesa tra teoria e prassi, emerge come un faro la retrospettiva dedicata al grande Maestro Kengo Kuma (Yokohama, 1954), la cui idea di costruito è la sintesi perfetta e riuscita dei due concetti. Il suo approccio progettuale si ispira spesso al passato ed è sicuramente strutturale sotto molti aspetti, ma allo stesso tempo è anche tattile, sensoriale e talvolta sensuale. La sua sensibilità include il ritmo e il flow, elementi tipici della musica. Gli edifici progettati da Kuma hanno spesso una leggerezza inaspettata o un tipo di movimento che lui stesso attribuisce al suo processo di concetto musicale. Il modo in cui l’architetto giapponese si pone verso materiali è un punto chiave della sua originalità. Evitando il più possibile l’uso del cemento, realizza opere che sembrano posarsi delicatamente sul terreno, talvolta apparendo evanescenti o addirittura ambigue. Kuma si definisce un “materialista” nel senso fisico del termine. La sua ricerca interattiva di materiali da costruzione nuovi e (a volte) antichi gli permesso di capire che esiste una ricchezza di oggetti e materiali nuovi e diversi che aspettano di essere scoperti.
La mostra Kengo Kuma. Onomatopoeia Architecture, a cura di Chizuko Kawarada e Roberta Perazzini Calarota, in corso a Palazzo Franchetti, riporta la dimensione tradizionale e quasi anacronistica di un’esposizione di maquette di suoi progetti più celebri realizzati in tutto il mondo ad un livello altro, assumendo ogni pezzo/progetto il valore di un’opera d’arte sospesa nel tempo e nello spazio, in cui le superfici dei modelli non


Il “materialista”
Kengo Kuma, lezioni di architetturaThe Exchange (2019), Sidney, Australia © Kengo Kuma & Associates Photo Shimamura Kisshomaru The Portal, Setion Branko (progetto vincitore) © DoorScape 2023
coinvolgono solamente la vista, ma anche i sensi di olfatto e tatto. Il titolo della mostra sintetizza l’idea stessa di architettura di Kuma: «L’onomatopea non vede l’architettura come il soggetto delle operazioni di attori di un rango superiore (gli architetti), ma pone architettura ed esseri umani sullo stesso piano. Gli architetti non sono a capo dell’architettura, ma camminano attorno ad essa insieme ai fruitori».
ENG A rchitecture has long been debated as a discipline pending either more towards theory, or towards practice. Some interesting input on the matter comes courtesy of Kengo Kuma (b. Yokohama, 1954), whose idea of architecture is the perfect synthesis of the two. His designs take inspiration from the past, and is frankly structural in several aspects, but at the same time, it is tactile, sensorial, almost sensual. His sensitivity includes rhythm and flow, typically musical elements. His buildings have a certain unexpected lightness to them. Exhibition Kengo Kuma. Onomatopoeia Architecture reverts to the traditional array of maquettes of Kuma’s best projects, artefacts that will involve all our senses.

Tetti di capannoni agricoli, di aree industriali dismesse, di ferrovie o di depositi militari e tetti di locali commerciali abbandonati di medie dimensioni diventano oggetto di progettazione architettonica nell’ottica del recupero delle strutture esistenti ad uso abitativo.

Prix W 2023, promosso da Fondation Wilmotte, giunto alla sua decima edizione, ha lanciato una sfida progettuale attualissima, affascinante quanto essenziale: Un tetto per tutti! (un Toit pour Tous)
Inserendosi nel dibattito internazionale, di fronte all’attuale crisi dell’inadeguatezza delle abitazioni, la Fondation Wilmotte ha invitato studenti universitari e neolaureati di tutte le facoltà di architettura d’Europa a ideare una nuova tipologia di alloggi di qualità, reinventando e immaginando innesti architettonici e soluzioni originali per progettare moduli abitabili da spazi non convenzionali, e salvaguardare così l’ambiente contro l’abbandono di strutture fatiscenti.
Milioni di metri quadri coperti inutilizzati che potrebbero cambiare la vita di centinaia di migliaia di persone. Il target di riferimento sono infatti i senzatetto, le persone a basso reddito, i giovani lavoratori, gli studenti, i “non dirigenti” (lavoratori intermittenti, artisti, lavoratori autonomi, ecc.). Spazi vuoti sono divenuti così il palcoscenico perfetto per sperimentare un nuovo modo di pensare le periferie urbane e di esprimere l’architettura. Cinquantasette sono stati i progetti selezionati, quattro i premiati, tra cui due classificati al terzo posto a parimerito, e dieci progetti che hanno ricevuto una menzione speciale. I lavori dei vincitori, esposti nella Galleria della Fondation Wilmotte a Venezia fino al 12 novembre, offrono una panoramica progettuale ampia e originale, che mostra come le nuove generazioni di architetti siano pronti a guardare l’esistente, il già costruito, ricercando formule progettuali consapevoli.
ENG B arns, factories, train depots, military warehouses, and other abandoned buildings of all sorts all can be within the scope of restoration and conversion to housing unit. Prix W 2013, promoted by Fondation Wilmotte, launch a very special challenge: Un toit pour tous! (lit. ‘A roof for everyone!’) Seeing a show inadequate the housing supply can be, Fondation Wilmotte invited university students and recent graduates to develop original solutions for housing modules to be installed in unconventional spaces, and save the environment from the consequences of leaving large structures abandoned. Fifty-seven designs have been picked, four awarded, which will be exhibited at Fondation Wilmotte in Venice until November 12. An original outlook on the abilities of the younger generation of architects.
Prix W 2023
U n Toit pour Tous
Fino 12 novembre Fondazione Wilmotte, Fondamenta dell’Abbazia, Cannaregio 3560
www.fondationwilmotte.fr
Un tetto sopra la testaA roof over everybody’s head, Anna Myts, studente dell’Università Tecnica Ceca di Praga
L’isola della Certosa, nella Laguna di Venezia, a pochi minuti di navigazione dall’Arsenale, è stata coinvolta in un importante intervento di valorizzazione e studio, in particolare trasformando il suo parco in un laboratorio vivo, in crescita e quindi in costante trasformazione. Promosso da Fondazione MAXXI e curata da Domitilla Dardi, BioGrounds è un progetto che si pone come obiettivo quello di attivare una nuova coscienza ambientale condivisa. Il concept nasce dall’unione tra la vita ambientale (Bio) e l’assonanza con il termine playground (Grounds), l’obiettivo è di creare installazioni, dispositivi e performance in grado di raccontare al pubblico la storia di un luogo e la sua natura, coinvolgendo i visitatori tramite azioni e interventi. Nel passato i giardini didattici, zoologici e botanici svolgevano il compito di catalogare le specie botaniche e animali con spirito enciclopedico. L’attitudine contemporanea è invece quella di conoscere e mettersi in ascolto di ciò che un contesto ambientale può testimoniare. Quattro installazioni in diverse parti dell’Isola offrono esperimenti artistici su scala diversa, esito finale di un fitto dialogo tra progettisti, architetti, artisti, designer e teorici esperti di temi ecologici, filosofi, botanici, critici: Spaccasassi di Beka & Lemoine in dialogo con Stefano Mancuso; Invasi di Andrea Anastasio in dialogo con Angela Rui; Populus Alba di Studio Formafantasma in dialogo con Emanuele Coccia; Seed Bed di Studio Ossidiana, Progetto Alcantara-MAXXI. Il pubblico è invitato a osservarne il cambiamento degli interventi nel corso dei mesi di svolgimento del progetto (da maggio a ottobre), come parte integrante della fruizione attiva di BioGrounds
Il tour dell’Isola inizia presso i ruderi del chiostro dell’antico mona-
stero della Certosa, dove è stata collocata l’opera Spaccasassi. Creazione di un mito contemporaneo. Protagonista è un albero, un bagolaro, nato spontaneamente grazie alle acque residue del pozzo che alimentava la struttura. Questa specie arborea in dialetto è chiamata “Spaccasassi” per la sua prerogativa a farsi strada anche sulle dure superfici di strade e architetture imposte dall’uomo alla natura. La sua essenza è quindi quella di un essere resistente, che sopravvive alle condizioni più ostili: sia quelle direttamente create dall’uomo con i suoi artefatti, sia quelle climatiche generate dalle sue azioni. Una serie di attività performative rende tributo a questo albero che ha dato luogo a una sorta di mito proprio per le sue capacità di resistenza. La seconda tappa porta ad un’area anfibia del parco – boschiva e lagunare – dove trova posto l’opera Invasi, una moltitudine di vasi di terracotta tornano alla natura, divenendo nuovamente invasi che contengono piante e animali che li colonizzeranno nel tempo, in maniera spontanea. Riportando il vaso alla natura, esso torna ad essere grembo gestazionale, rifugio, protezione. Terza tappa, Populus Alba, un albero su cui sono stati appesi direttamente sul tronco, sui rami e alla base, alcuni dispositivi in metallo per posizionarvi uno smartphone. Il pubblico può ascoltare, tramite il QRcode, un file che contiene una voce, quella dell’albero che racconta la propria condizione. Gli strumenti hanno la funzione di amplificare il suono della voce, facendo da cassa di risonanza. Gli alberi sono organismi viventi e non una mera fornitura di legno da falegnameria. Ultima fermata, Seed Bed, un recinto o meglio un hortus conclusus, che sancisce un limite, una soglia in parte da attraversare e in parte da non valicare. Come un antico semenzaio, la terra coltivabile è protetta all’interno di una struttura realizzata in Alcantara che espleta la funzione primordiale di protezione e che con gli agenti atmosferici e il passare del tempo si consuma. M.M.

Laboratorio di coscienze consapevoli Il MAXXI sbarca all’Isola della Certosa attivando una trasformazioneSpaccasassi, Beka & Lemoine in dialogo con Stefano Mancuso, Isola della Certosa © Fondazione MAXXI

«Un biglietto da visita nella più bella piazza del mondo», così Adriano Olivetti definì il Negozio progettato da Carlo Scarpa, un ambiente che dialoga con la città di Venezia e che nello stesso tempo la racconta. Proprio qui, nel Negozio Olivetti, è ospitata in occasione della 18. Biennale Architettura la mostra dedicata alle opere di Massimo Micheluzzi, organizzata dal FAI e curata da Cristina Beltrami. L’artista veneziano nel corso degli anni ha rafforzato sempre di più il legame con la sua città, lavorando nella galleria antiquaria del padre e frequentando in seguito la fornace Venini, che gli ha permesso di varcare la soglia del mondo del vetro. All’interno del Negozio si possono ammirare vasi realizzati in opus sectile e mosaico in vetro soffiato che Massimo Micheluzzi ha realizzato a partire dal 2022 in dialogo con l’architettura del Negozio. Ritroviamo nei pavimenti di Carlo Scarpa, così come nei vasi dell’artista, un richiamo al mosaico e al mondo bizantino, passione che descrive il profondo legame di entrambi con Venezia. Scopo della mostra, infatti, è quello di celebrare le architetture, i riflessi, le luci e la storia della città. Un racconto materiale delle medesime radici da cui Carlo Scarpa prima e Massimo Micheluzzi ora hanno saputo sviluppare il proprio linguaggio raffinato e modernissimo in bilico tra tradizione e innovazione.
Lucrezia Sillo
ENG “ The calling card of the most beautiful piazza in the world” once said Italian industrialist Adriano Olivetti about the Olivetti Store, designed by Carlo Scarpa: a place that is open to the city of Venice and that, at the same time, tells its story. Right here, at the Olivetti Store, is an exhibition dedicated to Massimo Micheluzzi’s art, produced by FAI and curated by Cristina Beltrami. The Venetian artist has been working in his father’s gallery since his youth, and later worked at the Venini glass furnace, which introduced him to the world of glass art. At the Olivetti Store, we will be able to see vases made in opus sectile technique, mosaics, and blown glass that Micheluzzi created since 2022. The same reference to mosaics is to be found in the art as well as in the Scarpa-designed flooring, showing a common passion for the architecture of Venice. The very goal of the exhibition is to celebrate the architecture, reflections, lights, and history of our city.
Dal barocco al contemporaneo, cambiano i tempi e gli stili ma le illusioni ottiche continuano ad essere un soggetto affascinante per artisti e pubblico. Aprono una finestra su prospettive inaspettate e ci permettono di evadere da quella che è la semplice realtà oggettiva. Lo dimostra Radials al Fondaco dei Tedeschi, una nuova installazione visiva e percettiva, assolutamente analogica, realizzata dal collettivo Sbagliato, progetto artistico fondato nel 2011 da tre architetti e designer romani, nato dal desiderio di generare un’interferenza nel tessuto urbano, creando “varchi” all’interno dell’ordine rigido composto dalle architetture. Il loro approccio infatti sottende una ricerca creativa che pone l’accento sulla percezione e il percepito, rispondendo alla domanda: «Quanto è labile e soggettiva la realtà in cui viviamo?». Al Fondaco, Sbagliato interviene sulla loggia esterna in facciata e nello Spazio Eventi al quarto piano con due diverse soluzioni ottiche. In entrambi i casi è chiara la citazione che rimanda alla celebre Galleria prospettica di Palazzo Spada realizzata dal Borromini nel 1600. All’esterno le cinque arcate affacciate sul Canal Grande, riprodotte e moltiplicate, generano una prospettiva infinita, creando un effetto spaziale che stupisce lo spettatore stravolgendone la percezione reale. Al quarto piano sulle quattro pareti gli archi colorati di blu si muovono come riflessi sull’acqua, creando un’atmosfera onirica in cui lo sguardo resta sospeso tra realtà e sogno.

Lucrezia Sillo
ENG B aroque to modern – times change but styles and optical illusions never fail to fascinate: they open a portal on the unexpected and allow us to evade from objective reality. Exhibition Radials at Fondaco dei Tedeschi is a visual, perceptual, analogical installation produced by the Sbagliato (lit. ‘wrong’) collective. The three architects and designers carried out a creative research that highlights perception and the perceived in answering the question: how fragile and subjective is the reality we live in? At Fondaco, Sbagliato worked on the outer loggia and in the event space on the top floor with two optical installations. In both cases, the reference to the famous Galleria at Palazzo Spada, in Rome, is apparent: infinite perspectives and a spatial effect that twists our perception.
Radials
Fino 10 novembre Fondaco dei Tedeschi, Rialto w ww.sbagliato.net | www.tfondaco.com

Le società cambiano e di conseguenza cambiano anche le esigenze degli edifici e dei loro abitanti, nel contesto di questo continuo processo, chi riutilizza e ricicla materiali e componenti risparmia risorse, evita gli sprechi e utilizza l’energia grigia immagazzinata negli edifici esistenti. Umbau, dal tedesco “conversione” o meglio, declinato all’architettura, trasformazione continua delle strutture esistenti, è un’antica tecnica culturale che, in considerazione degli attuali obiettivi climatici, sta acquisendo una nuova importanza rivestendo di fatto perfettamente i parametri della sostenibilità della pratica architettonica. In una Venezia che sembra immobile, ma in realtà è in costante e silente trasformazione, non sorprende nei percorsi urbani paralleli alla Biennale Architettura trovare uno spazio inaspettato e “convertito” per esposizioni, che ospita una delle mostre più interessanti in città. Umbau. Nonstop Transformation, curata da von Gerkan, Marg and Partners Architects (gmp), tratta recenti casi studio relativi a pratiche di conversione del XXI secolo in Germania, ma non solo, che si occupano del patrimonio architettonico del Movimento Moderno, quali tra gli altri la Biblioteca di Stato al Kulturforum di Berlino (1978), lo Stadio Olimpico di Berlino (1936), il Kulturpalast di Dresda (1969), l’Hyparschale di Magdeburgo (1969) e l’Alster-Schwimmhalle di Amburgo (1973). Lo studio di Amburgo da oltre quarant’anni opera sul terreno della conversione/ Umbau sulla base di un inventario completo dell’esistente, sviluppando il preesistente come un’evoluzione architettonica. M.M.
ENG S ocieties change, and so do the needs of buildings and dwellers. Within this context, those who recycle and process materials and materials save on resources, avoid waste, and use the latent energy in existing buildings. Umbau is German for ‘conversion’ or ‘renovation’—the continuous transformation of existent structures and a cultural technique of sorts that, due to climate change-sensitive practices, is gaining more traction. Umbau. Nonstop Transformation shows recent case studies from Germany, like the library at the Kulturforum in Berlin (1978), the Olympiastadion (1936), the Kulturpalast in Dreseden (1969), the Hyperschale in Magdeburg (1969), and the Alster-Schwimmhalle in Hamburg (1973).
Tra architettura e spazio esterno sono sempre esistite diverse interrelazioni, che ora diventano centrali in una nuova visione progettuale che pone in primo piano la sostenibilità dell’abitare e il rispetto dell’ambiente naturale in contesti costruiti. Il confine tra interno ed esterno viene annullato se l’architettura si pone in dialogo e progetta non strutture rigide ma aperte e fluenti, in un continuum simbiotico tra paesaggio e spazio urbano. Questa stretta connessione crea una nuova idea e immagine di “paesaggio”, fondamenta del pensiero architettonico di Gerber Architekten, studio internazionale con sede in Germania, a Dortmund, Amburgo e Berlino.
In Context – Architecture + Landscape a Palazzo Bembo, sede dell’European Cultural Centre, nell’ambito di Time Space Existence, mette in mostra la varietà di concetti che Gerber Architekten disegna, progetta e realizza a livello nazionale e internazionale nel contesto dell’architettura e della pianificazione del paesaggio. Il riferimento al contesto e al sito specifico costituisce sempre il punto di partenza, in particolare indagando in modo specifico luogo, dintorni, paesaggio, rilevanze storiche. Il collegamento rispettoso con il centro storico o lo spazio urbano viene sottolineato e modellato, le architetture acquistano isole di tranquillità semi-pubbliche all’interno di un edificio o luoghi di comunicazione tra interno ed esterno. La connessione tra architettura e paesaggio crea situazioni di transizione, nascono cosi nuovi “spazi paesaggistici”. La gamma di esempi in mostra, da edifici culturali e per il tempo libero a edifici amministrativi e grattacieli, fino alle università, definisce chiaramente l’importanza del lavoro di Gerber Architekten.

ENG A rchitecture and outdoor spaces relate in many different ways, which are the focus in a new visual project on the sustainability of living the natural environment around urban cores. The division between inside and outside is blurred if and when architecture is able to design not rigid structures, but open, flowing constructs, in a symbiotic continuum between landscape and city. In Context – Architecture + Landscape, produced by European Cultural Centre, shows designs Gerber Architekten built around the world as their landscape architecture practice. The starting point is always the specific site they will be working on, thus respecting its historical context.
A rchitecture + Landscape by Gerber Architekten
Fino 26 novembre European Cultural Centre, Palazzo Bembo www.gerberarchitekten.de




Storico dell’arte, Alberto Craievich è il responsabile di Ca’ Rezzonico, Museo del Settecento veneziano, e del Gabinetto dei disegni e delle stampe del Museo Correr di Venezia, fiore all’occhiello della Fondazione Musei Civici Veneziani. I suoi studi, dedicati in particolare all’arte veneziana del Sei e Settecento, sono pubblicati in numerosi volumi e riviste specializzate. Lo abbiamo incontrato in occasione della riapertura di Ca’ Rezzonico avvenuta a fine giugno, al termine dei lavori di restauro svoltisi principalmente al piano terra del Palazzo, necessari e indifferibili a causa dei danni significativi arrecati dall’Acqua Granda del 12 novembre 2019, intervento reso possibile grazie alla donazione da parte di Coop Alleanza 3.0 di oltre 450.000 euro. Oltre al restauro del livello compromesso dalla drammatica inondazione, i lavori hanno portato all’ampliamento della collezione, con integrazioni dai depositi e dalle donazioni private, al riassetto completo dell’illuminazione del Gabinetto dei disegni e delle stampe, ospitato dal 2021 nel mezzanino di Ca’ Rezzonico, alla messa in sicurezza del giardino e alla ridefinizione dei servizi di accoglienza nel Portico al pianterreno.
Lo storico palazzo fu commissionato dalla famiglia Bon a metà del Seicento all’architetto Baldassarre Longhena, il progettista più celebre del periodo, artefice negli stessi anni di Ca’ Pesaro e della Basilica della Salute. Il monumentale progetto si dimostra tuttavia troppo ambizioso per le fortune dei Bon e il palazzo risulta non ancora terminato alla morte dell’architetto nel 1682. Poco dopo, vista l’incapacità della famiglia di sopportare le ingenti spese del cantiere, i lavori vengono bloccati e la fabbrica rimane incompleta. Nel 1750 Giambattista Rezzonico – la cui famiglia nel 1687 aveva acquistato la nobiltà attra-
verso esborso di denaro – compra l’edificio e ne affida i lavori di completamento a Giorgio Massari, all’epoca architetto di grido. Sarà questa famiglia a dare il nome al palazzo, i cui lavori vengono portati a termine in soli sei anni: in tempo per festeggiare l’inarrestabile ascesa sociale del casato culminata nel 1758, quando Carlo, figlio di Giambattista, è eletto pontefice con il nome di Clemente XIII.
La parabola dei Rezzonico è tuttavia assai breve e si consuma già con la generazione successiva. Senza eredi maschi, la famiglia si estingue nel 1810 con la morte di Abbondio e nell’Ottocento il palazzo cambia proprietà più volte, progressivamente spogliato di tutti i suoi arredi. Ridotto a un contenitore vuoto, dopo varie vicissitudini e passaggi di proprietà il palazzo venne acquistato dal Comune di Venezia nel 1935. A conclusione delle necessarie opere di adattamento funzionale, il 25 aprile 1936 la sede museale dedicata al Settecento viene ufficialmente inaugurata: uno straordinario museo d’ambiente che nelle sue sale, oltre a presentare opere di una delle stagioni più felici dell’arte europea, conserva il fasto e lo splendore irripetibile di una dimora del Settecento veneziano. Il nostro intento è oggi qui di raccontare, tramite le parole di Alberto Craievich, l’importante operazione di restituzione alla città di Venezia di Ca’ Rezzonico, che inaugura un nuovo capitolo della sua straordinaria storia.
Quale idea sottende a questo Museo che ripropone l’arte, la vita, la bellezza, le storie, il sogno del Settecento, secolo di massimo splendore e di altrettanto inesorabile declino per Venezia?
Il Museo del Settecento Veneziano apre al pubblico il 25 aprile 1936 e nasce dalla somma di due diverse opportunità: da un lato l’intuizione di alcuni funzionari determinati a salvare le ultime raccolte significative del XVIII secolo rimaste a Venezia, dall’altro lato il fatto che il
Rezzonico per la straordinaria qualità dell’architettura e degli ambienti è considerato il “tempio” del Settecento veneziano
di Franca Lugato e Fabio MarzariIntervista
Comune aveva potuto acquisire uno dei palazzi più belli affacciati sul Canal Grande che, in mani private, avrebbe rischiato di avere altre, probabilmente assai meno congrue, destinazioni. Ca’ Rezzonico risulta perfetto come contenitore perchè rispecchia pienamente questo suo specifico contenuto. Altro fattore storicamente decisivo per il recupero e la destinazione museale del palazzo sarà poi la scelta di colui il quale verrà chiamato ad allestire il nuovo Museo, vale a dire il critico d’arte e museografo Nino Barbantini, che opera a Ca’ Rezzonico in collaborazione con Giulio Lorenzetti. Nel progettare il Museo, secondo la sua cifra stilistica che ricrea sale di ambientazione in cui si mescolano manufatti artistici eterogenei, egli crea un delicato equilibrio tra il museo moderno e la casa abitata, una sorta di “mostra-museo”.
Erano passati pochi anni dalla grande esposizione del 1929 tenutasi ai Giardini della Biennale dedicata al Settecento italiano, diretta dallo stesso Barbantini, capace di riscuotere un grandissimo successo offrendo al pubblico uno spettacolare itinerario attraverso l’arte del secolo XVIII in particolare a Venezia, a cui naturalmente viene riservato un ruolo di primissimo rilievo.
Il Settecento in quegli anni, siamo nel periodo che precede la Seconda Guerra mondiale, era il secolo dell’arte più amato dal pubblico, un pubblico molto sofisticato ed elitario, che si rispecchia anche

per questo suo tratto compiutamente in quel secolo. Per citare Jean Starobinski, «È l’età del ferro che sogna l’età dell’oro». La borghesia industriale, che con l’acciaio e le macchine ha acquisito grandi ricchezze, arreda le case e sogna di vivere come nel Settecento. Il secolo XVIII è inteso non solo come una felice stagione artistica, ma come una vera e propria “nuova” civiltà. Per Venezia è il secolo di Carlo Goldoni, di Casanova, della vita in villa, della villeggiatura, del palazzo veneziano, di Vivaldi, del teatro, del melodramma. In Francia è il secolo di Madame de Pompadour, di Luigi XV... Tutto parte da Parigi, tuttavia il Settecento francese e quello veneziano si muovono in parallelo, raggiungendo le medesime, alte vette.
Questi ricchi industriali comprano anche materialmente il loro sogno, cercando di possedere tutto ciò che rimaneva a Venezia nell’Ottocento: vengono svuotati armadi e cantine, staccati affreschi che vanno ad abbellire le loro case. Come afferma sempre Starobinski, «Quei borghesi arricchiti che alla rivoluzione francese devono tutto, la odiano perché ha distrutto quel mondo che loro hanno sempre sognato».
Volendo dare un punto di riferimento temporale come ideale chiusura della stagione di fascinazione per il Settecento veneziano, lo si fa coincidere con la memorabile festa, l’esclusivo Bal Oriental, che il 3 settembre 1951 portò tra gli altri in una sola notte a palazzo
Labia a Venezia Salvador Dalì, Orson Welles, Winston Churchill, il tutto sotto il segno e la regia di Christian Dior. È un cerchio che si chiude: aperto con l’epoca di Napoleone III nella seconda metà dell’Ottocento e chiuso idealmente con quella festa a Venezia, che fa rivivere tanto nello stile – palazzo Labia era arredato in stile Settecento prima dell’asta dei suoi arredi – quanto nei modi – fontane che zampillavano vero vino, giocolieri, maschere – fattualmente questo sogno impossibile.
Ca’ Rezzonico oggi intende far rivivere le atmosfere dorate e regalare al visitatore l’emozione unica del Settecento veneziano che questo Palazzo e la sua collezione restituiscono magnificamente.

Nell’intervento di restauro, che ora riporta Ca’ Rezzonico a rinnovata bellezza, avete lavorato in filigrana nel mantenere e conservare l’integrità del Palazzo. Tuttavia si è trattato di una serie di interventi molto importanti, spesso non immediatamente percepibili eppure sostanziali, che hanno riguardato in particolare tutto l’apparato dell’illuminazione e della sicurezza.
È stata in particolare la bravura dei miei colleghi architetti a permettere l’ottima riuscita di questo non semplice intervento di restauro. Sono stati infatti capaci di ridurre il meno possibile l’impatto della tecnologia sul contenitore. Proprio perché Ca’ Rezzonico è una ricostruzione d’ambiente, si è reso necessario per quanto possibile rendere meno evidenti le luci, limitare visivamente, pur all’interno delle norme, le lampade di emergenza e gli estintori, nascondere, o meglio, celare i climatizzatori, e così via... Se non si vede il lavoro svolto, allora significa che abbiamo lavorato bene. Intervenire in filigrana era quindi la parte più complicata del lavoro; non ci siamo riusciti dappertutto, però nel complesso possiamo dire di avercela fatta, sì. Va detto che le soluzioni tecnologiche di cui oggi disponiamo rispetto anche al più recente passato aiutano molto in questo tipo di interventi. Il settore dell’illuminazione ha compiuto passi da gigante in pochissimi anni, passando dalle energivore luci alogene, che scaldavano tantissimo e si rompevano periodicamente, ai led, che durano fino a dieci anni, con consumo energetico bassissimo. Led che inoltre possono essere posizionati in sicurezza vicino a ciò che si deve illuminare senza correre il pericolo che “tostino” il quadro o la stoffa, con tutte le conseguenze nefaste che ciò comporta. Da questo punto di vista Ca’ Rezzonico ora è diventato davvero un museo moderno.
L’investimento è stato certamente notevole; tuttavia, sia sul fronte del risparmio energetico che su quello connesso del rispetto dell’ambiente, possiamo dire che il gioco è valso assolutamente la candela, anzi, il led!
Altro elemento di novità di questo intervento di restauro, anch’esso significativo e questa volta visibile, è la riqualificazione del magnifico Portego passante del piano terra. L’intervento è stato declinato sul piano dell’accoglienza (ingresso, biglietteria, guardaroba, bookshop, caffetteria, didattica), rispettando i nuovi parametri di fruizione museale. Di fatto un’incredibile apertura alla città e uno spazio comune unico e funzionale.
Il piano terra era da tempo la parte più debole del Museo. Gli ultimi restauri erano ormai risalenti a molti anni fa, in più l’Acqua Granda
del 2019 aveva fortemente compromesso diverse parti di esso, tanto da rendere necessario e davvero urgente l’intervento di restauro. La fruizione non risultava omogenea e uniforme per una serie di aggiustamenti successivi, non legati a un piano di sviluppo pianificato: prima l’inserimento della caffetteria, poi la biglietteria, poi ancora il recupero del bookshop... Il Portico non era stato pensato come uno spazio unico, coerente, né dal punto di vista della fruizione né dal punto di vista puramente allestitivo e cromatico. Dovendo intervenire anche sulla struttura, i colleghi architetti hanno studiato attentamente l’intervento, inserendolo coerentemente nella cifra architettonica dello spazio, in particolare ‘sfruttando’ i materiali del Portico, come la pietra d’Istria, andando ad armonizzare i diversi spazi che si aprono sul portico stesso e che si connotano per i servizi al pubblico, con un colore comune campionato dal famoso dipinto La Nobiltà e la Virtù abbattono l’Ignoranza (1744-1745) di Giambattista Tiepolo, l’azzurro polvere, che ha sostituito il colore di rappresentanza del Museo, dandogli una nuova e coerente identità.
Sfruttando quella che è la peculiarità del Museo, cioè un Portico passante, il piano terra diviene ora uno spazio libero sia per i residenti che per i visitatori, i quali possono accedere direttamente dal Canal Grande attraversando il ponte in legno vicino all’imbarcadero per arrivare fino al bellissimo giardino. Si è creato così un nuovo spazio pubblico, una corte veneziana aperta. Nel portico si affacciano un bookshop e una libreria a disposizione di tutti, una caffetteria con tavolini interni ed esterni, uno spazio che racconta il Museo del Settecento per persone ipovedenti e uno spazio edutainment per bambini, oltre al guardaroba e alla biglietteria. Lo considero a ragione uno spazio pienamente recuperato per la città; lo era già in parte, ma non aveva quell’unità né quella valenza civica che possiede ora.
Fa una certa impressione pensare che negli anni Venti Cole Porter prendeva in affitto il palazzo per trascorrervi parte dell’estate...
A pensarci oggi sicuramente sì. Del resto la dimora ha avuto una sua storia, diciamo così, dagli esiti assai difformi. Questo palazzo si chiama Rezzonico, la famiglia lo acquista a metà del Settecento, ma nel giro di una generazione si estingue, precisamente nel 1810.
Dall’autunno del 1847 al 1848 fu residenza di Carlo Maria Isidoro di Borbone-Spagna, protetto dal governo austriaco. Il palazzo viene ceduto più volte e svuotato dell’arredo dopo varie destinazioni. Si risolleva solo quando lo compra Robert Browning, che qui trascorre le estati del 1887 e 1888, morendovi nel dicembre 1889. Il palazzo diventa un luogo di riferimento, come Palazzo Barbaro, della colonia angloamericana a Venezia. Vi i soggiornerà, tra gli altri, anche Sargent. Nel 1906 Lionello Hierschel de Minerbi, figlio di un commerciante ebreo austriaco con attività a Trieste, all’epoca come è noto fiorente polo commerciale, acquista Ca’ Rezzonico da Robert Barrett Browning, figlio di Robert Browning, restaurando l’edificio e adattando la residenza al proprio gusto. È un personaggio novecentesco: campione di tennis, giocatore di calcio, deputato del Regno, grande proprietario fondiario. A Venezia, oltre a Ca’ Rezzonico, acquista Palazzo Grimani e Villa Foscari a Malcontenta. Il grande musicista Cole Porter vi abita, per l’appunto, dal 1926 al 1927.
A causa di difficoltà economiche legate alla crisi del ‘29, Hierschel de Minerbi è costretto a vendere il palazzo; se la vede davvero brutta perché ha troppi debiti. Il palazzo viene pignorato dal credito fondiario, che lo mette all’asta per due volte, ma nessuno lo acquista perché va assolutamente restaurato, con relativi, ingenti costi. Alla fine il Comune di Venezia inizia nel 1931 a trattare l’acquisto, concretizzandolo solo nel 1935.

La riapertura al pubblico e ora, dopo poche settimane, la prima mostra dedicata al vetro.
Un omaggio a Lino Tagliapietra, il grande maestro vetraio che tutti conosciamo, un tributo che la Fondazione Musei Civici doverosamente gli dedica. Artista viaggiatore, sperimentatore, alla costante ricerca di stimoli da trasferire nelle sue opere, tra ricerca appassionata, perfezionamento tecnico e sublimazione della bellezza del vetro. Il suo modo di lavorare antitetico rispetto a certe soluzioni minimal che sono di moda oggi si sposa perfettamente con il Museo del Settecento Veneziano.
E poi ci sono i 350 anni dalla nascita di Rosalba Carriera. Qui presentiamo probabilmente la parte meno nota dell’arte di Rosalba, che tutti conoscono come la grande pastellista, quando
però il suo percorso espressivo ha inizio soprattutto con il ritratto in miniatura, il cui linguaggio sarà capace di rivoluzionare. Sfrutta infatti l’avorio, dimostrandone una sua nuova, straordinaria potenzialità. Non è lei probabilmente a inventare questa tecnica, ma la trasforma in arte vera e propria. E poi la miniatura diventa l’oggetto del desiderio del Grand tour, il ritratto che si può portare con sé, che si invia agli affetti, alla persona amata, una cosa molto rococò che si contempla in privato con la lente.
Torniamo al restauro. A partire dal 2024 il cantiere continuerà con il progetto di conservazione del soffitto affrescato del grande Salone da ballo. Un cantiere che sarà aperto nonostante la presenza del pubblico in visita. Che occasione può rappresentare per i visitatori questa soluzione che avete adottato?
Aperto perché il Museo non chiuderà, sì. Stiamo studiando soluzioni in sicurezza per renderlo anche visitabile, in particolare per offrire la possibilità di vedere gli affreschi da un altro punto di vista, quello ravvicinato e al contempo rovesciato, per far vedere anche come si lavora dal punto di vista tecnico durante gli interventi di restauro. Ogni volta che mi capita l’occasione di salire su una impalcatura e di poter quindi ammirare gli affreschi da vicino è immancabilmente una grandissima emozione. Il restauro interviene per risolvere un problema che c’è sempre stato, fin dalla ideazione stessa di questo meraviglioso soffitto. Massari decide di portare il Salone a doppia altezza, tirando giù un piano. Per fare ciò crea una grande struttura ingegneristica che lo tiene su. Tuttavia il tempo, i canali e le infiltrazioni hanno reso necessario intervenire sia dal punto di vista statico, sia dal punto di vista conservativo, vale a dire direttamente sull’affresco (ora sono visibili i punti più critici dell’intervento, coperti con carta di riso).
L’importanza del mecenatismo, perché da soli non si va da nessuna parte. Ci parli di chi vi ha sostenuto in questa difficile impresa.
Non possiamo che ringraziare vivamente Coop Alleanza 3.0, che facendo scegliere ai propri soci i diversi progetti da finanziare attraverso l’art bonus – e i soci hanno scelto Ca’ Rezzonico! –, ha reso possibile il recupero della zona compromessa dall’Acqua Granda. In modo virtuoso la Fondazione ha deciso di investire a sua volta e di restaurare anche gli altri piani, sfruttando efficacemente gli otto mesi di chiusura. Tuttavia senza Coop Alleanza non ci saremmo forse neanche mai avventurati in questo percorso di remise-en-forme.
Un’ultima curiosità. Se lei dovesse dare un’indicazione su cinque cose imperdibili, gli highlights di Ca’ Rezzonico, a un visitatore non dico distratto, ma un po’ frettoloso, cosa consiglierebbe?
I due Canaletto, acquisto recente del Museo: non si trovano infatti a Venezia altre vedute del Maestro; certamente la Sala Longhi, con tutta un’umanità varia che ci osserva dalle pareti; Il Parlatorio delle monache di San Zaccaria di Guardi; i soffitti di Tiepolo. Poi, da un punto di vista strutturale-architettonico, invitare a comprendere naturalmente la genialità del Longhena, che rivoluziona il palazzo veneziano creando un’architettura di luce, come si legge ora chiaramente nel Portego del pian terreno.



Grazie alla visione creativa di Adriano Berengo, Sam Baron trasforma in un laboratorio lo spazio di un ex-farmacia storica. Un insieme di “pezzi singoli” in vetro popolano gli scaffali, il bancone e le vetrine, tra fiori, foglie, spine e veleni che seducono e inquietano al tempo, lasciando aperta la domanda sulla natura amica e nemica, amena e terribile, preziosa e fragile come il vetro. Lo sguardo contemporaneo di Baron sull’arte ancestrale del vetro mette in discussione l’aspetto decorativo della sua produzione per recuperare i dettagli ornamentali e i riferimenti culturali di un’arte antica.

Fino 1 ottobre
B erengo Collection, Ex Farmacia, San Marco 412 www.berengo.com
L
14
Le opere di sei artisti pionieri della scultura contemporanea, nati in Boemia nelle prime decadi del secolo scorso, costituiscono il percorso di questo nuovo capitolo espositivo de Le Stanze del Vetro. Dopo la Seconda Guerra mondiale, il vetro in Boemia (attuale Repubblica Ceca) si emancipa dalla tradizionale categorizzazione di arte applicata e decorativa per un utilizzo della materia al servizio della realizzazione di sculture astratte, vetrate, architetture, installazioni e lavori site-specific.
Fino 26 novembre
Le Stanze del Vetro, Isola di San Giorgio Maggiore w ww.lestanzedelvetro.org | www.cini.it
Lo spazio pervasivo di Punta della Dogana, con la sua riuscitissima commistione tra architettura seicentesca e contemporanea, anche in occasione di ICÔNES costituisce un ponte ideale e visivo tra Venezia e il mondo, passato e presente.

Fin dal titolo della mostra, i curatori Emma Lavigne e Bruno Racine propongono uno spunto o riflessione sul tema dell’immagine, proiezione di un legame sotteso spazio-temporale; nel senso etimologico della parola se ne coglie la forza che la proietta dalla contemporaneità oltre l’hic et nunc dell’oggi, per trascenderla fino a suggerire piuttosto una dimensione altra, al di là dello spazio e oltre il tempo. Così come la concezione religiosa legata al cristianesimo orientale bizantino diviene principio spirituale quanto astratto. Non a caso ad aprire questo viaggio attraverso un percorso fatto di pause scandite come fossero cappelle o luoghi di meditazione è un Concetto spaziale di Fontana, il cui taglio sfonda la superficie piatta per aprirsi all’ignoto cosmico. Avvolta nel buio da cui affiora come pioggia dorata è l’installazione di fili luminosi della brasiliana Lygia Pape, che sembra invitarci ad entrare nel suo universo magnetico fatto di raggi di luce che tagliano l’oscurità fino a creare un’atmosfera persino surreale, magica. Finché salendo le scale, si finisce risucchiati nel buio di una stanza totalmente immersiva per rivivere nel video di Philippe Parreno La Quinta del Sordo, un omaggio a Francisco Goya, al suo ciclo di 14 opere murali conosciute come Pitture nere, in un alternarsi di suoni e immagini dove l’architettura sembra percepita al tatto, mentre udito e vista risultano stimolati oltre il luogo e il tempo, in quella casa a sud di Madrid dove Goya dal 1819 visse ormai sordo e malato i suoi ultimi difficili anni. Il percorso continua attraverso un’ottantina di opere di artisti che fanno parte della Collezione Pinault in un dialogo tra figurazione ed astrazione, passato e presente, pittura, scultura, videoarte, performance, con Venezia e la sua tradizione di crocevia tra Oriente e Occidente sullo sfondo di un viaggio immaginario. Culture e orizzonti si intersecano, divenendo vere e proprie
migrazioni. Colpisce Ombre indigene, una bandiera ondeggiante di capelli al vento issata in un’isola della Martinica che fu teatro nel 1830 del naufragio di una nave clandestina di schiavi africani. Opera dell’artista belga Edith Dekyndt, è una sorta di quadro in movimento, proiezione di un martirio lontano, ma che tragicamente sembra riproporsi inesorabile nella fuga di chi scappa dalla guerra o da ogni forma di oscurantismo, che sia l’Iran o l’Africa. Criptico il messaggio di James Lee Byars che espone un chiodo dorato in una teca di mogano, reliquia dal forte valore simbolico che gioca tra il sacro e il profano a riproporre l’idea del sacrificio di Cristo, del dolore umano in chiave sovrannaturale, eterna.
L’artista vietnamita-danese Dahn Vo porta le tracce del suo vissuto di esule di seconda generazione, maturato attraverso una doppia cultura che ripropone in una valigia dove ha racchiuso la statua a pezzi di Cristo, esponendola provocatoriamente a Venezia, luogo di transito di civiltà e di religioni.
Le icone che scorrono nel film di Sergej Eisenstein dedicato alla glorificazione dello zar Ivan il Terribile, quale tormentato padre della patria, diventano un messaggio veicolato dalla cinepresa che si sofferma su inquadrature che esaltano, in una sorta di dramma shakespeariano, dubbi e solitudini estrapolate dalla fissità delle icone. Altrettanto il regista Andrej Tarkovskij dedica un film ad Andrej Roublev, pittore del XV secolo che esprimeva il suo desiderio di libertà nella raffigurazione di immagini sacre.
Un’esigenza di ascesi, di purezza, di semplificazione formale che per alcuni artisti significa astrazione, come in Joseph Albers, di sollecitazione emozionale come suggerisce il purismo delle tele di Agnes Martin, o la ricerca sui bianchi di Robert Ryman e Roman Opalka; opere diversissime nella resa ma che sembrano avere un approdo comune nell’aspirazione al silenzio contemplativo. Michela Luce
ICÔNES
Fino 26 novembre Punta della Dogana, Dorsoduro 2 www.pinaultcollection.com

Da Robert Rauschenberg e Cy Twombly ai Maestri dell’Arte povera Mario Merz, Michelangelo Pistoletto, Pier Paolo Calzolari, Gilberto Zorio, nel mezzo l’arte del secondo Novecento con opere fondamentali di Anselm Kiefer, Gino De Dominicis, Francesco Clemente, Enzo Cucchi, Mario Schifano, Tony Cragg ed Ettore Spalletti. Accanto l’altra metà dell’Avanguardia rappresentata da Marina Abramovic´, Vanessa Beecroft, Candida Höfer, Mariko Mori, Shirin Neshat, tra le altre. Importanti le presenze di Sabrina Mezzaqui, Paola Pivi, Marinella Senatore. E ancora, autori diversi dell’arte internazionale come Thomas Ruff e Thomas Struth, John Currin, Thomas Demand, Anish Kapoor e Marlene Dumas, David Salle e Julian Schnabel, Tony Oursler, Gabriel Orozco, Kcho, Kendell Geers, Yang Fudong, Subodh Gupta, Chantal Joffe, Brad Kahlhamer, Lari Pittman, William Kentridge, Chris Ofili, Adrian Paci, Do-Ho Suh, Chen Zhen, Francesco Vezzoli, Bill Viola, Ai Weiwei, Piotr Uklan´ski. Trisha Baga, Pascale Marthine Tayou e molti altri. Una raccolta straordinaria nata dalla passione di Gemma De Angelis Testa, collezionista visionaria che ha deciso di donare le proprie opere a Ca’ Pesaro, completando e integrando le collezioni esistenti. Centocinque pezzi che aprono una nuova era della Galleria d’Arte Moderna e ne riscrivono la storia, ponendo Ca’ Pesaro al centro esatto del Contemporaneo. ENG T he itineraries of Gemma De Angelis Testa’s taste begin from the mid-twentieth century and develop in a continuous dialogue with the work of Armando Testa. This exceptional donation completes and joins the Ca’ Pesaro Collections with 105 works by Kiefer, De Dominicis, Clemente, Cucchi, Schifano, Cragg, Spalletti, Rauschenberg, Twombly, Merz, Pistoletto, Calzolari, Zorio, Abramovic, Beecroft, Hofer, Mori, Neshat, Kentridge, Ofili, Paci, Do- Ho Suh, Chen Zhen, Vezzoli, Viola, Ai Weiwei and many more. Works that embrace different techniques, cultures and geographies, restoring Ca’ Pesaro to its central position in the contemporary art world.


«Come si può scrivere di Edmondo Bacci? Impenetrabile modesto sensibile evanescente. Io non ho alcun indizio. È mio vicino di casa a Venezia, abita a un ponte di distanza da casa mia (è così che misuriamo le distanze a Venezia), e lo incontro quasi tutti i giorni nella calle vicino a casa o al traghetto. I nostri saluti sono formali ma amichevoli. Non riesco a conoscerlo meglio, questo misterioso piccolo uomo, ma i suoi quadri, quelli, sono un’altra faccenda. Quelli li conosco. Li capisco. Sono i bambini di oggi. Sono dinamici. Sono la bomba atomica su tela. Scoppiano di luce, di energia e colore. Ogni nuova opera è più vitale della precedente. Le sento così esplosive che mettono in pericolo la sicurezza del mio palazzo. Ogni volta che un americano entusiasta ne porta via una, sento che la mia casa è in minor pericolo. Ma poi Bacci me ne porta una nuova. Ognuna è più meravigliosa, più eccitante e più pericolosa». [Peggy Guggenheim, tratto da “Introduzione”, Catalogo della XXIX Biennale Internazionale d’Arte di Venezia, Ente Autonomo La Biennale di Venezia, 1958] È incredibile come l’arte di Bacci e la sapiente curatela di Chiara Bertola negli spazi espositivi della Collezione Peggy Guggenheim abbiamo saputo ricreare a distanza di più di mezzo secolo la stessa energia, dinamismo, potenza di poesia, incanto, colore e luce descritta da Peggy Guggenheim nel 1958. La mostra Edmondo Bacci. L’energia della luce è una “gioiosa ebrezza” per gli occhi e per la mente. Non perdetela!
ENG “ He is my Venetian neighbor. He lives one bridge away from me (this is how we measure distance in Venice). I meet him almost daily in the calle near my home or at the traghetto. Our greetings are formal but friendly, I never get to know him any better. So much for the mysterious little man. But his paintings, that is another matter. I know them. They are children of today. They are dynamic. They are the atomic bomb on canvas. They burst with light, energy, and color. Each new one is more vital than the last. I feel they are so explosive that they endanger the safety of my palace.” Thus Peggy Guggenheim on Edmondo Bacci, the protagonist of the current exhibition at the Guggenheim Venice, curated by Chiara Bartola. Energy, dynamism, enchantment, colour, light, and the power of poetry. You won’t want to miss it.

Cosa significa parlare del tempo? Sembra quasi un modo di dire futile e sterile, un riempitivo narrativo, un discorrere tenendo le distanze dall’interlocutore, tuttavia al giorno d’oggi diventa una necessità impellente richiamare l’attenzione sulla crisi climatica, considerati i disastri che il meteo provoca nel mondo, i dibattiti in ogni luogo sul global warming e il cambiamento climatico che avvertono forse il precipitare della Terra verso il fatidico punto di non ritorno. Ecco, parlare del clima oggi è un atto di responsabilità e lo è ancor più intitolare una mostra, una bella mostra come quella in corso alla Fondazione Prada, Everybody Talks About the Weather, un atto geniale e critico allo stesso tempo. Il curatore Dieter Roelstraete afferma che il mondo dell’arte non sembra molto attento a questo tema così importante, dunque tutti parlano del tempo tranne che nel mondo dell’arte! La mostra è costruita proprio partendo da questa criticità, scegliendo artisti che cercano di reindirizzare in maniera creativa quello che spesso paralizza per la troppa potenza distruttiva. Tradurre il disastro ambientale in bellezza è quello che accade osservando le opere in mostra, la delicatezza e l’intensità di ciò che viene esposto impedisce di cadere nello sconforto e apre uno spiraglio di ottimismo e di luce sul futuro. Roelstraete suggerisce questa visione “metereologica” dell’arte, per continuare a parlare del tempo come un modo di pensare l’impensabile e di raccontare il nostro stare al mondo, esponendoci a qualsiasi intemperie.
Il percorso della mostra si snoda tra piano terra e primo piano nobile presentando le opere per nuclei tematici, legati alle diversità atmosferiche: vento, neve, pioggia, sole e poi desertificazione, migrazioni, inquinamento e innalzamento degli oceani. L’arte si intreccia alla scienza, le opere contemporanee dialogano con quelle storiche, rivelando l’attenzione degli artisti di tutto il mondo nei confronti del tempo. Accompagnano le opere esposte alcuni pannelli che non solo ne spiegano le origini e il significato, ma le raccontano scientificamente con grafici e dati elaborati in collaborazione con il New Institute Centre For Environmental Humanities (NICHE) dell’Università Ca’ Foscari.
Al piano terra un grande schermo trasmette in loop le previsioni del tempo da tutto il mondo, facendo entrare il visitatore nel giusto clima. Tra le opere antiche non potevano mancare le riproduzioni della Tempesta di Giorgione e del dipinto di Pieter Bruegel Jagers in de Sneeuw, mentre la deliziosa tela della laguna ghiacciata di anonimo, assurge a manifesto della mostra. Claude Monet con la sua Impression, Soleil Levant dialoga con Sole e Brina di Nomellini. Il primo piano ospita una magnifica opera dell’artista argentina Vivian Suter, tele senza telaio che sono state appese al sole e alla pioggia, assorbendo la forza e il colore del tempo. Fa da contrapposto il grande arazzo di Goshka Macuga, Who gave us a sponge to erase the horizon, da guardare con gli occhiali 3D. Giorgio Andreotta Calò presenta dei carotaggi di roccia messi a terra, sculture potenti a confronto con il cromatismo in marmo e tela di Pieter Vermeersch. Plastic Horizon di Dan Peterman sono opere fatte con la plastica riciclata degli oceani che creano molteplici linee sovrapposte, patetici e stupendi orizzonti di plastica. Il suggestivo video dell’indiana Himali Singh Soin, We are opposite like that, si riflette sull’acqua, suggestiva rappresentazione di una possibile nuova glaciazione.
Maria Laura BidoriniWhat does it mean to talk about the weather? It sounds trite and boring, a filler, a way to distance yourself from whom you’re speaking with. But today, it is important to talk about the climate crisis, considering what bad weather can do to our world and how far the Earth is hurling to the point of no return. To talk about climate, today, is an act of responsibility, even more so, to dedicate the title of an exhibition at Fondazione Prada: Everybody Talks About the Weather is a critic, genius act. Curator Dieter Roelstraete maintains that the world of art doesn’t seem to be paying enough attention to this important topic, and his exhibition wants to address this. Two floors present a collection of art grouped thematically: wind, snow, rain, sun, desertification, migration, pollution, and rising ocean levels. Art blends with science, historical art interfaces the modern, and the attention artists dedicated to weather is revealed. Accompanying the art is information on its origin and meaning, with facts and figures elaborated by the New Institute Centre for Environmental Humanities at the local Ca’ Foscari University. The art includes a magnificent piece by Vivian Suter, frameless canvases hung in the sun and in the rain that absorbed the strength and the colour of weather. Opposing it is a large tapestry by Goshka Macuga, Who gave us a sponge to erase the horizon, to be watched using 3D goggles. Giorgio Andreotta Calò presents rock samples arranged on the ground, while Pieter Vermeersch opted for chroma works on marble and canvas.
Passaggio di testimone: Artemisia Gentileschi e la sua Cleopatra lasciano Palazzo Cini per ritornare alla Collezione Cavallini Sgarbi e il suo posto viene subito occupato da un nuovo prestigioso ospite, Bernardo Bellotto con la sua Veduta di Varsavia con la chiesa di Santa Croce, 1778, proveniente dal Museo del Castello Reale di Varsavia. La Galleria di Palazzo Cini a San Vio dal 14 luglio apre le porte a Bellotto, nipote e allievo di Canaletto, considerato uno dei più importanti vedutisti europei del suo tempo per le sue opere di altissima qualità artistica e di eguale valore storico. A Dresda viene chiamato come pittore di corte, in una città messa a dura prova dalla Guerra dei Sette Anni, vi rimane dal 1762 al 1766, tuttavia presto si trasferisce a Vienna invitato dall’imperatrice Maria Teresa d’Austria. Dopo un breve passaggio a Monaco di Baviera e un nuovo ritorno a Dresda, Bellotto si trasferisce definitivamente nella Varsavia del re Poniatowski, segnata da un profondo conflitto sociale, capitale di un Paese in grave declino politico ma pulsante di vita. Qui immortala la città – e la Veduta ora in mostra – con la precisione di un fotoreporter, riesce a catturare anche lo spirito di quella magnifica capitale: la combinazione di Barocco e Medioevo, la vitalità degli abitanti, il cielo e la sua luce. Il suo stile rispecchia quello dell’illustre zio, la luce è cristallina e i particolari perfetti, con il passare del tempo però diventa via via più contrastato, esalta il chiaroscuro e gioca sugli effetti di luci e ombre. Lucrezia Sillo
Tradizione, fascinazione, tecnica, unicità: i fuochi d’artificio sono l’insieme di tutti questi elementi che sommati creano meraviglia. I giapponesi li chiamano poeticamente “fiori di fuoco”, la parola hanabi è composta da Hana che significa “fiore” e Bi una delle pronunce di “fuoco”, mentre in italiano “artificio” deriva dal latino artificium, derivazione di artı˘fex “artefice”, colui che usa l’arte per ottenere fini determinati, quindi abilità, maestria per raggiungere un migliore effetto, per creare un’illusione, per far apparire più bella una cosa. I fuochi d’artificio, dunque, sono pensati per sbalordire e sorprendere l’occhio di chi guarda, in cui lo stimolo percettivo diventa partecipe dell’elaborazione dell’esperienza.

Arthur Duff parte da qui: trae ispirazione dalla storia della visione, dell’effimero e del meraviglioso tratto dalle straordinarie xilografie giapponesi ottocentesche raffiguranti le diverse declinazioni e forme dei fuochi d’artificio – autentici cataloghi di vendita – e li traghetta nella contemporaneità, traducendo questo caleidoscopio di luci e colori con il linguaggio della tecnologia e un potentissimo sistema laser che coinvolge l’occhio e la mente del visitatore. L’unicità dello scoppio visivo diventa metafora dell’espressione delle potenzialità individuali, che come i fuochi d’artificio esplodono se accesi, se stimolati.

Con The Hungriest Eye. The Blossoming of Potential Arthur Duff crea una varietà di forme e composizioni personalizzate e transitorie, prodotto finale di un percorso di conoscenza attiva e partecipata che ogni visitatore di The Human Safety Net, al terzo piano delle Procuratie Vecchie in Piazza San Marco, è invitato a seguire attraverso A World of Potential. L’occhio affamato di Duff restituisce l’unicità di ognuno di noi tramite la lente dell’arte, regalando un fuoco d’artificio esclusivo per forma e colori a ciascun visitatore, espressione personale e originale del proprio potenziale.


ENG T radition, charm, technique, uniqueness: fireworks are the combination of all these elements. When taken together, the experience is pure marvel. The Japanese word for ‘fireworks’ translates to ‘fire flowers’, while in Italian, they are known as fuochi d’artificio, or fire of artifice, meaning ability, dexterity, the craft of illusion. Fireworks are there to amaze and surprise our sight, which is the concept Arthur Duff worked on. He took beautiful vintage Japanese xylography depicting different kinds of fireworks and translated them into modern art languages using technology and a laser apparatus. The uniqueness of the visual explosion is a metaphor of individual potential: they fire up if lit up, stimulated. The Hungriest Eye. The Blossoming of Potential creates personalized, short-living shapes and compositions for each visitor at The Human Safety Net, an exhibition space in Piazza San Marco. The uniqueness of each of us is magnified through art to create an amazing individual expression of our potential.

Potenziale pirotecnico L’occhio affamato di Arthur Duff restituisce l’unicità di ognuno di noi
©Andrzej Ring, Lech Sandzewicz The Hungriest Eye. The Blossoming of Potential di Arthur Duff per The Art Studio in A World of Potential - Photo Matteo De Fina
«Tutte le sue opere nascono da un unico, straordinario accumulo di energia creativa, che esplode nella sequenza ininterrotta di capolavori che segnano la sua carriera. Dal lontano 1945, anno che chiude nella disfatta il Ventennio fascista (e che prendiamo come termine post quem della mostra), e prima, quando da autodidatta insegue il suo destino di pittore nelle calli veneziane, e poi, quando nella precoce maturità, siamo quasi alla fine degli anni Quaranta, nella compagine degli artisti del suo tempo, abbraccia la scelta più radicale, quella dell’astrattismo, scelta perentoria, senza ritorno». Così Gabriella Belli racconta Rivoluzione Vedova, la mostra all’M9 – Museo del ‘900, la prima dedicata all’arte contemporanea, progettata e curata magistralmente dalla stessa Belli e “messa in scena” dagli autorevolissimi architetti Massimo Alvisi e Junko Kirimoto. La mostra intercetta l’istinto di Emilio Vedova nel far coincidere la storia con il gesto della pittura, restituendo un susseguirsi di movimenti “tellurici”, dove l’esistenza del Maestro incontra la cronaca del mondo, quel mondo fatto di rivoluzioni culturali e politiche. La storia è protagonista, è il respiro e le vampate della sua pittura, che si muove e sviluppa all’unisono con le sue battaglie per i diritti civili, il pacifismo, contro l’inganno delle ideologie e la violenza delle dittature, per incalzare il cambiamento, per la difesa di Venezia e molto, molto altro ancora.
Tutto ciò non vi sembra attuale? Vedova è un contemporaneo che ancora ci ispira. Il suo vivere nel presente, “esserci dentro”, misurarne i conflitti e le contraddizioni in una quotidiana dialettica si manifesta oggi quasi più di ieri in maniera evidente.
All’ultimo piano di M9, museo ideato e progettato nel centro di Mestre da Sauerbruch Hutton, tra i pochi musei italiani dedicati alla storia del Novecento, in uno spazio unico e continuo di circa 1350 metri quadrati, le opere costruiscono un “paesaggio” nuovo, un terreno comune di condivisione di affanni, dolori, potenza e sentimento, vita, libertà, ideali. I giganteschi Absurdes Berliner Tagebuch ‘64, ...in continuum, compenetrazioni/traslati ‘87/’88, centodue dipinti in un’unica installazione senza soluzione di continuità e, ancora, i Dischi e i Tondi, lavori realizzati negli anni Ottanta e Novanta, interagiscono con lo spazio in un incrocio di forme rotanti, colore che cola oltre il perimetro curvo della tela, amalgama di forme, furore creativo che ha pochi eguali.
«Protesta e resistenza di un artista che ad ogni impeto fa corrispondere un lucido pensiero, e ad ogni audace slancio e urto della sua pittura, emozioni e sentimenti di tale empatia, che sentiamo ancora vivi nel ricordo di quella sua possanza e autorità fisica» (Gabriella Belli).
Rivoluzione Vedova, frutto di un’inedita collaborazione comune tra Fondazione di Venezia, M9 e Fondazione Emilio e Annabianca Vedova, non è solo una bellissima mostra e un omaggio a un grande Maestro, ma un sistema nuovo e collaterale di pensare il nostro presente, da più punti di vista e da nuove prospettive. La voce di Emilio Vedova, i suoi movimenti, i suoi gesti emblematici, il suo gigantismo espressivo rimangono tatuati sulla pelle. M.M.

At the M9 Museum in Mestre, exhibition Rivoluzione Vedova documents painter Emilio Vedova’s instinct and ability to make one of history and the painting action in a series of ‘seismic’ motions, where the existence of the artist meets the events of the world, a world of cultural and political revolutions. History is the protagonist, it is the breath and the heat on the canvas, it moves and develops on the struggle for civil rights, peace, against the falsity of ideologies and the violence of dictatorship, and more. Wouldn’t you say all of this is perfectly modern? Vedova lives on and inspires us. On the top floor at M9, Vedova’s art builds a new landscape, a terrain to share struggle, pain, power, and feeling. Life, freedom, ideals. 102 paintings in a continuous installation. His Dischi (discs) and Tondi (roundels) interact with the space in a blend of rolling shapes and colour that drips over the curved canvases into a mix of shapes and creative fury that knows few equals. A beautiful exhibition and an homage to a great maestro as well as a new way to think about our present from new points of view and new perspectives.
R ivoluzione Vedova Fino 26 novembre M9 – Museo del ‘900-Mestre w ww.m9museum.it | www.fondazionevedova.org


Le Gallerie dell’Accademia sono in movimento, vive e impegnate in un’incredibile e continua definizione espositiva. I lavori di riqualificazione dell’esistente e la ridefinizione di sale e percorsi hanno portato a nuovi allestimenti pensati per valorizzare al massimo la fruizione dell’ingente patrimonio artistico. Ma non solo, le Gallerie sono un luogo aperto e in costante ampliamento come testimonia la mostra Da Vivarini a Tiepolo. Nuove acquisizioni per le Gallerie dell’Accademia, curata da Michele Nicolaci e inaugurata il 22 giugno nel nuovo spazio (Sala XVI) destinato a mostre dossier, parte delle cosiddette “Sale Palladiane” del museo, appena restaurate e riaperte.
Dieci nuove opere fino ad adesso inedite perché appartenenti a collezioni private o inaccessibili, acquistate di recente dallo Stato per oltre un milione di euro, arricchiscono la collezione dell’Accademia: tre tavole di Bartolomeo Vivarini, verosimilmente appartenenti al registro superiore del Polittico dei Tagliapietra, già conservato alle Gallerie; il dipinto inedito Sansone e Dalila della straordinaria pittrice veneziana Giulia Lama; la Scena della vita di San Pietro Martire di Antonio Vivarini, parte probabilmente di un polittico smembrato già documentato nella Basilica dei Santi Giovanni e Paolo; la Coppia di amanti (La dichiarazione), un intenso dialogo amoroso di Bonifacio de’ Pitati; la tela di notevoli dimensioni con Cristo davanti a Caifa di Pietro Ricchi, una delle sue opere migliori, ispirata a lontani modelli caravaggeschi “a lume di candela”; la piccola e inedita tela montata su tavola di Francesco Fontebasso, di guizzante e fresca stesura, il Matrimonio mistico di santa Caterina d’Alessandria e Estasi di santa Teresa d’Avila ; un bellissimo foglio recto/verso di Giambattista Tiepolo, il primo che va ad arricchire il Gabinetto Disegni e Stampe del Museo, in cui il Maestro con pochi magistrali tratti e leggere ombre a inchiostro acquerellato definisce due splendide immagini di uomo e ragazzo. Si tratta delle cosiddette “teste di fantasia”, un genere che godette di grande apprezzamento nella Venezia del Settecento. Ognuna delle nuove opere porta con sé una storia unica e a volte singolare, vi invitiamo a scoprirla. M.M.

Un intenso dialogo amoroso è raffigurato nella Coppia di amanti (La dichiarazione) di Bonifacio de’ Pitati, risalente al 1527-28 circa. Già nella collezione dei principi di Hannover, si tratta di un’opera rara del pittore veronese, artista a capo di una fiorente e importante bottega a Venezia nella prima metà del Cinquecento. Bonifacio è pittore ben documentato alle Gallerie (Sala XII), ma che trova in questo lavoro un’intonazione diversa e inedita, ispirata alle scene amorose di derivazione giorgionesca e palmesca.

Di particolare rilevanza le tre tavole raffiguranti i Santi Giovanni Battista, Caterina d’Alessandria, Niccolò da Tolentino, già notificate dallo Stato nel 1920. Secondo una recente ipotesi ricostruttiva apparterrebbero al registro superiore del Polittico di Sant’Ambrogio (1477) della scuola dei Tagliapietra, già nelle collezioni dell’Accademia, insieme ad altri due scomparti oggi negli Stati Uniti nei musei di Seattle e di Boston. Grazie alla recente acquisizione oggi si possono ammirare otto tavole su dieci.
Lo scomparto raffigurante una scena della vita di San Pietro Martire faceva parte probabilmente di un polittico smembrato, già documentato nella Basilica dei Santi Giovanni e Paolo. San Pietro martire nella sua cella conversa con tre vergini (1450 circa) colpisce per la vivace caratterizzazione del gruppo di figure e per la smaltata qualità cromatica della stesura pittorica. L’altra acquisizione del caposcuola dei fratelli Vivarini è la piccola tavola raffigurante San Benedetto (1440-1445 circa), appartenuta alla collezione Manfrin.

acquisizioni per le Gallerie dell’AccademiaBonifacio De’ Pitati detto Bonifacio Veronese Antonio Vivarini Bartolomeo Vivarini


Tesori su carta patinata che incarnano una certa visione della storia, ovviamente soggettiva, in quanto rappresentativa di un’élite culturale e finanziaria occidentale: sono le riviste del gruppo editoriale internazionale Condé Nast, fondato nel 1909 dal giovane e ambizioso editore Condé Montrose Nast. Un patrimonio straordinario di storie e immagini del Novecento racchiuso negli immensi archivi, in parte acquisiti dalla Pinault Collection nel 2021 e ora messi per la prima volta in mostra a Palazzo Grassi. Più di 400 opere e fotografie realizzate tra il 1910 e il 1979, ordinate cronologicamente per decenni, che mostrano donne, uomini, momenti storici, vita quotidiana, sogni e drammi del XX secolo. Chronorama è un avvincente display di bellezza e di arte fotografica – sono presenti tutti i grandi maestri del Novecento –, tuttavia non è un semplice processo di riproduzione del reale, ma un viaggio tra immagini magiche che catturano, esprimono e trasformano il reale restituendo al visitatore un saggio visivo dell’evoluzione estetica della società moderna. Chronorama è il Novecento messo in copertina, visto attraverso gli occhi dei lettori e delle lettrici, uno specchio che non si limita a tradurre la realtà, ma va ben oltre, con una potenza tale da deformare la realtà stessa. Così, tempo e immagini diventano inseparabili. Le persone ritratte, davvero rappresentative del secolo scorso come Charlie Chaplin, James Joyce, Henri Matisse, Ernest Hemingway, Mick Jagger, Catherine Deneuve, Karl Lagerfeld, Richard Avedon, Arthur Ashe, Twiggy, Veruschka e molti altri, ricordano che è impossibile scindere la moda dall’arte, dal teatro, dalla danza, dall’architettura e dalla realtà urbana.
«Ugo Mulas è stato un punto di riferimento fondamentale per mettere a fuoco le modalità espressive di un linguaggio “ambiguo” che, allora, doveva ancora trovare un posizionamento tra mestiere e arte: da una parte i processi di documentazione e racconto tipici del reportage, dall’altra l’autonomia autoriale riconosciuta agli artisti» (Denis Curti). Ed è Mulas a compiere quel passo in avanti che supera questo dualismo: un autodidatta che diventa maestro indiscusso del mezzo, un fotografo con un’inimitabile capacità di essere innovativo attraverso una costante ricerca e messa in discussione sia della fotografia che del fotografo. Un autore che ha voluto approfondire tematiche diverse, ogni volta cercando la profondità della “quantità umana”. Duecentocinquanta immagini, documenti, libri, varie pubblicazioni, filmati compongono la mostra Ugo Mulas. L’operazione fotografica in corso a Le Stanze della Fotografia, bellissimo spazio sull’Isola di San Giorgio dedicato alla fotografia e ai suoi maestri, passaggio di testimone dalla Casa dei Tre Oci, voluto da Marsilio Arte e Fondazione Giorgio Cini.
Una sintesi certamente non esaustiva dell’enorme corpus di lavoro di Mulas, tuttavia in grado di restituire una lettura multipla che si apre alle diverse esperienze affrontate nel corso della sua carriera breve e molto intensa, in cui smessi i panni del fotografo dell’arte e degli artisti si rivela un narratore del mondo pur mantenendo sempre riconoscibile quel tratto identitario, quel bianco e nero inconfondibile e unico che acquista la potenza espressiva del realismo magico. M.M.




Un tuffo nel Mediterraneo, tra mito, storia e dolorosa realtà. Creature mitologiche e lingue perdute vi accompagneranno.
Due nuove commissioni firmate TBA21–Academy occupano gli spazi monumentali dell’ex Chiesa di San Lorenzo: le sculture poetiche in vetro e in ceramica dell’artista americano-libanese Simone Fattal e un ecosistema composto da una serie di sculture di grandi dimensioni di creature ibride, acquatiche e terrestri, del duo Petrit Halilaj & Álvaro Urbano, indagano il tema dei Mediterranei.


ENG T wo new commissions by TBA21–Academy occupy the monumental spaces of the former Church of San Lorenzo: poetic sculptures in glass and ceramic by American-Lebanese artist Simone Fattal and an ecosystem composed of a series of large sculptures of hybrid creatures, both aquatic and terrestrial, by Petrit Halilaj & Álvaro Urbano investigate the theme of Mediterraneans. Fino
La dimensione dell’avventura e della scoperta di mondi lontani. Ammirate le miniature, i colori, lasciatevi inebriare dalle fragranze dell’India Moghul.
Viaggi leggendari e vite avventurose. Il titolo svela in maniera diretta ed eloquente il cuore narrativo di questa straordinaria parabola umana e culturale. L’esposizione ripercorre le tappe salienti della vita del viaggiatore veneziano, restituendo lo sguardo prezioso, diremmo quasi unico per durata ed intensità del vissuto, di un testimone privilegiato della storia e della ricchezza culturale dell’India Moghul.
ENG L egendary journeys and lives of adventure. The exhibition traces the various stages in the life of the Venetian traveler, offering us the precious – we might almost say unique in terms of duration and intensity of experience – gaze of a privileged witness to the history and cultural richness of Mughal India.

Fino Until 26 novembre November Palazzo Vendramin Grimani, San Polo 2033 www.fondazionealberodoro.org
Il fascino della tradizione, ricami dorati, personaggi classici e ancestrali, bagliori di luce e improvvise ombre trasportano direttamente nella piena estate di Atene.
L’Ego che per l’artista diventa eroe, mano creativa, colui che decide sulla bellezza. Su questo tema sono stati invitati a riflettere quattro artisti, immersi in una Venezia che è la massima espressione di bellezza fragile ed eterna. Carles Valverde, Didier Guillon, Vangelis Kyris e Anatoli Georgiev sono i protagonisti della nuova stagione espositiva di Fondation Valmont.
ENG The Ego that becomes hero and creative hand for the artist – he who decides about beauty. Immersed in a Venice that is the most extreme expression of fragile and eternal beauty, four artists were invited to reflect upon this theme: Carles Valverde, Didier Guillon, Vangelis Kyris and Anatoli Georgiev are the protagonists of the new exhibition season of Fondation Valmont.
Fino Until 25 febbraio February, 2024 Palazzo Bonvicini, Calle Agnello Santa Croce 2161/A www.fondationvalmont.com
Per tutti quelli che quest’estate resteranno in città, Venezia offre diversi luoghi dove è possibile assaporare la sensazione tipica di una vacanza. Luoghi sospesi, fuori dal tempo o luoghi che suscitano ricordi ed emozioni lontani. Di seguito, tre mostre in cui immergersi per viaggiare e sognare.
22 luglio July-10 settembre September
Due artiste, entrambe americane, diverse ma non distanti tra loro, che denunciano un’affinità di ricerca tutta al femminile: Jenne Currie e Tracy Phillips sono protagoniste di una prima doppia personale in Italia, curata da Cross Contemporary Art Projects.

La passione per i viaggi segna l’inizio della carriera artistica di Jenne Currie, le cui influenze creative mostrano confini temporali e spaziali dilatati: dalla scultura greca arcaica ai mosaici bizantini, da Tiziano a Cezanne. La sua indagine condotta attraverso linguaggi artistici diversi porta Currie ad alternare nelle sue opere scultura, pittura e tecnica mista del collage. I suoi collage bilanciano lo spazio scultoreo con i limiti della superficie pittorica bidimensionale: le ombre create dai materiali sono forme sospese influenzate dalla luce che muta con il passare delle ore, risultando quindi in continua evoluzione e diventando parte integrante dell’opera stessa al pari dei pigmenti di colore e dei materiali utilizzati.
Tracy Phillips esplora il contemporaneo catturando nelle sue opere pittoriche un’iconografia in continua evoluzione, soggetti sia figurativi che astratti, che hanno in comune narrazioni molto attuali quali il cambiamento climatico e, in particolare, l’impatto umano sull’ambiente. L’aspetto psicologico, sottolineato dai colori, cifra che caratterizza l’opera di Phillips da sempre, trasporta le sue opere in uno spazio che si sposta tra interno ed esterno, un paesaggio che diventa dimensione dell’esistenza e del sentire interiore. La pennellata descrive tratti naturalistici e nitidi su configurazioni in equilibrio tra il conosciuto e l’inconoscibile. La sensazione percepita è quella di un mondo che ha origine da qualche parte all’interno dello spettatore e a poco a poco si sposta oltre, in regni più oscuri. ENG T wo American artists, different though not distant, interpret artistic research from women’s point of view. Jenne Currie and Tracy Phillips are the protagonists of their new double exhibition in Italy. Passion for travel marks the beginning of Jenne Currie’s career: her investigation of different art languages inspired her to alternate sculpture, painting, and collaged mixed media in her art, which balances the sculptural space with the limits of bi-dimensional painting. Tracy Phillips explores modernity by capturing, in her paintings, a continuously-evolving iconography: both figurative and abstract subjects share contemporary narratives such as climate change and human impact on the environment. Fondamenta San Giuseppe, Castello 780 www.crosscontemporaryprojects.com


The Floating Realm
1 luglio July-20 agosto August
L’art studio h220430, guidato dall’architetto e artista Satoshi Itasaka, volge lo sguardo al passato, quello dell’infanzia, regno della fantasia e del sogno, che col passare del tempo svanisce. Un ritorno a quella dimensione “fluttuante” ( floating ) che abbiamo vissuto da bambini, qui fatta riemergere però totalmente nel nostro presente, con i sensi attivati e concentrati nello sperimentare tutto per la prima volta. Vediamo così Mushroom Lamp, Balloon Mirror o The Birth Lamp trasformarsi in veri e propri strumenti per sospendere il fluire del tempo e rifugiarsi in un luogo alternativo in cui fermare la pesantezza della vita e ricaricarsi di fantasia. I progetti dell’art studio h220430 sfidano senza timore i confini convenzionali della società, integrando arte, design e architettura. Satoshi Itasaka è protagonista anche della mostra Time Space Existence, a Palazzo Bembo.
ENG A rt studio h220430 by architect and artist Satoshi Itasaka turns its gaze to the past–childhood, the realm of fantasy, and of those dreams that fade away over time. A return to that ‘floating’ dimension we experienced as children, here fully re-emerging into our present with our senses activated and concentrated on experiencing everything for the first time. We will see Mushroom Lamp, Balloon Mirror, or The Birth Lamp transformed into tools that suspend the flow of time and take refuge in an alternative place where we can pause the hardships of life and recharge our imagination.
Riva del Vin, San Polo 1100
www.in-ei.it
Tommaso Andrich, Atelier 12, Davide Barbini, Matilde Bresaola, Piero Canal, Chen Jinyue, Cheng Luna, Cong Yubo, Giulia Gaffo, Li Zhiwei, Lin Chengwei, Marco

Luciani, Francesco Masetto, Giuliano

Vaccai, Xu Tongxin, Wang Yuelin, Wu Han, Marco Zilja, Irma Zorzi
23 WATT
Fino Until 29 luglio July
Un gruppo di artisti, formati o che si stanno formando all’Accademia di Belle Arti di Venezia, propongono una riflessione sulla rivoluzione ed evoluzione tecnologica del nostro tempo. Cinque le aree tematiche sviluppate attraverso fotografia, installazioni multimediali e intelligenza artificiale in un spazio di sperimentazione e di ricerca carico di energia. Gli artisti, nativi digitali, mettono in mostra opere in grado di esprimere un nuovo sentire generazionale. Lo spettatore, circondato da fotografie, sculture, video e immerso in ambienti interattivi, viene spinto a interrogarsi sui cambiamenti dell’ambiente, sull’importanza di preservare un pensiero indipendente dai media, sul confine tra la vita umana e virtuale e la meta-realtà. Il titolo della mostra 23 WATT indica la potenza che il cervello può generare in stato di veglia, riportando immediatamente la cifra identitaria dell’esposizione: la fondamentale e unica dimensione umana. L.S.
ENG A team of artists offer a reflection on the technological evolution and revolution taking place currently. Five themes are explored by means of photography, multimedia installation, and artificial intelligence in a space for experimentation that is full of energy. The digital native artists show creations that express the sentiment of a new generation. Spectators will find themselves immersed in a world of photographs, sculptures, videos, and interactive environments that will force them to reflect on environmental changes, the importance of thought independent of mass media influence, on the border between human and virtual lives, and on meta-reality. The title of the exhibition, 23 Watt, indicates the power the brain can generate: the essential, unique human dimension.
Dorsoduro 264
www.accademiavenezia.it
Solo Exhibition
Fino Until 25 agosto August
Allan “Think” Kioko è un artista visivo, illustratore e pittore murale, che vive a Karen Village a Nairobi in Kenya. È un pittore espressivo, amante delle pennellate audaci, dove il colore è deciso, così come la resa della texture. Le sue opere sono realizzate con acrilico su tela e acquerello su carta. Gran parte della sua produzione scava in profondità nella sua esperienza personale, traendo ispirazione dalla sua vita e dai luoghi in cui ha viaggiato. Il fil rouge di questa serie di opere è il popolo Mangbetu, un gruppo etnico del Sudan centrale presente nella Repubblica Democratica del Congo, che ha un forte legame con varie forme d’arte. I Mangbetu sono anche caratterizzati da una forma del cranio allungata, derivante da un rituale della tradizione praticato sui neonati. La mostra è parte del programma African Identities tenuto da AKKA Project.
ENG A llan ‘Think’ Kioko is a visual artist, illustrator, and muralist based in Karen Village, Nairobi, Kenya. He is an expressive painter and loves bold strokes, colour, and texture. His artwork uses acrylic on canvas and watercolour on paper. It is thought provoking, humorous, and occasionally controversial. Kioko draws inspiration from his own life experiences and places he’s been to. The thread that ties it all together is the Mangbetu people, a Central Sudanic ethnic group present in the Democratic Republic of Congo.
Ca’ del Duca, Corte del Duca Sforza San Marco 3052 www.akkaproject.com

22 luglio July-10 settembre September
La mostra, prodotta da Fondazione Bevilacqua La Masa e nata da una importante rete di collaborazioni e contributi, racconta alcune forme di espressione artistica dei linguaggi legati al suono, all’ascolto e alla parola. Il progetto ha preso il via dai materiali conservati nell’Archivio Storico Bevilacqua
La Masa, in particolare dagli artisti appartenenti “all’ultima avanguardia veneziana”, che alla fine degli anni Settanta si sono confrontati con le nuove tecnologie. In mostra, concessi dall’Archivio Cardazzo e da ASAC - Archivio Storico delle Arti Contemporanee, La Biennale di Venezia, alcuni video in cui l’utilizzo del suono scardina l’estetica visiva e invita a riflettere sullo spazio. Inoltre grazie alla collaborazione della Fondazione Archivio Luigi Nono sono mostrati documenti audio-visivi riguardanti uno dei capisaldi del rimodernamento sonoro e stravolgimento compositivo, Luigi Nono. L’indagine si estende alle ricerche più recenti e alla produzione di una nuova generazione di artisti, molti dei quali hanno esposto, hanno avuto uno studio o hanno gravitato attorno alla Bevilacqua La Masa, proseguendo in un percorso di sperimentazione.
ENG T he exhibition produced by Fondazione Bevilacqua La Masa is a collection of artistic expressions related to sound, listening, and word. The project built upon material from the Foundation’s historical archive, in particular from art belonging to the ‘latest Venetian avant-garde’, who in the 1970s employed then-new technology in their making art. On exhibition will be videos that will challenge the place of visual aesthetics with the use of sound, and will invite us to reflect on space. Also, there will be audio/video documents on one of the most prominent personalities in the renovation of sound composition: Luisi Nono. The investigation then goes on and touches more recent productions by younger generations of artists, many of which have been sponsored, over the years, by Bevilacqua La Masa.
Galleria di Piazza San Marco 71/cwww.bevilacqualamasa.it
Matteo, il futuro apostolo, riccamente vestito da gabelliere ebreo, viene invitato dal Cristo (in manto rosso, che prefigura la passione) a lasciare il suo banco e a seguirlo. La scena ambientata a Cafamao, antica città della Galilea, diventa con Carpaccio un angolo di Venezia con le botteghe e le tipiche aperture medievali e i parasole di legno, mentre sullo sfondo una torre militare su di una porta cittadina e diversi palazzi ricordano una città tipicamente veneta...

Terminata con successo la mostra a Palazzo Ducale – e non poteva essere diversamente data la grandezza dell’arte raggiunta dal Maestro –, la nostra passione per Carpaccio non si esaurisce, anzi. Venezia cela suoi capolavori massimi a iniziare dalla Scuola Dalmata dei Santi Giorgio e Trifone (detto San Giorgio degli Schiavoni), da dove ricominciamo il nostro percorso di “riscoperta” della sua incredibile personalità artistica. E lo facciamo andando proprio nelle pieghe del suo dipingere, grazie al racconto scientifico e affascinante del restauro della Vocazione di San Matteo (1502), che Valentina Piovan, restauratrice specializzata, e Stefania Randazzo, storica dell’arte, ci hanno gentilmente concesso. Il testo di seguito è infatti tratto dal loro approfondimento La metodologia di restauro del ciclo di Vittore Carpaccio alla Scuola Dalmata: la Vocazione di San Matteo, un esempio di studio e intervento. Dal 2019 è infatti in corso un importante intervento di restauro sulle opere di Vittore Carpaccio realizzate per la Scuola Dalmata di Venezia tra il 1502 e il 1511, restauri finanziati da Save Venice in onore di Patricia Fortini Brown.
[…] La Vocazione di San Matteo è l’opera scelta per raccontare il restauro (intervento concluso a dicembre 2020) e spiegare cosa abbia rappresentato nel processo di conoscenza e approfondimento della tecnica esecutiva e del procedimento creativo adottati dal Carpaccio.
Prima di approfondire l’analisi della Vocazione possiamo già affermare che grazie ai risultati alle indagini diagnostiche condotte prima e durante l’intervento, sono emersi alcuni elementi comuni alle opere del ciclo. Questi dati, confrontati con le informazioni ottenute grazie alla rilettura dei documenti – in particolare ci si è soffermati sulla ricerca documentaria nei fondi nell’archivio e nella biblioteca della Scuola Dalmata, sul reperimento dell’iconografia completa del dipinto (disegni, incisioni, copie, fotografie) e sui passati interventi di restauro, partendo dall’ultimo documentato del 1946 di Mauro Pellicioli (Archivio personale conservato presso Associazione Giovanni Secco Suardo e fototeca Pellicioli) – , hanno permesso di ricostruire con precisione anche le vicende conservative del ciclo.
La prima informazione emersa dall’osservazione del supporto è l’uniformità: tutti sono composti da due tessuti di lino con un’altezza di circa cm 70-72. La scelta dell’armatura a tela e la sua fittezza rispondono ad una specifica finalità cioè la realizzazione di un supporto il più possibile liscio. Lo scopo dell’artista, quindi, potrebbe essere stato quello di ridurre lo spessore della preparazione per rendere i supporti più flessibili e per garantire una miglior adesione del colore, meno soggetto così alla formazione di crettature. Questi accorgimenti dovevano essere sicuramente bagaglio comune di una buona “bottega” perché si ritrovano anche nei teleri di Gentile Bellini. A quanto è stato finora verificato sulle opere sottoposte al restauro, il Carpaccio segna con una leggera incisione il limite della pittura, lasciando i bordi perimetrali con la tela a vista solo colorata di marrone o nero: fasce adeguate a essere
ripiegate per il tensionamento sul telaio o coperte dalla cornice. Le indagini chimico-stratigrafiche, eseguite preliminarmente su cinque micro-frammenti di materiale pittorico, hanno confermato la presenza di una sottile preparazione composta da gesso e colla animale con sopra una leggera mano di biacca stesa a tempera proteica, per rendere liscio e bianco il piano su cui riportare il disegno preparatorio. Le immagini riflettografiche in infrarosso rivelano un disegno preparatorio, eseguito a pennello, ben definito sia per la realizzazione dei volti, delle mani, dei panneggi e delle architetture, sia per comporre i piccoli oggetti, fini decori e le ombreggiature. I pigmenti tipici della tavolozza quattrocentesca sono stesi mediante due mani di colore, sfruttando trasparenze e mescolanze per schiarire o scurire le tonalità. Risparmiava il prezioso lapislazzuli per gli strati finali per rendere l’effetto bluastro sui mantelli dei monaci o per le tinte più intense del cielo. Per realizzare le decorazioni delle vesti, aureole, riflessi di luce non usa la foglia d’oro, ma sottili linee o piccoli tocchi corposi di colore giallo, con cui ottiene lo stesso effetto. Il legante sembra proteico, ma l’individuazione del materiale è ancora oggetto di studio. La sottigliezza e l’abrasione del colore ne rendono difficile l’indagine poiché non è possibile raccogliere del materiale non inquinato dai consolidanti applicati nei passati interventi di restauro.
La Vocazione di San Matteo
Solo uno studio preparatorio del volto di un discepolo e di alcuni dettagli è, ad oggi, ciò che si può riferire ad una fase iniziale di progettazione della Vocazione di San Matteo. Il disegno della Fondation Custodia di Parigi, ritenuto autografo, riporta nel recto il profilo di un uomo barbuto, vero e proprio studio preparatorio della figura del discepolo tra il volto di Matteo e quello di Cristo e nel verso i Tre studi con drappeggi, gamba e piede (1502-1508), da riferire allo studio del panneggio della gamba destra di Cristo, posta lievemente in diagonale per suggerire l’idea del movimento e quindi l’avvio del cammino fisico e devozionale. Il dettaglio del piede potrebbe inoltre collegarsi ad un disegno che ritrae lo stesso arto ancora privo di calzari, presente nella prima versione della scena, senza la lesena bianca in primo piano. La riflettografia in infrarosso ha rivelato alcuni particolari interessanti del modo in cui Carpaccio ha realizzato quest’opera. Gli studiosi hanno nel tempo riconosciuto nella composizione la presenza di due ritratti: il volto di profilo a sinistra di Matteo e quello di una figura, tra gli apostoli, caratterizzata da un naso aquilino. Il personaggio a sinistra dietro Matteo è stato aggiunto dopo l’esecuzione dell’edificio: il disegno preparatorio dell’architettura attraversa infatti il volto. L’immagine prima del restauro e soprattutto quella dopo la rimozione della vernice e dei ritocchi del Pellicioli del 1946, rivela una ridipintura molto antica che ricostruisce la parte superiore della testa, l’orecchio, parte del mento e del collo. Guido Perocco ha identificato il ritratto di profilo di Sebastiano Michiel, priore dell’Ordine di Malta di Venezia dal 1490 al 1503, nella veste di probabile donatore delle tele cristologiche. Seguendo le indicazioni dello storico, è corretto mettere a confronto il profilo della Vocazione di San Matteo con quello del committente, lo stesso Michiel, che si trova nella tavola del Battesimo di Cristo (1500-1504) attribuito a Giovanni Bellini, nella Chiesa di San Giovanni al Tempio del Priorato di Malta. Carpaccio definisce i caratteri del volto in maniera più approssimativa rispetto al Bellini: si deve però tener conto del cattivo stato di conservazione dell’incarnato, piuttosto abraso e oramai privo del film
pittorico di finitura. Durante il restauro si è scoperto che la ridipintura potrebbe essere una sovrammissione, non corretta, appositamente realizzata per coprire il capo calvo e le tempie dell’uomo, per renderlo non identificabile a seguito delle successive discordie tra il Priorato e la Scuola, ampiamente descritte nei documenti d’archivio. Lo stesso particolare del colletto della toga nera con il profilo bianco compare, inoltre, nella sua veste di priore gerosolimitano in entrambe le figure. Confrontando i due profili nelle rispettive immagini in infrarosso sembra plausibile che Carpaccio si sia servito dell’opera di Giovanni Bellini per eseguire il ritratto di Michiel o che entrambi abbiano utilizzato la stessa fonte.



Il profilo di una delle figure nel gruppo degli apostoli sembra essere stato aggiunto in corso d’opera: nell’immagine IR si nota anche quello di un vecchio calvo a sinistra e di uno retrostante appena visibile. È probabile che in una prima versione, in quel punto, vi fossero due volti, poi coperti dal personaggio con il naso aquilino, forse il Guardian Grande, come già indicato da Perocco, probabilmente Gregorio dalle Acque, il Gastaldo che il 24 aprile 1502 ricevette le reliquie di san Giorgio.
Anche a luce visibile, più chiaramente nell’immagine riflettografica, è facile riconoscere alcune modifiche dell’edificio a sinistra: il banco dell’esattore è stato dipinto prima interamente con sopra la piccola cassaforte, le ceste con i sacchetti e le monete sparse fino al vassoio ad imbuto; poi è stato creato una sorta di porticato, allungando la tettoia ed inserendo un pilastro sottile, passante in mezzo al tavolo. Sembra una costruzione incongrua, aggiunta con il solo scopo di mettere in piena vista, nella parte inferiore, uno stemma caratterizzato da due fasce di colore rosso e blu, simile a quello di Andrea Vendramin, cavaliere gerosolimitano e valoroso difensore di Rodi, senza la fascia in giallo oro nel mezzo. Al centro, Carpaccio progettò intenzionalmente il reliquiario con la medesima forma del porta reliquie di san Giorgio, come tutt’oggi appare. Lo stesso stemma è dipinto anche nell’Orazione nell’orto, sopra un libro, che costituisce un chiaro riferimento alla Mariegola, come già indicato da Perocco. Le indagini riflettografiche hanno infine permesso di esaminare nel
dettaglio la firma, «VICTOR CARPATH / IVS FINGEBAT */ MDII *», coerente con l’unica firma completa originale nel cartiglio della Visione di Sant’Agostino, sul quale è anche evidente l’incisione per definire lo spazio e l’altezza dei caratteri delle lettere. Anche nei cartigli dell’Orazione nell’orto, nei Funerali di San Girolamo e nel Battesimo dei seleniti le poche lettere leggibili, osservando nel dettaglio le immagini preliminari ad infrarosso, sembrano indicare la firma VICTOR CARPATHIVS, e non CARPATIVS VENETVS come finora riportato in vari testi, uguale quindi in tutte le opere del ciclo, differenziate solo, probabilmente, per la mancanza della data o del verbo. Con l’attuale restauro sono state rimosse la vernice imbrunita e le velature con le quali Pellicioli aveva coperto le diffuse lacune e le abrasioni della pellicola pittorica. Come è stato dimostrato in altri restauri da lui compiuti, nel conservare la patina o la vernice (originale o meno) si cela l’obiettivo di mantenere un equilibrio cromatico che prescinde dalle scelte operative. Con la rimozione della vernice, delle sostanze alterate e dei composti non adeguati, difficilmente ritrattabili per il loro progressivo degrado nel tempo, si è potuto ridare alla rappresentazione una più corretta lettura della lucentezza dei colori. Questi sembrano essere stati scelti sapientemente dal Carpaccio per rendere la preziosità del tessuto damascato (giallo di piombo e stagno di tipo I e verde rame) dell’abito di Matteo o creare effetti di luce e gradazioni tonali sulle vesti in lacca rossa di Cristo e di San Giovanni Evangelista, che, nonostante la scelta del medesimo colore, assieme al gioco di mani espresso o sottinteso sotto le tuniche, magistralmente rende spazio e movimento.
Nella Vocazione rimane comunque aperto il quesito in merito all’integrazione del profilo del probabile priore. Perciò si è deciso di conservare gli antichi rifacimenti che testimoniano un intervento molto antico, anche se di dubbia motivazione, antecedente anche all’intervento di Paolo Fabris del 1843 e correttamente mantenuto da Pellicioli. Valentina Piovan e Stefania Randazzo
«Così... porremo fine alla Seconda Parte di queste Vite, terminando in Luca come in quella persona che col fondamento del disegno e delli ignudi particolarmente, e con la grazia della invenzione e disposizione delle istorie, aprì alla maggior parte delli artefici la via all’ultima perfezzione dell’arte». (Giorgio Vasari, 1568)
Inevitabile sottolineare, attraverso le parole del Vasari, come Luca Signorelli (1450 – 1523) – Luca d’Egidio di Ventura il vero nome o Luca da Cortona – sia esattamente al centro della storia dell’arte italiana, straordinario innovatore della stagione rinascimentale. Si forma ad Arezzo nella bottega di Piero della Francesca, è al fianco di Perugino nella realizzazione della Cappella Sistina, la sua opera traccia la strada che sarà seguita da Raffaello e Michelangelo, i due Maestri che divenuti giganti finiranno per oscurarne la sua fama.

A 500 anni dalla sua morte, Cortona, sua città natale, ha realizzato la preziosissima mostra Signorelli 500. Maestro Luca da Cortona, pittore di luce e poesia, curata da Tom Henry, tra i massimi esperti al mondo dell’artista, ospitata a Palazzo Casali, sede del MAEC – Museo dell’Accademia Etrusca e della Città di Cortona, organizzata da Villaggio Globale International e aperta al pubblico fino l’8 ottobre.
L’eccezionale monografica offre l’occasione per riscoprire e riconoscere l’unicità dell’arte di Luca Signorelli, ripercorrendo puntualmente i 60 anni di carriera e di committenti famosi, tra cui munifici mecenati come Pandolfo Petrucci il Magnifico, Lorenzo de’ Medici, Papa Sisto IV e Papa Giulio II. Una trentina di opere dell’artista, provenienti da prestigiosi musei italiani ed esteri, compresi importanti prestiti da collezioni private e da oltreoceano, rendono manifesta l’incredibile forza del suo colorismo, la portata e l’originalità delle sue invenzioni tanto ammirate da Vasari, la potenza narrativa e immaginifica delle opere e la capacità che egli ebbe di andare oltre i suoi contemporanei, divenendo «un faro per i grandi del Rinascimento».
La mostra integra gli “Itinerari di Signorelli”, in città, in particolare al Museo Diocesano e nella chiesa di San Niccolò, e nelle località tosco umbre – una fra tutte Orvieto – custodi di importanti testimonianze del Maestro, come momento fondamentale di completamento del percorso espositivo.
«Quando per la prima volta a otto anni ho visto i quadri di Ligabue – racconta Nico Vascellari –, non ero interessato a cosa volessero significare. Ero tramortito da qualcosa che era già dentro di me e l’arte l’aveva tirata fuori… Melma… l’arte è questo per me».
A vent’anni di distanza dalla prima sua mostra realizzata proprio a Firenze il 25 giugno 2003, Nico Vascellari (1976, Vittorio Veneto) torna sull’Arno con MELMA al Forte Belvedere, intrecciando la dimensione personale a quella collettiva. È la prima volta che il Forte, nei suoi spazi interni ed esterni, viene occupato da un artista italiano della generazione di Vascellari con un progetto espositivo ambizioso e unico, curato da Sergio Risaliti, direttore del Museo Novecento, promosso dal Comune di Firenze e organizzato da MUS.E.
Una selezione di opere inedite, concepite appositamente per la mostra e realizzate con media e registri molto diversi tra loro, dalla performance alla scultura, dall’installazione al disegno, dal video all’esplorazione del suono, che offrono un’immersione totale nel lavoro di Vascellari, concentrato sulla relazione tra uomo e natura, tra esistenza e trascendenza, tra corruzione e rigenerazione.


«La Melma è una materia primordiale, qualcosa che cela la vista e proietta sull’ignoto, inteso sia come mondo interiore sia come tensione verso l’esterno» spiega l’artista. «Ho sempre parlato dell’arte come una pesca a mani nude nel fango, dove è possibile trovare ciò che non conosci ma che tenti di riconoscere. La Melma richiama per ognuno di noi qualcosa di pasticciato, paludoso, magmatico e “merdoso”, ma rimanda anche ad alcune mitologie per le quali tanto la foschia quanto la melma sono portali che permettono l’accesso al magico e al misterioso. A livello sensoriale, ricorda uno stato prenatale, perché è dalla terra, dall’humus, che viene plasmato l’umano». Lo sguardo antropologico di Vascellari, che si nutre di riferimenti al mondo arcaico, ai rituali e al folklore mescolati all’estetica underground, si traduce in un linguaggio estetico molto definito e unico nel suo genere. La mostra a Forte Belvedere è la prima parte di un percorso articolato che porterà Vascellari a ottobre in Piazza della Signoria e nei musei di Palazzo Vecchio e Museo Novecento in dialogo tra Rinascimento e contemporaneo. M.M.
Abituati ai romanzi (e alle serie) poliziesche, il titolo fa pensare subito ad un fitto interrogatorio, che in effetti, in questo caso, trattasi di quello alchemico tra artista e stampatore. Entrare nella Stamperia d’arte Albicocco a Udine, una delle più antiche d’Italia, è come varcare la soglia della creazione, dove la mente e il cuore dell’artista dialogano con il braccio e l’esperienza tecnica dello stampatore. Sinergia pura creata dalla composizione di azione e mediazione, tecniche tradizionali e energia creativa, bulini e punzoni, lastre e incisioni, acido e inchiostro, passaggi di colore e fissaggi, torchio e asciugatura, tutte “azioni” che portano alla realizzazione di incisioni e stampe d’arte, grafiche su carta “fatte a mano” come dicono i puristi, autentici lavori autografi a tiratura limitata. Acquaforte, acquatinta, puntasecca, carborundum, eredità del Rinascimento, vengono messe a dura prova da sperimentazioni estreme che alterano tecniche, inchiostri, strumenti, per raggiungere una nuova dimensione contemporanea dell’incisione. In piena era digitale Corrado e Gianluca Albicocco hanno stampato e stampano a mano per i più grandi artisti italiani e internazionali (Santomaso, Vedova, Zec, Kounellis, Isgrò e la nuova generazione di artisti come Velasco, Pizzi Cannella, Pignatelli, Petrus...). Affinità elettive che si creano e ricreano sempre come la prima volta quando arrivano nuovi artisti e progetti, dove essere contemporanei con tecniche antiche e tradizionali è una vera sfida contro l’estetica immateriale.
Marco Petrus non è nuovo all’arte della stampa grazie al padre, Vitale Petrus, protagonista della scena artistica lombarda degli anni Sessanta e Settanta, che lo spinge a interessarsi fin da giovanissimo all’architettura oltre che alle sperimentazioni riguardanti le tecniche di stampa e di riproduzione artistica. Si diploma al corso per assistente grafico dell’Umanitaria nel 1980 e al liceo artistico nel 1984, anno in cui si iscrive alla Facoltà di architettura al Politecnico di Milano, che frequenta per un breve periodo. Alla morte del padre, Marco Petrus apre una stamperia d’arte, che diverrà luogo di incontri e frequentazioni con altri artisti, preludio del suo esordio pittorico nel 1991 con una personale a Milano. Marco Petrus ha creato e ora messo in mostra proprio negli spazi della Stamperia di Udine opere qui realizzate. Time after time ripercorre infatti il sodalizio tra l’artista milanese e la Stamperia d’arte Albicocco: 20 opere calcografiche realizzate tra il 2003 ed il 2023. Architetture degli edifici milanesi, come la celebre Torre Velasca, visti da una prospettiva che porta il fruitore dell’opera ad osservare le realtà urbane attraverso un punto di vista inaspettato, sia estetico che “meditativo”. Il silenzio di queste realtà architettoniche in qualche modo prosegue con le opere più recenti, dove si evince una ricerca nuova, ancor più estraniata, quasi congelata, dove i rapporti cromatici diventano protagonisti con fasce di colore, linee, geometrie, che assumono nella sostanza del colore la forma delle architetture ormai astratta. M.M.












Extending along the waterfront on one of the most beautiful stretches of the Grand Canal, the splendid Gritti Terrace continues to be the social hub of Venice. Drop in from 12:30pm until 17:30pm for an informal lunch, afternoon snacks, or a glass of perfectly chilled bubbles immersed in a living canvas of the city’s legendary monuments.

FOR RESERVATIONS, PLEASE CALL +39 041 794611 OR VISIT CLUBDELDOGE.COM











Prosegue infaticabile il lavoro di Fabrizio Plessi, che quest’estate è protagonista di due importanti mostre a Brescia, al Complesso museale di Santa Giulia e a Milano, nella sala delle Cariatidi di Palazzo Reale.
Partendo da Brescia, che con Bergamo divide lo scettro di città capitale della cultura italiana nel 2023, Plessi sposa Brixia è un progetto site-specific pensato per l’area archeologica del Capitolium e per il Museo di Santa Giulia, un percorso immersivo e coinvolgente, di grande valenza scientifica e culturale, ad alto impatto visuale e di altissima perfezione tecnologica, formato da installazioni digitali, videoproiezioni e digital walls monumentali. Un viaggio che mette in evidenza le vestigia e il patrimonio di Brescia, riscrivendoli con l’alfabeto tecnologico e multimediale di Plessi, con la luce, il suono e le immagini in movimento.
Un’esposizione diffusa che ‘invade’ gli spazi del complesso museale di San Salvatore e Santa Giulia, il Capitolium e le Sale dell’Affresco, dove sono esposte la raccolta delle tavole di progetto del Maestro. È impossibile non provare un profondo senso di ammirazione e stupore per l’intensità dei lavori proposti da Fabrizio Plessi, così come si rimane incredibilmente colpiti dalla bellezza e ricchezza del patrimonio archeologico che si presenta allo sguardo del visitatore. La mostra prende le mosse in tempo di pandemia, quando Plessi ricevette dei volumi che descrivevano l’area di Santa Giulia a Brescia e dalla lettura di questi libri ne sono derivati moltissimi disegni, suscitati da un viaggio metacronico nella mente del Maestro, stimolati dal ricco giacimento archeologico della Brixia di epoca romana, una città del passato che si modifica, cambia, si liquefà per poi ricrearsi infinite volte, preziosa e luccicante come l’oro da cui è avvolta. C’è tuttavia tra tutte le opere di Plessi una che riesce a dialogare con l’infinito in maniera speciale: Floating Santa Giulia. L’artista diventa spirituale, coglie le sfumature drammatiche della Santa crocefissa con un’intensità che lo avvicina al mistero di una fede che non è esercizio di un credo religioso, ma è pura partecipazione all’umana sofferenza, con una delicatezza sottile e profonda che solo un gran-

de interprete può riuscire a raggiungere. Una scoperta continua tra stanze ricche di reperti archeologici in cui spiccano, al centro di una sala, delle colonne digitali che si sbrecciano lasciando colare l’oro, che è valore ma anche causa di cupidigia tra gli uomini, simbolo di civiltà e decadenza, in un comporre e scomporre che porta in sé la forza del divenire.

Nella sala delle Cariatidi di palazzo Reale a Milano, 80 anni dopo il bombardamento che ne squarciò le forme, lo stesso luogo scelto da Picasso nel 1953 per esporre il suo Guernica, si trovano dodici gigantesche barche in acciaio, lunghe nove metri, al cui interno si agita un mare d’oro: « Mariverticali. Tutto dunque è pronto per salpare su queste nuove elettroniche arche di Noè, innalzate al cielo per noi, increduli e stupefatti aborigeni-digitali del nostro tempo». Questo è l’incitamento del Capitano/Maestro, che dedica ai mari del Pianeta la sua installazione. Sono imbarcazioni inclinate al limite della caduta, esposte a ogni fragilità, che poggiano su specchi neri, a simboleggiare un’oscurità che ricorda le profondità degli abissi. Il mare d’oro che si agita all’interno delle barche vuole imprimere nelle mente e negli occhi del visitatore un messaggio: «nonostante la loro tenuta fragile gli oceani rappresentano la ricchezza del futuro». Con il loro precario equilibrio, le barche riportano alla metafora della condizione umana contemporanea, fatta di instabilità, incertezze e tensioni. Con il suo linguaggio Plessi riesce ad esprimere con forza ed emozione, messaggi collettivi urgenti, la sua arte non è nichilista, anzi al contrario: «Non bisogna mai smettere di sognare – afferma –, perché la vecchiaia comincia quando i rimpianti sostituiscono i sogni e io a 83 anni ancora sogno… non bisogna mai avere paura della grandezza dei sogni».
Fabio Marzari

La nostra Biennale Danza
2023, Altered States, vi invita dal 13 al 29 luglio ad alterare la vostra chimica interna, cambiare il vostro modo di essere attraverso l’esperienza della danza e della creatività di danzatori, coreografi, compositori e artisti per trasportarvi in un altrove lontano, insolito e profondo. Mentre ci prepariamo ad accogliere le informazioni sensoriali che i nostri corpi ci restituiscono minuto per minuto influenzando ogni nostra decisione, percezione, movimento ed emozione, affidiamo i nostri sensi al teatro affinché li dirotti e li solleciti, li stimoli e li arricchisca, li influenzi e li commuova.
E ora lasciamoci senz’altro trasportare da questa danza eccezionale oltre le parole, fuori dal mondo razionale e sempre più in contatto con questo sentire: i nostri personali Altered States.




Wayne McGregor (vedi intervista p. 14)
Il Leone d’Oro alla Carriera di Biennale Danza 2023 è stato attribuito a Simone Forti, una figura di artista visionaria ed innovativa abbastanza anomala anche nel panorama assai intrigante e ibridato della danza contemporanea. Perché Simone Forti rappresenta al meglio l’immagine dell’artista “senza confini”, che nell’arco della sua carriera sviluppatasi dalla seconda metà degli anni Cinquanta del secolo scorso, non è mai arretrata di fronte a nessuna spinta creativa che la portasse a mettere insieme movimento, improvvisazione, performance, voce, musica, oggetti, in uno sforzo totale di intrecciare discipline e atteggiamenti artistici. Come ha scritto Wayne McGregor nella motivazione del premio «…Simone Forti ha dato vita ad un corpus di opere – performance, disegni, film, video, fotografie, installazione e scritti – sorprendente per varietà e unico per capacità visionaria». Nata a Firenze nel 1935, a tre anni emigra coi genitori a Los Angeles a causa delle leggi razziali in Italia, e comincia a frequentare a San Francisco i Dancers Workshop di Anne Halprin, che allora iniziava ad elaborare un rigetto della tecnica e delle convenzioni della danza classica per approdare ad una danza di improvvisazione come parte dell’esperienza anatomica. Nasce qui la caratteristica fondamentale dell’arte di Simone Forti: quel suo rifuggire dalla dimensione della coreografia non solo della danza classica ma anche della modern dance allora in auge, a favore del movimento come espressione di un corpo pensante, che non sia solo espressione di vitalità biologica ma anche luogo di manifestazione del pensiero, e del logos. Fin dai suoi inizi artistici Forti, nel frattempo trasferitasi a New York dove viene introdotta al lavoro di John Cage, è affascinata dall’ibridazione tra danza e happening e già nel 1961, nel loft di Yoko Ono, propone una performance che unisce movimento ed oggetti, in una elaborazione di azioni quotidiane e semplici come correre, arrampicarsi, stare in piedi aggrappati a delle corde. Decisiva nel rivoluzionare il concetto di danza e movimento è la performance Dance Construction, che diventerà una specie di marchio dell’arte di Forti: i danzatori uniscono i loro corpi a formare una montagna che ciascuno di loro dovrà affrontare, superare e ridiscendere, in un tentativo incessante e romantico di affermare la natura individuale e collettiva, biologica e immateriale, del corpo che possediamo. Un altro momento decisivo nella carriera dell’artista sarà il suo soggiorno, dal 1968 al 1970, a Roma, dove diventa punto di riferimento della galleria L’Attico di Fabio Sargentini. Qui realizza Sleepwalkers, performance che nasce dalle sue visite allo zoo di Roma per catturare il movimento degli animali. Tra gli anni Ottanta e Novanta sviluppa una pratica improvvisativa che si fonda sulla relazione tra parola e movimento e crea le News Animations, ovvero la rappresentazione delle notizie del giornale attraverso il movimento corporeo.
Grazie alla collaborazione con il Museo d’Arte Contemporanea di Los Angeles (MOCA), durante il Festival sarà presentata l’inaugurazione europea della mostra Simone Forti, che celebra sei decenni di folgorante carriera dell’artista. Oltre alle sue Dance Constructions. che saranno eccezionalmente riproposte da un cast di artisti e creativi di Biennale College, verranno esposte all’Arsenale in Sala d’Armi opere su carta, video, ologrammi, ephemera e documentazioni sulle sue performance.
Con il Leone d’Oro a Simone Forti, Biennale Danza premia una grande artista, una donna curiosa, impertinente e geniale nella sua semplicità, ed un modello di creatività che ha informato di sé tutta la metà del secolo scorso. F.D.S.

The Venice Dance Biennale awarded the 2023 Golden Lion for Lifetime Achievement to Simone Forti, a visionary, innovative artist that is a quite peculiar character even in a world as intriguing and hybridized as modern dance. Forti represents the ideal image of the artist that knows no borders and whose art never took a step back in front of creative elan: motion, improvisation, performance, voice, music, objects… a total commitment to multi-disciplinarity. Born in Florence in 1935, Simone Forti moved to Los Angeles with her parents at three years of age after Italy enacted racial laws that targeted Jews. She later attended Anne Halprin’s Dancers’ Workshop in San Francisco. Halprin was working on the rejection of classical dance techniques and formality to elaborate a new kind of dance that integrated improvisation as part of an anatomical experience. This is where Simone Forti developed her own rejection of the choreographic dimension not only of classical dance, but of then-popular modern dance. In her eyes, motion is the expression of the thinking body, not only an expression of biological vitality, but a place where thought – logos – shows. In cooperation with the Los Angeles Museum of Contemporary Art, the Dance Biennale will host the European inauguration of the exhibition Simone Forti
S imone Forti
14-29 luglio
S ala d’Armi A, Arsenale

Un Leone d’Oro celebra i sessant’anni di carriera di Simone FortiSimone Forti © Jason Underhill, 2012. Courtesy of the artist and The Box LA
Fondata a Pechino nel 2008 da Tao Ye, Duan Ni e Wang Hao, TAO Dance Theater è la prima compagnia di danza contemporanea cinese invitata al Lincoln Center Art Festival di New York, all’Edinburgh International Art Festival, alla Sydney Opera House, al Théâtre de la Ville di Parigi e all’American Dance Festival, dove è stata anche in residenza. A Londra è invitata diverse volte dal Sadlers’ Wells, che le ha commissionato cinque lavori. Quest’anno la compagnia riceve il Leone d’Argento della 17. Biennale Danza.

«Tao Ye e Duan Ni hanno creato un genere di danza unica ed evoluzionistica che cattura con la sua forza ipnotica e minimalista. La loro compagnia […] è impegnata in un’estetica di ‘danza pura’, essenziale, che elimini ogni categorizzazione del movimento – scrive Wayne McGregor nella Motivazione – e, per estensione, di loro stessi. Il corpo viene presentato come elemento da percepire in quanto affascinante alla vista – privo di rappresentazione, narrativa, contesto: semplicemente esistente come oggetto. Esso viene amplificato solo dall’uso della luce e del suono, così da consentire agli spettatori di essere messi a confronto – e alla prova – con tecniche, vocabolario e forme rigorosamente focalizzate sul corpo.
È questa fiducia nel potere del solo movimento (sviluppato tramite il loro innovativo Circular Movement System ) con tutto il suo potenziale e la sua espressività latente, le sue sfumature, la sua eleganza, idiosincrasia, limiti e restrizioni che ci chiede di guardare e guardare ancora – di apprendere la sintassi nascosta e di ‘vedere’ davvero come se facessimo esperienza del corpo e della danza per la prima volta – in tutta la sua meraviglia spettacolare, eleganza e comunicatività diretta, viscerale, cinestetica.
TAO Dance Theater è una compagnia eccezionale, con una visione, una missione e uno scopo. Come i grandi della danza del passato, comprendono la vera natura del corpo quale “microcosmo dell’universo” e hanno individuato il loro territorio particolare da esplorare ed espandere. Immergersi qui, in questo territorio ignoto, è originale, importante ed edificante e noi veniamo allo stesso tempo avvolti e provocati dalla loro genialità». In totale accordo con le parole del direttore McGregor abbiamo voluto porre qualche domanda al fondatore della compagnia Tao Ye, in attesa di poterlo vedere all’opera sul palco.
Dalla sua fondazione TAO Dance Theater si è affermata a livello internazionale come nessun’altra compagnia cinese, andando a calcare i palchi più
prestigiosi del mondo. Su quali pilastri si fonda la filosofia di TAO Dance Theater?
In realtà il nome cinese di TAO Dance Theater è 陶身体剧 场, ovvero “TAO Body Theater”, la cui traduzione precisa è TAO “Teatro del Corpo”. La nostra idea è di tornare al corpo e dirigere tutta la nostra attenzione all’esplorazione del contesto corporale. Il corpo è sorgente di vita, viene dal passato, vive nel presente e si connette al futuro. È sincero, fragile e potente… Tutti i nostri modi di esprimerci possono trovare verità nelle azioni del corpo in uno spirito di infinita introspezione. Perché ci muoviamo? Come potrei muovermi diversamente da come faccio? Immaginiamo lo studio dei movimenti del corpo in modo caleidoscopico, verifichiamo la verità, combattiamo l’annichilimento. Danzo, dunque esisto.
In cosa consiste il Circular Movement System e perché avete scelto di adottare quest’approccio nella vostra pratica?
Noi vediamo il corpo come un’asse e il mondo come un cerchio. In questo modo possiamo generare infinite connessioni grazie al movimento che scorre lungo la curva. Il cerchio è sia un inizio che una fine e rivela che la danza deve esistere in un processo continuo. Nei nostri allenamenti quotidiani non usiamo specchi e i danzatori devono quindi rendersi conto dell’esistenza di ogni centimetro del loro corpo per mezzo dell’esercizio fisico. A questo punto la coscienza del cerchio diventa una continuazione di punti all’interno di un flusso curvo, come un’onda, e allo stesso momento è necessario guardare al di fuori e prestare attenzione allo spazio. Ogni minima parte si collega al corpo per ottenere un moto circolare, come una pennellata a mano libera sul corpo. Ogni minima parte è una pennellata per dipingere nello spazio e collegare il corpo a ogni momento, ogni frazione del tempo e dello spazio. È una ricerca di perfezione ed eccellenza e richiede che il danzatore sia costantemente attento e diligente, che conduca ogni movimento come se fosse una domanda, un atto di speculazione, e ogni movimento risponde alla seguente domanda: dov’è il corpo? In quale altro modo potrei muovermi? L’espressione del corpo diventa così ininterrotta e senza fine.
Founded in 2008 by Tao Ye, Duan Ni, and Wang Hao, TAO Dance Theater is the first Chinese modern dance company to be invited at the Lincoln Center Art Festival in New York, the Edinburgh International Art Festival, the Sydney Opera House, the Théâtre de la Ville in Paris, and the American Dance Festival, where they were also assigned a residency. This year the company received the Silver Lion of the 17th. Dance Biennale.
“TAO Dance Theater is an exceptional company of vision, mission, and purpose. Like the great dance makers of the past, they understand the very nature of body as a ‘microcosm of the universe’ and have found their special territory to explore and expand. Their deep dive here, in this unfamiliar territory is ingenious, significant, and edifying as we are simultaneously embraced and provoked by their brilliance”.
According to Dance Biennale Director Wayne McGregor McGregor’s words, we wanted to ask the company founder Tao Ye a few questions while waiting to see him at work on stage.
Since its inception in 2008, TAO Dance Theater became an international asset as no other Chinese company could, performing in the most prestigious international theatres. What philosophy does TAO Dance Theater follow?

The Chinese name of TAO DanceTheater translates to TAO Body Theater. Our idea is to return to the body and direct all attention to the exploration of the body context. The body is the source of life – it comes from the past, lives in the present, and connects to the future. It is sincere, fragile, and powerful. All our expressions can practise the truth through the actions of the body. This is a spirit of infinite self-view. Why move? How else can I move? Take the study of body movement as a kaleidoscope-like pursuit, verify the truth, fight against nothingness. I dance, therefore I exist.
We regard the body as an axis, and the world as a circle, generating infinite connections through movement flowing in curves. The circle is both a beginning and an end, and it reveals that dance should exist in continuous process. In daily training, there is no mirror in our space, and dancers need to observe the existence
of every inch of the body through exercise. At this moment, the consciousness of the circle becomes a continuation of points forming a wave-like curved flow. At the same time, it is necessary to look outside and pay attention to the space. Every inch connects with the body to achieve circular motion, like freehand brushwork on the body, every inch becomes a brushstroke, painting in space, connecting the body with every moment and every angle of time and space. This is a pursuit of perfection and excellence, which requires the dancer to be constantly aware and diligent, to make every movement a question like speculation, and the next movement to answer the question: where is the body? How else can I move? So that the expression of the body is continuous and endless.
You stated that persistence and ritual repetition can give an ultimate meaning to anything. In what ways can this happen, and does happen, in your work?
For me, there are no shortcuts in the world of dance. It is lightness against the weight of the body, and freedom by understanding the limitations of the body. The excellent expressiveness of the dancers on the stage comes from the dancers’ repeated polishing of the body day after day, facing the body directly with the body. Respond to perception with perception. I have always believed that the continuous movement and labor of dance can fight against the fragility of human nature and the barrenness of spirit, and an extraordinary sublimation can be obtained through the ultimate practice of the body. The road that seems to be the most difficult is often the shortest. For me, repetition is the road to sincerity and love.
What does being awarded the Biennale’s Silver Lion mean to you?
One of the most precious and best encouragements in our life.
At the Dance Biennale, we will see three pieces of yours taken from Series of Numbers: 11, a national premiere, and 13 and 14, European premieres. Why did you title them? What kind of experience will your Venetian audience enjoy?
I started the creation of “Numerical Series” in 2008 when I founded TAO Dance Theater. Over the last 15 years, I have com-
Ha dichiarato che la persistenza e la ripetizione rituale possono dare a tutto un significato ultimo. In che modo questo può accadere e accade nei vostri lavori?
Secondo me non ci sono scorciatoie nel mondo della danza. È leggerezza contro il peso del corpo e libertà che si acquisisce attraverso la comprensione dei limiti del corpo stesso. L’eccellente espressività dei danzatori deriva dalla cura che essi si prendono del proprio corpo giorno dopo giorno, corpo contro corpo. Rispondono a percezione con nuova percezione. Ho sempre creduto che i movimenti ininterrotti e lo sforzo della danza siano una lotta contro la fragilità della natura umana e l’aridità di spirito, una straordinaria sublimazione che può essere ottenuta tramite la miglior cura dell’esercizio fisico. La strada che sembra la più difficile è spesso la più breve. Per me la ripetizione è la strada che porta alla sincerità e all’amore.
Come ha accolto il Leone d’Argento assegnatovi dalla Biennale e cosa rappresenta questo riconoscimento per voi?
È uno dei più grandi onori e il più prezioso incoraggiamento che potessi ricevere.
Per Biennale Danza vedremo tre creazioni tratte da Series of Numbers, ovvero 11, in prima nazionale, e 13 e 14 in prima europea. Perché la scelta di non dare un titolo agli spettacoli? Che tipo di esperienza si deve aspettare il pubblico veneziano?
Ho cominciato a lavorare sulle mie Series of Numbers nel 2008, quando ho fondato TAO Dance Theatre. Negli ultimi 15 anni ho completato 13 pezzi di questa serie. Tutti i brani della serie vanno a formare un’opera che è l’infinita esplorazione del linguaggio del corpo. Penso che la danza sia un linguaggio primitivo; è più antica delle parole, è astratta e concreta. Uso i numeri come titoli per i miei lavori perché spero che danzatori e pubblico possano abbandonare ogni preconcetto e comunicare direttamente nel contesto del corpo. Se il corpo è l’unica ipotesi non ci sono limiti a ciò che possiamo vedere insieme. Mi auguro che in quest’epoca di folgorante esplorazione verso l’esterno, ci sia un’altra cosa su cui concentrarsi, ovvero il microcosmo interiore di ognuno di noi. È un mistero meraviglioso che vale la pena di scoprire per tutti.
La danza come cura. Cosa può donare la danza alla società contemporanea e come può l’essere umano trovarvi un rifugio dalla barbarie di un presente frenetico e annichilente?
La danza indica una delle più essenziali attività del corpo, non solo esterne ma anche interne. La danza attiva i sette sensi in modo completo: occhi, orecchie, bocca, naso, corpo, mente, tempo, che nel loro insieme in movimento permettono una comprensione approfondita del mondo e dell’esistenza. L’esperienza emotiva è insostituibile in quest’epoca di tecnologia avanzata e di svariate possibilità di intrattenimento. Tutte le persone danzano perché è l’unico modo in cui riescono ad esprimere ciò che provano. Il linguaggio corporale della danza è in grado di liberare un potere spirituale interiore. È sacro e coinvolgente. È come un dialogo con Dio. Ogni volta che entro nello spazio della danza è come se stessi uscendo dal mondo ordinario per entrare in una dimensione pura e innocente.
La danza sembra un’arte istantanea, ma io sono convinto che essa abbia un suo intrinseco potere, ossia che possa presentare un quadro completo della purezza assoluta racchiusa nella nostra vita. Indipendentemente dalla tensione, la danza può smuovere il tempo e lo spazio, riportarci all’inizio, sentire il futuro, capire il presente, in un momento che vale quanto l’eternità.
La vita potrà anche essere insignificante da una macroprospettiva, ma osservandola da una microprospettiva ciascuno di noi può trovare un significato per sé stesso.
pleted 13 works of the Numerical Series. All works of the series are completing one piece, which is the infinite exploration of body language.
I think dance is a primitive language, it is older than words, it is abstract and concrete. Naming dance works with numbers shows my hope that dancers and audiences can let go of all presuppositions and communicate directly with the context of the body. Facing the proposition of ‘body’, we can peek into a more infinite possibility together. I hope that in this era of dazzling outward exploration, there is another home that can be focused on, which is everyone’s own inner microcosm. It’s a wonderful mystery worth discovering by everyone.
Dance as cure. What can dance give to modern society, and can we find, in dance, solace from the inhumanity of a frenzied, nihilistic present?
Dance points to the most essential activity of the body –not only external, but also internal. Dance activates the seven complete senses of the body. Eyes, ears, mouth, nose, body, mind, and time can give people a deeper understanding. Emotional experience is irreplaceable in this era of diverse technology and entertainment possibilities. People often dance because they can’t express what they feel any other way. The body language of dance just releases this deeper spiritual power. It is immersive and sacred. It’s like a dialogue with God. Whenever I enter the dance space, I feel like I’m getting out of the ordinary world and gaining a pure and innocent experience.
Dance seems to be an instant art, but I always firmly believe that dance still has a power, that is, it can present the full picture of absolute purity engraved in life. Dance can stir up time and space at this moment, bringing us back to the beginning, Feel the future, understand the present, this moment is eternity. Maybe life is meaningless from a macro perspective, but from a micro perspective, we can give ourselves meaning.
Immaginiamo lo studio dei movimenti del corpo in modo caleidoscopico, verifichiamo la verità, combattiamo l’annichilimento.
Danzo, dunque esisto
Jacques Offenbach
direttore Antonello Manacorda regia Damiano Michieletto
nuovo allestimento Fondazione Teatro La Fenice in coproduzione con Sydney Opera House, Royal Opera House of London, Opéra de Lyon
24, 26, 28, 30 novembre, 2 dicembre 2023 / Teatro La Fenice
Giacomo Puccini
direttore Stefano Ranzani regia Francesco Micheli
allestimento Fondazione Teatro La Fenice nel 100° anniversario della morte di Giacomo Puccini
2, 4, 6, 8, 10 febbraio 2024 / Teatro La Fenice
Wolfgang Amadeus Mozart
direttore Robert Treviño regia Damiano Michieletto
allestimento Fondazione Teatro La Fenice
16, 17, 18, 19, 21, 22, 23, 24, 25 maggio 2024
Teatro La Fenice
Giacomo Puccini
direttore Francesco Ivan Ciampa regia Cecilia Ligorio
allestimento Fondazione Teatro La Fenice
nel 100° anniversario della morte di Giacomo Puccini
30 agosto, 3, 8, 14, 18 settembre 2024 / Teatro La Fenice
LIBERAMENTE ISPIRATO ALLE QUATTRO STAGIONI DI VIVALDI
Antonio Vivaldi e Giovanni Antonio Guido
coreografia Thierry Malandain direttore e violino Stefan Plewniak
Malandain Ballet Biarritz
nuovo allestimento Fondazione Teatro La Fenice in coproduzione con Opéra Royal de Versailles, Festival de Danse de Cannes, Opéra de Saint-Etienne Teatro Victoria Eugenia, Ballet T Ville de Donostia San Sebastian, Malandain Ballet Biarritz
10, 11, 12, 13, 14 gennaio 2024 / Teatro La Fenice
Ottorino Respighi
direttore Manlio Benzi regia Pier Luigi Pizzi
nuovo allestimento Fondazione Teatro La Fenice
8, 10, 12, 14, 16 marzo 2024 / Teatro Malibran
Antonio Vivaldi
direttore Diego Fasolis regia Fabio Ceresa
nuovo allestimento Fondazione Teatro La Fenice
7, 9, 11, 13, 15 giugno 2024 / Teatro Malibran
Luigi Nono
Arnold Schönberg
direttore Jérémie Rhorer regia Daniele Abbado
nuovo allestimento Fondazione Teatro La Fenice nel 150° anniversario della nascita di Arnold Schönberg e nel 100° anniversario della nascita di Luigi Nono 13, 15, 17, 19, 22 settembre 2024 / Teatro La Fenice
Gioachino Rossini
direttore Renato Palumbo regia Bepi Morassi
allestimento Fondazione Teatro La Fenice
26, 28 gennaio, 1, 3, 7, 9, 11, 13 febbraio 2024 Teatro La Fenice
Arrigo Boito
direttore Nicola Luisotti
regia Moshe Leiser e Patrice Caurier
nuovo allestimento Fondazione Teatro La Fenice
12, 14, 17, 20, 23 aprile 2024 / Teatro La Fenice

Richard Strauss
direttore Markus Stenz
regia Paul Curran
nuovo allestimento Fondazione Teatro La Fenice in coproduzione con Fondazione Teatro Comunale di Bologna
21, 23, 25, 27, 30 giugno 2024 / Teatro La Fenice
Gian Francesco Malipiero
direttore Francesco Lanzillotta regia Valentino Villa nuovo allestimento Fondazione Teatro La Fenice
31 ottobre, 3, 5, 7, 9 novembre 2024 / Teatro Malibran
Pierangelo Valtinoni
OPERA PER LE SCUOLE
direttore Marco Paladin regia Gianmaria Aliverta
allestimento Fondazione Teatro La Fenice
18, 19, 20, 24 gennaio 2024 / Teatro Malibran
Studenti di composizione del Conservatorio Benedetto Marcello di Venezia
OPERA PER LE SCUOLE
direttore Luisa Russo regia Emanuele Gamba
Orchestra e Coro del Conservatorio Benedetto Marcello di Venezia nuovo allestimento Fondazione Teatro La Fenice in collaborazione con Accademia di Belle Arti di Venezia prima rappresentazione assoluta
18, 19, 20, 21 aprile 2024 / Teatro Malibran

Abbiamo avuto il piacere di intervistarla due anni fa, in occasione di Biennale Danza 2021, quando le è stato conferito il Leone d’Argento e ha presentato in prima nazionale il suo Hard to Be Soft – A Belfast Prayer, primo lavoro importante del 2017, che l’ha catapultata al successo internazionale, in cui ha saputo ha catturato l’energia e le atmosfere della sua città natale con originalità, affetto e vitalità. «Danzare è una sorta di preghiera per me, che coinvolge anima e corpo. E quando sono sul palcoscenico mi sento in preda ad un’energia che non so dire esattamente da dove provenga – ci aveva rivelato Oona Doherty durante l’intervista –, forse dall’atto stesso del pubblico che guarda una persona che danza. È come se il teatro fosse una parte infinitesimale del rituale liturgico. Quando ballo è come se venissero fuori tutti i miei fantasmi in una sorta di processo catartico; forse però non sono solo i miei fantasmi, ma anche quelli del mio lignaggio, dei miei antenati. Anche se non sono un sacerdote e tantomeno uno sciamano, talvolta la danza mi fa sentire come se fossi portatrice di un messaggio proveniente da un mondo ignoto». Per Altered States la coreografa nord-irlandese è stata invitata con Navy Blue, creazione più ampia e inquietante, commissionatale dalla stessa Biennale e coprodotta con Kampnagel International Summer Festival, Sadler’s Wells, Théâtre National de Chaillot, Maison de la Danse di Lione, Belfast International Arts Festival, The Shed and Big Pulse Dance Alliance, che raccoglie Dance Umbrella, Dublin Dance Festival, Torinodanza Festival, Julidans. Una rete di altissimo profilo a riprova del grande interesse internazionale riscosso dal nuovo lavoro di Doherty. Ambientato in una fabbrica, luogo opprimente che evoca la catena di montaggio, dove 12 danzatori in tuta da lavoro si muovono all’uni-
sono, Navy Blue è un’ode frastagliata alla crudeltà e all’inutilità della vita. Una storia viscerale sulla nostra insignificanza di fronte all’enormità dell’universo: «noi piccoli punti in piedi sul nostro punto blu, che lottano tra loro per essere momentanei protagonisti di una frazione di un fottuto punto» dice la voce di Doherty fuori campo.
I danzatori, prima disposti in un’unica linea e poi nello spazio, eseguono i passi sulle struggenti note del Concerto per pianoforte e orchestra n. 2 in do minore di Rachmaninov, lasciando immaginare un adagio neoclassico ma, dopo poco, colpi di pistola alla Squid Game punteggiano il lussureggiante romanticismo del brano. Ora il sottofondo è la voice over della coreografa che, continuando l’analisi sulle disuguaglianze sociali, sui ruoli di classe e di genere, recita un testo scritto a quattro mani con l’autore, attore e regista Bush Moukarzel, ispirandosi al Pale Blue Dot dell’astronomo Carl Sagan.
«Niente verrà a salvarci da noi stessi, quindi sì, ne prendo un doppio», dice Doherty mentre la colonna sonora del dj e producer londinese Jamie xx, con sintetizzatori gonfi, percussioni melodiose e infine terrore puro, accompagna il crescendo drammatico della coreografia fino all’estrema danza del panico dello spettacolare assolo di Amancio Gonzalez.
«Ci inarchiamo nel nero galattico dello spazio profondo. Disseminato di stelle cadenti, con corpi che squarciano il cielo notturno di un profondo blu acrilico. Questo è un inchino alla danza – scrive Doherty in una nota –, questa è una domanda su cosa fare dopo». E conclude lo spettacolo dicendo: «Uscirò da questo teatro, e voi uscirete da questo teatro, e faremo cose insignificanti ma quelle cose, grazie a Dio, conteranno».
We had the pleasure of meeting Doherty two years ago, for the 2021 Dance Biennale, when her Silver Lion-awarded Hard to Be Soft – A Belfast Prayer had its Italian premiere. For Altered States, the Irish choreographer will present the international co-production Navy Blue, a larger-scoped, eerie creation commissioned by the Biennale. Set in a factory, a looming environment that reminds of production lines where twelve dancers, clad in workers’ overalls, dance in unison, Navy Blue is a sort of ode to the cruelty and uselessness of life. A visceral story of our meaninglessness compared to the vastness of the universe. “Nothing’s coming to save us from ourselves, so aye, I will have a double,”says Doherty’s voice, out of field. The dancers are first arranged in a single line, then scatter all over, and perform their routine on the notes of Rachmaninoff’s Piano Concerto No. 2 in C, which will make us think of a neo-classical adagio at first, but Squid Game -like gunshots soon transport us into the piece’s lush romanticism. The background is the choreographer’s own voice, debating social inequality on a text co-written with Bush Moukarzel and inspired by Carl Sagan’s Pale Blue Dot
Nata a Napoli, classe 1987, Luna Cenere si diploma in danza contemporanea nel 2009 e al termine dei suoi studi è già coinvolta nella scena artistica della città con diversi progetti fino al 2011, quando lascia l’Italia per proseguire la formazione presso la SEAD, Salzburg Experimental Academy of Dance, dove consegue la laurea, trasferendosi poi nel 2014 in Belgio. In quegli anni frequenta festival internazionali come Deltebre Danza, Impulstanz e la Biennale di Venezia e studia con maestri come David Zambrano, Francesco Scavetta, Martin Kilvady, Josef Frucek, Linda Kapetanea e Matej Kejzar tra gli altri. Partecipa alle creazioni di Anton Lacky e Josef Frucek e nel 2014 lavora con Simone Forti e Lacky. Si unisce nel 2016 alla Compagnia Virgilio Sieni impegnandosi in progetti come La Mer e Il Cantico dei Cantici, mentre nel 2017 lavora al film di Mario Martone Capri Revolution con la direzione coreutica di Raffaella Giordano. Attualmente ha intrapreso una personale ricerca artistica che la conduce simultaneamente verso impegni come interprete per coreografi quali Sieni, Jean Abreau, Leonardo Diana e Elio Gervasi.
Luna Cenere vince la seconda edizione del bando italiano della Biennale Danza per una nuova coreografia con il progetto Vanishing Place : un luogo in cui il tempo, inteso nella sua evanescenza, si genera e si perde, come le emozioni del presente e la memoria. Un paesaggio in movimento fatto di corpi, gesti e immagini dai contorni sfumati, inafferrabili, in cui ogni azione manifesta custodisce in sé il suo contrario, la sua stessa assenza: uno spazio surreale in cui il tempo è sottratto a sé stesso.

Attingendo all’immaginario di artisti quali Ren Hang, Evelyn Bencicova e AdeY, «Luna Cenere – scrive il direttore McGregor – continua la sua ricerca sul corpo, la postura, l’oggetto e il gesto, mettendoli in sorprendente dialogo tra loro. Vanishing Place, la sua nuova ‘installazione’ coreografica, spinge questa conversazione in una direzione fresca e inaspettata, indagando che cosa significhi danzare e che cosa la danza possa diventare in futuro…».
Ispirata fin dalla sua prima creazione – l’assolo Kokoro – dal testo The Invisible Actor di Yoshi Oida e Lorna Marshall, Luna Cenere s’interroga su cosa sia il corpo in scena: «Volevo che diventasse altro, che non fosse solo corpo antropomorfo, ma memoria collettiva, suggestione nello spettatore, elemento paesaggistico in cui ognuno vede qualcosa. Il corpo nudo può astrarsi, soprattutto quando elimini il rapporto frontale con lo spettatore. Se elimini il volto, il genere, si esprime la persona».
ENG B orn in Naples, Italy, in 1987, Luna Cenere has been working in her hometown until 2011, when she left Italy to further her education at the Salzburg Experimental Academy of Dance. Cenere then moved to Belgium in 2014. In 2016, she joined the Virgilio Sieni Company to work on such projects as La Mer and Il Cantico dei Cantici. This year, Luna Cenere won the second edition of the Dance Biennale Choreography competition with her Vanishing Place, a place where the evanescence of time generates and dissipates like the feelings of the presents and memory. We will be looking at a moving landscape made of blurred, undefinable bodies, gestures, images, where each visible action bears the essence of its opposite and its absence: a surreal space where time is subtracted from itself. Cenere drew inspiration from The Invisible Actor by Yoshi Oida and Lorna Marshall since her first creation, a solo piece named Kokoro. In her words: “I wanted the body to become something else – not only an anthropomorphic shape, but a collective memory, a suggestion for the audience, a landscape element that everybody can interpret differently. The naked body can sublimate: if you cross out faces and genders, that’s where the person shines out.”
Luna Cenere vince la commissione italiana per una nuova creazioneVanishing Place © Stefano Mattea
Già Plinio il Vecchio nella storia di Butade Sicionio racconta come dal suo lavoro di artigiano di vasi d’argilla nacque la scultura con un atto d’amore per la figlia. Spesso si dimentica che la danza nasce anche come bisogno di compattare l’ordine sociale di una comunità, ed è qui che Andrea Peña si muove. Una rigorosa scelta di movimenti del corpo in uno spazio che diviene anch’esso protagonista, tra oggetti sempre significativi.
«Le cose hanno vita propria… si tratta soltanto di risvegliargli l’anima» raccontava lo zingaro Melquíades a José Arcadio Buendìa in Cent’anni di solitudine
Andrea Peña è giovane, colombiana di origine, ma immigrata presto in Canada. Ha lavorato con le prestigiose Ballet BC e Ballet Jazz di Montréal, ha conseguito un master in Industrial Design, e nel 2014 ha fondato la propria compagnia multidisciplinare AP&A (Andrea Peña & Artists).

Ha vinto il bando internazionale lanciato da Biennale Danza per una nuova creazione con il progetto, ora spettacolo, Bogotà, che vedremo in prima mondiale dal 13 al 15 luglio in Arsenale alle Tese dei Soppalchi. È stato un immenso piacere dialogare con lei.
Giustamente lei ha affermato che la tecnologia
è da sempre stata usata nella danza e nell’arte. Ricordo nel 1980 lo scalpore suscitato da Stelarc nella sua performance artistica; tutti i manager già in quegli anni studiavano body language e Watzlawick. Cosa vi è di veramente nuovo che la tecnologia può oggi offrire al mondo della danza?
Per me la tecnologia non è un mezzo che offre solo possibilità estetiche, ma un’intelligenza, ed è qui che trovo lo spazio per giocare ed elaborare quello che faccio. Penso alla tecnologia in termini di tékhne¯ , la cui radice filosofica è nel fare, nella pratica come forma di conoscenza, come forma di saper fare. In questa direzione tékhne¯ indica un tipo di intelligenza, una tecnica, una tecnologia presente nella nostra modalità di fare le cose; è questa definizione fluida e ibrida che informa il mio rapporto con
la tecnologia: per ristrutturare non l’apparato tecnologico ma il saper-come-fare di una tecnologia, cioè la sua intelligenza. Per questo mi incuriosisce usare la tecnologia nella danza come modo di rivelare l’intelligenza presente all’interno di un sistema.
Riconoscere che la tecnologia è per lo più occulta nella nostra società, riconoscere il modo in cui la danza e l’arte possono usare la tecnologia per squarciare il velo che la cela, mostrare le possibilità e la complessità interna di un apparato o di un sistema tecnologico è, in un certo senso, come smascherare la tecnologia per allontanarsi dalla semplice-bellezza. La semplice-bellezza è un’alterazione artificiale della bellezza che consumiamo nella società moderna e che ci impedisce di interagire con la complessità. Penso che la tecnologia possa offrire alla danza modi nuovi di pensare piuttosto che nuovi modi di rappresentare o di abbellire.
La sua ricerca Performing Digital Intimacies ci ha molto coinvolto e incuriosito. Ci può raccontare come si è svolto il progetto e come ha utilizzato questa ricerca nei suoi lavori?
Questo lavoro rappresenta uno di quei momenti preziosi che ci sono rivelati durante le restrizioni dovute alla pandemia. Sono stata invitata al PHI Center in collaborazione con Shared Studios per sviluppare un progetto di portali digitali dislocati in 24 città del mondo, in particolare a Montreal, Berlino, Ede, e Città del Messico. Questi portali per me rappresentano opportunità digitali di connessione attraverso il corpo. In un momento in cui molti coreografi lavoravano sul tradurre coreografie in film, io ero curiosa di usare questa tecnologia di streaming digitale come strumento per incontri umani e corporali. Mi interessava creare intimità in
We sometimes forget that dance answers society’s need for order and communality—that’s where Andrea Peña works. A rigorous, precise choice of body movements in a space that is as much a protagonist as the performer, with each item on stage being given meaning. “Things have a life of their own… all you need to do is to wake up their soul” said gypsy Melquíades to José Arcadio Buendía in One Hundred Years of Solitude. Andrea Peña is a young Colombian-Canadian choreographer. She worked with prestigious Ballet BC and Ballet Jazz of Montreal, is an Industrial Design graduate, and in 2014, founded her own multi-disciplinary company AP&A (Andrea Peña & Artists). Peña won the Dance Biennale’s international open call with her project and upcoming show Bogota, which will premiere on July 13 to 15 at the Arsenale in Venice. It was a pleasure to meet her.

You rightly stated that technology has always been used in dance and in the arts. I remember in 1980 the stir caused by Stelarc in his performance art; all managers already in those years were studying body language and Watzlawick. What is there that is really new that technology can offer the dance world today?
I personally see technology not as a medium that offers solely aesthetic possibilities, but as an intelligence, and this is where I find room for play and investigation within my practice. I think of the term technê, which has its philosophical root in craft, practice, as founded in the form of knowledge; as a form of “knowing-how”. Technê here denotes a type of intelligence, a technique, technology in the “how” we know, and it’s this fluid and hybrid definition that guides my relationship to technology, to reframe not the technological apparatus, but rather the “knowing-how” of a technology, (its intelligence). I’m thus curious to use technology within dance
as a way of revealing the intelligence inside of a system or a thing. Recognizing that technology is predominantly opaque in our society, how through dance/art do we use technology as a way to demask its opaque veil, and reveal the possibilities and internal complexities of an apparatus or technological system. In a way, de-masking technology to get away from smooth beauty. Smooth beauty is the artificial deceit of beauty that we are consumed by in our contemporary society, and which keeps us dormant in the possibility of our engagement with complexity. I think technology can offer dance new ways of thinking rather than new ways of representing or decorating.
Your research Performing Digital Intimacies has us very interested. Can you tell us how the project unfolded and how you have used this research in your work?
This work is really one of those precious moments that was revealed through the constraints of the pandemic. I was invited by the PHI center in collaboration with Shared Studios to develop a project in inflatable digital portals, located across 24 cities in the world, focused on Montreal, Berlin, Ede and Mexico City. These portals for me were digital opportunities for connection through the body. In a time when many choreographers were working on translating choreographic works on film, I was curious to use this digital streaming technology as a tool for bodily and human encounters.
I was curious about creating intimacy in a time where physical intimacy, new encounters and human connection were diminished. The New York Times released an article 36 Questions that Lead to Love, that would guide you and another person closer to each other. With the use of technology and code, I set up a system that would auto generate a selection from the thirty-six ques-
Il nostro obiettivo è affrontare l’ibridazione come luogo che lascia spazio alla possibilità di esplorare il ruolo della cultura all’interno di un’opera e le sue manifestazioni fisiche e materialiBogota - Photo Andrea Peña
un momento in cui l’intimità fisica, i nuovi incontri e le connessioni umane erano limitate. Il «New York Times» ha pubblicato un articolo dal titolo 36 Questions that Lead to Love, una guida per due persone che vogliono avvicinarsi l’una all’altra usando la tecnologia e la programmazione. Ho impostato un sistema che genera un estratto dalle 36 domande e le sottopone a uno dei due partecipanti, ciascuno in una città. I partecipanti devono poi rispondere in modo verbale o attraverso il movimento a uno sconosciuto dall’altra parte dello schermo. Stiamo parlando di schermi a grandezza umana che mostrano un’immagine a figura intera, nonché il suono dell’altra persona all’altro capo del mondo. Rispondere a queste domande intime, sia verbalmente che fisicamente, guidati dalle richieste di una voce algoritmica, ha permesso a due sconosciuti di conoscersi in un contesto di gioco digitale. Si è venuta a creare una connessione fisica ed emotiva tra gli artisti dell’AP&A a Montreal e gli sconosciuti di altre tre città. I partecipanti sono stati molto coinvolti in questa esperienza, dalla durata di trenta minuti: hanno giocato, riso, pianto e ballato insieme mostrando tratti della loro intimità a qualcuno che non conoscevano dall’altra parte del mondo. Per me questa ricerca è stata fondamentale nella sperimentazione di sistemi coreografici, in questo caso guidati da un algoritmo, che hanno dato partecipazione e spazio all’interpretazione individuale. È stato il mio modo di usare la tecnologia come intelligenza e di creare spazio per connessioni umane piuttosto che estetiche.
Nel suo monito a «Returning, individually and collectively, to our essence as humans» sembra implicito un punto di svolta: siamo veramente mai stati umani in un significato positivo o la violenza è da sempre connaturata nel genere umano?
L’artista coreografo, il creatore di performance, la danza in generale come possono intervenire e contribuire a questo ritorno?
Come esseri umani siamo fatti di opposti e sono questi opposti che ci permettono di capire la profondità e la risonanza di ciascuno di essi. Tuttavia, ci dimentichiamo di ritornare alla vasta gamma all’interno di questi opposti, poiché è proprio quello a renderci umani. Siamo costantemente avvolti in un artifizio e dimentichiamo le nostre vulnerabilità, umiltà, fragilità, purezza e insicurezze in quanto fondamentali elementi complessi che definiscono l’essere umano. Per me è qui che la pratica coreografica ancora mantiene un potenziale per rivelare che cosa ci rende umani. Gli artisti che si impegnano nel fare qualcosa permettono agli spettatori di vederli come veicoli di fragilità e vulnerabilità loro proprie e dell’umanità in generale. La pratica coreografica si risolve dunque nel tempo, nello spazio e nel movimento, per permettere al sacro e al profano presenti nell’umanità di coesistere nell’individuale e nel collettivo, sia dei danzatori che della comunità che si crea tra gli spettatori di questa forma di spettacolo. Mi piace molto il termine “pluriverso” ideato dal filosofo Félix Guattari, che indica la pluriversalità come un distacco dal nostro costruire un uni-verso e che ci porta ad una comprensione della coesistenza attraverso la pluralità. Laddove uni-verso indica un obiettivo unico verso la comunità, il pluriverso indica la capacità di più universi di coesistere. È qui che trovo lo spazio per nuova coreografia, lì dove il ruolo del coreografo può essere messo in discussione e dove questi lavori trovano spazio per esprimere la complessità piuttosto che la singolarità, dove uno spettacolo può essere visto come veicolo per un’esperienza di pluriverso che contiene armonia e molteplicità nella differenza tra gli stessi interpreti.

tions to one of the two participants, each in a city, and ask them to answer the question either verbally or through movement to the stranger on the other side of the screen. These were full body screens inside small inflatables that would stream a full view image and the sound of the other person across the globe. Answering these intimate questions both verbally and physically, guided by the commands of an external algorithmic voice, allowed two strangers to get to know each other in a context of digital-play. It was a physical and emotional connection between AP&A artists in Montreal and strangers across these three cities. People were extremely moved through the thirty-minute experience, they played, laughed, cried and danced together revealing pockets of their own intimacy to someone across the world. This research for me has been pivotal in the experimentation with choreographic systems, in this case guided by an algorithm, that give agency and space to the individual interpretation. It is my way of using technology as an intelligence that makes space for human connection, in this case, rather than an aesthetic.
In your admonition to “Returning, individually and collectively, to our essence as humans” a turning point seems implicit: have we really ever been human in a positive, or has violence always been inherent in humankind? The artist choreographer, the performance creator, dance in general how can they intervene and contribute to this return?
As humans we are built from polarities and it’s these polarities that allow us to understand the depths and resonance of each, however we forget to continuously return to the vast range within these polarities as that which makes us human. Constantly wrapped
in artifice, we forget our vulnerability, humility, fragility, resilience, purity and insecurities as the complex core elements that define human. For me that’s where the choreographic practice holds potential to reveal that which makes us humans. Artists who bring themselves to a work, allow an audience to witness them as vessels of their own and a larger human fragility and vulnerability. The choreographic practice then is about carving practices of time, space and movement to allow for the sacred and profane of humanness to co-exist within the individual and collective of the performers as much as the community that is created with each public who witnesses and share the experience of the work.

I am fascinated with the term pluriverse, by philosopher Felix Guattari, who offers pluriversality as a departure from our desire to construct a uni-verse towards an understanding of coexistence through plurality. Where uni-verse denotes a singular goal towards commonality, pluriverse denotes the capacity for plural or multiple universes to co-exist. It’s here where I find choreography has room to shift, where the role of the choreographer has room to be challenged and questioned. Where works have the space to engage with making space for complexity rather than singularity. Where a piece can be seen as a vessel for the pluriverse experience that contains a harmony of multiplicity through difference within the interpreters themselves.
In my works we attempt to investigate not emotions but rather sentiments, as the attitudes towards emotions, places where we can contain not a singular emotion like melancholy, joy, desire but rather the physical and lived states of these emotions as visceral layered experiences that contain multiple emotions at once. A pluriversal state of sentiments and perspectives shared through the varied perspectives of each interpreter.
In addition to being a dancer and choreographer you are also an industrial designer. How can dance and design mutually benefit from this fusion?
I’ve started to consider myself as a movement designer. In trying to encapsulate what I do, I realized that the hybrid and merge of choreography and design is at the axis of the ways AP&A makes work. For many years I was negotiating these two practices in trying to understand how they could have a conversion, and it was through my Masters of Design, that I began to carve a written practice to understand the relationship of both, and like you suggest how they mutually benefit.
Choreography greatly benefits from this immersion within design, as it no longer becomes (for me) about a choreographic ideal as in clear delineation in the body within a choreography that can be replicable but rather I see myself as a choreographer or I would add designer of movement frameworks that guide an interpreter towards their choreographic expression. Design offered me the ability to see systems rather than the fixed form, interrelations rather than representation, and process as an iterative laboratory with tools to think of the work across various mediums and brainstorming platforms. Design has allowed my choreographic practice to be a practice of facilitating the harmony between all the mediums. On the other hand, I think design has the most to learn from choreography. My masters studies the choreographic gestures that are imposed on our bodies through the built environments
Nelle mie opere cerco di investigare non solo le emozioni, ma piuttosto i sentimenti come atteggiamenti verso le emozioni; “luoghi” in cui non è contenuta un’unica emozione come la malinconia, la gioia o il desiderio, dove anche lo stato fisico è il vissuto di queste emozioni come esperienze viscerali e stratificate fatte di più emozioni unite insieme. Uno stato pluriversale di sensazioni e prospettive condivise nelle diverse prospettive di ciascun interprete.
Oltre che danzatrice e coreografa lei è anche designer industriale. In che modo danza e design possono vicendevolmente beneficiare della loro possibile interazione?
Ho cominciato a considerarmi una designer del movimento. Cercando di definire quello che faccio, mi sono resa conto che l’ibridazione e la congiunzione di coreografia e design è l’asse su cui lavora AP&P. Per molti anni ho cercato di bilanciare queste due pratiche e provato a capire come potesse esserci una sorta di conversione, ma è stato dopo aver preso un master in design che ho cominciato a usare la scrittura per capire la relazione tra le due discipline, quindi il modo in cui possono beneficiare l’una dell’altra.
La coreografia trae grande beneficio da questa immersione nel mondo del design poiché non aspira più, almeno per me, a un’ideale coreografico in chiara definizione rispetto al corpo. Vedo me stessa come coreografa o, direi, designer di strutture di movimento che guidano un interprete nella sua propria espressione coreografica.
Il design mi ha offerto la capacità di vedere sistemi invece che forme fisse, interrelazioni piuttosto che rappresentazioni, e di processare il tutto in un laboratorio interattivo con strumenti per pensare al lavoro così come può essere riversato in media differenti. Il design ha permesso alla mia pratica coreografica di diventare una pratica di facilitazione dell’armonia tra più tecniche. D’altro canto, penso che il design possa anch’esso imparare molto dalla coreografia. Il mio master studia i movimenti coreografici che sono imposti sui nostri corpi attraverso l’ambiente costruito che abitiamo. Esso guarda al designer industriale come a un coreografo che non progetta sul corpo, ma utilizzando parametri coreografici compresi nella forma, nella funzione e nell’uso di un oggetto. Penso che il design abbia molto da imparare dalla storia delle pratiche incorporate e somatiche, che hanno studiato non solo il rapporto del corpo con il tempo e lo spazio, ma anche la singolare espressione del corpo visto come organizzazione di movimenti. È qui che il design mostra i suoi limiti: ci siamo dimenticati di osservare, mettere in discussione e risolvere il problema di come il design possa alterare e limitare l’espressione del corpo.
Nata in Colombia e trapiantata in Canada, lei è un’artista necessariamente di frontiera. Secondo lei ha ancora senso oggi nel mondo della danza parlare di identità culturale connessa alla radice territoriale nativa o quest’ultima è stata fagocitata dalla multiculturalità?
Viviamo in tempi post-coloniali, uno spazio che è stato ricavato per rivedere la storia e interagire con nuovi futuri immaginari. Penso che anche il nostro ideale di cultura e i modi in cui ci relazioniamo ad essa stiano cambiando. Per quanto riguarda l’arte post-coloniale sono molto interessata alle pratiche di costruzione del futuro che artisti di culture marginalizzate usano per reimmaginare i loro passati personali e ancestrali e per creare nuovi futuri. Penso a pratiche
come futurismo indigeno, afrofuturismo, chicanofuturismo e altre ancora. Queste pratiche deformano il tempo e lo spazio tra l’ancestrale e il futuro per dare senso alla modernità. Penso che se interagiamo con un po’ di umiltà con più culture allargheremo la nostra capacità di interagire con la complessità. Come artista biculturale di parziale estrazione colombiana, che vive in Canada e lavora all’estero, sono colpita e ispirata dalla nozione di ibridazione. Come può l’ibridazione fare spazio a tutto ciò che sta nel mezzo? In realtà l’ibridazione può essere una nuova forma di umanità, dal momento che tutti noi abbiamo alle spalle lignaggi complessi, mutazioni che creano nuovi ibridi.
Fa parte del nostro ruolo imparare a interagire continuamente con l’ampia gamma di lavori artistici che appartengono alle culture dell’identità. Ci sono culture che vivono nella periferia e altre che vivono al centro: in che modo possiamo fonderle e metterne in discussione le divisioni? Dissolvere la polarità tra centro e periferia? Ci sono temi su cui lavoriamo molto con gli altri artisti alla AP&A: come trasformare la periferia in centro, come decentralizzare il centro stesso?
Il nostro obiettivo è affrontare l’ibridazione come luogo che lascia spazio alla possibilità di esplorare il ruolo della cultura all’interno di un’opera e le sue manifestazioni fisiche e materiali. Molte, molte domande... ci sono più domande che risposte!
Bogota. Lo spettacolo con cui ha vinto il bando internazionale per una nuova coreografia evoca il Realismo magico alla Marquez della sua terra d’origine, la Colombia. Come è nata e cosa racconta questa creazione che il direttore McGregor definisce “radicale e innovativa”?
Bogota è un lavoro ispirato dalla complessa storia della Colombia. È un’opera che prende questa storia e la pone nella sensazione universale dell’oggi. È la prima volta che porto la mia storia personale come fonte creativa in un lavoro alla AP&A e per me è un dono avere la possibilità di rivisitare la conoscenza ancestrale della mia gente e mettere in discussione che posto abbia e che rappresentazione abbia nella società contemporanea. Per me il Realismo magico è diventato uno strumento per esplorare il farsi futuro dell’ancestrale all’interno della moderna era post-industriale e post-umana. Giochiamo con la spiritualità, l’immaginario, le storie, le tradizioni come pratiche e idee per creare e sviluppare nuovi universi che riflettono versioni alternative, critiche e più vulnerabili del nostro Realismo magico. In Bogotá il Realismo magico prende forma nella scenografia industriale abbandonata ricreata sul palco (ponteggi, rinfuse, lampade e altoparlanti ammucchiati) nei costumi e nello stile di ogni artista (ciascuno ispirato dalla fusione di leggende colombiane e creature di sottoculture contemporanee) e si integra nel sistema coreografico e nel simbolismo dei corpi dei danzatori (sirene, personaggi in stile barocco queer, figure precolombiane, figure tratte dal mondo dell’attivismo politico). Il tutto interrogato da una prospettiva queer, attraverso corpi queer. Quest’opera non è interpretata o creata da artisti colombiani, ma canadesi-libanesi, afroamericani, francesi, indigeni, asiatici, russi… Artisti che portano le loro ricche storie e individualità come luogo di incontro all’interno delle idee che informano l’opera stessa. Con questo lavoro gli interpreti si offrono umilmente come veicoli per far spazio alla possibile riconciliazione della popolazione colombiana e all’espressione delle forme ancestrali colombiane di oggi.
we inhabit. It is looking at the industrial designer, as a choreographer, that does not directly choreograph onto the body but does so through the choreographic parameters embedded in the form, function and utility of an object. I think here design has much to learn from the history of embodied and somatic practices, that have been studying not only the body’s relationship to time and space, but to the singular expression of a body through an organization of movement. Here is where design has fallen short, we have forgotten to observe, question and address how a design might alter and limit the expressibility of the body.
Born in Colombia and transplanted to Canada, you are a bi-cultural artist. In your opinion, does it still make sense today in the dance world to talk about cultural identity or has the latter been engulfed by multiculturalism?
As we find ourselves in postcolonial times, a space that has been carved to revisit history in order to engage with the imaginary of new futures, I think we are also shifting the ideal of culture and finding new ways to anchor within it. Within postcolonial arts practices I’m very interested in the futuring practices that artists from marginalized cultures engage with as forms of re-imagining their personal and ancestral past in order to create new futures, practices such as Indigenous Futurism, Afrofuturism, Chicanafuturism.. and more. Practices that warp time and space between the ancestral and the future, as was of making sense within our current epoch. I believe if we commit to a humble engagement with multiplicities of cultures we stretch our capacity to engage with complexity. As a bi-cultural artist with indigenous Colombian heritage, situated in Canada and working overseas, I’m humbled and inspired by the notion of hybridity. How can hybridity make space for everything that is in between? Hybridity as a new form of human, as we all carry complex lineages, as mutations that create new hybrids.
Within dance and the performing arts, there is a vast spectrum of work within “the cultural” of identity. I think it’s our role to learn to continuously engage with this spectrum as ways of blending the conversations between the center and the periphery. There are still cultures who lie in the periphery, and those who lie in the center. How can we blend, merge and challenge these divides
in order to dissolve the polarity between the periphery and the center? These are themes we work on a lot with the artists of AP&A. How to make the periphery the center? How to de-center the center? We aim to engage with hybridity as a place that makes room for possibility to explore the role of culture within a work and its physical and material manifestations. Many, many questions... I’ve always figured: “more questions than answers!”
Bogota. The show with which you won the international call for a new choreography evokes the Marquez-style Magic Realism of your homeland, Colombia. How did it come about and what does this creation, which director McGregor calls “radical and innovative”?
Bogota is a work inspired by Colombia’s complex history, but one that takes this history and situates it in universal sentiments of today. Bringing for the first time to a creation of AP&A’s my cultural heritage as the source, it has been a gift to return and revisit the ancestral knowledge of my people, and question what is its place and representation in our contemporary society today. Magical realism became for us a tool to explore the futuring of the ancestral within the post-industrial and post-human epoch of now. We are playing with spirituality, imagery, tales, traditions as practices and ideas to create and develop new universes that reflect alternative, critical and more vulnerable versions of our own? Magical realism in the work of BOGOTÁ, takes shape across the barren industrial scenography on stage (scaffolds, industrial bags, piles of lamps and speakers); in the costumes and styling of the artists (each inspired by merging mythical Colombian tales and creatures with contemporary subcultures); and interwoven into the choreographic systems and symbolism held within the performers bodies (ie. mermaids, queer baroque, pre-Columbian figures, political statements). All interrogated from a queer-ing perspective, through queer bodies. The work is not performed or created by Colombian artists, but rather Canadian-Lebanese, African-American, French, First Nations, Asian, Russian, artists who bring their rich histories and unique singularities as a meeting place within the ideas of the work. Through this work they humbly offer themselves as vessels that make space for the healing of Colombian peoples and the expression of Colombian ancestral forms of today.

Nato nella contea di Longford, il coreografo irlandese Michael Keegan-Dolan ha fondato nel 1997 e poi portato all’apice del successo il Fabulous Beast Dance Theatre – di cui ricordiamo una sbalorditiva Giselle del 2003 che Keegan-Dolan stravolse, trasponendo la storia dell’eroina a Ballyfeeny, Co Roscommon – prima di scioglierlo nel 2014 per trasferirsi dalle Midlands irlandesi al West Kerry Gaeltacht, sulla costa sud-occidentale, una delle sette contee dove si parla ancora il gaelico e si mantengono vive la cultura e la lingua irlandese. Qui nel 2016 fonda Teac˙ Dam˙sa – letteralmente “il posto dove la danza succede” – con l’obiettivo di creare una profonda e significativa connessione tra la propria disciplina e la lingua, le tradizioni e la musica irlandesi. Seppur visceralmente radicata nel territorio, la Compagnia è costituita da un ensemble internazionale di artisti e collaboratori capace di realizzare acclamati progetti a livello internazionale come la pluripremiata prima produzione Swan Lake / Loch na hEala del 2016, brillante attacco agli abusi della chiesa cattolica, con cui il coreografo sbalordì tutti ricoprendo l’intero palco con una raffica di piume.

MÁM, creato nel 2019, è stato il primo spettacolo interamente concepito, provato e prodotto nel West Kerry Gaeltacht ed è stato nominato per un Olivier Award per la migliore nuova produzione nel 2020 e due UK Critics’ Circle National Dance Awards nel 2022. Nato dall’incontro tra Michael Keegan-Dolan e il virtuoso di concertina Cormac Begley, lo spettacolo prende il titolo da un termine gaelico che significa “passo di montagna” e quindi potenziale luogo di incontro tra solista ed ensemble, tra classico e tradizionale, tra locale e universale. Immerso nel paesaggio irlandese, MÁM ricerca il suo immaginario alle pendici del Cnoc Bréanainn, il monte sacro del Kerry Gaeltacht che Keegan-Dolan immagina come un portale sull’ignoto, il magico, il meraviglioso. Sul palco rivive l’atmosfera dell’antico villaggio gaelico di Kerry Gaeltacht e della sua tradizione in una sorta di immaginifico rituale evocativo pronto a sfociare in una festa apocalittica.
L’incantevole fisarmonica di Cormac Begley accompagna tutto lo spettacolo, insieme all’ensemble berlinese stargaze che innesta sapientemente sonorità jazz contemporanee nel ritmo e folklore irlandese, mentre i dodici danzatori internazionali – tra cui il vincitore della BBC Young Dancer Connor Scott – sempre in scena nel duplice ruolo di performer e spettatori incarnano ogni genere di umana emozione in novanta minuti di rutilante maratona.
Irish choreographer Michael Keegan-Dolan and the company he founded in 1997, the Fabulous Beast Dance Theatre, are famous for their amazing Giselle of 2003, adapted by them to an Irish setting. His present company, Teac˙ Dam˙sa, works even more intensely on connecting dance with Irish language, traditions, and music. The company is an ensemble of international artists, whose curriculum includes a Swan Lake / Loch na hEala production that shocked the audience in its attack to the Catholic Church. MÁM, their 2019 show, has been the first show entirely created, rehearsed, and produced in West Kerry Gaeltacht, and has been nominated for an Olivier Award in 2020 and two UK Critics’ Circle National Dance Awards in 2022. The piece draws its name from the Gaelic word for ‘mountain pass’, the potential place of meeting between solo artist and ensemble, classic and traditional, local and universal. Immersed in the Irish landscape, MÁM embraces the slopes of Cnoc Bréanainn as a portal to the unknown, the magic, and the wonderful. Cormac Begley’s enchanting concertina music accompanies, together with Berlin-based group stargaze.
Keegan-DolanDanzatore e coreografo svedese, direttore artistico del Danish Dance Theatre di Copenhagen fino allo scorso anno, Pontus Lidberg è nato a Stoccolma e si è formato alla Royal Swedish Ballet School e al Conservatoire National de Musique et de Danse di Parigi. Ha conseguito un MFA in Contemporary Performing Arts presso l’Università di Göteborg e si è velocemente affermato sulla scena internazionale per una creatività visionaria che fonde danza e cinema con straordinaria sensibilità.

Sul palcoscenico ha creato opere di grande successo per compagnie di prestigio tra cui Paris Opera Ballet, New York City Ballet, Martha Graham Dance Company, Les Ballets de MonteCarlo, Semperoper Ballet Dresden, Royal Swedish Ballet, Royal Danish Ballet, Le Ballet du Grand Théâtre de Genève, Acosta Danza, Beijing Dance Theatre e molti altri. Ha conquistato pubblico e critica con il suo primo, pluripremiato film del 2007, lo struggente The Rain, capace secondo il «New York Times» di illustrare «ciò che la danza filmata può dire che la danza messa in scena non può dire». Seguono Labyrinth Within, miglior film al Dance on Camera Festival nel 2012 e Written on Water, con Aurélie Dupont, presentato in anteprima al Festival International du Film sur l’Art di Montréal nel 2021.
A Venezia vedremo la prima mondiale della sua nuova creazione, commissionata direttamente dalla Biennale di Venezia, On the Nature of Rabbits, opera nata da un tour de force collaborativo di un team creativo che annovera il drammaturgo Adrian Guo Silver, il compositore e produttore musicale Stefan Levin e il genio dell’animazione Jason Carpenter, vincitore di un Emmy e collaboratore di lunga data di Lidberg, con cui ha già lavorato per la produzione di Siren (Danish Dance Theatre) e Dogs and Wolves (Vienna Staatsoper).
Ispirato alla vera storia di un giovane ballerino arrivato dall’ex Germania dell’Est a Parigi nel 1993, On the Nature of Rabbits indaga «la relazione tra i cimeli dell’infanzia e le sfumature del desiderio. La presenza di un coniglio di pannolenci diventa il veicolo di nostalgie e desideri inespressi. In una serie di scene oniriche – scrive Lidberg nella presentazione –, il lavoro contempla la persistenza degli attaccamenti dell’infanzia, il delicato equilibrio tra realtà e immaginazione, la complessità del desiderio e delle relazioni. Proiezioni animate aggiungono una dimensione interattiva e giocosa alla danza». Lidberg è pronto a stupire e coinvolgere il pubblico attraverso il connubio di danza e immagine in movimento per trasportarlo in una dimensione parallela, dove due anime si affannano nell’ostinata ricerca l’una dell’altra. C.S.
Swedish dancer and choreographer Pontus Lidberg was born in Stockholm and educated at the Royal Swedish Ballet School and the National Conservatory of Music and Dance in Paris. He earned an MFA in Contemporary Performing Arts at the Gothenburg University and quickly established his creative vision: a blend of dance and cinema. On stage, Lidberg authored successful pieces for famous company such as the Paris Opera Ballet, the New York City Ballet, the Martha Graham Dance Company, Les Ballets de Monte-Carlo, Semperoper Ballet Dresden, Royal Swedish Ballet, Royal Danish Ballet, Le Ballet du Grand Théâtre de Genève, Acosta Danza, Beijing Dance Theatre, and many others.
His poignant The Rain of 2007 convinced both critics and audiences: according to the New York Times, it “illustrates what filmed dance can say that staged dance cannot.” Further works are Labyrinth Within and Written on Water, starring Aurélie Dupont. Lidberg’s latest show, On the Nature of Rabbits, will premiere in Venice soon.
The Biennale-commissioned piece is the brainchild of playwright Adrian Guo Silver, music composer and producer Stefan Levin, and animator Jason Carpenter, the winner of an Emmy and a long-time collaborator of Lidberg’s, with whom he co-authored Siren and Dogs and Wolves Inspired by the real story of an East Germany-born young dancer who moved to Paris in 1993, On the Nature of Rabbits investigates “the relationship between childhood keepsakes and the nuances of desire. The presence of a felt rabbit is the vehicle for unexpressed nostalgia and desire. In a series of dream sequences, the piece contemplates the persistence of childhood attachment, the delicate balance between reality and imagination, and the complexity of desire and relationships.
Pontus LidbergO n the Nature of Rabbits
26, 27 luglio Teatro alle Tese, Arsenale www.labiennale.org
Memorie di un coniglio Una nuova creazione di Pontus Lidberg e Jason CarpenterOn the Nature of Rabbits © Luca Ianelli
Tra le figure più influenti del balletto contemporaneo, Carlos Acosta approda per la prima volta a Venezia con la sua compagnia Acosta Danza. Invitato dal direttore Wayne McGregor, il coreografo cubano presenta una serata che è lo specchio della sua pratica, all’intersezione tra danza classica, contemporanea, urbana, afro e latina. Prendendo in prestito il titolo Ajiaco da un succulento piatto tradizionale cubano, la cui peculiarità è proprio il ricchissimo mix di ingredienti e spezie, Acosta riunisce le coreografie di quattro artisti differenti per generazione e stile: Micaela Taylor, fondatrice e direttrice artistica del TL Collective, tra le compagnie emergenti in maggior ascesa di Los Angeles, il coreografo belga-marocchino Sidi Larbi Cherkaoui, oggi alla testa del prestigioso Ballet du Grand Théâtre de Genève, Alexis Fernández, formatosi alla scuola cubana della leggendaria Alicia Alonso e ora direttore e cofondatore con Caterina Varela della compagnia galiziana La Macana, e il coreografo di origine venezuelana Javier de Frutos, tra gli artisti più eminenti della scena londinese, già ospite di Ismael Ivo per Biennale Danza 2007.

L’Ajiaco di Carlos Acosta mescola dunque ingredienti molto pregiati per ottenere sapori decisi ed inebrianti, a partire da Performance di Micaela Taylor, in cui la coreografa unisce il mix di hip hop e balletto classico che caratterizza la propria formazione alle conoscenze acquisite durante il periodo di collaborazione con Acosta Danza, durante il quale Taylor ha lavorato per «imparare dalla loro cultura, dal modo in cui si muovono, dal loro stile, apprendendo quanto più possibile». Sidi Larbi Cherkaoui con il suo Faun rilegge il classico del balletto moderno di Nijinskij L’après-midi d’un faune che, con l’aggiunta della musica del compositore britannico di origini indiane Nitin Sawhney alla partitura immediatamente riconoscibile di Debussy, si libera di un ingombrante retaggio culturale per diventare di per sé duplice e multiplo, primordiale e moderno, improvvisamente sradicato dalla storia e dalla geografia.
Ci riporta invece nel cuore vivo e pulsante dell’Avana, e più precisamente lungo il celebre lungomare El Malecón, Alexis Fernández con De Punta a cabo, una riflessione sulla sua Cuba contemporanea, su tutti quei contrasti e le contraddizioni che ne fanno un Paese tanto difficile quanto meraviglioso.
Chiude il ‘piatto’ Javier de Frutos con 98 Días, accompagnandoci nell’incanto degli anni Venti che stregò García Lorca «in quella Cuba scintillante, Federico si sentiva più a casa e tornato alle sue radici di quanto non si fosse mai sentito. Doveva fermarsi per una settimana sulla via del ritorno in Spagna da New York. Alla fine novantotto furono i giorni di quella visita, secondo le sue stesse parole, i giorni più felici della sua vita. 98 Días prende quel preciso momento come punto di partenza e lo trasforma in un’ode, non solo a García Lorca, ma a tutti gli stranieri che cercano e si trovano inaspettatamente catturati da una forza a cui non si può resistere e dove l’amore e la bontà possono essere solo illusori».
One of the most influential figures in the world of modern ballet, Carlos Acosta will be in Venice for the first time with his company, Acosta Danza. Invited by the Dance Biennale director Wayne McGregor, the Cuban choreographer presents a show that intersects classical, modern, urban, Afro, and Latino dance. The show’s title, Ajiaco, is taken from a tasty Cuban dish, rich in ingredients and spices. Acosta blends choreographies by four creators, different in generation and style: Micaela Taylor, Sidi Larbi Cherkaoui, Alexis Fernández, and Javier de Frutos. Ajiaco is a mix of fine ingredients, for tasty, inebriating flavours. It starts with Performance, by Micaela Taylor: a mix of hip-hop and classical ballet. Sidi Larbi Cherkaoui’s Faun is a re-reading of Nijinsky’s classical modern ballet L’après-midi d’un faune on an arrangement of Debussy’s music by Nitin Sawhney for a double take, primordial and modern, on a piece of cultural heritage. Alexis Fernández takes us to Havana with De punta a cabo, a reflection on modern Cuba. Ending the offer is Javier de Frutos’ 98 Días, a journey into the 1920s that enticed Federico García Lorca. “In that scintillating epoch of Cuban history, Federico felt home, and closer to his roots than he had ever been. He was supposed to spend a week in Cuba, on his way back to Spain from New York. In the end, he spent ninety-eight days there –in his words: the happiest of his life. 98 Días is an ode not only to García Lorca, but to all foreigners who find themselves enthralled by an irresistible force.”
Per la prima volta a Venezia la compagnia Acosta DanzaFaun (Duet), Sidi Larbi Cherkaoui © Toti Ferrer
Viene da Roma, Andrea Salustri. Nella sua città ha imparato la giocoleria, la manipolazione del fuoco e ha lavorato come artista di strada. Dopo la laurea in Filosofia alla Sapienza nel 2013, si trasferisce a Berlino per conseguire una formazione in danza contemporanea, dapprima presso Tanzfabrik Berlin e successivamente alla HZT Berlin University. La sua formazione transdisciplinare si manifesta nell’eclettismo di Materia, creazione del 2021 già vincitrice di Circusnext European Circus Label e grande successo al Fringe Festival 2022 di Edimburgo. In questo straordinario pezzo di teatro visivo Andrea Salustri esplora le possibilità di un materiale, se vogliamo, banale come il polistirolo e arriva a renderlo vivo protagonista degli eventi in scena. In qualità di animatore quasi invisibile, ricoprendo un ruolo di mero facilitatore, Salustri ci mostra come interagiamo con gli oggetti, consentendo a quest’ultimi di esprimere la propria abilità artistica creando una sorta di magia davanti agli occhi del pubblico. Nessuna metafora narrativa o pesante, solo straordinarie evocazioni sensoriali. E non c’è da preoccuparsi neanche per la plastica: «Tutto il polistirolo utilizzato durante gli spettacoli di Materia sarà raccolto e trasportato a Berlino – rassicura Salustri –, dove ha sede la compagnia, per essere compostato da vermi chiamati Zophobas Morio. Questi vermi possiedono enzimi batterici nel loro intestino che bio-degradano il polistirene, rendendoli in grado di digerirlo».
ENG A ndrea Salustri is a street artist and fire juggler. A philosophy graduate from Rome, Salustri moved to Berlin to further his education in modern dance. His trans-disciplinary formation shows in the eclecticism of his Materia, his 2021 creation that earned him the Circusnext European Circus Label and delighted audiences at the 2022 Fringe Festival in Edinburgh. The possibilities of a, shall we say, mundane material like polystyrene are limitless when manipulated by an artist, one who can recreate magic in front of our eyes. No deeper narration, only amazing sensorial suggestions.
Da oltre vent’anni sulla scena con il dichiarato obiettivo di «sfidare ed estendere i limiti della danza contemporanea», l’acclamata compagnia di Melbourne fondata nel 2002 dalla coreografa australiana Lucy Guerin è ospite della 15. Biennale Danza con due distinti progetti: la performance Pendulum, in prima europea, allestita al Teatro alle Tese dell’Arsenale dal 14 al 29 luglio, e Split, creazione del 2017 in prima nazionale, in scena al Teatro al Parco di Mestre il 22 e 23 luglio. Sette performer vagano in un campo di pendoli in movimento, ciascuno costituito da una campana sospesa che suona, pulsa e ronza. Mentre i pendoli sfrecciano nell’aria in viscerali ondate di suoni e luci, la musica composta dall’artista percussivo Matthias Schack-Arnott è guidata dalla velocità e dalla forza del loro movimento. Gli artisti attivano le campane: le scagliano, afferrano, fermano, girano, schivano e resistono all’oscillazione in una danza con la gravità. Il potere e la vulnerabilità del corpo umano si rivelano attraverso i tentativi di controllare l’inarrestabile salita e discesa del peso del pendolo, dove l’ascesa e la caduta evocano il tempo come un continuum che si estende dietro di noi e davanti a noi, situando i nostri corpi in un momento fugace sulla Terra. Pendulum ci invita a «sentire lo scorrere del tempo – scrive McGregor –, costruendo empatia intima e cinestetica con i performer, il pendolo e la nostra chimica interna».



Tra i lavori di maggior successo della Compagnia, Split è invece un’avvincente meditazione strutturale resa in movimento, frutto delle acute ed eleganti indagini coreografiche di Lucy Guerin. In uno spazio vuoto ed essenziale, via via sempre più ridotto e segmentato al ritmo della partitura composta dal britannico Scanner, due danzatrici si muovono su una coreografia che riporta la danza ai suoi fondamentali di tempo, spazio e movimento, rimettendo in discussione la percezione del corpo femminile.
ENG T he Company has been treading the boards with the explicit goal of “challenging and extending the limits of modern dance.” Founded in Melbourne in 2002 by Australian choreographer Lucy Guerin, the eponymous company will participate to the 15th Venice Dance Biennale with two projects: Pendulum, whose European premiere will be at Teatro alle Tese on July 14 and 29, and Split, in national premiere at Teatro al Parco (Mestre) on July 22 and 23.
Sfida al limitePendulum © Gregory Lorenzutti Split © Gregory Lorenzutti Materia © Milan Szypura
Come è possibile cogliere una differenza in ciò che è identico? Questa la sfida raccolta dal danzatore e coreografo franco-algerino Rachid Ouramdane, direttore del parigino Théâtre national de la Danse de Chaillot, tra i protagonisti di primo piano della danza contemporanea francese e internazionale. Con Variation(s), interpretato magistralmente dai danzatori Ruben Sanchez e Annie Hanauer, Ouramdane torna ai fondamentali e presenta «un’opera musicale estrema, al limite della trance – nelle parole di Wayne McGregor – , due fenomenali assoli, in cui il nostro “normale” e quotidiano stato di veglia è ipnotizzato ed elevato a un’esperienza di profonda alterazione». Il tutto nasce dall’incontro con il compositore e maestro Fernand Schirren, che durante un incontro invitò il coreografo a cercare appunto la “differenza nell’identico”. «Per rendere visibile e tangibile la differenza nell’identico è importante mantenere sguardo e ascolto vigili – afferma Ouramdane –, solo così potremo vedere in cosa sussiste la variazione, la differenza. Da qui l’idea di chiamare questo spettacolo Variation(s), vale a dire una variazione attorno alla medesima cosa, un tema musicale, e di farne un’esperienza diversa ogni volta. Abbastanza rapidamente, lo spettacolo è stato costruito in collaborazione con il compositore Jean-Baptiste Julien, a lungo al mio fianco. L’idea era di mostrare la struttura musicale in modo diverso attraverso il gesto, la danza».
ENG How can you tell two identical things apart? This is the challenge posed by Algerian-French dancer and choreographer Rachid Ouramdane, the director of the Théâtre national de la Danse de Chaillot in Paris and a protagonist of French and international dance. His Variation(s), performed by Ruben Sanchez and Annie Hanauer, is an “extreme musical piece, bordering trance. Two phenomenal solos that show our daily, normal state of wake as hypnotized, and elevated to an experience of deep alteration” (Dance Biennale director Wayne McGregor). The dance piece was composed after Ouramdane met composer Fernand Schirren, who invited Ouramdane to look for a difference in what is identical.
R achid Ouramdane
Variation(s)
19, 20 luglio Tese dei Soppalchi, Arsenale
Classe 1991, Botis Seva è nato e cresciuto a Londra in una famiglia congolese tradizionale. Ha trovato da giovanissimo la propria vocazione verso la creatività e la danza grazie alla musica rap e alla danza hip hop. Intrapresa da subito una ricerca indipendente, a soli 19 anni fonda la pluripremiata compagnia Far From The Norm ed è oggi una delle voci più innovative e originali della nuova generazione di coreografi della scena europea. Originato da un brano di 25 minuti, già premiato con un Olivier Award nel 2019, l’acclamato Blkdog viene presentato a Venezia in prima nazionale nella sua versione definitiva. Straniante come il sogno di un ricordo d’infanzia e al tempo stesso potente come un pugno nello stomaco, Blkdog è il commento meravigliosamente brutale di Botis Seva alla situazione dei giovani di oggi, costretti ad affrontare un mondo che non è stato costruito per loro. In quest’opera poetica, Seva attinge all’attualità e alla propria biografia per svelare il circolo vizioso attraverso il quale la scoperta di sé porta all’autodistruzione, e s’interroga su come combattere i nostri demoni interiori per riuscire a trovare un senso di pace.
«Blkdog è per tutti coloro che hanno affrontato traumi e lutti. Per chiunque abbia dovuto guardare i membri della famiglia attraversare la depressione o la perdita. Viviamo in una società in cui parlare delle nostre emozioni potrebbe non venire mai compreso – scrive il coreografo –; ho trascorso la mia infanzia senza mai parlare delle mie emozioni e ora a 30 anni posso finalmente parlare».


E Blkdog parla forte e chiaro: «una potente evocazione di alienazione, oppressione e memoria» (The Guardian).
ENG B orn in 1991, Botis Seva was born and raised in London in a traditional Congolese family. Aged merely 19, he founded award-winning company Far From the Norm, and is today one of the most innovative and original young choreographer in Europe. Blkdog will be presented in its definitive form in Venice: built upon a 25-minute piece, it is Seva’s amazingly brutal commentary on modern youth, who are forced to face a world that hasn’t been built for them. “A powerful evocation of alienation, oppression and memory.”
B otis Seva – Far From The Norm Blkdog
18, 19 luglio Teatro alle Tese, Arsenale

EACH OF THE TEN ROOMS IS CHARACTERIZED BY A PRECISE IDENTITY. DURING THE RESTORATION, THE HISTORY AND TRADITIONS OF VENICE WERE CAREFULLY PRESERVED,






AND ARE NOW ENHANCED BY THE MODERN DESIGN OF SELECTED FURNISHINGS AND FABRICS. A MAGICAL PLACE HOLIDAYS, PRIVATE FUNCTIONS, WEDDINGS, EXCLUSIVE EVENTS OR FAMILY CELEBRATIONS.



Come nelle precedenti edizioni firmate Wayne McGregor grande punto di forza del Festival, Biennale College Danza porta anche quest’anno a Venezia giovani talenti creativi e grandi Maestri, invitati a dare vita a nuovi progetti commissionati e prodotti dalla stessa Biennale.
Lavorano con i sedici danzatori del College in residenza da aprile, il fenomeno della danza cinese Xie Xin, che allestirà con gli allievi When I am facing U, una coreografia inedita sulla stasi nella confusione emotiva, e Brigel Gjoka e Riley Watts, danzatori della compagnia di William Forsythe, che riallestiranno il Duo dallo spettacolo A Quiet Evening of Dance (2019) del coreografo statunitense. Entrambi gli spettacoli andranno in scena in due repliche al Teatro Piccolo Arsenale il 28 e 29 luglio.

A Sarah Swenson, tra le massime specialiste dell’opera di Simone Forti, invece l’incarico di guidare gli allievi del College nell’apprendimento e nel riallestimento delle sue celebri Dance Constructions che saranno presentate nell’ambito della retrospettiva dedicata al Leone d’Oro, Simone Forti, alle Sale d’Armi dell’Arsenale dal 14 al 29 luglio. Per la coreografia due nuovi talenti internazionali emergenti sono stati invitati a lavorare su altrettante creazioni per gli allievi del College: il coreografo e danzatore Scott Elstermann, primo australiano e più giovane assegnatario della Pina Bausch Fellowship nel 2018, che presenterà il brano Mosaic, e la danzatrice, coreografa e regista di Taipei, Hai Wen HSU, dal 2011 impegnata in una ricerca all’intersezione tra danza, teatro e arti visive, con la sua creazione Ténèbres Vacillantes. Interpretati dai danzatori del College, i brani sono presentati in prima mondiale a Ca’ Giustinian in Sala delle Colonne il 23 e il 25 luglio. ENG A s in the earlier edition curated by Dance Biennale director Wayne McGregor, the Dance Biennale College will host both young talents and established maestros to create new projects commissioned and produced by Biennale. Xie Xin and her students will stage When I am facing U, a choreography on the stasis of emotional confusion. Brigel Gjoka and Riley Watts will re-stage their Duo from A Quiet Evening of Dance of 2019 (July 28 and 29). Further shows that will be performed between July 23 and 25 are retrospective Simone Forti by Sarah Swenson, Mosaic by Scott Elstermann, and Ténèbres Vacillante by Hai Wen Hsu.
Seguendo il tema Altered States, il Festival di Wayne McGregor invita il pubblico a farsi coinvolgere – e stravolgere, se possibile, nella propria visione e percezione – andando oltre gli spettacoli: partecipando agli incontri e ai dialoghi con gli artisti prima e dopo le messinscena, ai workshop e alle masterclass aperte al pubblico, alle proiezioni dedicate alla danza. Domenica 23 luglio, dalle 11 alle 22, il Teatro Piccolo Arsenale ospita una vera e propria ‘maratona’ con le opere cinematografiche degli artisti del Festival insieme a opere da loro selezionate, tra importanti novità di registi affermati e visioni più sperimentali, oltre ad anteprime di artisti di generazioni diverse, fra cui Transparent, biopic della settantenne coreografa britannica Siobhan Davies. Come sempre, tutti gli artisti che presentano o eseguono lavori alla Biennale Danza sono invitati a tenere un workshop per una vasta gamma di partecipanti durante il Festival, un cruciale programma di laboratori in continua espansione che consente a un pubblico eterogeneo di danzatori professionisti e amatoriali di sperimentare dal vivo gli incredibili universi corporei dei grandi maestri internazionali. Tra questi, lo stesso McGregor con il suo Studio, l’astro della danza cinese Xie Xin, il Leone d’Argento Tao Ye e la compagnia Far From the Norm di Botis Seva con uno speciale laboratorio partecipativo al Teatro al Parco di Mestre, che intende infondere ispirazione e nuovi stimoli grazie alla sua energia positiva e alla sua visione d’insieme. ENG Following programme Altered States, the Venice Dance Biennale invites the audience to get involved and go beyond the watching of any given show: there will be options to participate in meetings, debates, conversations with the artists before and after the show, workshops, masterclasses, screenings. On Sunday, July 23, from 11am to 10pm, the Teatro Piccolo Arsenale will house a ‘marathon’ with films by Biennale participants, both by established authors and emerging talents. As per workshops, Dance Biennale director Wayne McGregor will hold one of his own, as will Xie Xin, Tao Ye, and Botis Seva’s company Far From the Norm.

La musica di Paolo Conte ha trovato più volte posto nei cartelloni di Veneto Jazz. Un sound, il suo, che appartiene al jazz, con un atteggiamento sempre trasversale, al di sopra delle mode e comunque assolutamente contemporaneo. Gli appassionati di questo mondo, unico nel cantautorato italiano, fatto di poesia e musica, di pianoforte e parole antiche, sembrano trovarsi a loro agio anche nelle atmosfere jazz che Conte ha sempre richiamato. Che fosse al Teatro La Fenice o al Parco di Villa Pisani, abbiamo amato questo artista, riservato ma generoso nell’arte e nella musica, che ha saputo regalarci momenti sempre unici e diversi. Il suo ritorno in Piazza San Marco dopo 14 anni per un tour da molti indicato come l’ultimo, per noi ha il sapore della rinascita. Da quel 2009 molte cose sono cambiate. Una pandemia che ha rivoluzionato il modo di ascoltare e organizzare i concerti; una città, Venezia, che lotta fra grandi eventi mediatici ma poco sostenibili e ancor meno progetti di qualità, realizzati ad hoc per la sua fragile e magnifica identità; produzioni sempre più costose che impongono nuove strade e nuove idee artistiche. La rinascita allora non può che essere quella di ritrovare l’alchimia perduta del rapporto fra artista e luoghi, di arrivare in punta di piedi in un sito ineguagliabile arricchendolo con l’unico ingrediente possibile: altra Arte, con la “A” maiuscola. Confidiamo sia solo l’inizio di un percorso di consapevolezza sul valore inestimabile che la città offre agli artisti, sulla coscienza degli organizzatori invitati a rispettare la fragilità e l’unicità di un simile contesto, sull’amore del pubblico verso proposte sostenibili e originali. In questa auspicabile e obbligata direzione ora non ci resta che attendere il ritorno sul palco di questa icona indiscussa della musica cantautorale internazionale, a distanza di 14 anni dal concerto del 31 luglio 2009 con l’Orchestra Sinfonica di Venezia.
Nato ad Asti nel 1937, Paolo Conte è ciò che si definisce un artista a tutto tondo. In oltre cinquant’anni di carriera ha collaborato con tantissimi artisti, scrivendo per loro canzoni indimenticabili. Cantautore, pittore, artista: la storia di Paolo Conte è la storia della musica italiana.
Come tutti i grandi artisti ogni live non è mai uguale al precedente e le interpretazioni delle sue canzoni regalano emozioni sempre uniche. In piazza San Marco riserverà quest’anno al pubblico uno spettacolo nuovo, esibendosi in una speciale scaletta con cinque brani diversi, presentata per la prima volta durante il concerto alla Scala. Anche per la tappa di Venezia il cantautore sarà accompagnato dal suo storico ensemble orchestrale di undici musicisti eccezionali: Nunzio Barbieri (chitarra e chitarra elettrica), Lucio Caliendo (oboe, fagotto, percussioni e tastiere), Claudio Chiara (sax contralto, sax tenore, sax baritono, flauto, fisarmonica, basso e tastiere), Daniele Dall’Omo (chitarre), Daniele Di Gregorio (batteria, percussioni, marimba e piano), Luca Enipeo (chitarre), Francesca Gosio (violoncello), Massimo Pitzianti (fisarmonica, bandoneon, clarinetto, sax baritono, piano e tastiere), Piergiorgio Rosso (violino), Jino Touche (contrabbasso, basso elettrico e chitarra elettrica) e Luca Velotti (sax soprano, sax tenore, sax contralto, sax baritono e clarinetto).
always kept Paolo Conte in high esteem. The legend singer-songwriter cannot be ascribed to any trend, as he has always been absolutely modern. Music and poetry, piano and ancient words seem to feel at home in jazzy atmospheres. Conte will be back in Piazza San Marco fourteen years after what was supposed to be his last tour, and a lot has change since 2009. To us, this feels like rebirth: finding back the chemistry we thought long gone, and gracing an unparalleled stage with the best art there is around. Born in 1937, Paolo Conte is an all-around artist. In over fifty years, he wrote unforgettable songs that will be preserved in history. No two concerts of his are alike, and for the upcoming Venetian performance, there will be a five-track playlist once presented at the Scala Theatre in Milan. Conte will be accompanied by his band, a formation of eleven excellent performers.
«Mia madre diceva che questa canzone era antica e moderna insieme. L’antico era soprattutto nella musica, come una tenerezza d’altri tempi, e proprio in questo sentimento risiedeva anche la sua modernità: era una canzone trasgressiva nell’epoca beat in cui è nata. Capimmo subito che era una canzone vincente. Rimane una canzone importante per me e non l’ho mai dimenticata». Conosciuta anche nella famosa versione portata al successo da Adriano Celentano, il cantautore astigiano parla così di uno dei più grandi classici della musica italiana, di cui lui stesso depose un foglio con il testo nella bara della madre, che tanto la amava. Una canzone che ha festeggiato il mezzo secolo di vita nel 2018 e sembra scritta ieri.
«Una canzone – afferma Conte – in cui non si parla tanto di sport, ma di esistenza umana, dell’attesa dell’uomo qualunque che aspetta che dietro una curva spunti un sogno in forma di ciclista». Il Ginettaccio nazionale si fa ancora una volta emblema di un’epoca, personaggio a tutto tondo raccontato da versioni che tributarono anche Bruno Lauzi ed Enzo Jannacci: Bartali è ciclista ma uomo comune, con le sue tristezze, debolezze e con una forza d’animo fatta di muscoli, sudore, stramaledetta e benedetta fatica, orgoglio italiano che fa incavolare i cugini d’Oltralpe, eterni rivali sportivi. Tra “i francesi che si incazzano e i giornali che svolazzano” ecco spuntare all’orizzonte “quel naso triste come una salita, quegli occhi allegri da italiano in gita”.
Non è un caso che il titolo di questa canzone sia stato cucito addosso anche al documentario che Giorgio Verdelli ha dedicato a Paolo Conte e presentato alla Mostra del Cinema di Venezia nel 2020, con interventi tra gli altri di Roberto Benigni, Vinicio Capossela, Caterina Caselli, Francesco De Gregori e Stefano Bollani. Inserito nell’album Paris milonga del 1981, è forse il brano più iconico del cantautore piemontese, registrato per la prima volta allo studio Format di Torino: «It’s wonderful/It’s wonderful/ It’s wonderful/Good luck my baby/It’s wonderful/It’s wonderful/It’s wonderful/I dream of you…» è ritornello universalmente riconosciuto, dall’immarcescibile cadenza swing.


Nilza Costa è una cantante. Ma non solo. È autrice e compositrice brasiliana, di Salvador Bahia per la precisione, con un cuore pulsante di ritmi ancestrali dell’Africa, trasfigurati nel suo canto in un linguaggio artistico estremamente originale. Le forme tradizionali della cultura musicale e religiosa brasiliane, come il candomblé, la capoeira, samba duro, maculelé e la Cantigas de Roda, sono filtrate da una sensibilità musicale che fa trasparire una spiccata attitudine alternativa.
La passione per la musica le viene trasmessa dalla nonna materna (di origine afroindigena) che accompagnandola alle feste candomblé le permette di avvicinarsi alla cultura Yoruba, religione afro brasiliana basata sul culto degli Orixas, divinità appartenenti originariamente alla mitologia dei popoli dell’Africa Occidentale. Il suo disco di debutto, Revolution, Rivoluzione, Revolução, uscito nel 2014, è un appassionante viaggio nella migliore world music che contamina l’afro-jazz con samba, blues e atmosfere ipnotiche.

A ottobre 2016 esce il secondo album, Roots, co-prodotto dall’Associazione Culturale Studio SoundLab, con gli arrangiamenti del batterista Roberto “Red” Rossi, che ritroviamo al Laguna Libre di Venezia il 15 luglio nel 4et della cantante per presentare l’ultimo lavoro, Le Notti di San Patrizio: un viaggio tra Brasile ed Europa, con lo sbarco in questo piccolo paese della bassa Romagna, San Patrizio appunto. La notte, il silenzio, il cielo stellato, l’orixa, fanno tutti parte del bagaglio che l’artista espone in questo lavoro, che fonda le sue basi su una commistione di culture insita ed espressa nella musica e dai musicisti che la accompagnano in questo concerto nella notte del Redentore.
ENG Nilza Costa is more than a singer: she is a Brazilian author and composer who is able to draw beautiful inspiration from ancestral African rhythm and infuse it into traditional religious Brazilian culture. Her passion for music comes from her African-indigenous Brazilian maternal grandmother, who used to take her to candomblé fetes and taught her about Yoruba culture, the Afro-Brazilian devotion to the Orixas, deities proper of Western African cultures. Nilza Costa’s 2014 debut album, Revolution, Rivoluzione, Revolução, is a compelling journey into world music, Afro-jazz, samba, blues, and dreamlike atmospheres. On July 15, Costa will perform music from his second album, Roots, published in 2016.
Da Heitor Villa Lobos in poi, il violoncello è diventato una delle icone musicali del Brasile. Il suo timbro dolce e romantico, l’incredibile somiglianza del suo suono con la voce umana, la sua naturale flessibilità tra articolazioni oscillanti e pura poesia, fanno sì che questo strumento, di origine europea, assuma un’identità molto ‘brasiliana’. Il violoncello è stato amato e utilizzato come mezzo espressivo molto particolare (e peculiare) da grandi compositori brasiliani come Antonio Carlos Jobim, Caetano Veloso e Gilberto Gil, tra molti altri.
Combinando tutti questi elementi, il violoncellista, compositore, arrangiatore, direttore e produttore brasiliano Jaques Morelenbaum offre una visione panoramica della samba, dalle sue radici ai giorni nostri, interpretando nei suoi concerti composizioni di Dorival Caymmi, Jacob do Bandolim, Antonio Carlos Jobim, Newton Mendonça, Carlos Lyra, João Gilberto, Caetano Veloso, Gilberto Gil nonché opere di una nuova generazione di compositori, come Luisão Paiva e Lula Galvão, oltre alle loro composizioni originali. Jaques Morelenbaum e il suo CelloSam3aTrio, ospiti del Venezia Jazz Festival il 22 luglio allo Squero della Fondazione Cini, portano nella samba un sapore intimo di musica da camera, esaltato da due immensi talenti brasiliani come il chitarrista Lula Galvão e il batterista Rafael Barata.
Tra gli innumerevoli stili musicali sviluppati in Brasile, il samba è quello che meglio rappresenta la vasta diversità culturale di questo Paese. Il perfetto mix tra influenze africane, europee e native brasiliane, ha portato a questa onda ritmica e musicale piena di fascino, sensualità, grazia melodica e raffinatezza armonica, che servono gli amanti della musica sia per le delizie della danza che per la degustazione estetica e l’approfondimento spirituale. Jaques Morelenbaum all’Auditorium Lo Squero presenta brani originali di Antonio Carlos Jobim, Egberto Gismonti, Milton Nascimento, Gilberto Gil e tanti altri con i quali nella sua lunga carriera ha collaborato, nell’occasione in una formazione arricchita dalla strabiliante voce della moglie Paula.
Siamo fatti di musica
Il Brasile dei Morelenbaum
The cello is a musical icon of Brazil. Its sweet, romantic timbre, the incredible similarity of its sound to the human voice, its natural flexibility, all allow this European-originated instrument to take a very Brazilian identity. Cellist, composer, arranger, conductor, and producer Jaques

Morelenbaum offers an all-around vision on samba, from its origin to the present day, interpreting music by Dorival Caymmi, Jacob do Bandolim, Antonio Carlos Jobim, Newton Mendonça, Carlos Lyra, João Gilberto, Caetano Veloso, Gilberto Gil, and contemporary composers like Luisão Paiva and Lula Galvão. Jaques
Morelenbaum and his CelloSam3aTrio have been invited by Venezia Jazz Festival to perform at Fondazione Cini on July 22. They will bring to Venice a kind of intimate samba that will give off chamber music vibes thanks to the talent of guitarist Lula Galvão and drummer Rafael Barata. One of the many musical styles that developed in Brazil, samba is the one that best represents the vast cultural diversity of the country. The perfect mix of African, European, and Native Brazilian influences gave charm, sensuality, melodic grace, and harmonic refinement to this beautiful rhythmic waves.
La musica elettronica è nata come ricerca di nuove forme ed espressioni musicali, spesso la definiamo tout cort come genere elaborato con strumenti elettronici o digitali da contrapporre alla musica acustica. La Germania può essere considerata la patria di questo genere, avendo visto la nascita dei Kraftwerk, ritenuti il primo vero gruppo di musica elettronica. La verità è che è uno dei generi meno compresi e difficili da definire, pochi ascoltatori e appassionati possono dire di conoscerla davvero.
Con lo scopo di promuovere la creatività dei giovani artisti, nell’ambito della quindicesima edizione di Venezia Jazz Festival, dal 3 al 5 agosto nella sede di Combo a Venezia si svolge il MOOG Summer Camp, un seminario dedicato a MOOG e sintetizzatori elettronici. La direzione è affidata a Enrico Cosimi, uno dei massimi esperti di sintesi sonora a livello internazionale, musicista, compositore e docente. Ai partecipanti sarà rilasciato un attestato di partecipazione e verrà data la possibilità di concorrere per una borsa di studio, che prevede l’assegnazione di apparecchiature specifiche per la produzione musicale, dedicata alla memoria di Marcello Mormile, fondatore del festival di musica elettronica Nu Fest e primo promotore del progetto.

È prevista una masterclass dal titolo I sintetizzatori analogici nella musica da camera di oggi tenuta da Francesca Guccione, compositrice e violinista italiana. Nata in Sicilia e appassionata di viaggi, unisce gli studi di violino con quelli di composizione e di scrittura cinematografica. Nella sua musica esplora il rapporto tra suono e immagine, ispirata dai colori della sua terra e dai luoghi che ha visitato.
A conclusione del seminario, il 5 agosto alle 21.30 Francesca Guccione si esibirà in un concerto per violini e sintetizzatori aperto al pubblico. La sua musica sognante e poetica, in bilico tra realtà e immaginazione, trasporta il pubblico in mondi interiori dall’atmosfera magica. Lucrezia Sillo
ENG E lectronic music calls Germany home, the land where Kraftwerk was born, which many regard as the first real electronic music band. As a genre, it is often regarded as whatever music is produced with solely electronic or digital instruments – opposite acoustic instruments – but, in fact, remains one of the least understood genres and one of the hardest to define. The Venice Jazz Festival, in its work to sponsor the creativity of young artists, will hold the MOOG Summer Camp on August 3 to 5, a seminar dedicated to MOOG and electronic synthesizers. Directing the seminar is Enrico Cosimi, one of the best experts in sound synthesis worldwide as well as musician himself, composer, and teacher. Concluding the seminar, on August 5, Francesca Guccione will perform in a violin-and-synthesizer concert (free admission).
Da Simona Severini a Erica Boschiero, da Silvia Donati a Ilaria Fantin, le più belle voci femminili in Italia e non solo cantano anche quest’anno per le donne del mondo in difficoltà in occasione di Women For Freedom In Jazz, la maratona estiva veneziana di concerti a cena e solidarietà a sostegno dell’organizzazione umanitaria Women for Freedom, sulla terrazza panoramica dell’Hotel Carlton on The Grand Canal di Venezia, dal 6 luglio al 7 settembre, ogni giovedì alle 20.30. Antico con moderno, tradizioni e culture lontane con sperimentazioni contemporanee si mescolano e si contaminano nelle proposte delle voci protagoniste del cartellone dell’edizione 2023. Il 20 luglio la storica etichetta Caligola Music, che conferma per il secondo anno la collaborazione con la manifestazione, ci porta in viaggio in Sudamerica, lungo le Ande, attraverso le vibrazioni del Cuarteto Remedio, di nuova formazione e composto da Laura Vigilante, voce, David Soto Chero (chitarra, cuatro, charango), Alberto Zuanon (contrabbasso, voce) e Sergio Marchesini (fisarmonica), che per Caligola ha appena pubblicato il nuovo album Semillas.

Women For Freedom In Jazz è una rassegna musicale nata nel 2017 da un’idea di Elena Ferrarese con l’intento di supportare attraverso la musica l’organizzazione umanitaria indipendente, apartitica e laica, fondata nel 2014 con l’obiettivo di aiutare donne e bambini a raggiungere la libertà e il pieno godimento dei diritti fondamentali, offrendo protezione, educazione, assistenza e riabilitazione alle vittime di traffico umano, sfruttamento sessuale, violenza e povertà e promuovendo una cultura del rispetto.
7. Women For Freedom In Jazz 6 luglio-7 settembre Hotel Carlton on the Grand Canal www.womenforfreedom.org
Canta amori, sofferenze e vita vissuta, nostalgico e malinconico come in un film di Woody Allen. Sognatore e poeta, i punti di riferimento di Damien Rice sono Leonard Cohen e Nick Drake. Il suo animo nomade lo ha portato a cantare per le strade viaggiando di città in città. Un artista dal carattere ombroso, che nel corso della sua carriera ha rilasciato pochissime interviste e che non si adegua ad alcun codice meccanico dello show-biz. Proprio per le richieste troppo esigenti della casa discografica nel 1999, poco prima di firmare un nuovo contratto, abbandona i Juniper, band con cui aveva iniziato la carriera artistica, perché fare musica «era diventato un lavoro». Decide allora di lasciare tutto, trasferendosi in Toscana per lavorare in una fattoria. Poi capisce che ha ancora molto da condividere con la musica e torna a Dublino pubblicando O, il suo primo album da solista destinato a un meritato ed inevitabile successo internazionale.
«And so it is», basta questo primo breve verso per riconoscerla: The Blower’s Daughter è la canzone più celebre dell’artista, capace di emozionarci ad ogni ascolto ed emblema della sua arte. Un concentrato di pura introspezione, in cui Damien decifrando sé stesso ci regala brani che parlano di emozioni ed esperienze che abbiamo più o meno tutti vissuto. Come lui stesso afferma, i suoi brani «parlano della gelosia, dell’insicurezza, del dolore, della frustrazione, dei fraintendimenti. Più che canzoni d’amore sono canzoni sugli esseri umani che cercano di capire l’amore, ma che alla fine non lo capiscono».
Damien Rice è un artista che ha dimostrato quanto si possa avere successo restando sé stessi, senza scendere a compromessi che spesso ci allontanano troppo da quello che siamo. Fa le cose decisamente a modo suo Rice: solo tre album in vent’anni di carriera; i suoi tour sono composti da poche date, perché «troppe date tolgono energia. Preferisco non esagerare, concedermi dei giorni liberi tra un live e l’altro». Palco in penombra, lui illuminato da qualche faretto, giochi di ombre e riflessi. Nei suoi concerti punta tutto sulla semplicità, sulle emozioni e sull’empatia con il pubblico; esibizioni che restituiscono appieno il suo carattere, la sua profonda identità introspettiva. Un’atmosfera onirica e malinconica è quello che ci aspettiamo per le prossime date italiane, di cui una alla Fenice l’11 luglio firmata Veneto Jazz. Lucrezia Sillo

Una casa aperta alle comunità, dove la storia aiuta a leggere il presente e offre strumenti per entrare nel futuro. A house open to communities, where history helps read the present and offers tools to step into the future.


La musica da sempre accompagna la storia dell’uomo. È legata a riti, tradizioni, cultura, è lo specchio della società. I cantautori sono stati la colonna sonora della mia giovinezza, i loro testi riportavano le speranze, le lotte, il cambiamento di quegli anni, ma sapevano anche coinvolgere raccontando emozioni, sentimenti, amore. Incontro oggi un cantautore, Gerardo Balestrieri, che ha deciso di vivere a Venezia, non in un luogo qualunque ma in luogo incantato: la celebre Corte Sconta di Hugo Pratt e del suo Corto Maltese, quel marinaio libero che trasporta il lettore in atmosfere esotiche, avventure senza tempo, luoghi magici. Proprio ispirandosi a Pratt, Balestrieri nel 2019 ha pubblicato Canzoni del mare salato, concept album dedicato a Corto Maltese. Cantautore raffinato, colto, polistrumentista, Balestrieri è un artista completo, più volte premiato al Premio Tenco. Il suo è uno straordinario mix di jazz, swing, ritmi contagiosi, echi gitani, stile greco, atmosfera francese, twist e Sud America, con la sua voce profonda canta in diverse lingue e dialetti: italiano, francese, inglese, greco, spagnolo e napoletano. I suoi testi sono poetici, alti e leggeri al tempo stesso, vi troviamo sarcasmo e ironia, metafore, giochi di parole che evocano viaggi, romanzi, magia. Nato in Germania, esordisce nel 2007 con l’album I nasi buffi e la scrittura musicale. Nel corso della carriera ha pubblicato 12 album tra cui Dancing, Rue de la Paix, Elettro gipsy, Pandemika. Da poco è uscito in digitale The Best OF, la raccolta della maturità in cui attraverso diciotto canzoni riassume il suo percorso artistico dagli inizi ad oggi. Ha lavorato per il teatro e per il cinema, ha tenuto concerti in tutta Europa e ha fatto un lungo tour dal vivo in California. Vanta molte collaborazioni con artisti come Mosheen Namjoo, Arturo Brachetti, Daniele Sepe.
È appena uscito il suo ultimo album The Best OF, come definirebbe questo lavoro?
Lo considero come una raccolta dopo la semina. È una sintesi di 15 anni di attività discografica, un modo per ripartire con un’età più matura e con le canzoni stesse che son cresciute in questi anni. Infatti dei 18 brani contenuti nell’album (più una bonus track), 6 li ho registrati di nuovo proprio quest’anno tra Venezia, Napoli, Dusseldorf, Tolosa, Torino e Los Angeles.
Come considera la sua personalità artistica?
Mi è stato “accollato” il termine “apolide” agli inizi della mia avventura discografica e credo sia una giusta definizione. Per vicissitudini
esistenziali ho girato molto, nella mia vita. Sono nato e ho vissuto a Wuppertal in Germania, poi in Alta Irpinia, Napoli, Piemonte, Francia. Da 15 anni circa, sono veneziano.
Chi sono i suoi maestri che l’hanno “spinta” verso questo mondo?
Il primo in assoluto, ancora bambino, credo sia stato mio padre e un signore che suonava la fisarmonica. In età matura ho ascoltato tanto Paolo Conte e Fabrizio De Andrè, Tom Waits e altri ancora.

Qual è la canzone che vorrebbe aver scritto?
Tanti auguri a te, che pare abbia reso 50 milioni di dollari in diritti d’autore prima che diventasse di dominio pubblico! Seriamente, Alle prese con una verde milonga di Paolo Conte
Perché ha scelto Venezia come città in cui vivere?
Ho visto Venezia per la prima volta nel 2001, dovevo trasferirmi con la mia compagna dell’epoca. Poi la vita ha fatto uno dei suoi giri e ci sono arrivato da solo nel 2007. La scelta è stata dettata dalla bellezza in tutte le sue forme che questa città esprime, dal suo essere multiculturale e naturalmente anche dalla musica.
Ora è partito il suo tour, dove potremo ascoltare dal vivo la sua musica?
Sono in tour da giugno. Ho presentato il disco a Roma, Milano, Napoli, Venezia. Altre date sempre veneziane sono in programma a luglio. Il resto del tour è in divenire. Sono alla ricerca di un’agenzia che si occupi della promozione dei concerti. Per il momento... suono.
Tiziano Ferro è un artista che sa cosa vuol dire fare la gavetta. Ha iniziato la sua carriera vent’anni fa, quando i social non esistevano e bisognava viaggiare e mostrare la propria faccia per farsi conoscere. Se li ricorda bene i primi concerti in locali quasi vuoti e poi, anno dopo anno, con un pubblico sempre più numeroso fino alla consacrazione con il terzo disco e un concerto al Forum di Assago. Una carriera artistica segnata da una vita personale non libera da ostacoli. Il bullismo al liceo, la depressione e poi nel 2010 la scelta coraggiosa di fare coming out, quando non era ancora una decisione scontata, quanto piuttosto un possibile, potenziale suicidio artistico. «Goditi il trionfo, crea il tuo miracolo/cerca il vero amore, dietro ogni ostacolo». Tiziano è sicuramente riuscito a creare il suo miracolo: il successo internazionale, il matrimonio, i figli e i vent’anni di carriera da festeggiare con un tour posticipato a causa del Covid. Finalmente il ritorno nel 2023, dopo sei anni lontano dai palchi, con un programma di 14 date partendo da San Siro, con ben tre concerti. «E in ogni stadio c’è una storia/ il timore, l’amore», una storia che i fan dell’artista hanno contribuito a creare in tutti questi anni e a cui hanno preso parte in tutti i suoi tour, e che sicuramente vivranno anche al concerto del 14 luglio all’Euganeo di Padova.

«Ed una voce, un coro, che spaccano il cielo». È questa l’aspettativa per il nuovo tour negli stadi, al cui straordinario successo in termini di pubblico l’artista non può che essere immensamente grato: «Ho visto troppe lacrime, troppo dolore per dimenticarmi quanto sia importante e unico questo appuntamento».
Lucrezia Sillo
Gli anni ’90 sono stati anni cruciali e contraddittori per il panorama musicale, fatti di addii e nuove nascite: Freddie Mercury e Kurt Cobain che ci lasciano prematuramente, i Pink Floyd che si sciolgono, così come i Guns N’ Roses, e, dopo un breve, folgorante ritorno, i Velvet Underground che si riaccomiatano definitivamente. Nascono gli ultimi grandi gruppi rock destinati a restare nella storia come gli Oasis e i Radiohead e si assiste alla consacrazione del rap. Tra grunge e britpop, questi sono anche gli anni che proprio nella loro intrinseca contraddizione vedono la nascita dei Placebo: uno degli ultimi sospiri della lunga onda punk e della new wave, contraddistinto da un evidente stile glam rock alla David Bowie. Proprio lui li volle sul palco per aprire i suoi concerti, benedicendone il successo e sancendone l’inevitabile consacrazione.
Il Duca Bianco non si sbagliava, i Placebo avevano davvero qualcosa da dire e i loro vent’anni di carriera dimostrano come siano riusciti ad andare incontro ai cambiamenti cogliendo e restituendo in musica le difficoltà esistenziali delle nuove generazioni. Nel 1996 cantavano «Alcoholic kind of mood/lose my clothes, lose my lube/Just another nancy boy/woman man or modern Monkey/just another happy junkie»: Nancy Boy diventa il loro pezzo identificativo, in grado di incarnare rabbia giovanile e vuoto esistenziale, droga e ambiguità sessuale, angosce di una generazione che in fondo guardava ancora al futuro con celato ottimismo. Poi gli anni Zero: nuove crisi, nuove esigenze e nuovi ostacoli. Il gruppo si evolve, si interessa a nuovi temi e va verso un sound più elettronico, senza tuttavia mai rinnegare le origini punk.
Nel 2016, dopo il tour per festeggiare i vent’anni dal loro primo album, arrivano a un bivio: sono stanchi e credono di essere finiti, «intrappolati in un meccanismo commerciale di autocelebrazione» a loro dire, ma affrontano la crisi e cominciano a lavorare ad un nuovo disco. «Vorrei scrivere qualcosa che riflettesse il dolore, la sofferenza e la frustrazione che proviamo come esseri umani ogni giorno. Il processo creativo si sta svolgendo al contrario, parto dal titolo del pezzo per poi costruire il testo e la melodia», così Brian Molko, voce e frontman del gruppo, illustra l’essenza del progetto.
Il loro ultimo album pubblicato nel 2022, Never Let Me Go, risponde alla crisi e alle paure che affliggono questi nuovi anni ’20, dalla crisi climatica alla piaga del capitalismo e l’ossessione per la ricchezza, fino alla saturazione tecnologica e alla esasperata mancanza di privacy. Il 18 luglio li vedremo salire sul palco dell’Anfiteatro Camerini, a Piazzola sul Brenta. Lucrezia Sillo
«Ho una missione: avere un buon impatto sulla vita delle persone». Quando si dice avere ben chiaro cosa fare della propria vita, Kendrick Lamar potrebbe essere preso ad esempio.

Dalle parole e dai gesti di quello che viene definito il “Re del rap” traspare un grande senso di calma e tranquillità, che quasi sembra cozzare con il magmatico brulicare di idee che nella testa del nostro albergano, diffuse al suo sterminato pubblico attraverso rime licenziate a spron battuto.
Qualcosa sta decisamente cambiando se Kendrick Lamar è stato il primo musicista non-classico e non-jazz a ricevere il Premio Pulitzer per la musica, il più prestigioso riconoscimento per la produzione ‘colta’ negli Stati Uniti. Il rapper ha ottenuto il premio per DAMN, disco del 2017 unanimemente acclamato come un capolavoro e oggetto di stima da parte di Barack Obama, sempre attento ricercatore di spunti di riflessione politica e sociale, da ovunque essi provengano.
Il passo del comitato del Pulitzer, della Columbia University di New York, è stato però più radicale e lungimirante: Lamar non è solo un afroamericano, ma un musicista di umile estrazione, cresciuto nei quartieri popolari di Compton con una storia familiare non sempre facile (come lui stesso racconta in un brano del disco premiato). Ed è per giunta un musicista non ancora quarantenne e nel pieno della carriera, non certo una vecchia gloria pacificamente accettata da tutte le comunità e da tutti i pubblici americani.
Il rapper, cantautore e produttore discografico statunitense arriva all’Arena di Verona il 17 luglio fresco del trionfo registrato ai Grammy Awards 2023, dove (dopo ben otto nomination) si è portato a casa tre premi, nelle categorie Best Rap Album, con Mr. Morale & The Big Steppers (quinto album in studio, pubblicato il 13 maggio 2022), e Best Rap Song e Best Rap Performance con la canzone The Heart Part 5

Nato nel 1987 in California, nella Contea di Los Angeles, Lamar si è buttato a capofitto fin da giovanissimo nelle sette note. Nel 1995 ha assistito alle riprese del videoclip di California Love di Tupac e Dr. Dre. Il primo vero faccia a faccia con un microfono arriva nel 2004, quando con pseudonimo K-Dot fa uscire il suo primo mixtape, Y.H.N.I.C. Seguono altri mixtape, un EP e l’apparizione nel video musicale del singolo All My Life (In the Ghetto) di Jay Rock. Nel 2009 la svolta: cambia identità artistica, abbandonando quel nickname e ritornando al suo vero nome. Lamar inizia a collezionare collaborazioni di prestigio con artisti del calibro di Dr. Dre, The Game, Drake, Young Jeezy, Talib Kweli, Busta Rhymes e Lil Wayne. Nel 2011 pubblica il suo primo album in studio, intitolato Section.80, che sei anni dopo ottiene la certificazione d’oro. A meno di un anno di distanza dal suo ultimo concerto italiano, uno dei massimi esponenti della scena musicale mondiale è pronto per tornare nel nostro Paese mandando in visibilio il proprio folto e affezionatissimo pubblico. Vederlo esibirsi in un luogo tanto meraviglioso e iconico come l’Arena di Verona rende lo show, se possibile, ancora più imperdibile. D.C.
Si tiene a Venezia l’11, il 14 e il 15 luglio Boato, il festival organizzato dal collettivo Cult of Magic, già parte del public program de La Biennale di Venezia. Un progetto unico che prenderà vita l’11 luglio in zona San Marco con il Cult of Magic Analog Techno Live Set e si sposterà poi sul Vaporetto dell’Immaginario il 14 luglio con Francesco Sacco live + Re Penelope e il 15 con This Little World’s Too Crowded Now + Cult of Magic Analog Techno Live Set. Il Vaporetto dell’Immaginario è un battello storico ormeggiato all’isola delle Vignole, vero e proprio paradiso naturalistico situato nella parte nord est della laguna, comodamente raggiungibile con il trasporto pubblico.

Boato 11, 14, 15 luglio Piazza San Marco paroleedintorni.it
La magia dell’arpa in uno dei luoghi più iconici di Venezia: il giardino delle sculture della Collezione Peggy Guggenheim. Grazie alla collaborazione tra Pro Helvetia in Venice e il museo di Dorsoduro, nell’ambito del progetto multidisciplinare New Echo System. Protagonista è una delle figure più originali della scena musicale svizzera, l’arpista Julie Campiche, che dopo il passaggio al prestigioso Montreux Jazz Festival dell’8 luglio conclude il proprio tour in solo circondata dai capolavori della prestigiosa Collezione. Un’occasione per vivere da una prospettiva unica la forza e l’intimità della musica della Campiche, che con il proprio strumento e l’elettronica avvolge chi l’ascolta in una sorta di umanissima nuvola di sogni.
J ulie Campiche 12 luglio Collezione Peggy Guggenheim www.guggenheim-venice.it
Arrivato alla diciottesima edizione, il festival di Sesto al Reghena anche quest’anno apre il proprio scrigno agli intenditori con una settimana di musica di cui non sai se ammirare di più l’accortezza nell’offrire un palinsesto di nomi tutti molto à la page su cui è sorto da poco il sole della notorietà internazionale, o l’intelligenza interpretativa che sta dietro a questa scelta sulle correnti e sulle dinamiche molteplici che innervano la musica popolare oggi. Non è quindi un caso che orgogliosamente ci si fregi della nuova espressione boutique festival, ad indicare uno spazio dove la musica non si limita a essere consumata, e questo grazie anche alla strepitosa location di piazza Castello dominata dalla torre campanaria di origini medievali. Si comincia il 6 luglio con Hania Rani, giovane pianista e compositrice polacca divenuta negli ultimi anni la star nascente della cd musica neoclassica, il cui disco del 2021 Inner Symphonies è stato pubblicato dalla storica casa discografica tedesca Deutsche Grammophon. Il 7 luglio arrivano i King Hannah, duo di Liverpool il cui primo disco, I’m not sorry, I was just being me, uscito nel 2022, ha trovato un notevole successo internazionale. La musica del duo non mi viene da definirla altro che ‘atmosferica’, nel senso che le loro canzoni di graffiante malmostosità sono fortemente esposte al turbinìo degli elementi, sotto forma di artigliate di chitarre elettriche ululanti e intorbidite cui si accompagna la voce scabra della cantante, che tesse ruvide trame vocali sopra una ritmica lenta ed oppiacea. Interessanti. L’8 luglio arrivano i Verdena, storico gruppo indie di Bergamo in pista da 30 anni circa, e che è sempre riuscito a mantenere una sua precisa connotazione fatta di autenticità e di uscite discografiche piuttosto rarefatte. Il 9 luglio è la volta di Ben Howard, musicista inglese autore di un folk un po’ nostalgico che però nei giorni scorsi è uscito con un disco, Is it?, in completa distonia rispetto alla produzione precedente, percorso da brividi elettro-pop e con uso massiccio di strumenti digitali. Si chiude l’11 luglio con l’unica data italiana dei Dry Cleaning, gruppo della South London che si caratterizza per l’uso di testi parlati, quasi in uno stato di trance, da parte della cantante Florence Shaw, mentre i suoi tre compagni inanellano ritmi e riff che ricordano molto le grandi band post-punk inglesi. F.D.S.


Il Vittoriale degli Italiani a Gardone Riviera, sulla sponda bresciana del lago di Garda, è la residenza museo di Gabriele D’Annunzio, luogo divisivo, che si ama o si detesta, ma che certo non lascia indifferenti i visitatori con le sue atmosfere tra l’onirico e il gotico. Nel magnifico parco, immerso tra dolci declivi rivolti alle acque lacustri e le fronde ombrose di alti alberi, sorge un Anfiteatro che pare sospeso tra le suggestioni mesmerizzanti del Vittoriale e il lago, completato nel 2020 secondo il progetto originario di Gabriele D’Annunzio e sontuosamente rivestito in marmo rosso di Verona.
Con la direzione artistica affidata dal Presidente della Fondazione Il Vittoriale degli Italiani, Giordano Bruno Guerri a Viola Costa (Ripens’arti), il Festival musicale Tener-a-mente presenta vari appuntamenti, fino al 26 luglio. L’attesa rassegna, che ha vissuto negli anni un crescente successo registrando quasi sempre il sold out spaziando tra esclusive nazionali, sperimentazione, artisti internazionali e grandi cantautori italiani, ha preso il via con Mannarino proseguendo con James Bay e ancora Nils Frahm, per poi passare a Venerus. Atteso il concerto di Fiorella Mannoia e Danilo Rea il 9 luglio, così come quello di Dean Lewis il 12. Tra gli appuntamenti imperdibili anche il cantautore irlandese Damien Rice il 15 luglio, pochi giorni dopo il suo passaggio alla Fenice di Venezia. Da segnalare anche i live di Hozier il 16 e dei Kaleo il 17. Il 19 è la volta di Tom Odell, mentre il 21 sale sul palco la leggenda Herbie Hancock. E ancora, il 22 il concerto di Fabio Concato e quello di Jacob Collier il 23 luglio. Chiudono la kermesse il concerto di Stewart Copeland, il mitico batterista dei Police il 24 e il concerto di Nick Mason, il batterista dei Pink Floyd il 26 luglio. Per gli amici dei 4 zampe va segnalata un’interessante iniziativa volta a promuovere l’accesso in teatro ai cani, garantendo un’accoglienza speciale nella platea dell’Anfiteatro del Vittoriale con posti speciali dotati di ciotole per l’abbeveraggio, biscotti ed altri servizi offerti ai visitatori che desiderano partecipare ai concerti con il proprio cane. Per ogni spettacolo sono garantiti 16 posti evidenziati dal simbolo della zampa.
E poi c’è il Vittoriale, quel complesso di edifici, vie, piazze, giardini e corsi d’acqua eretto tra il 1921 e il 1938, su un sito precedente, che merita di essere visitato con i suoi ossimori estetici e le follie di un genio visionario. Una destinazione perfetta per una notte d’estate, tra musica di gran classe e il fantasma ingombrante di un uomo controverso, certo, ma faro indiscusso per la cultura mondiale. F.M.

Il proposito era quello di non iniziare l’articolo con il solito ritornello su quanto sia difficile portare avanti una rassegna musicale in Italia. Davvero, le intenzioni c’erano tutte. Poi però ci si imbatte nel programma dello Sherwood Festival, precisamente nelle serate “1 euro può bastare”, e tutti i buoni propositi vanno bellamente a farsi benedire.
Sì, perché la possibilità di vedere Carmen Consoli e Marina Rei, Dub FX, Andrea Pennacchi, Kabaka Pyramid, Giancane per una spesa totale di meno di 10 euro credo non abbia eguali in Italia, quando il portafogli piange spesso e volentieri e andare ad un concerto diventa un lusso riservato a pochi.
Sherwood Festival, che per 30 giorni rende vivo il Parcheggio Nord dello Stadio Euganeo, è possibile grazie alla passione e alla cooperazione collettiva di centinaia di attiviste e attivisti degli spazi sociali del Nordest, associazioni culturali, sportive, di volontariato sociale e decine di volontari che ogni anno rispondono all’accorato appello degli organizzatori per collaborare alla riuscita del Festival.
Fino al 15 luglio con la consueta suddivisione tra Main e Second Stage la musica torna al centro di quel villaggio che ormai ogni estate si insedia nel Park Nord dello Stadio Euganeo, a sua volta teatro dei grandi eventi musicali dell’estate quest’anno con Rammstein, Mengoni e Ferro.
Nella Foresta di Sherwood a giugno il pubblico ha potuto incontrare Verdena e Ska-P, oltre alle sopracitate Consoli e Rei, per concerti ad alto tasso qualitativo, con in particolare la band bergamasca dei fratelli Ferrari tornata live dopo sette anni con Volevo magia. Luglio non può in alcun modo essere da meno, a partire dalla parentesi teatrale con un purosangue come Andrea Pennacchi e proseguendo con i Baustelle che in aprile hanno pubblicato Elvis, dopo 4 anni di elaborazione.
Il programma come al solito è bello perché è vario, in grado di accontentare ogni padiglione auricolare che bazzichi da quelle parti. Siete scettici? Il folk rock cantautorale di Giancane (5), il reggae proveniente da Kingston di Kabaka Pyramid (7), i Calibro 35 e il loro rock strumentale (8), il rapper, produttore e cantautore Carl Brave (11) rappresentano le date campali di un luglio da godersi al fresco delle fronde di Sherwood, magari con un filo d’erba in bocca…

S herwood Festival
Fino 15 luglio Park Nord Stadio Euganeo-Padova www.sherwoodfestival.it

Lo slogan “More than a Reggae Festival” non è semplicemente uno slogan per l’Overjam International Festival, che torna ad animare con l’undicesima edizione le rive del fiume smeraldo della meravigliosa Valle d’Isonzo, a Tolmino dal 16 al 20 agosto. Immerso nella natura incontaminata ai piedi del Parco Nazionale del Monte Triglav, il coloratissimo villaggio di Overjam prende vita e richiama appassionati di musica reggae e festivalieri da tutta Europa con un programma che assicura la presenza di grandi star della scena reggae internazionale, ma anche l’occasione di scoprire nuovi talenti emergenti e molte proposte di altissima qualità che spaziano nella musica giamaicana a 360 gradi. Il programma dei cinque palchi è semplicemente sterminato e per fare la vostra scelta vi rimandiamo al sito che trovate in calce, anche se il nostro caldissimo consiglio è di non scegliere affatto e optare per la formula abbonamento! Vi basterà sapere che a calcare il palco principale ci sono personaggi del calibro di Anthony B, tra le voci piu influenri del panorama reggae mondiale, fiero portabandiera della cultura Rastafari, Barrington Levy, detto anche la “golden voice” della dancehall giamaicana, Steel Pulse, la leggendaria band di Birmingham dal 1975 sulla scena, l’eminente dj e producer Mad Professor, o King Jammy, leggasi anche il padre della Digital Dancehall giamaicana, che all’Overjam concede il suo unico show europeo. E per fare qualche altro nome: Dubioza Kolektiv, il misterioso collettivo L’Entourloop accompagnato dall’incredibile MC bermudiano Troy Berkley e dal maestro N’Zeng alla tromba, Seun Kuti, figlio di ‘quel’ Fela Kuti che diede vita all’Afrobeat, nuovi e ruggenti leve della scena giamaicana come Lila Iké e Jaz Elise, Stylo G, Warrior Sound Intl, Wicked Dub Division con North East Ska Jazz Orchestra, Jah Sun e moltissimi altri. Sul palco dub, Dub Ville, troviamo invece Aba Shanti-I, Weeding Dub, Channel One, Anja G & Dr. Obi e Mystical Sound, Warrior Charge Sound System & MC D-Vibe al comando. Come sempre, ci sarà anche un palco dedicato alla dancehall con Triggafinga Intl. a fare gli onori di casa; torna la musica in spiaggia con il Beach Stage, a cura di Roots in Session Sound System, e il palco Jammin’, con sound come Freedom Fighters, Ljubljanjah Vibes, Jamcoast Family e Kings HiFi & Friends. Quindi, sì, tanta tanta musica, ma la vibrazione positiva di Overjam offre un’esperienza che va oltre con un foltissimo programma di conferenze, workshop di ogni tipo, classi di danza, attività dedicate a bambini e famiglie, proiezioni, un colorato mercatino, un camping attrezzato, food truck da tutto il mondo e cibo originale giamaicano preparato dal team dell’Overjam. Una vera e propria fuga da Babilonia… remembering Zion !
Chiara SciasciaAd un nome del genere, francamente, non ero del tutto preparato. Andando a scorrere il programma del No Borders Music Festival, preziosa occasione per godere di grandissima musica ad alta quota, con la quinta naturale tra gli altri di uno dei più belli laghi alpini di cui il nostro Paese disponga, il Lago di Fusine, trovare gli Skunk Anansie mi ha fatto lo stesso effetto di quando ci si imbatte in un fiore splendido, raro, difficile ma non impossibile da trovare a determinate latitudini.
Gli Skunk Anansie, musicalmente radicali dalla nascita, portano il 22 luglio sul palco del No Borders la loro essenza fatta di miscela di influenze, culture e personalità. Emotivi, carichi, conflittuali e teneri, sapranno regalare al pubblico del Festival un concerto unico nel suo genere, di questo possiamo essere assolutamente certi, dopo che nel 2019 hanno tracciato un bilancio in musica della loro sfolgorante carriera con la personale pietra miliare, 25LIVE@25, un album dal vivo che ha riunito le più grandi canzoni dei sei album in studio realizzati negli anni precedenti.

Dopo i Baustelle, il 2 luglio, ad offrire al pubblico le loro ultime riflessioni musicali, il programma si districa con il solito equilibrio tra il cantautorato di Ben Harper (15 luglio), sempre a proprio agio tra le vette, e quello di Mannarino (16 luglio). Già ospite del Festival lo scorso anno con un doppio appuntamento, di cui ricordiamo un concerto in notturna in alta quota a Sella Nevea, tra i luoghi più suggestivi delle Alpi Giulie del Tarvisiano, Mannarino si conferma cantautore dall’animo generoso e dalla penna sempre efficace.
Il 20 luglio ecco LP, per la prima volta al Festival d’altura, artista senza limiti di genere, con un’identità forte, cantante multiplatino con oltre tre miliardi di stream, più di un milione di visualizzazioni al giorno e oltre sette milioni di ascoltatori mensili in tutto il mondo.

Mika il 23 e Stefano Bollani insieme a Trilok Gurtu il 29 luglio riescono a saziare la voglia di pop intelligente e jazz alla massima qualità disponibile, con questi ultimi insieme per la prima volta sull’altopiano del Montasio.
In chiusura di edizione, il 30, ecco il piano solo acustico di Benjamin Clementine, vincitore del Mercury Prize torna nel Tarvisiano carico di nuove esperienze e un nuovo album, uscito il 28 ottobre scorso, And I Have Been Artista singolare che offre stile, equilibrio e poesia, Clementine condivide con il pubblico del No Borders il suo intimo mondo sperimentale e d’avanguardia, libero da frivolezze e dalla forte ispirazione letteraria.
Scorrendo le line up delle edizioni passate, il primo pensiero che viene spontaneo è quello di un Festival capace di cambiare pelle. In principio fu Asolo ad ospitare la rassegna, fin dal 2017 in grado di arruolare per la causa nomi come Calcutta, Tre Allegri Ragazzi Morti, Kula Shaker e Motta, a dimostrazione di non trovarsi di fronte all’ennesima manifestazione acchiappa-spettatori quanto piuttosto ad una piantina appena nata, sì, ma da annaffiare con costanza. Nomi come Interpol, Baustelle, Brunori Sas, Cosmo, Ska-P e Guè Pequeno sanno proprio di salto di qualità: se vi dicessi, per esempio, che l’anteprima di quest’anno è affidata ad un duo di musica elettronica composto dai britannici Ed Simons e Tom Rowlands, cosa mi direste? Si fanno chiamare The Chemical Brothers… suona qualche campanella? Assieme a Prodigy e Fatboy Slim hanno ‘semplicemente’ inventato la big beat, arrivando a Villa Ca’ Cornaro di Romano d’Ezzelino l’8 luglio per una data che verrà ricordata a lungo, statene certi.
E dopo un aperitivo l’8 luglio con i suddetti e concerti di Bloody Beetroots e Motel Connection, ci si dà appuntamento dal 23 al 27 agosto per il corpus principale della rassegna, succosa e varia come sempre fin dal primo appuntamento in compagnia di Salmo, rapper e cantautore torinese tra i più progressisti e influenti artisti della scena italiana contemporanea.
A voler individuare una tinta dominante in questa edizione andremmo sicuramente sul dark, con una piacevole altalena in equilibrio tra nomi nuovi del panorama metal e rap assieme a mostri sacri del settore: tra 24 e 25 agosto se è dell’hip hop che siete adepti ecco ben tre occasioni di puro godimento acustico con Cypress Hill, Colle der Fomento e Articolo 31, mentre se siete in cerca di qualcosa di ancora più forte la ditta AMA può offrirvi nientemeno che gli italianissimi Lacuna Coil di Cristina Scabbia e Megadeth di Dave Mustaine. Annoverati tra i gruppi thrash metal più influenti del mondo, i Megadeth sono nati a Los Angeles nel 1983 e con la loro musica veloce, aggressiva e complessa, hanno contribuito alla definizione vera e propria del genere. Hanno venduto oltre 38 milioni di dischi in tutto il mondo, con 5 album consecutivi certificati disco di platino nei soli Stati Uniti. Nel corso della loro lunga carriera i Megadeth hanno collezionato 11 candidature e una vittoria ai Grammy Award nella categoria Best Metal Performance e mantengono intatta la capacità di offrire ancora oggi uno spettacolo dal vivo coinvolgente e di altissima qualità. Davide Carbone
Hostaria in Certosa – Crocodiles in Venice, un’alternativa musicale per le domeniche d’estate sul pontone fronte laguna all’isola della Certosa. Una festa che inizia alle 17 e vede alternarsi alla consolle Dj di fama internazionale con la certezza del brand Alajmo a garantire la qualità del servizio extra musica. Drinks e cibo perfetti per unire il piacere di una fine giornata estiva in uno dei luoghi più vitali della Laguna. Che si raggiunga in barca o col vaporetto poco conta, quando si arriva alla Certosa si viene abbracciati da una travolgente onda di serenità sonora che rende contagiosa la voglia di lasciarsi andare, divertendosi senza pensare al lunedì. L’atmosfera sospesa, i riflessi del sole che lentamente scivola verso la fine del giorno, la selezione musicale dei Dj proposti dal collettivo Crocodiles in Venice, che riporta alle più ambite mete estive del Mare Nostrum, fa della Certosa un must be in cui poter rivendicare il primato della Laguna che racchiude divertimento, cibo e tanta incomparabile bellezza a Km 0!

ENG A music-infused alternative for summer Sundays on the pontoon at Certosa Island. The party starts at 5pm and will see alternating DJs at the dome and the guarantee of the Alajmo brand for an extra special service: perfect drinks and food to pair the final hours of a beautiful summer day with one of the most vital places in the Venetian Lagoon. Whether you land at Certosa with your own boat or with the public vaporetto, you will be embraced by a wave of sound serenity that makes you let it all go and have fun. A zero-mile adventure!
Isola della Certosa
Tutte le domeniche fino al 24 settembre www.alajmo.it | crocodilesinvenice.com
Una terrazza a Murano sospesa a metà tra due canali, lo sguardo che si perde nelle vastità lagunari e un locale, Punta Conterie, in cui il design contemporaneo dialoga fieramente con la tradizione secolare del vetro di Murano. Le atmosfere della convivialità unite alla perfezione dei cocktail proposti dal più bravo di tutti, Lucas Kelm, che aggiunge una carica di umana simpatia alla capacità di mescolare tra loro gli elementi, sapendo esaltare le caratteristiche di ogni ingrediente. Il posto perfetto per indugiare pigramente in compagnia di musica eseguita anche dal vivo e dove non servono pretesti per voler festeggiare. La terrazza è il luogo ideale per ascoltare i suoni dell’estate e le note della stagione calda risuonano in maniera più armoniosa se accompagnate da una brezza ristoratrice che accarezza i pensieri. Inebriati dai cocktail di Lucas Kelm tutto sembrerà più piacevole e lo scorrere del tempo assume le trasparenze e i colori dei vetri dei Maestri muranesi. Tempo fragile, ma prezioso e durevole.

ENG A terrace in Murano between two canals, an amazing view over the wild lagoon, and a restaurant, Punta Conterie, where modern design watches proudly at Murano’s blown glass traditions. An air of conviviality and Lucas Kelm’s cocktails will exalt your day as you laze about with the sound of live music, and you don’t need an excuse to have some fun. The terrace is the ideal place to listen to the sound of summer, and the notes of the warm season resonate harmoniously if accompanied by a light breeze. Try it, and everything will feel better. Time is fragile like glass, as much as it is precious.
Murano, Fondamenta Giustinian 1 puntaconterie.com



Piazza San Marco diventa ancora una volta un ineguagliabile teatro all’aperto in occasione dell’esecuzione della Nona Sinfonia di Beethoven diretta dal maestro slovacco Juraj Valcˇuha, alla testa dell’Orchestra e Coro del Teatro La Fenice, con la partecipazione del soprano Federica Lombardi, del tenore Michael Schade, del mezzosoprano Veronica Simeoni e del basso Mark S. Doss, il Coro è affidato alla direzione di Alfonso Caiani.
La Sinfonia in programma è una pagina musicale assai conosciuta e dall’alto valore simbolico che va oltre il semplice ascolto. Rispecchia la complessa personalità di Beethoven, che seppe trovare la sua espressione più compiuta e più alta nella musica sinfonica: le sue 9 Sinfonie, che lo impegnarono negli anni compresi tra il 1800 e il 1832 esprimono la forza esplosiva ed innovativa della sua energia musicale e dischiudono un universo di suoni in cui il mondo interiore di Beethoven si dispiega in tutta la propria complessità.
La Nona ed ultima Sinfonia, concepita nella commovente tonalità del re minore, è da considerarsi come un capolavoro assoluto, sintesi suprema di valori etici e di sentimenti profondissimi.
L’innovatività di Beethoven è palese nel superamento dei confini tra i generi musicali: mai nessuno prima di lui aveva osato introdurre in una composizione sinfonica quattro voci soliste e un coro di uomini e donne. Con un’operazione oltremodo audace affidò ai solisti e al coro
il compito di chiudere questo possente lavoro sinfonico, nel quale inserì alcune strofe dell’Inno alla Gioia di Schiller, che tanto sentiva vicino per la complessità del suo mondo spirituale. Una scelta che va spiegata attraverso motivazioni non esclusivamente stilistiche e musicali; integrare la sinfonia con le parole di un componimento di Schiller significava inserire dei contenuti ideologici che, attraverso un testo scritto, mostravano chiaramente gli ideali morali che animavano Beethoven: l’aspirazione alla fratellanza universale tra gli uomini in nome del comune dolore, il superamento della sofferenza in una superiore Armonia del Cosmo e il fondamento della Gioia sull’amore per un Padre Celeste che non ha nome.
Emerge qui, tanto nella Sinfonia di Beethoven quanto nei versi di Schiller, un profondo anelito all’Assoluto e il desiderio di conquistare valori immortali di Grandezza e di Fede che lo avvicinino a Dio. Si tratta di un elemento rivelatore, che ha dato adito nel passato alla convinzione di una possibile lettura massonica dell’opera, quantomeno nel ritenere che Beethoven fosse, come Schiller, un convinto fiancheggiatore dell’ideale massonico.
La Nona Sinfonia venne eseguita la prima volta a Vienna il 7 maggio 1824, al Theater am Kärntnertor, con il contralto Caroline Unger e il tenore Anton Haizinger. Si narra che il pubblico la accolse con grande entusiasmo, tributando a un Beethoven ormai completamente sordo, invece degli applausi, un festoso sventolare di fazzoletti. L’Inno alla gioia è stato adottato dal Consiglio d’Europa come sua ode nel 1972. Nel 1985, è diventato l’inno ufficiale della Comunità Europea e, in seguito, dell’Unione Europea.
si può mettere
di Beethoven in un diagramma cartesiano? Ci sono delle realtà che non sono quantificabili, ma semplicemente incommensurabiliJ uraj Valcˇuha | Nona Sinfonia di Beethoven
Piazza San Marco turns once again in the most beautiful open-air theatre for a production of Beethoven’s Ninth Symphony that will see Juraj Valcˇuha conduct the Fenice Theatre Orchestra and Choir.
The Symphony is a very well-known piece of classical music of high symbolic value. It goes beyond entertainment, and reflects Beethoven’s complex personality, which expressed in the highest in symphony form, indeed. Composed between 1800 and 1832, his ninth symphonies convey the explosive, innovative force of his musical energy.
The Ninth, composed in a poignant Etone, is an absolute masterpiece, a synthesis of ethical and sentimental depth. Beethoven’s modernity is apparent in the regrouping of musical genres: never before had anyone included four solo voices and a mixed choir of male and female voices. Daringly, he entrusted the solo voices and choir the finis of this powerful musical work, which integrated a few verses from Schiller’s Ode to Joy. This meant integrating ideological content that mirrored Beethoven’s own moral ideals: an aspiration to universal brotherhood, the overcoming of suffering in a higher order of harmony, and the foundation of joy upon the love of our celestial father. In Schiller’s poetry, we find a heartfelt yearning for the absolute and a desire for the immortal value of greatness and faith, which draw us closer to God. It is a revealing moment in that a parallel had been drawn between these contents and a possible masonic reading. It has been speculated that both Beethoven and Schiller espoused these masonic ideals.

The Ninth Symphony was performed for the first time in Vienna on May 7, 1824, starring contralto Caroline Unger and tenor Anton Haizinger. Legend has it that the audience loved it enthusiastically, and tributed Beethoven – by the time almost completely deaf – not with clapping, but by waving their kerchiefs.
The Ode to Joy has been adopted by the Council of Europe as anthem in 1972. In 1985, it has been adopted by the European Economic Community, which later became the European Union.

Vi sono alcuni film che godono da sempre di una popolarità straordinaria, alcuni esempi tra gli altri: Via col vento di Victor Fleming, Arancia meccanica di Stanley Kubrick, Apocalypse Now di Francis Ford Coppola, Gli ammutinati del Bounty di Lewis Milestones, Rocky di John G. Avildsen, Il Signore degli Anelli di Peter Jackson. Anche nel mondo operistico vi sono delle opere che si sono imposte perfino nell’immaginario di coloro che in Teatro non vi mettono mai piede: Aida e Traviata di Giuseppe Verdi, Tosca di Giacomo Puccini ( Vissi d’arte, la celebre aria), l’aria Nessun dorma in Turandot sempre di Puccini identificata con il popolare «Vincerò!» e sicuramente, fin dal successo straordinario del suo debutto alla volta del 1890 presso il Teatro Costanzi di Roma, Cavalleria rusticana di Pietro Mascagni. Il libretto, tratto dalla novella di Giovanni Verga da Giovanni Targioni-Tozzetti e Guido Menasci, offre una vicenda scarna, violenta, soluzione ristretta dello scontro fra forze primordiali ed arcaiche: odio, possesso, amore, prevaricazione, onore, morte, tragedia. Un gorgo denso, avvolgente e tremendo, emozionante. Cavalleria rusticana va in scena al Teatro La Fenice di Venezia da venerdì 25 agosto con l’Orchestra e coro del Teatro La Fenice diretti da Donato Renzetti. Andrea Oddone Martin
ENG Some films are legends: Gone with the Wind, A Clockwork Orange, Apocalypse Now, Mutiny on the Bounty, Rocky, The Lord of the Rings. In the world of opera, some pieces grew so famous that are known to everybody—even those who never set foot in an opera house: Verdi’s Aida and Traviata, Puccini’s Tosca, the aria Nessun dorma in Turandot, and certainly Pietro Mascagni’s Cavalleria Rusticana every since its premiere in Rome in 1890. The story is a bare, violent telling of primordial, archaic forces: hate, possession, love, oppression, honour, death, tragedy. Cavalleria rusticana will run at Fenice Theatre from August 25.
Segna il debutto in Arena del pluripremiato attore e regista Antonio Albanese la nuova produzione di Rigoletto di Giuseppe Verdi, in scena per il 100° Arena di Verona Opera Festival. Il capolavoro verdiano, in programma dal 1° luglio al 4 agosto 2023, è la seconda nuova produzione che il Festival propone nella stessa edizione, dopo l’Aida inaugurale. «Considero Rigoletto un’opera impetuosa capace di esaltare passione e amore, vendetta e potere». Queste le parole di Albanese, che con il suo spettacolo omaggia il grande cinema neorealista italiano degli anni Cinquanta. Protagonisti un poker di grandi baritoni come Roman Burdenko, Ludovic Tézier, Luca Salsi e Amartuvshin Enkhbat. Accanto a loro altre grandi voci internazionali come Rosa Feola (al suo atteso debutto in Arena), Nina Minasyan e Nadine Sierra nella parte di Gilda e Yusif Eyvazov, Juan Diego Flórez e Piotr Beczała che interpreteranno il Duca di Mantova. Sul podio dell’Orchestra e del Coro della Fondazione Arena di Verona Marco Armiliato. Le scene sono curate da Juan Guillermo Nova, i costumi da Valeria Donata Bettella, le luci da Paolo Mazzon e le coreografie da Luc Bouy. «Ci siamo orientati verso gli anni Cinquanta: un periodo ancora drammatico, precedente il boom economico – prosegue Antonio Albanese – in cui le ferite della guerra sanguinavano ancora e in molte zone del Paese, poverissime, si moriva di fame, di pellagra o di colera. Abbiamo optato per un paesaggio padano, malsano e stagnante, lo stesso che si ritrova in tanti film neorealisti che hanno saputo documentare vividamente

La lirica al centro dell’Arena© EnneviFoto
le atmosfere e le contraddizioni dell’immediato dopoguerra. Ecco perché in questo Rigoletto abbiamo avvertito l’esigenza di sviluppare un discorso coerente con quelle suggestioni cinematografiche».
Da luglio a settembre l’attività in Arena si conferma febbrile, con recite incrociate dei capisaldi lirici più famosi al mondo, dalla Carmen al Barbiere di Siviglia, passando per Tosca, Traviata e Nabucco, in un calendario impreziosito dagli eventi speciali in compagnia dei più grandi nomi della scena lirica mondiale, come i tenori Juan Diego Flórez (23 luglio) e Jonas Kaufmann (20 agosto) e gli habituè dell’anfiteatro scaligero Plácido Domingo (6 agosto) e Roberto Bolle (19 luglio) con il suo imperdibile Gala di danza. Daniele Pennacchi
ENG Award-winning opera actor and director Antonio Albanese debuts at the Verona Arena with his Rigoletto, staged expressly for the one hundredth year of the Verona Opera Festival. The masterpiece by Verdi is scheduled over the July 1—August 4 period, and will star the greatest baritones, such as Roman Burdenko, Ludovic Tézier, Luca Salsi, and Amartuvshin Enkhbat. Beside them, the great international voices of Rosa Feola (at her debut at the Arena), Nina Minasyan, Nadine Sierra playing Gilda. Conducting the orchestra and choir will be Marco Armiliato, scenes by Juan Guillermo Nova, costumes by Valeria Donata Bettella, lights by Paolo Mazzon, and choreography by Luc Bouy. Says director Albanese: “The Rigoletto is a wild piece of opera, it inflames passion, love, revenge, and power […] we set our story in the northern Italian countryside in the 1950s: a time of poverty, hunger, pellagra, and cholera. This is the same setting we know from neo-realist films that documented post-WWII Italian history.”

Poche personalità, non solo nel mondo dell’arte, hanno legato tanto il proprio destino a quello di Venezia come Peggy Guggenheim. «Si è sempre dato per scontato che Venezia è la città ideale per una luna di miele, ma è un grave errore. Vivere a Venezia, o semplicemente visitarla, significa innamorarsene e nel cuore non resta più posto per altro» recita una sua famosa frase, a testimonianza di un rapporto con la città che superò i confini del mecenatismo e dell’arte per abbracciare le sfere più intime della collezionista americana, a oltre quarant’anni dalla scomparsa ancora figura cardine del panorama cittadino, con una Collezione che è autentico fulcro dell’attività culturale veneziana.

Sarà il Quartetto della Fondazione Accademia Teatro alla Scala di Milano ad esibirsi quest’anno nel giardino della Collezione Peggy Guggenheim in occasione del tradizionale concerto per il compleanno di Peggy, sabato 26 agosto, con ingresso riservato ai soci del museo.
Durante la serata verranno suonati Wolfgang Amadeus Mozart, Quartetto in sol maggiore n.14 K.V. 387 “La primavera” e Dmitrij Dmitrievicˇ Šostakovicˇ, Quartetto per archi n. 8 Op. 110. Il Quartetto del compositore austriaco è il primo dei sei dedicati all’amico e compositore Franz Joseph Haydn, composti tra il 1782 e il 1785 e suddiviso nei seguenti movimenti: Allegro vivace assai, Minuetto (Allegro), Andante cantabile e Molto allegro.
Il Quartetto per archi n. 8 di Shostakovich si articola in cinque movimenti: Largo, Allegro molto, Allegretto, Largo, e Largo. Fu scritto, in soli 3 giorni nel luglio del 1960, poco dopo l’adesione del compositore sovietico al Partito Comunista per ricordare le vittime del fascismo e della guerra. A luglio del 1960 Shostakovich si reca a Dresda, città sottoposta a pesanti bombardamenti a febbraio, marzo e aprile 1945, dove si stanno effettuando le riprese del film Cinque giorni, Cinque notti, per il quale è incaricato dal governo sovietico di comporre la colonna sonora. A distanza di tre lustri sono ancora evidenti le tremende devastazioni della seconda guerra mondiale; profondamente turbato, Shostakovich avverte la necessità di tradurre in musica i suoi sentimenti di dolore, di condanna, di partecipazione, di ricordo delle vittime e, d’impulso, nell’arco di tre giorni, compone questo Quartetto.
Il 26 agosto del 1898 nasceva a New York Marguerite Guggenheim, meglio nota come Peggy, destinata a lasciare un segno indelebile nella storia dell’arte del Novecento, attraversando con eleganza il “secolo breve” e facendosi promotrice e sostenitrice dei maggiori movimenti d’avanguardia in Europa e in America.
Visit our current shows:
Education is the movement from darkness to light
May 20 - November 26, 2023
Open Wednesday to Monday, 11 am - 7 pm (closed on Tuesdays)
Sala Tiziano | Courtyard of Centro Culturale Don Orione Artigianelli
Dorsoduro 919 (free admittance)
Home Stage
May 20 - November 26, 2023

Open Wednesday to Sunday, 11 am - 7 pm (closed on Mondays and Tuesdays)
Next to Ponte dei Pensieri
Castello, Salizada Streta 96 (free admittance)
UMBAU Nonstop Transformation
May 19 - November 26, 2023
Open Tuesday to Sunday, 10 am - 6 pm (closed on Mondays)
Salone Verde

Santa Croce, Calle della Regina 2258 (free admittance)
Passeggiata di Scardanelli in Carso (Scardanelli’s Walk in Karst)
July 1 - August 13, 2023
Open Monday to Friday, 10 am - 6 pm (closed on weekends)
SPARC* - Spazio Arte Contemporanea
San Marco, Campo Santo Stefano 2828A (free admittance)

www.veniceartfactory.org
info@veniceartfactory.org
@veniceartfactory
La Stagione musicale 2023-2024 del Palazzetto Bru
«Sarà una stagione con numerosi debutti, titoli rari e da tempo assenti dal cartellone veneziano, e grandi caposaldi del repertorio. Infine enfatizzeremo le ricorrenze di musicisti, artisti e delle figure simbolo della nostra cultura musicale e non solo».
Queste le parole del Sovrintendente e direttore artistico Fortunato Ortombina nel presentare la Stagione Lirica e Balletto e la Stagione Sinfonica 2023-2024 della Fondazione Teatro La Fenice. «Investiremo moltissime energie nell’attenzione ai giovani, confermando gli appuntamenti dedicati agli under 35, soprattutto nell’ambito della programmazione sinfonica».


La Stagione Lirica e Balletto prende il via il 24 novembre con Les Contes d’Hoffmann di Jacques Offenbach, in una coproduzione internazionale con la regia di Damiano Michieletto e la direzione musicale di Antonello Manacorda. Sul versante barocco, sarà proposto Il Tamerlano di Antonio Vivaldi, affidato a due specialisti del repertorio quali il direttore Diego Fasolis e il regista Fabio Ceresa. Per celebrare gli anniversari di Luigi Nono e Arnold Schönberg saranno proposte in un’unica serata rispettivamente La fabbrica illuminata ed Erwartung, in un allestimento con la regia di Daniele Abbado e la direzione di Jérémie Rhorer.
L’apertura della Stagione Sinfonica è invece affidata a Robert Treviño: nel solco di una lunga linea progettuale ormai di molte stagioni legata a Gustav Mahler, il maestro americano dirigerà la Terza Sinfonia del compositore austriaco. Si rinnoveranno inoltre anche in questa nuova Stagione, il Concerto di Natale nella Basilica di San Marco e nel Duomo di Mestre, con Marco Gemmani e la Cappella Marciana; il Concerto di Capodanno con la direzione musicale di Fabio Luisi e il concerto sinfonico in Piazza San Marco, in piena estate. Si consolida infine la collaborazione con il Patriarcato di Venezia con la seconda edizione della rassegna di musica sacra La Fenice nella Chiesa di San Fantin, tra aprile e maggio 2024.
È infine in programma una prestigiosa tournée : Madama Butterfly di Giacomo Puccini, una delle produzioni più applaudite degli ultimi anni, sarà in scena al Festival Ljubljana a luglio 2024 nella suggestiva mise-en-scène prodotta dalla Fenice nel 2013 con la regia di Àlex Rigola ripresa da Cecilia Ligorio, le scene e i costumi dell’artista giapponese Mariko Mori, che fu progetto speciale della cinquantacinquesima Esposizione Internazionale d’Arte della Biennale di Venezia. L’Orchestra e il Coro del Teatro La Fenice in trasferta saranno guidati da Daniele Callegari, alla testa di un cast composto per i ruoli principali da Monica Zanettin, Manuela Custer e Vincenzo Costanzo.
Dal 24 novembre Teatro La Fenice, Teatro Malibran www.teatrolafenice.it
Zane è ricca di viaggi e di celebrazioni: dai due festival veneziani di autunno e primavera ai numerosi incontri internazionali, tutte le opere in calendario suggeriranno un viaggio intorno al mondo con i loro libretti e con i luoghi delle loro ispirazione musicale. E poi alcuni importanti anniversari da commemorare: il bicentenario della nascita di Édouard Lalo (1823) e il centenario delle morti di Gabriel Fauré e Théodore Dubois (1924). Con il festival Mondi riflessi in programma a Venezia dal 23 settembre al 27 ottobre, il Palazzetto Bru Zane mette in evidenza l’ispirazione straniera nella musica francese del XIX secolo. Accompagnate dal pianoforte di François Dumont, Jodie Devos ed Éléonore Pancrazi ci faranno viaggiare con un florilegio di arie d’opera e di duetti dalla Spagna e dal Portogallo – terre di partenza per esplorare il mondo – fino all’India e al Giappone durante il concerto d’inaugurazione il 23 settembre. In primavera, le porte del Palazzetto Bru Zane di Venezia si spalancheranno per accogliere Gabriel Fauré e i suoi allievi nell’ambito del festival Il filo di Fauré dal 23 marzo al 23 maggio 2024. Le mélodies e la musica da camera dell’autore del Requiem, pur godendo oggi di meritata fama, acquistano ulteriore risalto se ascoltate accanto a pagine più intime firmate dai suoi discepoli. Colui che la generazione di Ravel scelse come vero e proprio patrono di una nuova modernità ritrova così la sua giusta collocazione. In Québec, per il ciclo Palazzetto Bru Zane Canada, le celebrazioni dedicate a Fauré comprenderanno Dubois, suo predecessore alla testa del Conservatorio di Parigi. Le compositrici, già al centro di un ciclo tematico nella scorsa Stagione, non verranno tralasciate: nel corso dell’11° festival Palazzetto Bru Zane a Parigi del giugno del 2024 saranno in cartellone i Contes fantastiques di Juliette Dillon, nonché le opere per violoncello e pianoforte di Henriette Renié, delle sorelle Boulanger e di Mel Bonis. Produzioni già acclamate – La Vie parisienne, Ô mon bel inconnu, Le 66! – proseguiranno la loro tournée internazionale, mentre Flannan Obé e i suoi allegri compari ci inviteranno a scoprire il mondo fantasioso del café-concert nell’ambito del Carnevale di Venezia. Infine, Le Roi d’Ys di Lalo sarà rappresentato a Budapest e ad Amsterdam, a ricordarci che questo compositore – già celebrato nel 2015 – appartiene a buon diritto all’élite del repertorio promosso dal Centre de musique romantique française. Un programma come un lungo viaggio musicale dunque ma, rigorosamente, all’insegna della musica romantica francese.
Il palco e la città

Carl Gustav Jung
Centinaia di studentesse, studenti, allievi attori e attrici, maestranze e ogni genere di professionista legato alle arti performative dal 2013 hanno calcato il palco di Campazzo San Sebastiano, dando vita ad uno degli eventi più seguiti dell’estate veneziana, il Venice Open Stage – Rising theatre festival giunto quest’anno all’undicesima edizione.
Millepiani – Invasioni randomiche teatrali è il titolo scelto per raccontare il pluridecennale impegno di Cantieri Teatrali Veneziani, associazione ideatrice e curatrice di VOS, nel diffondere le arti performative e creare connessioni con accademie internazionali, compagnie teatrali, musicisti e artisti, in un sistema aperto dove tutti gli elementi si relazionano e si supportano. Proprio come i rizomi delle piante, si legge nella presentazione, «Venice Open Stage è una struttura decentralizzata che si estende in diverse direzioni e attraverso la quale molteplici realtà culturali hanno l’opportunità di relazionarsi, una forma di organizzazione che rispecchia l’immagine della vita stessa, in cui non esiste una gerarchia predefinita, ma solo l’invasione dello spazio attraverso connessioni randomiche». Queste connessioni rappresentano l’arena del VOS, chi ci lavora in tutti i settori, il pubblico, i legami sviluppati e consolidati e quelli che saranno creati in futuro. Come da tradizione, è una speciale serata di musica ad aprire i festeggiamenti in Campazzo, domenica 2 luglio, con dj set aperitivo curato da Dj Outback, per poi proseguire con due eccellenze emergenti del territorio: in apertura Trust the Mask, e a seguire i Queen of Saba.
E, a proposito di connessioni randomiche, inaugura il Festival nell’arena dedicata al padre, il regista, professore IUAV e fondatore di VOS, Gigi Dall’Aglio, scomparso nel 2020, Emanuela Dall’Aglio, già premio UBU nel 2021 per i costumi dello spettacolo Naturae di Armando Punzo, che abbiamo avuto il piacere di intervistare in occasione della scorsa Biennale Teatro. Rumori Nascosti, ideato, diretto e interpretato da Emanuela Dall’Aglio, è ispirato alla fiaba Lupi nei muri di Neil Gaiman e racconta la storia della piccola Lucia, un’avventura tra le mura domestiche, dove le paure prendono la forma di lupi, animali archetipo, che diventano reali e distruttivi, ma che per un gioco di reciprocità, dopo essere stati così temuti all’inizio vengono spaventati e sconfitti grazie a meccanismi comuni che generano uguali paure, i rumori nascosti per l’appunto.
VOS prosegue martedì 4 e mercoledì 5 luglio con una delle accademie internazionali più aficionadas alla rassegna veneziana, ovvero la Faculty of fine Arts / School of drama della Aristotle University di Salonicco, con lo spettacolo Greek Summer (is a state of mind). La sezione FERMENTI, dedicata ai giovani protagonisti, si apre invece il 6 luglio con I PORCI – Una gastronomia machista della compagnia R.E.M.S. (Resources for Expressive Mindfulness Society) e prosegue con Vedere te (1322) di Noemi Piva il 7 luglio, per chiudersi poi con senza titolo (mâcher ses mots) di Elena Bastogi sabato 8. Domenica 9, un altro gradito ritorno: quello della Civica Accademia di Arte Drammatica “Nico Pepe” di Udine con il canovaccio originale di commedia dell’arte Il nuovo ordine… tutto cambia niente cambia. ArtEZ – Master in Theatre Practices di Amsterdam partecipa al VOS con Creature Chronicles della performer Vicky Maier (10 luglio) che, basandosi su una ricerca sulla narrazione comica come forma di espressione capace di evocare la risata, illuminare le questioni sociali e unire le persone, si propone con questo spettacolo di esplorare l’etica della commedia. Il gruppo toscacarusa presenta il 12 luglio la propria opera prima, Tu eri turbolenta scritta, diretta e interpretata da Tolja Djokovic, con Aura Ghezzi e Martina Tinnirello, mentre giovedì 13 va in scena la Aleksander Zelwerowicz National Academy of Dramatic Art di Varsavia con l’originale performance Men’s Talk che vuole rispondere al fenomeno del “mansplaining”.
Chiude l’edizione 2023 di VOS il 14 luglio, Farmacia Zooè con la messinscena di R.R., spettacolo ispirato alla storia di Rolandina Roncaglia, nata maschio (Rolandino, con la O) in provincia di Padova nel 1327, e trasferitasi a 19 anni a Venezia per vivere come femmina.
L’arena vi attende all’imbrunire, dalle 20 per Rizomi – Sound connections, aperitivo pre-spettacolo con la collaborazione di Opificio… appuntamento in Campazzo!
Uundreds of students and performance art professionals have been working at Campazzo San Sebastiano since 2013 in one of the most popular events of Venetian summers: Venice Open Stage – Rising theatre festival. “Venice Open Stage is a decentralized structure that extends in multiple directions. Cultural operators will be able to network and organize in a way that is the image of life itself: no pre-defined hierarchy, only an invasion of space building on random connections.”
The festival will open with a musical night on Sunday, July 2: a DJ-set curated by DJ Outback, plus performances by Trust the Mask and Queen of Saba. The first theatre event will be Rumori Nascosti (lit. ‘hidden noise’), the story of Lucia and an adventure unfolding within the home: fears take the shape of wolves, archetypical animals, real and destructive, but in the end defeated thanks to the reciprocating mechanism of hidden noise.
On July 4 and 5, the Drama School of the University of Salonica, Greece, present Greek Summer (is a state of mind). The youth section, FERMENTI, presents I PORCI – Una gastronomia machista by R.E.M.S., Vedere te (1322) and untitles (mâcher ses mots). On Sunday 9, an elaboration on commedia dell’arte historical Italian comedy: Il nuovo ordine… tutto cambia niente cambi, while Amsterdam-based company ArtEZ will participate with Creature Chronicles on July 10, a show on the ethics of comedy.
Company Toscacarusa will present their debut piece on July 12: Tu eri turbolenta, while on Thursday 13 the Warsaw-based Aleksander Zelwerovicz National Academy of Dramatic Art will stage Men’s Talk, a piece about mansplaining. Rounding up the programme on July 14 is company Farmacia Zooè presenting R.R., a show inspired by the story of Rolandina Roncaglia, born Rolandino and assigned male at birth in the year 1327 (yes, that’s thirteen twenty-seven), at age nineteen she moved to Venice and lived her life as a woman.


Fino a settembre il parco di Villa Groggia ospita gli spettacoli della rassegna teatrale Verde Groggia, organizzata da La Piccionaia in collaborazione con il Settore Cultura del Comune di Venezia. Le rappresentazioni teatrali serali a ingresso gratuito si svolgono in armonia con la piacevole cornice del Parco e non sono solo momento di svago, ma anche di approfondimento. Gli spettacoli offrono uno spunto di riflessione sul rapporto con noi stessi e con la società, dando voce a personaggi che solitamente non vengono ascoltati, chiedendoci chi siamo al di fuori del nostro lavoro e ragionando sul rapporto tra finzione e realtà in un mondo bombardato dalle informazioni. Tra luglio e agosto due appuntamenti in programma.
Giovedì 6 luglio, la compagnia Gli omini porta in scena Trucioli : due attori sul palco e tantissime voci provenienti da altrettanti luoghi diversi. Le voci di persone comuni, della gente reale, ascoltate nei bar, nelle piazze, nelle strade, che riportano l’immagine della società e dei nostri tempi.
Spettacolo finalista al Forever Young 2022, prodotto da La Corte Ospitale Solo quando lavoro sono felice di Niccolò Fettarappa e Lorenzo Maragoni va in scena giovedì 31 agosto, interrogandosi sull’annosa questione “quanto ci definisce il lavoro?”. Una riflessione sul rapporto tra noi stessi e il lavoro, sul valore che diamo al nostro tempo e ai soldi, per arrivare infine alla consapevolezza di uno stato di continuo autosfruttamento a cui ci sottoponiamo pretendendo di essere sempre “operativi”. Lucrezia Sillo

In scena in prima assoluta, dal 13 luglio al 6 agosto, presentato dal Teatro Stabile del Veneto nella suggestiva sala della Torre di Porta Nuova all’Arsenale, che con la sua scala in legno ottocentesca costituisce l’ambientazione perfetta, Alonso è un’esperienza immersiva a 360 gradi e al tempo stesso un’avventura teatrale da vivere lasciandosi guidare dall’attore premio Ubu Andrea Cosentino.
Progetto ideato da Fucina Culturale Machiavelli, scritto e diretto da Sara Meneghetti, Alonso reinterpreta in chiave contemporanea gli archetipi del Don Chisciotte di Cervantes, in uno spettacolo ibrido tra cinema e teatro, suddiviso in tre episodi visibili tramite visore per la realtà virtuale.
«Don Chisciotte è chi guarda la realtà e vede altro rispetto a quello che c’è, e notoriamente viene additato come pazzo. A me non interessava esplorare il tema della follia – racconta l’autrice nel dietro le quinte –, nel domandarmi chi potesse essere Don Chisciotte oggi ho pensato che mi interessava l’ingenuità di chi si sente libero di immaginare una realtà diversa, un futuro diverso per sé, ed è quell’ingenuità che hanno solo i ragazzi intorno ai vent’anni nel momento in cui finiscono un percorso di studi e si affacciano a quello che sarà il loro avvenire».
Ed è così che Alonso – il protagonista condivide con Don Chisciotte il nome di battesimo… e non solo – diventa un ragazzo veronese di diciotto anni, che sogna di fare l’illustratore e trascorre i lunghissimi giorni di lockdown sprofondato nel divano del soggiorno, perso nella sua immaginazione tra sogni e illusioni.

A dispetto delle restrizioni dettate dalla pandemia, l’esuberante Nina, compagna di classe, irrompe in casa sua alla ricerca di una connessione internet, proprio nel momento in cui Alonso riceve una telefonata cruciale dalla casa di riposo dove la nonna è ricoverata. Il ragazzo deve raggiungerla in tempo se vuole svelare il mistero del taccuino in cui sua madre stava riscrivendo la storia del Don Chisciotte e avere le risposte che cerca su sé stesso. Spronato dalla fidata Nina, tra l’investitura a cavaliere di un improbabile vicino, un tragicomico duello con un rider e l’accompagnamento di un inaffidabile ‘destriero’ a due ruote, Alonso si ritroverà a vivere l’avventura cavalleresca che non aveva mai osato sognare.
Al termine dello spettacolo il pubblico è invitato a partecipare ad un aperitivo e a visitare la terrazza della Torre, un’occasione esclusiva per godersi il tramonto sulla laguna da un’inusuale e affascinante prospettiva.
A lonso. Don Chisciotte tra realtà e virtuale 13 luglio-6 agosto Torre di Porta Nuova, Arsenale www.teatrostabileveneto.it
Perdono, chiedo perdono. Ma non mi può non venire in mente l’episodio Le vacanze intelligenti di Alberto Sordi del 1978, laddove una verace coppia romana di fruttivendoli deve affrontare, costretti dai figli che li vogliono acculturare, il concerto di John Cage 4’33’’. Proprio ieri ho assistito allo spettacolo La Plaza della compagnia El Conde de Torrefiel alla Biennale Teatro ed ora mi trovo a scorrere il programma di Scene di Paglia – Festival dei casoni e delle acque Obiettivi diversi, pubblico diverso. Qui è essenziale anche «il dialogo che si instaura tra le proposte artistiche e i luoghi del festival. Casoni di campagna e di laguna, barchesse, parchi, idrovore, case coloniche, scuderie, parchi storici, piazze e angoli urbani». Scene di Paglia quest’anno ha scelto il titolo Rotte Contrarie ed è fortemente radicato sul territorio tra terra e laguna: Piove di Sacco, Arzergrande, Codevigo, Brugine, Legnaro, Mirano e Sant’Angelo. Intendiamoci, anche a Piove esiste un teatro “all’italiana”, il Filarmonico, costruito alla fine del 1800, ma trovare ed andare ad occupare spazi liberi e aperti induce e consente agli artisti una vicinanza non usuale con il pubblico. Pensiamo a Real Heroes della Compagnia Oscenica (3, 4 luglio), dove gli spettatori sono guidati per le vie del centro storico a vivere un’esperienza sia fisica che virtuale e immersiva grazie all’utilizzo di visori 3D mentre viene narrata la storia di due padri costretti a separarsi dai figli, oppure a Le villeggiature di Farmacia Zooè, in scena al Casone Ramei (4 luglio), che ci costringe ad uscire dall’agio della nostra quotidianità per entrare nel mondo della malattia mentale. Il Festival quest’anno è affiancato da Acta, associazione nata dal progetto SguardiItineranti, e realizzato in collaborazione con Università di Padova e Il Piccolo di Milano. Ci racconta una delle fondatrici Ottavia Cappellazzo: «Acta è una Associazione di promozione sociale con l’obiettivo di divulgare la cultura teatrale. Acta deriva dal termine latino che significa “azione”, ma è anche un acronimo: Associazione Culturale Teatro ed Azione. Azione, cioè voglia di raccontare l’essenza del teatro. L’affinità con Scene di Paglia è alta, un desiderio di ritorno all’oralità e alla dimensione dell’essere insieme, del qui ed ora. Portiamo con il nostro fedele pullman appassionati e studenti nei luoghi del Festival. Il 9 luglio, ad esempio, parteciperemo a Mbira, in scena musica e balli africani; ogni serata di questo spettacolo è diversa proprio per il ruolo del pubblico, che ballerà e canterà confondendosi con cantanti, ballerini e attori». Bello sentire l’entusiasmo di questa giovane, laureatasi da pochissimo, che sogna il suo prossimo tirocinio proprio al Piccolo e a una sua futura, possibile carriera di direttore artistico in un teatro. D’altronde si è guadagnata il soprannome “Octopus” sin dalle elementari proprio per le sue frenetiche attività verso gli altri.
Andiamo dunque ad esplorare Mbira in scena domenica 9 luglio ai Casoni della Fogolana di Codevigo. Lo facciamo con l’aiuto di Roberto Castello, coreografo dello spettacolo.

Roberto è una delle voci storiche della danza contemporanea in Italia. A Torino era indeciso da ragazzino se seguire la pallavolo o la
danza, ma presto lo troviamo nella Compagnia Carolyn Carlson a Venezia come danzatore prima, poi con le prime coreografie. È tra i fondatori della Compagnia Sosta Palmizi e nel 1993 crea Aldes. I suoi spettacoli non sono necessariamente di pura danza; tende infatti a vedere la danza quasi come una categoria merceologica, parla di teatro a 360 gradi come strumento per far riflettere e riflettere. Ma la danza ha un vantaggio: «è portatrice di una visione del mondo meno focalizzata sullo scritto, permette più facilmente di riprendere e intrecciarsi con la tradizione orale dell’antichità e di altri popoli». Roberto divenne noto al pubblico italiano nel 2010, quando Fabio Fazio e Roberto Saviano gli affidarono l’incarico di coreografare un balletto attoriale ad episodi che desse il tema a ogni puntata di Vieni via con me. Fu anche al fianco di Peter Greenaway nell’allestimento della mostra The Towers a Lucca. A Scene di Paglia presenta ora questo Mbira, che designa uno strumento musicale tipico dei griot, cantastorie dell’Africa subsahariana, costituito da una tastiera, in metallo o legno, e un risuonatore. Nelle comunità Shona riprese nello spettacolo il suono della mbira è associato ai riti di contatto con gli antenati, un codice di identità e trasmissione culturale. «Obiettivo del lavoro portato in scena è quello di smontare le idee preconcette sugli altri, con particolare focus sull’Africa, culla di tutte le nostre civiltà, ma di cui sappiamo pochissimo. Tutte le nostre ipocrisie si rivelano. Cosa sappiamo dei nigeriani in Italia? Sappiamo forse che la grande maggioranza viene dal martoriato Biafra? Che sono quei bambini con le pance gonfie per denutrizione e per vermi intestinali che da
decenni eravamo abituati a vedere nelle pubblicità di raccolta fondi? Sappiamo che sono in prevalenza cattolici?». Cogliamo l’occasione per ricordare la collaborazione tra Aldes e la meritoria ultracentenaria rivista «Nigrizia» dei missionari comboniani. In Mbira ascolteremo Zam Moustapha Dembélé, cantante e compositore, nonché creatore e artigiano di strumenti musicali. Ci faremo trasportare nelle atmosfere più magiche dell’Africa. «Lo spettacolo vuole ripristinare un senso di festa in tutti coloro che parteciperanno», conclude Roberto Castello.
E l’organizzatore del Festival, il direttore artistico, colui che spende il suo tempo a selezionare meticolosamente i migliori spettacoli da portare in questo angolo di terra e laguna? È Fernando Marchiori, appassionato intellettuale, professore all’Università di Padova di Multimedialità nelle arti performative, scrittore prolifico quanto volutamente riservato. Gli chiediamo il perché del titolo scelto quest’anno per il Festival, ossia Rotte Contrarie : «Solo ciò che sappiamo incontrare apre la sua anima, ci parla e, raccontando di sé, racconta qualcosa anche di noi. Ma bisogna invertire la rotta, capovolgere lo sguardo, andare incontro. Che si tratti dei volti di un continente immenso e sconosciuto come l’Africa o di un sentimento senza nome nascosto dentro di noi, guardare da un’altra prospettiva sposta il nostro orizzonte, ci pone in ascolto, ci scopre. Tutto ci riguarda, ci chiama in causa. E nella vita in scena può capitare di scorgere, come in una notte alzando gli occhi alle stelle, ciò che anche noi stiamo mettendo sulla scena della vita». Loris Casadei

Ed eccoci qui, al consueto appuntamento con l’Estate Teatrale Veronese. L’edizione di quest’anno, già dalla scelta dell’immagine, è dedicata alla fioritura – ecco quindi letteralmente sbocciare le diverse linee curatoriali, tra le quali spicca per longevità quella del Festival Shakespeariano, la più longeva manifestazione italiana dedicata a William Shakespeare, 75 anni fa punto di partenza di quella che poi è diventata l’attuale Estate Teatrale Veronese
Il 13 e 14 luglio va in scena Le allegri comari di Windsor, una delle più celebri commedie di William Shakespeare in cui l’autore inserisce il meglio del proprio repertorio: l’amore contrastato tra giovani, equivoci, scambi, travestimenti e beffe. Quella in scena al Teatro Romano è un’ironica versione curata da Angela Demattè in cui Andrea Chiodi conferma il suo talento registico, creando un mondo in tartan à la McQueen – sovradimensionato, astratto, mentale – abitato da un cast di talento, arricchito dall’iconica Eva Robin’s nel ruolo di Miss Quickly.

Il 20 e 21 luglio in Aspettando Re Lear, rielaborazione della tragedia shakespeariana che indaga il complesso rapporto tra generazioni ad opera di Tommaso Mattei con Alessandro Preziosi, che firma anche la regia, i cinque personaggi in scena, proprio come i protagonisti del beckettiano Godot, sembrano ereditare e abitare il vuoto che rimane dopo che la tragedia ha fatto il suo corso. Lo spettacolo concentra la tensione drammaturgica nel momento chiave della tempesta che colpisce il re mentre vaga nella landa desolata, culmine del caos a cui alla fine Lear – incarnazione del patriarca, del monarca e della gloria ormai perduta dell’Europa di oggi – deve arrendersi. Ispirata all’opera del Bardo è anche una parte della sezione danza, con i preludi di Chopin, perfetta celebrazione dell’amore romantico, interpretati da Anbeta Toromani e Alessandro Macario in Preludes for Juliet (25 e 26 luglio), mentre l’8 e il 9 agosto l’appuntamento è con la riscrittura coreografata da Fabrizio Monteverde di Giulietta e Romeo, l’opera di danza italiana più acclamata di sempre che sposta la scena nell’Italia contraddittoria del secondo dopoguerra e rivive oggi per festeggiare i suoi 20 anni con il Balletto di Roma. Una segnalazione a parte merita il Verona Shakespeare Fringe Festival (24-31 agosto): al Camploy spazio al teatro internazionale per una settimana di spettacoli in lingua originale (con sottotitoli) o in inglese dalla Norvegia alla Serbia, dall’Ucraina alla Georgia, dal Regno Unito alla Grecia, fino al Bangladesh.
Livia Sartori di Borgoricco
Da bassanese quarantenne, posso affermare di aver percepito la presenza di Operaestate attraverso i ricordi di una vita, proprio grazie al carattere diffuso e multidisciplinare della manifestazione.
Una rassegna che nel corso della propria storia ha tracciato confini solo con lo scopo specifico di puntualmente superarli per tracciarne di nuovi, oltrepassando limiti, portando ogni forma di spettacolo in un posto insolito e scoprendolo poi adatto, capace addirittura di esaltarne la potenza comunicativa.
La sua 43. edizione non fa eccezione, continua sulla strada tracciata fin dall’inizio e portata avanti grazie all’impegno programmatico e pragmatico, aprendo varchi che poi sarebbero stati imboccati da altre realtà culturali, facendo scuola: ecco allora dal 5 luglio al 26 settembre, oltre 100 spettacoli nei teatri e immersi nel paesaggio, in parchi, giardini e luoghi d’arte della Pedemontana Veneta, rinnovando l’invito rivolto a pubblici, comunità, visitatori, a entrare in contatto con i diversi linguaggi della scena, con le molteplici creazioni di artisti e compagnie italiani e internazionali, proseguendo anche nell’impegno verso un festival sempre più accessibile e sostenibile. Linguaggio artistico di punta di Operaestate che da anni ha reso Bassano centro di eccellenza internazionale è di sicuro la danza, sul palcoscenico principale del festival si alternano infatti grandi nomi del panorama internazionale, tra debutti e creazioni dal repertorio che ha consolidato i rispettivi linguaggi artistici. È il caso di Larsen C della Compagnia greca di Christos Papadopoulos (25/7), in cui i movimenti ripetuti portano alla trasformazione del corpo, in un invito alla meditazione, all’apertura verso immagini e memorie in continuo divenire, per una danza poetica e ipnotica al tempo stesso. Portano a Bassano l’eccellenza del balletto contemporaneo gli artisti dell’Hamburger Kammerballet (8/8), nuova compagine supportata dall’Hamburg Ballet di John Neumeier e fondata da Edvin Revazov per i colleghi ucraini in fuga dal conflitto. Una compagnia di eccellenze, che presenta in prima nazionale le coreografie di Revazov: Kleines Requiem für eine Polka, un commento all’assurdità della guerra, e The Britten Dance, nuova creazione su musica di Benjamin Britten. Il 21 luglio ecco Flavia Mastrella e Antonio Rezza, due artisti unici «per
folle e lucida genialità», dalla motivazione del Leone d’Oro alla Carriera che la Biennale di Venezia gli ha riconosciuto nel 2018, impegnati in una nuova dirompente creazione che si interroga e ci interroga, con la consueta energia, sull’antico rapporto tra natura e cultura. Parole e musica, affiancate sul palco come nella sensibilità degli artisti, sono protagoniste di Acqua rotta (11/8) con Mario Brunello, uno dei più completi e ricercati musicisti della sua generazione e Mariangela Gualtieri, poetessa, drammaturga e attrice, che si incontrano grazie al comune interesse per i temi dell’ambiente mettendo al centro l’elemento irrinunciabile alla vita sul nostro Pianeta. Operaestate è sinonimo anche di grandi concerti, lontani dagli scenari di folle oceaniche adoranti la star di turno, ma chicche acustiche dalla dimensione raccolta e intima, come testimonia l’esibizione del batterista e compositore statunitense Makaya McCraven, ospite del Teatro Gobbi il 23 luglio con il suo In These Times, lavoro che rifugge con veemenza all’etichetta di genere “jazz” identificandosi semplicemente con altro, non necessariamente catalogabile purché frutto di visionarietà e apertura alle più disparate influenze. Altro innovatore nel panorama musicale contemporaneo è di sicuro Lubomyr Melnyk (17/7), compositore e pianista di origine ucraina che si contraddistingue per la sua tecnica di “musica continua”, una corrente di suono costante e senza interruzioni, in un flusso perpetuo e magico.
Il Cinefestival ospitato dai Giardini Parolini, da alcuni anni tornati all’antico splendore grazie a grossi lavori di riqualificazione, offre ogni sera un film diverso scelto tra le pellicole protagoniste della stagione cinematografica più recente, mentre il Minifest, rassegna teatrale di qualità dedicata ai più piccoli, sembra chiudere un cerchio: accompagnare i propri figli ad uno degli spettacoli in programma dal 16 luglio al 2 settembre a Bassano o a Mussolente, a Rosà come a Cassola o Nove farà di sicuro un certo effetto. Un bellissimo, sorprendente effetto. Davide Carbone
Tra i diversi percorsi che il programma di Operaestate offre, BMotion è il più marcatamente orientato agli artisti emergenti e alla contemporaneità nelle diverse declinazioni delle arti performative. Negli ultimi anni è stata senza dubbio la Danza a crescere maggiormente all’interno del palinsesto, grazie ad un lavoro continuo di progettazione europea che ha saputo collocare Bassano tra i centri più vivaci della scena continentale.

Dal 17 al 20 agosto saranno molte anche quest’anno le realtà artistiche per la prima volta in Italia: Lara Barsacq dal Belgio, recentemente presente anche al Kunstenfestivaldesarts, Ioanna Paraskevopoulou, forse la più completa tra le personalità artistiche emerse dalla vivace scena greca e al suo debutto a Bassano come coreografa, o ancora Olga Dukhovnaya, ucraina basata in Francia che con il suo dirompente Swan Lake solo si interroga sull’uso politico che la propaganda russa continua a fare del celebre balletto di C ˇ ajkovskij.
Già note invece al pubblico italiano sono Leila Ka, di recente nel palinsesto di Set Up e Romaeuropa, Ayelin Parolin, coreografa italo/ argentino/belga già nel programma del Festival dei Due Mondi di Spoleto, e Mia Habib, che firmerà una creazione per i Dancers del progetto Dance Well nato nel 2013 e dedicato a persone affette da morbo di Parkinson ma non solo. Vero fiore all’occhiello dell’attività di Operaestate e del Comune di Bassano del Grappa, Dance Well propone una pratica condivisa con chiunque vorrà partecipare a delle classi aperte del mattino che precederanno degli incontri con alcuni degli artisti del Festival curati da Ariadne Mikou. Non meno importante la presenza italiana, che vedrà la partecipazione del Collettivo Cinetico impegnato con due lavori: Manifesto Cannibale e Urutau, quest’ultimo in prima assoluta, della napoletana Luna Cenere, per la prima volta a Bassano con il suo radicale approccio al corpo nudo in scena, e dei giovanissimi Aurelio Di Virgilio e Parini Secondo. In chiusura di programma Salvo Lombardo con il suo Dance Floor Outdoor, che in Piazza Libertà proporrà una performance preludio di una vera e propria festa all’aperto. Dal 23 al 27 agosto la programmazione si concentrerà sul teatro seguendo diverse linee tematiche pronte ad incrociarsi. Due spettacoli saranno proposti anche ad un pubblico di ciechi, ipovedenti e sordi in collaborazione con Al.Di.Qua Artists: Between Me and P di Filippo Ceredi e La vaga grazia di Eva Geatti, presente anche a Venezia nella programmazione di Asteroide Amor dell’Università Ca’ Foscari. Un vero e proprio focus sulla drammaturgia tedesca curato da
Monica Marotta, con testi di Sasha Marianna Salzmann e Nino Haratischwili nelle traduzioni di Anna Benussi e Angelo Callipo, è quello affidato a tre attrici venete, Leda Kreider, Federica Rosellini e Matilde Vigna, in collaborazione con Marsilio edizioni e il Goethe Institut. Non mancheranno le prime nazionali con Sergi Casero, artista spagnolo prodotto da Centrale Fies ed emerso nell’ambito del progetto Live Works, Benno Steinegger, già conosciuto con Codice Ivan ma per la prima volta in Italia come autore con una produzione belga, e il debutto del nuovo lavoro di Leonardo Manzan, sicuramente il più eclettico tra i nostri nuovi registi. Completano il programma nomi già affermati della scena italiana come Licia Lanera, Menoventi, Piccola Compagnia della Magnolia e nuovi talenti come Gianmaria Borzillo, che con il suo primo lavoro ha ricevuto la menzione al College della Biennale Teatro e al Premio Leo De Berardinis.
Il 30 agosto la sezione musica sarà aperta da Dan Kinzelman, artista molto noto al pubblico di BMotion grazie alla sua lunga collaborazione e alla presenza assidua nei nostri cartelloni sia nelle vesti di solista, che in quelle di collaboratore di diversi altri artisti. Segue il 31 il concerto dei Razen, formazione basata in Belgio, a Bassano con una singolarissima proposta ispirata al misticismo medioevale con strumenti a corde a fiato. La serata del 1 settembre sarà consacrata a Oleh Shpudeiko, noto anche con lo pseudonimo di Heinali, compositore e artista musicale ucraino autore di opere in cui reimmagina la musica tradizionale attraverso sintetizzatori modulari. Chiude il programma di B.Motion Musica il 2 settembre il duo Dal:um da Seoul, che sfida le possibilità sonore dei più noti strumenti a corda tradizionali coreani come il gayageum e il geomungo. Etereo e ultraterreno, Dal:um crea un avvincente mondo sonoro che custodisce dinamiche sottili e lo spazio tra le note, in un dialogo tra pratiche tradizionali e sperimentali.
BMotion invita a Bassano del Grappa per delle giornate intense fino alla fine dell’estate, facendo parte di una comunità temporanea dove artisti e pubblico possano condividere non solo spazi, ma più estensivamente pratiche fisiche e momenti di riflessione intorno ai lavori e ai diversi linguaggi. Soprattutto BMotion offre la possibilità di attraversare una città che ha reso partecipazione e benessere chiavi di accesso alla vita comunitaria, resa porosa alle relazioni nelle sue svariate forme e leva delle trasformazioni sociali.
17
A Lubomyr Melnyk la tastiera sembra non bastare. Ideatore della “Musica Continua per pianoforte”, la sua scoperta ha aperto una nuova era sinfonica rendendolo uno dei più grandi pianisti al mondo, non solo per la straordinaria abilità esecutiva ma per la visionarietà legata a questo strumento, sempre capace di aprire nuovi scenari. Attraverso istanze legate a pianoforte classico, percussioni minimaliste, arti marziali e meditazione trascendentale Melnyk riesce a fare qualcosa di mai visto prima, anche grazie a come padroneggia virtuosismi per creare effetti totalmente nuovi. A metà degli anni ‘70 ha iniziato a lavorare su un’idea di pianoforte che combinasse la tecnica classica con le filosofie trascendentali del Tai-chi e del Kung-fu. Negli anni la padronanza dello strumento l’ha portato verso altre dimensioni, con abilità che gli permettono di suonare a velocità mai immaginate prima in performance personali e irripetibili che hanno sorpreso il pubblico di tutto il mondo.

17 luglio h. 21.20 | Chiostro del Museo Civico, Bassano del Grappa
«Come si possono riempire le cose vuote? È possibile che il vuoto sia solo un punto di vista? La porta… perché solo così ci si allontana. Ognuno perde l’orientamento, la certezza di essere in un luogo, perde il suo regno così in terra e non in cielo. L’uomo fa il verso alla belva. Che lui stesso rappresenta. Senza rancore. La porta ha perso la stanza e il suo significato, apre sul nulla e chiude sul nulla. Divide quello che non c’è… intorno un ambiente asettico fatto di bagliori. L’essere è prigioniero del corpo, fascinato dall’onnipotenza della sua immagine trasforma il suo aspetto per raggiungere la bellezza immobile e silente che tanto gli è cara». L’ultimo spettacolo di Antonio Rezza e Flavia Mastrella, Hybris, è ontologico-umoristico, delirante-realista, psicanalitico-lunare e lunatico. Rinchiuso in un rettangolo dai lati solo disegnati in terra e quindi sempre valicabili, suggerisce un ambiente frigorifero per la conservazione della specie, dotato di qualche confort per i periodi di lunga reclusione, aperto agli infiniti dell’abiezione e della risata, del paradosso e dell’accelerazione stratosferica e incontenibile, del tormentone e dello sguardo antropologico.
21 luglio h. 21.20 | Teatro al Castello “Tito Gobbi”, Bassano del Grappa
È Makaya McCraven ad indicare la nuova direzione della musica black, insieme ad un manipolo di altri musicisti uomini e donne (qualche nome: Moor Mother, Matana Roberts, Christian Scott aTunde Adjuah) interessati come lui alla creazione di una musica dove composizione ed improvvisazione si confondono, e il focus è la ricerca di un suono biologico e digitale nello stesso tempo. In These Times, il suo ultimo disco uscito nel 2022, rappresenta l’apice qualitativo di un approccio che negli anni si è sempre mantenuto costante e che potrebbe avvicinarsi ad un intervento di neurochirurgia: inserire nel corpo apollineo del jazz, nella sua vocazione per le strutture forti e definite e gli assolo vibranti, un neuro-trasmettitore che introduca gli elementi inafferrabili, cangianti e tecno-digitali dell’hip-hop. Nuove combinazioni, nuove sintesi, nuovi suoni: perché Makaya interviene sul suono anche in fase di produzione, esattamente come più di 50 anni fa Teo Macero con i solchi di In a Silent Way del sommo Miles. Il batterista, compositore, produttore nato a Parigi da un batterista jazz ed una flautista folk ungherese (ovvero, l’ibridazione già nella nascita) ci offre una musica aperta alle complesse tessiture ritmiche del suo drumming su cui si innestano le improvvisazioni cocenti del jazz e le manipolazioni dell’hip-hop, in un rutilante arazzo sonoro che nutre la mente ed appaga i sensi. F.D.S. 23 luglio h. 21 | Teatro al Castello “Tito Gobbi”, Bassano del Grappa


Elementi ambigui, gesti e movimenti con qualità liminali amplificano un’esperienza in costante cambiamento. Apparenza e inganno sono i cardini intorno ai quali si anima il nuovo lavoro del coreografo greco Christos Papadopoulos: un’instancabile esplorazione della ripetizione del movimento e della trasformazione degli stati del corpo capace di generare molteplici livelli di significato ed esperienze percettive indimenticabili. Larsen C è un invito alla meditazione, all’apertura verso associazioni, immagini e memorie in continuo divenire, mentre prosegue la ricerca di una qualità profonda e naturale, per raggiungere il punto in cui il movimento è perso e ritrovato, si dissolve ed emerge, è privo di significato e al tempo stesso significativo. Il corpo umano può diventare metafora di qualità astratte come il tempo e la vita, o suggerire fenomeni naturali come il flusso dell’acqua, l’erosione del terreno o la dissolvenza della luce al tramonto.
25 luglio h. 21. 20 | Teatro Remondini, Bassano del Grappa
L’installazione si basa sulla rappresentazione spettrale di tutti i nomi; una sequenza della totalità dei sostantivi del vocabolario italiano proiettati uno a uno. Rappresentano potenzialmente tutti gli oggetti della realtà dotati di un nome. Si tratta di comprimere lo sguardo sul punto critico di fusione, poco prima della perdita dell’aggancio percettivo, nello sfarfallamento che sfugge alla netta distinzione dei singoli termini. Il frenetico e liminale susseguirsi delle parole fa sì che alcune di esse rimangano impresse nella corteccia visiva di ciascun spettatore; altre – la maggioranza – andranno perse. Lo spettatore, esposto a questo trattamento, subisce la parola umana sotto l’aspetto della quantità. L’affastellarsi frenetico delle nominazioni non lascia nessuno spazio alla scelta o al discernimento. Il nucleo del linguaggio ritorna al rumore bianco, che riporta al caos. Ogni pausa è abolita, occupata. La pausa, cioè l’assenza delle parole, diventa il campo di battaglia per l’aggressione militare delle parole, e i nomi del vocabolario così proiettati, sono le bandiere piantate in una terra di conquista. Precede la proiezione un’azione simbolica della performer Gloria Dorliguzzo darà vita a un cerimoniale di “accensione” del linguaggio. Il suono che accompagna l’installazione, composto da Scott Gibbons, sarà apodittico. 28 luglio h. 19.30 | CSC San Bonaventura, Bassano del Grappa
Su iniziativa e visione di Edvin Revazov, primo ballerino dell’Hamburg Ballett e con il supporto di John Neumeier, direttore e coreografo della compagnia e in cooperazione con il Teatro Kampnagel di Amburgo, l’Hamburger Kammerballet è stato ideato con l’intento di offrire ad alcuni danzatori ucraini la possibilità di continuare a fare quello che più di ogni altra cosa amano, ovvero danzare. Il programma della serata di Where Have All the Flowers Gone è composto da due distinte creazioni presentate entrambe in prima nazionale. In apertura il brano che è diventato ormai raffigurativo per l’ensemble, Kleines Requiem für eine Polka, coreografia di Edvin Revazov, su musica di Henry Gorecki, che porta l’attenzione sulla crudele, insensata assurdità del conflitto tra Russia e Ucraina, che purtroppo un’attuale desolante fotografia del nostro mondo. La seconda coreografia, sempre firmata da Edvin Revazov, su musica di Benjamin Britten è di nuovissima creazione e porta il titolo provvisorio Britten-Dances. 8 agosto h. 21 | Teatro al Castello “Tito Gobbi”, Bassano del Grappa




Il concerto per violoncello e voce recitante con Mario Brunello e Mariangela Gualtieri è affiancato sul palcoscenico da quasi-zero, installazione di Gianandrea Gazzola così raccontata dall’artista: «Un cristallo d’acqua gelata, sospeso a mezz’aria tra due lunghe aste sottili. Nel dialogo tra poesia e musica, quasi-zero è un convitato di ghiaccio. Presenza immobile, se non fosse per la quieta pulsazione che anziché la vita, ne scandisce goccia a goccia, la misura che lo separa dal nulla». Il testo di Acqua Rotta è composto in gran parte da versi inediti, scritti per questa occasione da Mariangela Gualtieri, figura interessante e affascinante di poetessa, drammaturga, attrice. La partitura musicale spetta al violoncello di Mario Brunello, uno dei più completi e ricercati artisti della sua generazione, che per questo progetto unisce le perfette architetture sonore di Johann Sebastian Bach alla musica contemporanea di Sofia Gubajdulina, Peter Joshua Sculthorpe e del giovane Lamberto Curtoni
11 agosto h. 21 | Teatro al Castello “Tito Gobbi”, Bassano del Grappa

Non deve essere facile essere all’altezza di un mondo in cui tutto è sempre perfetto. Si potrebbe magari aprire un dibattito sul concetto di “perfezione”, in questo caso stiamo parlando di una realtà in cui tutto o quasi è rosa shocking, la politica semplicemente non è contemplata e tutto quello di cui ci si deve preoccupare è organizzare gli impegni mondani e districarsi tra una festa e l’altra, giornate spese in spiaggia ad abbronzarsi, a correre sui rollerblades o sfrecciando su decappottabili rosa, sfoggiando abiti firmati… indovinate un po’? Ovviamente rosa.
È il mondo di Barbie, la bambola più famosa al mondo che ha segnato la giovinezza al femminile degli ultimi settant’anni, commercializzata dalla Mattel dal marzo del 1959 per l’esattezza e che da quel momento non ha mai più abbandonato l’immaginario collettivo, diventando fenomeno di costume e restando rigorosamente al passo con i tempi grazie all’introduzione di accessori e versioni così vari da poter riempire un’enciclopedia, come testimoniano tra l’altro i numerosissimi collezionisti che in giro per il mondo si contano ancora oggi.
Inevitabile, quindi, che la seconda bionda più famosa al mondo dopo Marilyn diventasse protagonista di un film, ma non si poteva certo prevedere quanto il cast potesse essere di prim’ordine: Margot Robbie sarà Barbie, Ryan Gosling nei panni un po’ ingrati di Ken, alla regia Greta Gerwig, che con Lady Bird del 2017 otteneva un Golden Globe e due candidature al Premio Oscar per la miglior sceneggiatura e la miglior regia.
Al centro della trama una Barbie che, nel bel mezzo di una studiatissima coreografia durante una delle interminabili feste a bordo piscina, spiazza tutti chiedendo a gran voce: «Avete mai pensato di morire?», facendo irrompere dubbi esistenziali in un mondo patinato che mai ne aveva avuti e che soprattutto mai ne avrebbe voluti.
Da lì, la nostra bionda inizierà un viaggio alla ricerca di sé stessa, un bildungsroman fosforescente in cui la accompagnerà Ken, un Ryan Gosling vanesio a livelli incalcolabili che grazie alla propria bravura riesce ad essere nonostante tutto estremamente credibile. Un personaggio, ovviamente, che non ha mancato di suscitare critiche, in nome di una gender quality rovesciata che paradossalmente il film è riuscito a risvegliare: «È molto divertente per me ascoltare queste critiche – spiega Gosling – addirittura hanno creato il movimento #NotMyKen. Vi siete mai preoccupati di Ken prima di questo film? No, non l’avete fatto. Non l’avete mai fatto. Non vi è mai importato. Se vi importasse davvero di Ken, sapreste che a nessuno è mai importato di Ken. Quindi la vostra ipocrisia è stata smascherata. Per questo la sua storia va raccontata. Se le persone non vogliono giocare con il mio Ken, ci sono molti altri Ken con cui giocare. Esco in giardino dopo aver ricevuto l’offerta di girare questo film e sapete cosa mi capita sotto gli occhi? Proprio Ken, a faccia in giù nel fango, accanto a un limone schiacciato. Ho mandato un messaggio con la foto a Greta Gerwig e le ho detto: “Sarò il tuo Ken, perché questa storia deve essere raccontata”».
Nel già celebre trailer di Warner Bros. Italia (2,8 milioni di visualizzazioni in un mese) vediamo il roseo mondo della bambola capovolgersi quando i suoi ‘caratteri’ iniziano a non funzionare correttamente: prima scivola giù dal secondo piano della sua casa dei sogni anziché fluttuare magicamente nella propria macchina come ogni mattina; poi inizia a sentire l’acqua fredda mentre si fa la doccia, e i suoi piedi, abituati ai tacchi, diventano improvvisamente piatti. Una Barbie ‘canaglia’, interpretata da Kate McKinnon, offre persino al personaggio di Margot Robbie un audace paio di sabot Birkenstock Arizona da indossare al posto della scarpetta con i tacchi. «Cosa scegli tra il tuo mondo e il mondo reale (Birkenstock)?» le chiede. E Barbie risponde senza dubbio: «I tacchi».
Ma la voglia di scoprire come vivono i comuni mortali avrà la meglio. Da quel momento, nulla sarà mai più come prima.
It must not be easy to keep up with a world where everything is perfect. Now, ‘perfect’ does a lot of heavy lifting, here. In this reality, everything is hot pink, politics don’t exist, and all you need to think of is organizing your life around partying, sunbathing, rollerblading, cruising in your pink convertible, showing off your labels… this is the world of Barbie, the most famous doll in the world and the icon of girlhood for over seventy years. A pop culture phenomenon that stayed relevant always, thanks to regular updates in wardrobe and accessories, so many they could fill an encyclopaedia. It was only a matter of time before Barbie was promoted to movie star, though certainly one couldn’t expect such a stellar cast: Margot Robbie will star as Barbie, while the (thankless?) role of Ken went to Ryan Gosling. The film has been directed by Greta Gerwig, whose Lady Bird of 2017 earned her a Golden Globe and two Oscar nominations (Best Screenplay, Best Director).
The story sees Barbie peacefully lounging at a very, very choreographed, interminable pool party. At one point, she raises her voice and asks: “Do you guys ever think about dying?” giving way to existential drama in a world that never experienced any—nor would ever want to.
From there, our favourite blonde will embark on a journey to self-discovery accompanied by Ken, an immeasurably vain man whose character can only be saved by Ryan Gosling’s acting skill. His character drew criticism, too, in a sort of reversed gender equality controversy. In Gosling’s words: “It is funny, this kind of clutching-your-pearls idea of, like, #notmyken. Like you ever thought about Ken before this? No, you didn’t. You never did. You never cared. I care about this dude now. I’m like his representative.”
The very trailer of the film shows Barbie’s pink world turned upside down as characters themselves glitch: first, she tumbles down from her mansion’s upper floor, instead of the usual magical floating right into her car seat; then, her shower water turns unexpectedly cold; her feet, used to high heels, turn flat.
A ‘rogue’ Barbie, played by Kate McKinnon, ironically offers Margot Robbie’s character a pair of Birkenstocks. She is puzzled, but her curiosity to find out just about how common people live will have the best of her. From that moment, nothing will ever be the same.
All inclusive
Riparte (o sarebbe meglio dire, accelera…) in occasione dell’80. Mostra Internazionale d’Arte Cinematografica di Venezia la macchina organizzativa del Premio Inclusione e Sostenibilità Edipo Re, premio collaterale ufficiale di Biennale Cinema, promosso dalla Edipo Re Impresa Sociale di Sibylle Righetti e Enrico Vianello, sotto la direzione artistica di Silvia Jop, in collaborazione con MYmovies e con il patrocinio di Ca’ Foscari e ResInt. Sesta edizione del premio e giuria di massima qualità, con gli attori Caterina Guzzanti e Alberto Malanchino e la scrittrice Carlotta Vagnoli a farsi volti di una Mostra del Cinema con apertura d’autore, Challengers di Luca Guadagnino, appena annunciato come prima proiezione in Sala Grande il prossimo 30 agosto, con Zendaya, Josh O’Connor e Mike Faist protagonisti di una storia ambientata nel mondo del tennis.

Il Premio Inclusione e Sostenibilità viene conferito selezionando uno tra i 12 film provenienti dal Concorso Internazionale, Orizzonti, Settimana della Critica e Giornate degli Autori (con la sezione off Notti Veneziane in Sala Laguna), precisamente all’opera che saprà mostrare uno sguardo capace di incoraggiare pratiche inclusive e sostenibili. L’organizzazione sosterrà la pellicola vincitrice attivando un circuito speciale di sostegno alla sua distribuzione in Italia. Novità di quest’anno è la Giuria Giovani, composta da studenti e studentesse dell’Università Ca’ Foscari, che affiancherà il lavoro dei giurati rafforzando il rapporto tra cinema e università.
L’impresa sociale Edipo Re, promotrice del premio, nasce attorno alla storica barca a vela che ospitò Pier Paolo Pasolini e Maria Callas, oggi trasformata in un vero e proprio innovation lab che promuove attività artistiche e culturali fondate su turismo sostenibile, enogastronomia e riattivazione delle economie locali nella Laguna di Venezia. Attorno alla barca Edipo Re si svolgerà dal 30 agosto al 9 settembre la rassegna intitolata Radici, palinsesto di eventi che avranno come scenario la barca, il suo approdo (riva Corinto) e la Sala Laguna. Letteratura, musica, cinema, sociale, food: presentazioni, degustazioni, live show e proiezioni si alterneranno in un cartellone non stop che rappresenta ormai dal 2017 l’anima off e social green del Festival del Cinema.
Arriva sotto casa un furgone attrezzato con schermo, proiettore e 99 sedie, con l’invito a godersi un film all’aperto e in compagnia, riscoprendo il valore della comunità e del tempo speso insieme. Campo San Polo, il Lido di Venezia, Mestre e i centri della città metropolitana seguono la bussola di Cinemoving alla ricerca di qualità coniugata alla popolarità dei grandi successi, sia di pubblico che di critica, con pellicole che si sono suseguite nelle sale negli ultimi mesi e che adesso il pubblico ha la possibilità di rivedere all’aperto, una sera d’estate.
Anche quest’anno l’appuntamento con la rassegna si è aperto a giugno al Parco San Giuliano, con Uno sguardo sul futuro, in collaborazione con Enel: sei serate dedicate al cinema d’ambiente con storie reali o immaginarie, tutte dedicate a temi importanti come le risorse ambientali e l’equilibrio fondamentale e precario tra Uomo e Pianeta.

Il centro storico è invece lo scenario della rassegna in Campo San Polo, Uno sguardo sull’Europa : da martedì 1 a domenica 20 agosto salgono a venti le serate in campo dedicate al cinema europeo, con lungometraggi, cortometraggi, documentari e film di finzione provenienti da diverse nazioni europee a cui saranno dedicati approfondimenti e presentazioni, in stretta collaborazione con istituzioni internazionali come Alliance Française, Premio LUX, Cinema Svizzero a Venezia e Venice Film Week.
Torna, ancora più ricca, la seconda edizione della rassegna Uno sguardo all’orizzonte. In una splendida atmosfera balneare, per sei venerdì dal 14 luglio al 18 agosto, in riva al mare, film che osservano l’orizzonte del nostro vivere, storie che affrontano con delicatezza e forza le relazioni sociali e le questioni che rendono gli esseri umani comunità come L’isola dei cani di Wes Anderson o Belfast di Kenneth Branagh.
E poi, come un filo sottile e resistente, il cinema itinerante arriva nei quartieri: il programma di Cinemoving 2023 è ricco di titoli per tutti i gusti, dal cinema italiano (Tito e gli alieni di Paola Randi) alle commedie, ai film dedicati ai bambini e di azione, a disposizione nelle diverse location di tutto il territorio comunale: Mestre, Favaro, Dese, Malcontenta, Campalto, Chirignago, Zelarino, Gazzera, Tessera, Terraglio, per raggiungere anche Pellestrina e il Lido. Qui un paio di novità: ad agosto Cinemoving torna a Malamocco e per la prima volta una serata si svolgerà agli Alberoni.
Una manifestazione che nasce durante la pandemia, arrivando all’edizione 2023 in ottimo stato di salute, dimostra semplicemente di avere una marcia in più. Torna per il quarto anno consecutivo Cinema Barch-in, il primo drive-in in barca d’Italia, in programma domenica 30 e lunedì 31 luglio e da giovedì 3 a domenica 6 agosto come da tradizione negli spazi dell’Arsenale, grazie al supporto del Comune di Venezia, di Vela e della Marina Militare.
La programmazione curata anche quest’anno dall’Associazione culturale FEMS du cinéma prevede ben sei serate di cinema all’aperto con molti ospiti dal vivo, musica, comicità e presentatori. Film, documentari, animazione e cortometraggi nella varietà di stili e generi che da sempre contraddistingue la rassegna, attraverso un filo rosso, che quest’anno sarà Venezia: Isole e non luoghi, ripercorrendo le tracce de Le città invisibili di Italo Calvino, nel centenario della nascita: «Arrivando a ogni nuova città il viaggiatore ritrova un suo passato che non sapeva più d’avere: l’estraneità di ciò che non sei più o non possiedi più t’aspetta al varco nei luoghi estranei e non posseduti» scriveva l’intellettuale ligure, evocando sensazioni che la rassegna intende risvegliare e approfondire.
Si parte il 30 luglio con il corto Papageno di Lotte Reiniger (1935) (grazie alla collaborazione con la Fabbrica del Vedere-Archivio Carlo Montanaro) e Lo sguardo su Venezia presentato da Ottavia Piccolo e si chiude il 6 agosto con la serie Christian di Stefano Lodovichi (2022) direttamente dalla piattaforma SKY, passando per isole e città da salvare, pianeti e mondi misteriosi, frammenti di memoria sotto il sole di un’estate lontana nel tempo.
Tra le novità artistiche si segnala il ponte con il Festival CinemAmbiente di Torino, vero e proprio pioniere nel suo genere che proporrà al pubblico di Barch-in alcuni titoli delle sue edizioni, in collaborazione con l’Università Ca’ Foscari di Venezia. Per la prima volta sul grande schermo a Venezia sarà proiettato After Sun, candidato all’Oscar 2023, grazie al supporto di MUBI.
Chicca finale: il 31 luglio e il 3 agosto Edipo Re propone un viaggio esperienziale a bordo della barca a vela che ospitò Pier Paolo Pasolini e Maria Callas con approdo finale al Cinema Barch-in e cena a bordo.
C inema Barch-in 2023
3 0, 31 luglio; 3-6 agosto Arsenale cinemabarchin.com

Posso permettermi di parlare di una regista ucraina? Giuro, non per seguire la moda. È una brava filmmaker, sceneggiatrice, scrittrice e poeta. Rivendico il diritto dell’arte di essere al di sopra di ogni parte politica. Parlo di Marysia Nikitiuk, che l’Università di Padova ha celebrato in una giornata a lei dedicata a fine maggio.
Avevo visto il suo primo film al Trieste Film Festival a gennaio e When the Trees Fall mi aveva entusiasmato. Il plot, la tecnica, la sceneggiatura, la stupenda fotografia di Michal Englert, tutto concorre a farne un film da vedere e rivedere. Mi piacerebbe usare il termine “realismo magico”, ma è troppo abusato. Eppure il giardino favolistico con i pomodori giganti ricorda Alice nel Paese delle meraviglie, le scene con l’acqua la pittura preraffaelita, il bianco cavallo nella radura piena di vapori ha infiniti rimandi letterari, non ultimo la fuga di Angelica dell’Ariosto. E la bravissima protagonista sogna proclamando il proprio amore: «Portami via, camminerò nuda, riderò sempre, mangeremo fichi...».

Un sogno appunto, la storia andrà in altra direzione. In un villaggio di campagna o nelle krusciovke di città la repressione è sempre la stessa, il controllo sociale aiutato dal conformismo politico uccide i sogni. Marysia, che ha vissuto parte dell’adolescenza in Italia racconta come al rientro in patria, ancora teen ager, pensasse al suicidio ogni giorno, nella Kiev industriale senza architettura, senza collegamenti, senza centri di aggregazione. L’ha salvata l’amore per la lettura e da questa ha capito come le storie, la storia vada raccontata, oppure sarà dimenticata o reinterpretata, molto spesso sbagliata, da altri. E il cinema «è il modo migliore per raccontare il contemporaneo». Per interpretare la pulizia e schiettezza del personaggio e il suo rifiuto di roboanti affermazioni, riporto un episodio dell’intervista.
La domanda, tendenziosa alquanto, era se le donne incontravano nel mondo del cinema ucraino maggiori difficoltà degli uomini. Risposta candida: «è un mondo prevalentemente maschile, pieno di tecnici e operai, le poche donne si trovano a doverli imitare, quindi spostare oggetti pesanti e con le mani sempre sporche...».
When the Trees fall è del 2018, poi Nikitiuk ha lavorato per quattro anni ad un nuovo film, Lucky girl, ma il titolo originale è Io, Nina, presentato al Blacks Nights Festival di Tallin a fine novembre 2022. Tra parentesi, Tallin sta diventando un evento strategico per la cinematografia dei Paesi dell’ex blocco sovietico. La trama riprende una storia molto conosciuta, la battaglia contro il cancro di una famosa giornalista e presentatrice televisiva ucraina, Yanina Sokolova. Ma il film «non è un biopic, ho intervistato a lungo medici e pazienti, l’obiettivo è mostrare la lunga battaglia interna che devono affrontare». Aspettiamoci un film duro, di luci dalle diverse tonalità, di ghiaccio (ricordiamo Il senso di Smilla per la neve?), corridoi d’ospedale, suicidi, ma anche voglia di combattere e tenacia per una rinascita. Loris Casadei


CINEFACTS
a cura di Marisa Santin
Non ha avuto un’esistenza sempre luminosa Francesco Nuti, con vita e carriera oscurate negli ultimi anni da una pesante nebbia personale e da un assordante e inspiegabile oblio mediatico. Persino la sua scomparsa, avvenuta il 12 giugno scorso, è passata quasi inosservata, schiacciata da altri avvenimenti più ‘rumorosi’. Vogliamo qui rendere un piccolo omaggio all’uomo e all’artista.
di Alessandro Benvenuti (1981)
Esordio sul grande schermo per i Giancattivi, quando il trio di Nuti, Athina Cenci e Alessandro Benvenuti, regista del film, aveva già raggiunto il grande pubblico televisivo in programmi RAI di successo come Non Stop. Il film ripropone gran parte del loro repertorio, costruito su una comicità caustica sostenuta dalla parlata gergale toscana.

di Maurizio Ponzi (1982)

Uno Spaccone alla toscana, con un Francesco Nuti impiegato d’albergo e appassionato di biliardo all’italiana (come nella vita reale). Il film che ha fatto incontrare Nuti e Giuliana De Sio (Chiara) è stato presentato nella sezione Un Certain Regard al 36. Festival di Cannes. David di Donatello e Nastro d’Argento a entrambi i protagonisti.

Il secondo film diretto da Nuti, scritto insieme a Vincenzo Cerami e Giovanni Veronesi, ci regala una storia intensa e delicata. Dopo cinque anni di prigione Romeo Casamonica ha perso tutto e decide di mettersi alla ricerca del figlio, che nel frattempo è stato dato in adozione. La determinazione di Romeo a riavere per sé il figlio si scontrerà con il suo desiderio di garantirgli una vita felice. Ornella Muti la co-protagonista.

Uno speaker radiofonico notturno che vive alla giornata (Nuti) e un amore improvviso per Anna (ancora la Muti), che però deve sposarsi il giorno dopo. Girato quasi tutto di notte in una Genova misteriosa e seducente, Stregati racconta una storia romantica fuori dai canoni, proibita e appassionata. Fotografia intensa su albe industriali e tramonti marini e colonna sonora (Giovanni Nuti) da Nastro d’Argento.

Il film ha regalato alcune frasi diventate dei veri tormentoni, da «la mortadella è comunista» a «Dammi un bacino». Comicità feroce, battute politicamente scorrette, toni surreali e malinconici: l’universo di Nuti c’è tutto in questo film che scorre sul filo della fragilità e della follia. Nel cast anche Clarissa Burt, Ricky Tognazzi, Novello Novelli e l’ “avvocato buono” Antonio Petrocelli.

Il Campiello è senza dubbio uno dei più importanti riconoscimenti nel campo della letteratura italiana, fondato dagli Industriali del Veneto nel 1961. Nel corso degli anni ha premiato opere fondamentali della narrativa del nostro Paese come, al suo esordio, La tregua di Primo Levi, romanzo imprescindibile per tutte le generazioni. La storia del Premio si intreccia infatti con quella dei più importanti autori da Bufalino a Sgorlon, da Tobino a Soldati, a Rigoni Stern, a Dacia Maraini fino a Veronesi, Scurati, Murgia, Vinci, solo per citarne alcuni.
Il Premio riproduce in argento la tipica vera da pozzo veneziana, ispirandosi a quella di Campo San Trovaso. La proclamazione avviene attraverso il giudizio di una duplice giuria, una tecnica, di cui è Presidente Walter Veltroni con i giurati Pierluigi Battista, Federico Bertoni, Daniela Brogi, Silvia Calandrelli, Edoardo Camurri, Chiara Fenoglio, Daria Galateria, Lorenzo Tomasin, Roberto Vecchioni ed Emanuele Zinato, che nomina i cinque finalisti, e una popolare composta da 300 lettori, che sceglie il vincitore. In gara per questa 61. edizione: La Sibilla. Vita di Joyce Lussu di Silvia Ballestra (Laterza), Centomilioni di Marta Cai (Einaudi), Diario di un’estate marziana di Tommaso Pincio (Perrone editore), La Resistenza delle donne di Benedetta Tobagi (Einaudi) e In cerca di Pan di Filippo Tuena (Nottetempo).
Il Premio Campiello Opera Prima è stato assegnato a Emiliano Morreale con L’ultima innocenza (Sellerio) ed è stata inoltre attribuita una Menzione speciale al libro di Ada D’Adamo, Come d’aria (Elliott), autrice esordiente recentemente scomparsa. Sabato 16 settembre verrà proclamato il vincitore in una cerimonia condotta da Francesca Fialdini e Lodo Guenzi al Teatro La Fenice di Venezia (in diretta su Rai 5).

Abbiamo chiesto agli autori finalisti di rispondere a queste tre domande:
1 _ Essere parte della cinquina finalista del Premio Campiello quale impatto ha sulla sua realtà di scrittore?
Silvia Ballestra – Laterza

Marchigiana, vive e lavora a Milano. È autrice di romanzi, raccolte di racconti e saggi pubblicati per i maggiori editori italiani. Tra i suoi libri, tradotti in varie lingue: Compleanno dell’iguana ; Gli Orsi ; Nina ; I giorni della Rotonda ; Joyce L. Una vita contro; Amiche mie ; Vicini alla terra. Storie di animali e di uomini che non li dimenticano quando tutto trema ; La nuova stagione Dal suo La guerra degli Antò è stato tratto l’omonimo film diretto da Riccardo Milani. Per Laterza ha pubblicato Christine e la città delle dame
2 Q uale la genesi del suo libro finalista?
1 Il premio Campiello è molto prestigioso, con un albo d’oro notevole, una lunga storia e una giuria di alto livello, quindi sono molto onorata e orgogliosa di essere tra i finalisti. Le tappe del tour assieme ai miei compagni di cinquina sono molto stimolanti (e divertenti, siamo un bel gruppo affiatato e amichevole). Sono particolarmente felice di questa occasione che mi permette di far conoscere la storia della mia Sibilla, come veniva anche chiamata Joyce Lussu, a più lettori possibili: proporre il ritratto di questa donna straordinaria che può ispirare e dare forza è lo scopo del libro. La finale al Campiello è un bel traguardo, molto gratificante!
3 _ Quanto proietta di sé stesso nei personaggi che racconta?
2 Il libro è un ritratto di una donna dalla vita magnifica e generosa che è stata una protagonista della storia del nostro Paese e non solo. È la biografia narrata di Joyce Lussu, scrittrice, poetessa, traduttrice, partigiana, donna coltissima aperta alla storia, alla politica, alle lotte per una società più giusta e più libera, femminista, medaglia d’argento per la lotta di liberazione, compagna per una vita del grande Emilio Lussu. Una donna d’azione (tanto che la sua biografia può essere letta come un libro di avventure e di viaggi oltre che d’amore e di storia) e di pensiero. Pensiero rivolto al futuro, il suo, precursore di temi molto attuali come la pace, l’ambiente, le lotte per i diritti delle donne e degli oppressi. Ho raccontato la sua storia lavorando sui documenti, sui suoi scritti, su diverse testimonianze, ma anche grazie alla conoscenza diretta con lei, che ho avuto la fortuna di frequentare per quasi un decennio.
3 Essendo questa una biografia narrata, non romanzata, e basata su fatti veri e su persone realmente esistite, il mio ruolo di narratrice è stato scegliere i fili che ritenevo più importanti per me in questa fase storica, intrecciarli rimontando l’ordito, trovare il tono – che, direi, è proprio il mio tono anche da autrice di romanzi e racconti – e guidare lettori e lettrici nel flusso di questa vita lunga e piena di prospettive originali e inaspettate. Trovo che Joyce Lussu sia un personaggio molto carismatico e spero di esser riuscita a trasmettere nel libro la grande spinta che lei ha saputo produrre con il suo lavoro a idee e persone e che ancora infonde fascino e bellezza.
Marta Cai – Einaudi
Nata a Canelli nel 1980, vive da qualche anno a Curitiba, in Brasile. Ha tradotto molti libri. Alcuni suoi racconti sono stati pubblicati su riviste («inutile», «il Reportage») e nel 2019 nella raccolta Enti di ragione (Edizioni SuiGeneris). Per Einaudi ha pubblicato Centomilioni (2023).
1 La dimensione pubblica che, almeno per un certo periodo, comporta essere in questa selezione, è qualcosa di assolutamente inedito per me, ma è un’esperienza che sto facendo insieme agli altri finalisti, da cui sto imparando molto. Ecco, non so ancora valutare quali saranno gli effetti sulla scrittrice Marta Cai, ma personalmente è un’esperienza inattesa, a dimostrazione della trasparenza della selezione, e di grande apprendimento.
2 Nella precedente raccolta di racconti avevo voluto indagare e mettere in scena gli effetti concreti delle illusioni, dei ricordi, delle proiezioni sulle relazioni umane, registrandole per così dire dall’alto, nella struttura che legava le storie tra loro. In questo libro invece ho voluto addentrarmi più in profondità, concentrandomi sugli effetti dirompenti, ma non necessariamente visibili, del desiderio, dell’impulso che ci muove verso l’altro o l’altrove, raccontando una storia piccola, con una protagonista “senza qualità” e apparentemente priva di moti vitali, tenuta in apnea in un mondo in cui qualsiasi slancio è violentemente annichilito o, peggio, codificato.
3 In una lettera a Freud, Stefan Zweig scrive: «Non esiste un prodotto dell’immaginazione senza fonti nella realtà: ogni invenzione è un ritrovamento»; ossia, più che proiettarmi, attribuendo al personaggio caratteristiche mie, avviene il processo inverso. Il mio punto di partenza è sempre un nucleo, un motivo esistenziale, e invento i personaggi che possano esserne animati, evitandone la riduzione a puri simulacri. E lì inevitabilmente mi ritrovo, più distillata che esposta.

Tommaso Pincio – Giulio Perrone editore

Scrittore e pittore, vive e lavora a Roma. Ha pubblicato M. (Cronopio, 1999), Lo spazio sfinito (Fanucci, 2000; minimum fax, 2010), Un amore dell’altro mondo (Einaudi, 2002), La ragazza che non era lei (Einaudi, 2005), Cinacittà (Einaudi, 2008), Hotel a zero stelle (Laterza, 2011), Pulp Roma (il Saggiatore, 2012), Panorama (NN Editore, 2015), Scrissi d’arte (L’orma editore, 2015) e Il dono di saper vivere (Einaudi, 2018). Ha tradotto autori quali Kerouac, Cheever, Dick, Fitzgerald, Updike, Orwell, Stoker.
1 L’impatto di uno stordimento felice e grato, un incrociarsi di emozioni diverse. Ci si sente immeritevoli ma comunque accolti. Immeritevoli perché scrivere vuol dire scoprirsi ogni giorno più piccoli, inadeguati, pieni di limiti. Accolti perché i premi davvero importanti e con una precisa identità sono sempre espressione di una tradizione, di un’idea di mondo e comunità, uno di quei momenti in cui i libri escono dalla solitudine di una stanza per scendere in piazza. Il Campiello peraltro esprime questa idea fin nel nome.
2 È nato d’impulso e quasi per caso, pensando a una passeggiata sentimentale per strade di Roma in compagnia di Ennio Flaiano, che nella Capitale è arrivato dodicenne per restarci fino alla morte, tra alti e bassi, momenti di amore e disamore. È anche un libro che rievoca il Novecento con gli occhi del presente, il mondo di ieri visto con gli occhi di oggi, dunque un libro sul più grande dei misteri: il tempo.
3 Vengo dall’arte. Sono un pittore mancato che si è ritrovato a scrivere. Osservo i miei personaggi con la disposizione di chi si appresta a fare un ritratto, per cui non mi resta che rispondere come Leonardo: ogni dipintore dipinge sempre se stesso.

Nata a Milano nel 1977, laureata in filosofia, Ph.D in storia presso l’Università di Bristol, continua a lavorare sulla storia dello stragismo. È stata conduttrice radiofonica per la Rai e collabora con «la Repubblica». Dal 2012 al 2015 è stata membro del Consiglio di Amministrazione della Rai. Si occupa di progetti didattici e formazione docenti sulla storia del terrorismo con la Rete degli archivi per non dimenticare. Per Einaudi ha pubblicato Come mi batte forte il tuo cuore. Storia di mio padre (2009 e 2011), Una stella incoronata di buio. Storia di una strage (2013 e 2019), Piazza Fontana. Il processo impossibile (2019) e La Resistenza delle donne (2022).
1 Essere inclusa nella cinquina è stata una sorpresa, una gioia e un’emozione grandissima. Come scrittrice, mi ha fatto piacere soprattutto riscontrare come le scelte di quest’anno vadano nella direzione di una sempre maggiore apertura rispetto a vecchie distinzioni come quella tra fiction e non fiction.
2 La Resistenza delle donne nasce insieme da un’occasione e da cause profonde. L’occasione è stata una manciata di fotografie d’archivio di donne partigiane dell’Istituto della Resistenza di Torino, immagini evocative, potenti, che spalancavano la porta al racconto: da lì è partita la ricerca e la scelta di costruire una narrazione in cui testo e immagini sono strettamente intrecciate. La causa profonda era il desiderio di riprendere il filo di un discorso intrapreso anni fa con Una stella incoronata di buio, in cui racconto una corale di giovani donne formidabili, protofemministe, a cui toccò in sorte di essere uccise dalla bomba di Brescia del 1974: desideravo raccontarle perché mi rendevo conto che era anche grazie a loro se, come donna, ho possibilità e libertà impensabili anche solo qualche decennio fa. Andando alla riscoperta dei volti e delle voci ho fatto un passo indietro in questa genealogia collettiva, alla scoperta delle “antenate”, come mi piace chiamarle.
3 Scrivo di personaggi reali: più che proiettare me stessa in loro, ho cercato di entrare in connessione con loro, farmi canale della loro voce. Nelle loro parabole esistenziali, nelle loro scelte, emozioni, paure, entusiasmi, ho trovato tantissime cose che risuonano profondamente nella mia vita, mi hanno messo davanti a domande difficili. Le ho sentite, e continuo a sentirle, come delle compagne di viaggio, che mi ispirano, mi provocano, mi danno forza.
Nato a Roma nel 1953, ha vinto il Premio Grinzane Cavour con Tutti i sognatori (Fazi, 1999), il Premio Bagutta con Le variazioni Reinach (Rizzoli, 2005; beat, 2015) e il Premio Viareggio con Ultimo parallelo (Rizzoli, 2007; il Saggiatore, 2021). Tra le sue opere recenti, tutte pubblicate dal Saggiatore: Le galanti (2019) e La voce della Sibilla (2022).

1 Per me, che compio settant’anni tra poche settimane, forse essere nella cinquina finalista del Premio Campiello potrebbe rappresentare la ciliegina sulla torta di una carriera più che trentennale.
2 Il libro, scritto durante il periodo cupo del Covid, nasce da ricordi di viaggi in Grecia, nelle Cicladi e nel Peloponneso e da una suggestione di un testo di Plutarco, dove una voce misteriosa proveniente dall’isola di Paxos annunciava che il “Grande Dio Pan è morto”. Il libro cerca di verificare se Pan sopravvive comunque.
3 Direi che proietto molto di me nella voce che narra i miei libri. Sono sempre presente e a volte intervengo direttamente, mentre i personaggi di cui racconto sono quasi sempre esistiti realmente, come esseri umani o come figure mitologiche.


Le usiamo tutti i giorni, senza accorgercene, senza pensarci, senza apprezzarle a dovere, istintivamente, per esprimerci, per comunicare, per domandare, per sentirci esseri umani, per criticare, per dissentire, per lodare, per ammirare, per litigare, per entusiasmarci, per ingannare, per alludere, per rifiutare, per accettare, per suggerire, per concretizzare pensieri, per spiegare, per protestare, per aiutare, per agitare, per chiamare, per trattare, per mortificare, per scusarci, per provare, per verificare, per tradurre, per scherzare, per accordarci, per escludere, per far rima, parole per conquistare, per materializzare, per rimandare, per declamare, per sostenere, per ripetere, per chiarire, per stupire, per sfogarci, per imparare, per risolvere, per negare, per vestire un canto, persino per pregare. Sono solo parole…
accennate, accusatorie, addolorate, affascinanti, affermative, allegre, allusive, ambigue, attese, che introducono, che presentano, chiare, chiarificatrici, complici, conclusive, consolatorie, contraddittorie, contrarie, creative, d’affetto, d’ammirazione, d’apprezzamento, definite, derivate, di addio, di circostanza, di gratitudine, di incoraggiamento, di pace, di saluto, di sfogo, dialettali, difficili, dispositive, dovute, enigmatiche, esplicite, false, formali, garbate, gridate, inappropriate,
incomprensibili, insensate, integrative, interrogative,
interrotte, intuite, inutili, inventate, leziose, mancanti, mendaci, narranti, negate, nostalgiche, note, nuove, originali, ovvie, poetiche, polemiche, profonde, ricercate, ripetute, riportate, riservate, rispettose, rubate, sante, scandite, scioccanti, sciocche, semplici, sentite, senza senso, sfuggite, sfumate, sicure, sintetiche, solidali, sospese, sporche, stimolanti, superficiali, sussurrate, tecniche, timide, traditrici, ultime, volgari.
E pensare che sono soltanto… parole! Già, ma per dare un’idea del loro valore pensate che addirittura, nella Bibbia (Torah) i dieci Comandamenti sono detti “Assèret ha’devarim” (Esodo 34:28) e la tradizione li chiama “assèret hadibrot”, ovvero “dieci parole” o “dieci espressioni”!
Soltanto parole? Cosa sarebbe il mondo senza? Non oso pensarci! Nella migliore delle ipotesi sarebbe monocolore, diciamo, convenzionalmente, grigio, irreale, uniforme, incomunicato, non comunicabile, non esprimibili i sentimenti, le sensazioni, i pensieri. Chissà perché mi viene in mente la famosa monade di Leibniz: noi potremmo essere tanti “granelli di polvere”, ciascuno un mondo a sé, incapaci di comunicare, di conoscere il mondo che ci sta accanto. Forse un mondo caotico. Ma, suvvia, cerchiamo di non essere così pessimisti, così tragici. Invece, per fortuna, guardiamo la realtà, la norma. Quanta ricchezza abbiamo! Quanta raffinatezza è messa a nostra disposizione! Ma, attenzione, anche quanta responsabilità: le parole sono pensieri, le parole sono pietre! Possono essere un’arma. Possono addirittura conquistare. Possono tradurre uno sguardo. Spiegarlo. Interpretarlo. Apriamo una finestra (anche mentale) e apprezziamole! Non sprechiamole. Sono insostituibili! Se avete il coraggio, datemi torto, si, ma per farlo, dovete farlo
ovviamente in silenzio, senza… parole!
Non si sfugge al Redentore, inteso come l’appuntamento di mezza estate a Venezia, un momento inevitabile nella scansione del calendario cittadino, di cui però nessuno si lamenta, anzi viene atteso dai più con trepidazione. Della notte dei foghi si è scritto la qualunque, ogni volta è una sfida per trovare le parole adatte a raccontare un momento di gioia collettiva, che va partecipato più che descritto. La festa del Redentore è famosa ben oltre i confini della Laguna e in questa occasione i molti detrattori di Venezia, che numerosi vivono in Veneto e che d’abitudine reputano la città lagunare un onere più che un onore, per una volta gioiosamente convenuti ad ammassarsi nelle rive a portata di spettacolo, apostrofano felici con esclamazioni afferenti alle divinità in generale ogni bagliore che appare a rischiarare la notte. Capita sempre con le feste che nascono a carattere religioso, si finisce col marginalizzare il significato originario della celebrazione per esaltarne la spettacolarizzazione e trattandosi del bacino di San Marco, illuminato da centinaia di fuochi colorati che fanno brillare il cielo in una notte di luglio come tante stelle che esplodono in una sequenza ritmata che cresce di pari passo con lo stupore delle migliaia di occhi all’insù, non può che costituire una fortissima esaltazione della bellezza e della pazzia di una città unica, che regge il suo destino sulla forza della sua stessa fragilità.
Il ponte votivo che collega le Zattere alla chiesa palladiana del Redentore crea una circolarità di movimento che regala l’ebbrezza di camminare sulle acque, togliendo per qualche ora alla Giudecca la sua identità di isola. Un miracolo laico che si compie a Venezia ogni anno, quando la bellezza riesce ad unire molti sotto lo stesso coloratissimo cielo.
The Redentore, the popular Venetian midsummer fete dedicated to Christ the Redeemer, is all-encompassing. There’s no way around it, every heart and mind in Venice are looking forward to the great event. So much has been written on, and dedicated to, the Redentore, and every time the challenge gets harder. What words can convey the sense of the greatest collective joy? It’s something you must experience in first person. Even the rest of the Venetia, who oftentimes think about their metropolis in terms of hindrance, rather than honour, can’t wait to join the crowd by the quays on the night of the foghi, the fireworks that are twice the show: one up in the sky, the second their amazing reflection on the water. Venice has a long history of popularizing what began as solemn religious fetes. Their original meaning had long been pushed back, and the fireworks night is now a celebration of the beauty and craziness of a unique city, whose destiny resides in the strength of its own fragility. A temporary bridge will be installed between the Zattere, the southern embankment on the main landmass of the city, and the Redentore Church in the Giudecca Island, due south of it. The exhilarating feeling of walking on waters is a popular miracle that happens in Venice every year, when beauty joins us together under the same rainbow-tinted sky.
Ricordo ancora con nostalgia prima dea festa del Redentor che a casa preparava, con euforia, paste e fasioi, peperonata e saor… Renato Pergola, Redentore del 1954

Alcuni consigli di cucina tradizionale da barca o in riva per la cena del Redentore:
Sardine fritte e cipolla passata in padella con dell’aceto bianco con aggiunte anche l’uva passa e i pinoli. Il piatto viene assemblato in una pirofila, uno strato di sardine, uno di cipolla e così via, e lasciato riposare in frigo per alcuni giorni. La ricetta pare risalga ai primi anni del 1300 e che sia nata dalla necessità dei marinai di conservare più a lungo il pesce. Il mix di cipolle e aceto permetteva al pesce di durare molto a lungo.

La ricetta ha radici molto antiche, alcuni la fanno risalire addirittura all’epoca di Marco Polo e rappresenta un piatto povero, ma molto ricco di sapore, un classico della cucina veneziana e veneta. Un tipo di pasta fatta in casa, la tradizione vorrebbe i bigoi di Bassano – in extremis si possono usare anche gli spaghetti –, condita con una salsa di acciughe e cipolla. Da servire rigorosamente senza parmigiano e, se avanzano, sono ancor più buoni freddi il giorno dopo.

Si possono utilizzare varie tipologie di pasta, anche se tradizione vorrebbe la “tiracca trevigiana”, i ditalini o il riso; i fagioli possono essere interi, macinati o mezzi e mezzi, dipende se si preferisce un piatto più o meno asciutto. Ottimi se serviti tiepidi, ma anche freddi sempre con un giro d’olio versato a filo. La tradizione prescrive una regola fondamentale: la provenienza dei fagioli, rigorosamente di Lamon, nel feltrino, a 600 metri di quota.

Essere un innovatore significa spesso lasciare un segno nella storia, in questo caso nella storia enologica del Prosecco di Conegliano Valdobbiadene, che 100 anni fa, quando nacque Giuliano Bortolomiol, era ancora tutta da scrivere. L’imprenditore di Valdobbiadene, venuto a mancare nel 2000, è stato uno degli 11 fondatori del Consorzio di tutela della Docg che oggi brilla sui mercati e uno dei pionieri della tecnica spumantistica: è stato il primo infatti a realizzare il Prosecco nella versione brut. A un secolo dalla sua nascita, le figlie Elvira, Maria Elena, Giuliana e Luisa, che ora guidano la cantina, con la presenza vigile e partecipata della loro madre Ottavia Scagliotti, hanno deciso di ristampare un libro di Ettore Gobbato: Il sogno del Prosecco di Giuliano Bortolomiol, edito da Giunti. Il volume racconta la storia del Prosecco attraverso la passione di una grande famiglia che ha saputo trasformare questo vino, originariamente consumato solo in una parte del Veneto, in un vino conosciuto, apprezzato, comprato e bevuto in tutto il mondo. Si tratta della realizzazione del sogno visionario di Giuliano Bortolomiol, che in un’epoca eroica ha saputo creare, vigna dopo vigna, l’azienda oggi tutta al femminile. Le testimonianze storiche che si trovano tra le pagine raccontano della tenace volontà di ricostruire un patrimonio di vigneti che erano andati quasi completamente distrutti dalla guerra e di una testarda resistenza all’omologazione, con la forte volontà di creare un’identità italiana anche nel vino. F.M.
Pietra Rossa è la nuova tappa gastronomica di Andrea Lorenzon, che dal Covino, piccolo e straordinario locale, che per un decennio ha deliziato i palati dei pochi fortunati avventori che riuscivano ad accaparrarsi un tavolo, si è spostato, sempre a Castello – una delle ultime aree in città rimaste ancora abitate da un nucleo di residenti resistenti – in un locale più ampio, che parte da una vecchia osteria, Alle Alpi da Dante, frequentata soprattutto da chi abitava in zona. Dopo un restauro significativo ne è nato un Covino ‘allargato’, in cui forse sarà meno arduo poter riservare un tavolo. Così Andrea Lorenzon parla della nuova avventura: «Un posto in cui ritrovarsi, in cui sentirsi da sempre a casa e in cui vorrei che ad ognuno sembrasse di essere già stato. Manterremo lo stile, la passione e la texture del Covino anche nei piatti, senza la rigida suddivisione in portate, ma piuttosto con verdure, pesce, carne e primi piatti, guardando a quanto di buono ci arriva grazie a Osti in Orto, al pescato dell’Alto Adriatico, alle carni dei presidi slow food e da filiere etiche e sostenibili. Oltre che alla carta, ci sarà anche qui la possibilità di scegliere la formula “ fa’ ti ” (ti lascio fare), affidandosi all’estro di chi sta in cucina».

Il luogo in cui si trova Pietra Rossa è uno dei più suggestivi di Castello, il sotoportego de la Corte Nova, che è al centro di suggestioni e leggende del passato. Qui si trova tra la pavimentazione abituale di Venezia, una pietra di colore rosso vivo, sopra la quale, così vuole la leggenda, cadde a terra la peste nera del 1630, che non ebbe riguardo degli abitanti di Venezia, colpiti massicciamente – i numeri parlano del quaranta per cento della popolazione di allora deceduta –, tranne miracolosamente i residenti della zona della Corte Nova che rimasero immuni. La leggenda narra che a una donna di nome Giovanna, residente in zona, apparve in sogno la Madonna che le disse di dipingere un quadro raffigurante la sua santa figura insieme a San Rocco e San Sebastiano. Il dipinto avrebbe dovuto essere collocato all’interno del sotoportego, secondo indicazioni mariane. Giovanna eseguì alla lettera quanto ordinato dalla Madonna. La peste venne bloccata, nel punto esatto dove oggi troviamo la pietra rossa, simbolo della sconfitta della piaga. Da quel momento in poi, i veneziani che passano per quella zona evitano di calpestare questa pietra rossa. Fabio Marzari




Opening: 19 May 2023, 7pm


Thursday — Monday 10am — 6pm
Complesso dell’Ospedaletto
Barbaria de le Tole 6691

Venice
An ecocritical laboratory projecting present Venice into the future
Iniziamo un percorso nel tempo in cui Venezia era ancora una città viva e popolata, con molti bambini per strada, brulicante di attività e capace di convivere con il suo passato senza per questo condizionare pesantemente il suo presente. Ma non vuole essere un’operazione nostalgica, al contrario un racconto basato su accadimenti reali condotto sul filo delle parole di un veneziano doc, Alessandro Zoppi, che ha avuto il privilegio di attraversare lo splendore di una normalità che aveva il carattere dello straordinario, senza rimanerne ingabbiato. Alessandro appartiene a quella stirpe di veneziani che incarnano al meglio il carattere della città, aperta al mondo, ma anche gelosa e fiera delle proprie tradizioni, in grado di mescolare continuamente il registro alto della bellezza e dell’esclusività con quello non necessariamente più basso, meglio definirlo normale, della quotidianità in un contesto di meraviglia.
Alessandro Zoppi è uno dei massimi esperti di storia del vetro di Murano, è un antiquario e collezionista di oggetti preziosi e rari che testimoniano un sapere unico ed originale, fragile e duraturo nei secoli. Un veneziano il cui sguardo non conosce confini e la cui eleganza è esercizio di pratica quotidiana, sic et simpliciter.
«Per circoscrivere un’età da cui partire, penso a me verso la fine delle scuole elementari, più o meno in quinta. Le estati di allora erano stagioni lunghissime, che iniziavano andando al Lido in spiaggia nel mese di giugno, poi a luglio ci trasferivamo nella villa di Onè di Fonte, dove passavamo le nostre estati. Ma la bella stagione aveva un arco temporale ancora più esteso, partiva infatti da Pasqua e si protraeva fino alla Regata Storica, a settembre. La mia famiglia aveva un albergo e un ristorante e allora quasi tutte le attività ricettive chiudevano in autunno e restavano solamente gli operai a fare la manutenzione, molti di loro provenivano dal Friuli. Pensando al turismo di oggi con tutti i suoi eccessi, ricordo la qualità e il livello di allora, anche il turismo cosiddetto medio era educato e molto rispettoso. Ho dei ricordi di ospiti inglesi che soggiornavano in albergo e si facevano lavare e stirare le camicie ed io, che curiosavo nella stireria che si trovava nel sotto tetto, sentivo le cameriere che commentavano «Varda ga tuti i polsi rosegai» (guarda ha tutti i polsi lisi)... e ancora i facchini che con sacchi di iuta sulle spalle trasportavano i blocchi di ghiaccio che arrivavano dalla fabbrica del ghiaccio alla Giudecca e i ventilatori con le striscioline di carta attaccate alle pale che orientavano la direzione del soffio.
Quando gli ospiti uscivano dagli alberghi la sera per andare a cena in via XXII Marzo e a San Moisè verso San Marco era come un giardino di profumi, veramente eccezionale.
Tornando alle ore diurne c’erano le infinite partite di pallone a San Stefano, in campiello Pisani, fino a quando capitava che arrivasse il vigile e sequestrava il pallone, ma la mia vera passione era la bicicletta, che potevo usare solo in campagna.

A Venezia c’erano molte botteghe e nelle case spesso la gente amava stare seduta fuori a conversare: tutto questo mondo di artigiani, dai falegnami agli argentieri, tappezzieri, materassai e moltissimi altri che vedevo lavorare non poteva che colpire e attrarre la mia fantasia. Altra cosa buffa a pensarci per me bambino era l’Italia, cos’era l’Italia? Era quando si partiva per andare in campagna col seguito dei due bulldog che mio padre metteva nel portabagagli, bastava arrivare a piazzale Roma e si formava ogni volta un capannello di
gente incuriosita da questi strani cani, che allora erano una assoluta rarità. L’Italia era quando uscivamo dal Ponte della Libertà, era quella l’Italia, per me esisteva Venezia!
Nei canali si nuotava, almeno molti ne approfittavano per fare il bagno, ma ahimè mi era assolutamente proibito farlo. Trasgredivo solo quando potevo accompagnare le inservienti che portavano i tappeti dell’albergo in Laguna per lavarli, venivano messi a mollo in acqua, e allora era impossibile non approfittare dell’occasione per un bel bagno.
Venezia era per me bambino un territorio da scoprire, c’era una parte della città in cui non potevo andare e quando mi recai di nascosto dai miei genitori con un mio amico alla Giudecca per la prima volta, avevo quasi 10 anni. Entrambi indossavamo i jeans e senza sapere una parola d’inglese ci fingemmo americani, forse perchè esplorando quel territorio per noi del tutto ignoto sentivamo le voci di qualcuno che additandoci diceva “vara i americani” (guarda gli americani) e così, sotto mentite spoglie, ho visto per la prima volta la Giudecca!»
[Primo episodio]



The most fabulous staircases of the City
Scuola Grande San Giovanni Evangelista and Scala Contarini del Bovolo





biglietto combinato | combined ticket
gioiellinascostidivenezia.it | scuolasangiovanni.it
 a cura di Fabio Marzari
a cura di Fabio Marzari
La rincorsa alla migliore ospitalità alberghiera trova un nuovo e importante stakeholder nel Nolinski Venezia, aperto alla città e al mondo nell’edificio che ospitò la Borsa di Commercio, in Calle Larga XXII Marzo, la strada dello shopping più elegante ed esclusivo. Un edificio novecentesco, completato nel 1929, che ebbe la particolarità di essere il primo in Laguna in cui venne usato il cemento armato come materiale di costruzione. Art Nouveau, Liberty e Modernismo si fondono in una perfetta armonia riportata a nuova luce dal duo di interior designer franco-italiano LeCoadic-Scotto. Un edificio imponente con i suoi cinque piani, almeno rispetto ai volumi veneziani, austero e parimenti delicato, di cui basta varcare la soglia d’ingresso per scoprire i dettagli che rendono il soggiorno un’esperienza magnifica. Un lavoro importante eseguito da esperti artigiani: lo stucco marmoreo e il marmorino gareggiano in preziosità e in contrasto con le boiseries e le cornici di legno di mango, mentre le opere d’arte antiche e contemporanee attirano lo sguardo in ogni angolo dell’hotel. L’edificio pur essendo abbastanza recente, racchiude in sé tutto il sapere di antiche e raffinate tecniche artigianali, quali i pavimenti e le lavorazioni in ferro battuto, a testimonianza di un’epoca felice per la città, almeno dal punto di vista della vitalità sociale e urbanistica. Elementi d’epoca convivono e si permeano alla perfezione con il design d’interni iper contemporaneo nelle 43 stanze, di cui 13 suite, oltre che negli spazi comuni come il patio, il caffè, il bar-biblioteca ricco di volumi in consultazione e lettura, il ristorante gastronomico, la Spa di ispirazione ottomana e la vasca piscina con vista panoramica, decorata con mosaici d’oro, in cui lo sguardo si protende sui tetti di Venezia. Un breve approfondimento meritano il bar biblioteca, che vuole essere un omaggio a Venezia capitale della stampa, con oltre 4000 volumi a disposizione del pubblico e il ristorante Palais Royal, fastoso e concepito come un vero e proprio teatro gastronomico in cui ogni giorno va in scena la “danza” dei camerieri in stile Grand Siècle Il servizio di alta qualità richiede tempo, commisurato alle emozioni che lo chef Philip Chronopoulos, in qualità di responsabile del cerimoniale in cucina, desidera far vivere. «Mi piace orientarmi verso una cucina più autentica, senza pretese di impressionare o mettermi in mostra con improbabili accostamenti. Desidero regalare un’esperienza da ricordare e servire ad ogni portata un piatto squisito [...]».
ENG Vying for a place in the Empyrean of Venetian hotellerie is a brand new contendent, the Nolinski, a hotel that opened in the building that once housed the Venice Stock Exchange. The building, completed in 1929, was the first in Venice that made use of reinforced concrete. Art Nouveau and Modernism blend in harmony, highlighted by the work of interior design firm LeCoadic-Scotto: marble stucco, boiserie, ancient and modern art, wrought iron, all beautiful testimony of a golden time in Venice,a t least from the point of view of social and urban vitality. Vintage elements coexist naturally with hyper-modern touches in the 43 rooms and in the common areas: the patio, café, library, restaurant, Ottoman-inspired spa, and the golden mosaic-decorated panoramic pool. The library we mentioned is of particular note. It pays homage to the early printing industry of Venice and maintains a collection of 4000 books. The high-quality restaurant service is entrusted to the care of chef Philip Chronopoulos, who won’t settle for anything but “authentic cuisine, no pretentiousness, no weird combinations, nothing but a great experience to remember.”
N olinski Venezia Calle XXII Marzo, San Marco 2032 www.nolinskivenezia.com
04
martedìTuesday
Sherwood Festival BAUSTELLE Rock d’autore Park Nord Stadio Euganeo-Padova h. 21.15
05 mercoledìWednesday
AMA Music Festival
THE CHEMICAL BROTHERS
BLOODY BEETROOTS
MOTEL CONNECTION
Musica elettronica
Villa Ca’ Cornaro-Romano d’Ezzelino h. 21
09 domenica Sunday
Venezia Jazz Festival
PAOLO CONTE
Jazz
Festival del Vittoriale DEAN LEWIS
Pop
Anfiteatro del Vittoriale-Gardone
Riviera h. 21.15
13 giovedìThursday
Women for Freedom in Jazz ROSA EMILIA DIAS
Jazz
Hotel Carlton on the Grand Canal h. 20.30
16 domenica Sunday
Festival del Vittoriale
HOZIER
Indie
Anfiteatro del Vittoriale-Gardone
Riviera h. 21.15
No Borders Music Festival
LAMANTE Folk Lago Superiore di Fusine-Tarvisio h. 13
Piazza San Marco h. 21
Sherwood Festival GIANCANE Pop Park Nord Stadio Euganeo-Padova h. 21.15
06 giovedìThursday
Sexto ‘Nplugged
HANIA RANI
Musica neoclassica
Piazza Castello-Sesto al Reghena h. 21.15
Festival del Vittoriale
NILS FRAHM
Musica neoclassica
Anfiteatro del Vittoriale-Gardone Riviera h. 21.15
07
venerdì Friday
Sherwood Festival
KABAKA PYRAMID
Reggae
Park Nord Stadio Euganeo-Padova h. 21.15
Sexto ‘Nplugged
KING HANNAH
Indie
Piazza Castello-Sesto al Reghena h. 21.15
Festival del Vittoriale VENERUS
Indie
Anfiteatro del Vittoriale-Gardone Riviera h. 21.15
08 sabato Saturday
Sherwood Festival
CALIBRO 35
Reggae
Park Nord Stadio Euganeo-Padova h. 21.15
Sexto ‘Nplugged VERDENA
Rock Piazza Castello-Sesto al Reghena h. 21.15
Festival del Vittoriale
FIORELLA MANNOIA
DANILO REA
Jazz
Anfiteatro del Vittoriale-Gardone
Riviera h. 21.15
Sexto ‘Nplugged
BEN HOWARD
Folk
Piazza Castello-Sesto al Reghena h. 21.15
11 martedìTuesday
DAMIEN RICE
Pop d’autore
Teatro La Fenice h. 21
Marghera Estate
ITALIAN DIRE STRAITS
Dire Straits tribute
Piazza Mercato-Marghera h. 21
Sherwood Festival
CARL BRAVE
Rap Park Nord Stadio Euganeo-Padova h. 21.15
Marostica Summer Festival
MIKA
Pop
Piazza degli Scacchi-Marostica h. 21.15
Sexto ‘Nplugged
DRY CLEANING
Post punk
Piazza Castello-Sesto al Reghena h. 21.15
12
mercoledìWednesday
JULIE CAMPICHE
Musica d’autore
“New Echoes System“
Collezione Guggenheim h. 21
Marghera Estate
SASHA TORRISI
Battisti tribute
Piazza Mercato-Marghera h. 21
Marghera Estate
SPANDAU VS DURAN
80’s tribute
Piazza Mercato-Marghera h. 21
Marostica Summer Festival BIAGIO ANTONACCI
Pop
Piazza degli Scacchi-Marostica h. 21.15
14 venerdì Friday
Venezia Jazz Festival
ESTEBAN MAXERA TRIO
Jazz Laguna Libre h. 20.45
Marghera Estate
CREDENCE CLEARWATER
REVIVED
Creedence tribute
Piazza Mercato-Marghera h. 21
TIZIANO FERRO
Pop Stadio Euganeo-Padova h. 21
15
sabato Saturday
Venezia Jazz Festival
NILZA COSTA
Afro jazz
Laguna Libre h. 20.45
Sherwood Festival
SEUN KUTI
Afro beat
Park Nord Stadio Euganeo-Padova h. 21.15
Festival del Vittoriale
DAMIEN RICE
Pop d’autore
Anfiteatro del Vittoriale-Gardone
Riviera h. 21.15
No Borders Music Festival
BEN HARPER
Rock d’autore
Lago Superiore di Fusine-Tarvisio h. 14
No Borders Music Festival
DORO GJAT
Rap Lago Superiore di Fusine-Tarvisio h. 14
No Borders Music Festival
MANNARINO
Musica d’autore Lago Superiore di Fusine-Tarvisio h. 14
17 lunedì Monday
KENDRICK LAMAR Rap
Arena di Verona h. 21
Festival del Vittoriale
KALEO
Rock
Anfiteatro del Vittoriale-Gardone Riviera h. 21.15
18 martedìTuesday
Marghera Estate EVERYPLAY
Coldplay tribute
Piazza Mercato-Marghera h. 21
PLACEBO
Rock
Anfiteatro Camerini-Piazzola sul Brenta h. 21
19 mercoledìWednesday
Marghera Estate
TIZIANO FERRO TRIBUTE Pop
Piazza Mercato-Marghera h. 21
Festival del Vittoriale
TOM ODELL
Indie
Anfiteatro del Vittoriale-Gardone Riviera h. 21.15
20 giovedìThursday
Women for Freedom in Jazz CUARTETO REMEDIO
Jazz Hotel Carlton on the Grand Canal h. 20.30
27 domenica Sunday
AMA Music Festival
MEGADETH LACUNA COIL KATATONIA
MESSA
Metal Villa Ca’ Cornaro-Romano d’Ezzelino h. 21
30 mercoledìWednesday
Operaestate Festival
DAN KINZELMAN
Musica contemporanea Chiostro del Museo Civico-Bassano del Grappa h. 21 h. 19
INDIRIZZI
ALTOPIANO DEL MONTASIO
Tarvisio www.nobordersmusicfestival.com
ANFITEATRO CAMERINI
Piazzale Camerini-Piazzola sul Brenta www.zedlive.com
ANFITEATRO DEL VITTORIALE
Via Vittoriale 12-Gardone Riviera www.anfiteatrodelvittoriale.it
ARENA DI VERONA
Piazza Bra-Verona www.arenalive.it
AUDITORIUM LO SQUERO
Isola di San Giorgio Maggiore www.venetojazz.com
CHIOSTRO MUSEO CIVICO
Piazza Garibaldi 34-Bassano del Grappa www.operaestate.it
COLLEZIONE GUGGENHEIM
Dorsoduro 701 www.guggenheim-venice.it
COMBO
Campo dei Gesuiti 4878 www.venetojazz.com
HOTEL CARLTON ON THE GRAND CANAL
Santa Croce 578
Fb: Women for Freedom in Jazz
LAGO SUPERIORE DI FUSINE
Tarvisio www.nobordersmusicfestival.com
LAGUNA LIBRE
Fondamenta Cannaregio www.venetojazz.com
PALAZZO MUNICIPALE
Piazza Marconi 16-Fiesso d’Artico www.venetojazz.com
31 giovedìThursday
Women for Freedom in Jazz
ILARIA FANTIN
Jazz
Hotel Carlton on the Grand Canal h. 20.30
Operaestate Festival
RAZEN
Musica contemporanea
Chiostro del Museo Civico-Bassano del Grappa h. 21 h. 19
venerdì Friday
RIGOLETTO
Musica di Giuseppe Verdi
Regia Antonio Albanese
Direttore Marco Armiliato
“100° Arena Opera Festival“
Ingresso/Ticket € 270/32
Arena di Verona h. 21
GIOVANNI ANDREA ZANON
violino
ELIA CECINO pianoforte
Musiche di Beethoven, Brahms
“Operaestate“
Ingresso/Ticket € 15
Teatro Tito Gobbi-Bassano del Grappa h. 21.20
PARK NORD STADIO
EUGANEO
Viale Nereo Rocco 40-Padova www.sherwood.it
PARCO RAGAZZI DEL ‘99 Bassano del Grappa www.duepuntieventi.com
PIAZZA CASTELLO
Sesto al Reghena www.sextonplugged.it
PIAZZA DEGLI SCACCHI
Marostica www.marosticasummerfestival.it
PIAZZA EREMITANI
Padova www.castellofestival.it
PIAZZA MERCATO
Marghera www.comune.venezia.it
PIAZZA SAN MARCO
Venezia www.venetojazz.com
RIFUGIO GILBERTI Sella Nevea www.nobordersmusicfestival.com
STADIO EUGANEO
Viale Nereo Rocco-Padova www.zedlive.com
TEATRO LA FENICE
Campo San Fantin 1965 www.venetojazz.com
TEATRO TITO GOBBI
Piazza Terraglio-Bassano del Grappa www.operaestate.it
TOLMINO
Slovenia
www.overjamfestival.com
VILLA CA’ CORNARO
Romano d’Ezzelino
www.amamusicfestival.com
08
sabato Saturday
ORCHESTRA E CORO DEL TEATRO LA FENICE
JURAJ VALCUHA direttore
FEDERICA LOMBARDI
soprano
VERONICA SIMEONI
mezzosoprano
MICHAEL SCHADE tenore
MARK S. DOSS basso
Musiche di Beethoven
Ingresso/Ticket € 280/40
Piazza San Marco h. 21
VENICE CELLO ENSEMBLE
Musiche di Rachmaninov, Vivaldi
“Il Marcello Suona 2023“
Ingresso libero/Free entry
Conservatorio Benedetto Marcello h. 20.45
TRAVIATA
Musica di Giuseppe Verdi
Regia Franco Zeffirelli
Direttore Andrea Battistoni
“100° Arena Opera Festival“
Ingresso/Ticket € 270/32
Arena di Verona h. 21
09
AIDA
domenica Sunday
Musica di Giuseppe Verdi
Regia Stefano Poda
Direttore Marco Armiliato
“100° Arena Opera Festival“
Ingresso/Ticket € 330/35
Arena di Verona h. 21
13 giovedìThursday
IL BARBIERE DI SIVIGLIA
Musica di Gioachino Rossini
Regia Hugo de Ana
Direttore Alessandro Bonato
“100° Arena Opera Festival“
Ingresso/Ticket € 270/32
Arena di Verona h. 21
14 venerdì Friday
TRAVIATA
Musica di Giuseppe Verdi
Regia Franco Zeffirelli
Direttore Andrea Battistoni
“100° Arena Opera Festival“
Ingresso/Ticket € 270/32
Arena di Verona h. 21
15 sabato Saturday
NABUCCO
Musica di Giuseppe Verdi
Regia Gianfranco De Bosio
Direttore Daniel Oren
“100° Arena Opera Festival“
Ingresso/Ticket € 270/32
Arena di Verona h. 21
16 domenica Sunday
AIDA
Musica di Giuseppe Verdi
Regia Stefano Poda
Direttore Marco Armiliato
“100° Arena Opera Festival“
Ingresso/Ticket € 330/35
Arena di Verona h. 21
19 mercoledìWednesday
ROBERTO BOLLE AND FRIENDS
Musiche e coreografie del repertorio classico e contemporaneo italiano e internazionale
“100° Arena Opera Festival“
Ingresso/Ticket € 240/28
Arena di Verona h. 21.15
20 giovedìThursday
RIGOLETTO
Musica di Giuseppe Verdi
Regia Antonio Albanese
Direttore Marco Armiliato
“100° Arena Opera Festival“
Ingresso/Ticket € 270/32
Arena di Verona h. 21
21 venerdì Friday
AIDA
Musica di Giuseppe Verdi
Regia Stefano Poda
Direttore Marco Armiliato
“100° Arena Opera Festival“
Ingresso/Ticket € 330/35
Arena di Verona h. 21
22 sabato Saturday
STUDENTI DEL CONSERVATORIO MARCELLO
Musiche di Dvorak, Ravel
“Il Marcello Suona 2023“
Ingresso libero/Free entry
Conservatorio Benedetto Marcello h. 20.45
IL BARBIERE DI SIVIGLIA
Musica di Gioachino Rossini
Regia Hugo de Ana
Direttore Alessandro Bonato
“100° Arena Opera Festival“
Ingresso/Ticket € 270/32
Arena di Verona h. 21
TRIO MICHELANGELI
Paolo Tagliamento violino
Alessandra Doninelli violoncello
Paolo Gagliardi pianoforte
Musiche di Beethoven, Schubert
“Operaestate“
Ingresso/Ticket € 7
Chiostro del Museo Civico-Bassano del Grappa h. 21.20
23 domenica Sunday
JUAN DIEGO FLÒREZ tenore
Musiche del repertorio rossiniano e belcantistico
Marina Monzó soprano
Vasilisa Berzhanskaya
mezzosoprano
Gabriele Sagona basso
Michele Pertusi basso
Direttore Christopher Franklin
Orchestra e Coro della Fondazione
Arena di Verona
“100° Arena Opera Festival“
Ingresso/Ticket € 285/99
Arena di Verona h. 21
27
giovedìThursday
TRAVIATA
Musica di Giuseppe Verdi
Regia Franco Zeffirelli
Direttore Andrea Battistoni
“100° Arena Opera Festival“
Ingresso/Ticket € 270/32
Arena di Verona h. 21
28
29 sabato Saturday
STUDENTI DEL CONSERVATORIO MARCELLO
Musiche di Schubert, Enescu
“Il Marcello Suona 2023“
Ingresso libero/Free entry
Conservatorio Benedetto Marcello h. 20.45
TOSCA
Musica di Giacomo Puccini
Regia Hugo de Ana
Direttore Francesco Ivan Ciampa
“100° Arena Opera Festival“
Ingresso/Ticket € 270/32
Arena di Verona h. 21
30
AIDA
04
venerdì Friday
RIGOLETTO
Musica di Giuseppe Verdi
Regia Antonio Albanese
Direttore Marco Armiliato
“100° Arena Opera Festival“
Ingresso/Ticket € 270/32
Arena di Verona h. 20.45
ORCHESTRA DI PADOVA E DEL VENETO
CORO LIRICO LI.VE.
MARCO ANGIUS direttore
Musiche di Orff
“Operaestate“
Ingresso/Ticket € 22
Teatro Tito Gobbi-Bassano del Grappa h. 21
domenica Sunday
Musica di Giuseppe Verdi
Regia Stefano Poda
Direttore Marco Armiliato
“100° Arena Opera Festival“
Ingresso/Ticket € 330/35
Arena di Verona h. 21
Ago Aug
01 martedìTuesday
I SOLISTI VENETI GIULIANO CARELLA
direttore
Musiche di Albinoni, Galuppi, Bach
“Operaestate“
Ingresso/Ticket € 15
Villa dolfin-Boldù- Rosà h. 21
02
AIDA
mercoledìWednesday
Musica di Giuseppe Verdi
Regia Stefano Poda
Direttore Marco Armiliato
“100° Arena Opera Festival“
Ingresso/Ticket € 330/35
Arena di Verona h. 20.45
03
venerdì Friday
NABUCCO
Musica di Giuseppe Verdi
Regia Gianfranco De Bosio
Direttore Daniel Oren
“100° Arena Opera Festival“
Ingresso/Ticket € 270/32
Arena di Verona h. 21
giovedìThursday
NABUCCO
Musica di Giuseppe Verdi
Regia Gianfranco De Bosio
Direttore Daniel Oren
“100° Arena Opera Festival“
Ingresso/Ticket € 270/32
Arena di Verona h. 20.45
05 sabato Saturday
STUDENTI DEL CONSERVATORIO MARCELLO
Musiche di Farkas, Beethoven
“Il Marcello Suona 2023“
Ingresso libero/Free entry
Conservatorio Benedetto Marcello h. 20.45
TOSCA
Musica di Giacomo Puccini
Regia Hugo de Ana
Direttore Francesco Ivan Ciampa
“100° Arena Opera Festival“
Ingresso/Ticket € 270/32
Arena di Verona h. 20.45
06 domenica Sunday
PLACIDO DOMINGO tenore
Musiche del repertorio classico
Orchestra e Coro della Fondazione
Arena di Verona
“100° Arena Opera Festival“
Ingresso/Ticket € 285/99
Arena di Verona h. 21
LILA violoncello
MARTINA CONSONNI
pianoforte
Musiche del repertorio classico
“Operaestate“
Ingresso/Ticket € 7
Chiostro del Museo Civico-Bassano del Grappa h. 21
10 giovedìThursday
TOSCA
Musica di Giacomo Puccini
Regia Hugo de Ana
Direttore Francesco Ivan Ciampa
“100° Arena Opera Festival“
Ingresso/Ticket € 270/32
Arena di Verona h. 20.45
11 venerdì Friday
CARMEN
Musica di Georges Bizet
Regia Franco Zeffirelli
Direttore Daniel Oren
“100° Arena Opera Festival“
Ingresso/Ticket € 270/32
Arena di Verona h. 20.45
MARIO BRUNELLO violoncello
MARIANGELA GUALTIERI
voce recitante
Musiche di Bach
“Operaestate“
Ingresso/Ticket € 15
Teatro Tito Gobbi-Bassano del Grappa h. 21
12 sabato Saturday
MADAMA BUTTERFLY
Musica di Giacomo Puccini
Regia Franco Zeffirelli
Direttore Daniel Oren
“100° Arena Opera Festival“
Ingresso/Ticket € 330/35
Arena di Verona h. 20.45
17 giovedìThursday
NABUCCO
Musica di Giuseppe Verdi
Regia Gianfranco De Bosio
Direttore Daniel Oren
“100° Arena Opera Festival“
Ingresso/Ticket € 270/32
Arena di Verona h. 20.45
18 venerdì Friday
AIDA
Musica di Giuseppe Verdi
Regia Stefano Poda
Direttore Marco Armiliato
“100° Arena Opera Festival“
Ingresso/Ticket € 330/35
Arena di Verona h. 20.45
19 sabato Saturday
TRAVIATA
Musica di Giuseppe Verdi
Regia Franco Zeffirelli
Direttore Andrea Battistoni
“100° Arena Opera Festival“
Ingresso/Ticket € 270/32
Arena di Verona h. 20.45
20 domenica Sunday
JONAS KAUFMANN tenore
Musiche del repertorio operistico
Orchestra e Coro della Fondazione
Arena di Verona
“100° Arena Opera Festival“
Ingresso/Ticket € 285/99
Arena di Verona h. 21
22 martedìTuesday
FILIPPO GORINI pianoforte
Musiche di Beethoven, Schubert
“Operaestate“
Ingresso/Ticket € 7
Chiostro del Museo Civico-Bassano del Grappa h. 21.20
23 mercoledìWednesday
AIDA
Musica di Giuseppe Verdi
Regia Stefano Poda
Direttore Marco Armiliato
“100° Arena Opera Festival“
Ingresso/Ticket € 330/35
Arena di Verona h. 20.45
24 giovedìThursday
CARMEN
Musica di Georges Bizet
Regia Franco Zeffirelli
Direttore Daniel Oren
“100° Arena Opera Festival“
Ingresso/Ticket € 270/32
Arena di Verona h. 20.45
25 venerdì Friday
CAVALLERIA RUSTICANA
Opera in un unico atto
Musica di Pietro Mascagni
Regia Italo Nunziata
Direttore Donato Renzetti
Orchestra e Coro del Teatro La Fenice
“Stagione Lirica e Balletto 20222023“
Ingresso/Ticket € 240/78
Teatro La Fenice h. 19
MADAMA BUTTERFLY
Musica di Giacomo Puccini
Regia Franco Zeffirelli
Direttore Daniel Oren
“100° Arena Opera Festival“
Ingresso/Ticket € 330/35
Arena di Verona h. 20.45
26
sabato Saturday
QUARTETTO ACCADEMIA
TEATRO ALLA SCALA
Musiche di Mozart, Sostakovich
Ingresso su invito/Admission upon invitation
Collezione Guggenheim h. 18
TRAVIATA
Musica di Giuseppe Verdi
Regia Franco Zeffirelli
Direttore Andrea Battistoni
“100° Arena Opera Festival“
Ingresso/Ticket € 270/32
Arena di Verona h. 20.45
27
domenica Sunday
CAVALLERIA RUSTICANA
Opera in un unico atto
Musica di Pietro Mascagni
Regia Italo Nunziata
Direttore Donato Renzetti
Orchestra e Coro del Teatro La Fenice
“Stagione Lirica e Balletto 20222023“
Ingresso/Ticket € 240/78
Teatro La Fenice h. 17
29
martedìTuesday
CAVALLERIA RUSTICANA
Opera in un unico atto
Musica di Pietro Mascagni
Regia Italo Nunziata
Direttore Donato Renzetti
Orchestra e Coro del Teatro La Fenice
“Stagione Lirica e Balletto 20222023“
Ingresso/Ticket € 240/78
Teatro La Fenice h. 19
31
giovedìThursday
CAVALLERIA RUSTICANA
Opera in un unico atto
Musica di Pietro Mascagni
Regia Italo Nunziata
Direttore Donato Renzetti
Orchestra e Coro del Teatro La Fenice
“Stagione Lirica e Balletto 20222023“
Ingresso/Ticket € 240/78
Teatro La Fenice h. 19
RICCARDO CHAILLY direttore
ORCHESTRA E CORO DEL TEATRO ALLA SCALA
Musiche di Verdi
“100° Arena Opera Festival“
Ingresso/Ticket € 240/28
Arena di Verona h. 21
INDIRIZZI
ARENA DI VERONA
Piazza Bra 1-Verona www.arena.it
CHIOSTRO DEL MUSEO
CIVICO
Piazza Garibaldi 34-Bassano del Grappa www.operaestate.it
COLLEZIONE GUGGENHEIM
Dorsoduro 701 www.guggenheim-venice.it
CONSERVATORIO
BENEDETTO MARCELLO San Marco 2810 www.conservatoriovenezia.eu
PIAZZA SAN MARCO
Venezia www.teatrolafenice.it
TEATRO LA FENICE
Campo San Fantin 1965 www.teatrolafenice.it
TEATRO TITO GOBBI
Piazza Castello-Bassano del Grappa www.operaestate.it
VILLA DOLFIN BOLDÙ
Via Giardini 4-Rosà www.operaestate.it
lunedì Monday
RUMORI NASCOSTI Emanuela Dall’Aglio “Venice Open Stage 2023”
San Sebastiano h. 21.45 04 martedìTuesday
GREEK SUMMER
(is a state of mind) Aristotle University of Thessaloniki, School of Drama, Faculty of Fine Arts – Grecia “Venice Open Stage 2023”
libero/Free entry
SUMMER
a state of mind)
Thursday
PORCI Una gastronomia machista R.E.M.S. (Resources for Expressive Mindfulness Society)
Open Stage 2023”
Piva
Open Stage 2023”
08 sabato Saturday
SENZA TITOLO (MÂCHER SES MOTS) Elena Bastogi “Venice Open Stage 2023”
10
lunedì Monday
CREATURE CHRONICLES
ArtEZ - Master in Theatre Practices (Paesi Bassi)
“Venice Open Stage 2023”
Ingresso libero/Free entry
Campazzo San Sebastiano h. 21.45
11
martedìTuesday
TU ERI TURBOLENTA
tostacarusa
“Venice Open Stage 2023”
Ingresso libero/Free entry
Campazzo San Sebastiano h. 21.45
12 mercoledìWednesday
MEN’S TALK
The Aleksander Zelwerowicz
National Academy of Dramatic Art Warsaw (Polonia)
“Venice Open Stage 2023”
Ingresso libero/Free entry
Campazzo San Sebastiano h. 21.45
13 giovedìThursday
ALONSO
Don Chisciotte tra realtà e virtuale
Scritto e diretto da Sara Meneghetti
Con Andrea Cosentino
Fucina Culturale Machiavelli
Ingresso/Ticket € 28/15
Torre di Porta Nuova, Arsenale h. 19
BOGOTA
Andrea Peña & Artists
“17. Biennale Danza – Altered States”
Tese dei Soppalchi, Arsenale h. 19.30
MEN’S TALK
(vedi mercoledì 12 luglio)
Campazzo San Sebastiano h. 21.45
NAVY BLUE
Oona Doherty
A seguire, talk con l’artista
“17. Biennale Danza – Altered States”
Teatro alle Tese, Arsenale h. 22
14 venerdì Friday
SIMONE FORTI
Inaugurazione della mostra Simone
Forti, dedicata ai 60 anni di carriera del Leone d’Oro della Biennale Danza 2023. La mostra è visitabile tutti i giorni (escluso il lunedì) fino al 29 luglio 2023
“17. Biennale Danza – Altered States”
Sale d’Armi, Arsenale h. 11-20
Lucy Guerin Inc e Matthias
Schack-Arnott
A seguire, talk con l’artista
“17. Biennale Danza – Altered States”
Teatro alle Tese, Arsenale h. 16
NAVY BLUE
(vedi giovedì 13 luglio)
Tatro alle Tese, Arsenale h. 22
ALONSO
(vedi giovedì 13 luglio)
Torre di Porta Nuova, Arsenale h. 19
AJIACO
Performance, Micaela Taylor
Faun, Sidi Larbi Cherkaoui
98 Dias, Javier de Frutos
De Punta a Cabo, Alexis Fernandez
(Maca) & Yaday Ponce
Acosta Danza
Segue talk con l’artista
“17. Biennale Danza – Altered States”
Teatro Piccolo Arsenale h. 20
R.R.
Dimmi che mi ami per i miei occhi soltanto...
Farmacia Zooè
Ingresso libero/Free entry
Campazzo San Sebastiano h. 21.45
15 sabato Saturday
PENDULUM
(vedi venerdì 14 luglio)
Teatro alle Tese, Arsenale h. 14
BOGOTA
(vedi giovedì 13 luglio)
Tese dei Soppalchi, Arsenale h. 16
AJIACO
(vedi venerdì 14 luglio)
Teatro Piccolo Arsenale h. 17
16
domenica Sunday
PENDULUM
(vedi venerdì 14 luglio)
Teatro alle Tese, Arsenale h. 17/19
ALONSO
(vedi giovedì 13 luglio)
Torre di Porta Nuova, Arsenale h. 19
BOGOTA
(vedi giovedì 13 luglio)
Tese dei Soppalchi, Arsenale h. 21
18
BLKDOG
Botis Seva / Far From the Norm
A seguire, talk con l’artista
“17. Biennale Danza – Altered States”
Teatro alle Tese, Arsenale h. 20
19 mercoledìWednesday
PENDULUM
(vedi venerdì 14 luglio)
Teatro alle Tese, Arsenale h. 16
BLKDOG (vedi martedì 18 luglio)
Teatro alle Tese, Arsenale h. 20
ALONSO (vedi giovedì 13 luglio)
Torre di Porta Nuova, Arsenale h. 19
VARIATION(S)
Rachid Ouramdane
A seguire, talk con l’artista
“17. Biennale Danza – Altered States”
Tese dei Soppalchi, Arsenale h. 21
20 giovedìThursday
VARIATION(S)
(vedi mercoledì 19 luglio)
Tese dei Soppalchi, Arsenale h. 18
ALONSO
(vedi giovedì 13 luglio)
Torre di Porta Nuova, Arsenale h. 19
MÁM
Michael Keegan-Dolan
A seguire, talk con l’artista
“17. Biennale Danza – Altered States”
Teatro Malibran h. 20
21 venerdì Friday
VANISHING PLACE
Luna Cenere
Segue talk con l’artista
“17. Biennale Danza – Altered States”
Teatro Piccolo Arsenale h. 18
ALONSO
(vedi giovedì 13 luglio)
Torre di Porta Nuova, Arsenale h. 19
MÁM
(vedi giovedì 20 luglio)
Teatro Malibran h. 20
martedìTuesday
PENDULUM
(vedi venerdì 14 luglio)
Teatro alle Tese, Arsenale h. 18
ALONSO
(vedi giovedì 13 luglio)
Torre di Porta Nuova, Arsenale h. 19
HYBRIS
di Flavia Mastrella, Antonio Rezza “OperaEstate Festival”
Ingresso/Ticket € 15/12
Teatro al Castello “Tito Gobbi”Bassano del Grappa h. 21.20
22 sabato Saturday
VANISHING PLACE
(vedi venerdì 21 luglio)
Teatro Piccolo Arsenale h. 18
ALONSO
(vedi giovedì 13 luglio)
Torre di Porta Nuova, Arsenale h. 19
SPLIT
Lucy Guerin Inc
A seguire, talk con l’artista
“17. Biennale Danza – Altered States”
Teatro del Parco-Mestre h. 21
23 domenica Sunday
A DAY OF FILMS
FEATURING OUR ARTISTS
Giornata di proiezioni di film selezionati o realizzati dagli artisti invitati alla 17. Biennale Danza
“17. Biennale Danza – Altered States”
Teatro Piccolo Arsenale h. 11-22
MOSAIC / TÉNÈBRES
VACILLANTES
Mosaic, Scott Elstermann
Ténèbres Vacillantes, Hai-Wen Hsu
Biennale College Coreografi
“17. Biennale Danza – Altered States”
Ca’ Giustinian h. 15/18
ALONSO
(vedi giovedì 13 luglio)
Torre delle Tese dell’Arsenale h. 19
SPLIT
(vedi sabato 22 luglio)
Teatro del Parco-Mestre h. 20
25
martedìTuesday
MOSAIC / TÉNÈBRES
VACILLANTES
(vedi lunedì 23 luglio)
Ca’ Giustinian h. 17
MATERIA
Andrea Salustri
A seguire, talk con l’artista
“17. Biennale Danza – Altered States”
Tese dei Soppalchi, Arsenale h. 20
LARSEN C
Concept e coreografia di Christos
Papadopoulos
“OperaEstate Festival”
Ingresso/Ticket € 20/16
Teatro Remonidini-Bassano h. 21.20
ZOE
Coreografia Luna Cenere
“BMotion – Danza”
Ingresso/Ticket € 5
Teatro Remondini-Bassano h. 21.30
20 domenica Sunday
SULL’ATTIMO
Progetto di Camilla Monga ed
Emanuele Maniscalco
“BMotion – Danza”
Ingresso/Ticket € 5
CSC San Bonaventura-Bassano h. 15.30/18.30
SIMPLE
Ideazione Ayelen Parolin
“BMotion – Danza”
Ingresso/Ticket € 5
Teatro Remondini-Bassano h. 20.30
OUTDOOR DANCE FLOOR
Ideazione, coreografia e regia
Salvo Lombardo
“BMotion – Danza”
Ingresso/Ticket € 5
Piazza Libertà-Bassano h. 22
23 mercoledìWednesday
ODRADEK
Menoventi
“BMotion – Teatro”
Ingresso/Ticket € 5
CSC San Bonaventura-Bassano h. 19
ENRICO IV
Regia Giorgia Cerruti
Piccola Compagnia della Magnolia
“BMotion – Teatro”
Ingresso/Ticket € 5
Teatro Remondini-Bassano h. 21.30
24 giovedìThursday
BETWEEN ME AND P. di e con Filippo Michelangelo Ceredi
“BMotion – Teatro”
Ingresso/Ticket € 5
CSC San Bonaventura-Bassano h. 19
NELL’UOMO DEVE ESSERE
TUTTO BELLO
Lettura di estratti dei romanzi pubblicati da Marsilio Editori a cura di Leda Kreider, alla presenza dell’autrice Sasha Marianna
Salzmann
“BMotion – Teatro”
Ingresso/Ticket € 5
Palazzo Sturm-Bassano h. 17.30
UNA PICCOLA OPERA
LIRICA di Leonardo Manzan
“BMotion – Teatro”
Ingresso/Ticket € 5
Teatro Remondini-Bassano h. 21.30
25 venerdì Friday
GLI ARISTOCRATICI di Sasha Marianna Salzmann
traduzione inedita di Monica Marotta
Con Federica Rossellini
“BMotion – Teatro”
Ingresso/Ticket € 5
Palazzo Sturm-Bassano h. 17.30
LA VAGA GRAZIA di Eva Geatti
“BMotion – Teatro”
Ingresso/Ticket € 5
CSC San Bonaventura-Bassano h. 19
LOVE ME di Antonio Tarantino
Regia e interpretazione Licia
Lanera
“BMotion – Teatro”
Ingresso/Ticket € 5
Teatro Remondini-Bassano h. 21.30
26
sabato Saturday
I BARBARI di Nino Haratischwili
Lettura a cura di Matilde Vigna
“BMotion – Teatro”
Ingresso/Ticket € 5
Palazzo Sturm-Bassano h. 17.30
THE CHANCE TO FIND YOURSELF di e con Jovial Mbenga & Benno Steinegger
“BMotion – Teatro”
Ingresso/Ticket € 5
Teatro Remondini-Bassano h. 21.30
27 domenica Sunday
L’AUTUNNO DEI SUCCUBI di Nino Haratischwili
traduzione inedita di Anna Benussi e Angelo Callipo
Con Leda Kreide, Federica Rossellini, Matilde Vigna
“BMotion – Teatro”
Ingresso/Ticket € 5
Palazzo Sturm-Bassano h. 17.30
UNDER THE INFLUENCE
Regia e drammaturgia
Gianmaria Borzillo
“BMotion – Teatro”
Ingresso/Ticket € 5
CSC San Bonaventura-Bassano h. 19
EL PACTO DEL OLVIDO di e con Sergi Casero
“BMotion – Teatro”
Ingresso/Ticket € 5
Teatro Remondini-Bassano h. 21.30
INDIRIZZI
CAMPAZZO SAN SEBASTIANO Dorsoduro www.veniceopenstage.org
CHIESA DI SAN GIOVANNI
Piazza Libertà 27 Bassano del Grappa www.operaestate.it
CSC SAN BONAVENTURA
Via dell’Ospedale 2-6 Bassano del Grappa www.operaestate.it
TEATRO AL CASTELLO “TITO GOBBI”
Piazza Castello Ezzelini
Bassano del Grappa www.operaestate.it
TEATRO MALIBRAN
Cannaregio 5873 www.labiennale.org
TEATRO DEL PARCO
Parco Albanese Via Bissuola-Mestre www.labiennale.org
TEATRO PICCOLO ARSENALE
Campo della Tana, Castello www.labiennale.org
TEATRO REMONDINI
Via Santissima Trinità 8/C Bassano del Grappa www.operaestate.it
TORRE DI PORTA NUOVA
Arsenale, Castello www.teatrostabileveneto.it
NATIONAL PARTICIPATIONS
AUSTRALIA
AUSTRIA
BELGIO
BRASILE
CANADA
Repubblica di COREA
DANIMARCA
EGITTO
FINLANDIA
(Padiglione Alvar Aalto)
FRANCIA
GERMANIA
GIAPPONE
GRAN BRETAGNA
GRECIA
ISRAELE
PAESI BASSI
PAESI NORDICI
(Finlandia, Norvegia, Svezia)
POLONIA
ROMANIA/1
SERBIA
SPAGNA
STATI UNITI D’AMERICA
SVIZZERA
UNGHERIA
URUGUAY
Repubblica Bolivariana del VENEZUELA
PADIGLIONE VENEZIA
NATIONAL PARTICIPATIONS
ALBANIA
Artiglierie
ARABIA SAUDITA
Sale d'Armi
ARGENTINA
Sale d'Armi
Regno del BAHRAIN
Artiglierie
REPUBBLICA CECA
Artiglierie
CILE
Artiglierie
CINA
Repubblica Popolare
Cinese
Magazzino delle Vergini
CROAZIA
Artiglierie
EMIRATI ARABI UNITI
Sale d'Armi
FILIPPINE
Artiglierie
Granducato di LUSSEMBURGO
Sale d'Armi
IRLANDA
Artiglierie
Repubblica del KOSOVO
Artiglierie
LETTONIA
Artiglierie
MESSICO
Sale d'Armi
PERÙ Sale d'Armi
SINGAPORE Sale d'Armi
Repubblica di SLOVENIA
Artiglierie
Repubblica del SUDAFRICA
Sale d'Armi
TURCHIA Sale d'Armi
UCRAINA Sale d'Armi
Repubblica
dell’UZBEKISTAN
Tese Cinquecentesche
PADIGLIONE ITALIA
Tese e Giardino delle Vergini
NATIONAL PARTICIPATIONS
BULGARIA
Sala del Tiziano, Centro Culturale Don Orione Artigianelli
Dorsoduro 909/A
Repubblica di CIPRO
Associazione Culturale Spiazzi Castello 3865
ESTONIA
Salizada Streta, Castello 96
GEORGIA
Giardino Bianco Art Space
Via G. Garibaldi, Castello 1814
GRENADA
Associazione Vela al Terzo Venezia
Fondamenta C. Giazzo, Castello 209
KUWAIT
Magazzino del Sale 5
Dorsoduro 262
LITUANIA
Campo della Tana, Castello 2125 (in front of the Arsenale entrance)
Repubblica della MACEDONIA DEL NORD
Scuola dei Laneri, Salizada San Pantalon, Santa Croce 131/A
MONTENEGRO
Palazzo Malipiero, Ramo Malipiero San Marco 3078-3079/A
NIGER
Isola di San Servolo
Repubblica di PANAMA
Tana Art Space Castello 2109/A e 2110-2111
PORTOGALLO
Palazzo Franchetti, San Marco 2842
ROMANIA/2
Giardini and New Gallery, Istituto Romeno di Cultura e Ricerca Umanistica, Palazzo Correr Campo Santa Fosca Cannaregio 2214
SANTA SEDE
Abbazia di San Giorgio Isola di San Giorgio Maggiore
Repubblica di SAN MARINO
Fucina del Futuro
Calle San Lorenzo, Castello 5063B
COLLATERAL EVENTS
DOCKS CANTIERI CUCCHINI A Fragile Correspondence. Scotland + Venice San Pietro di Castello 40
DOCKS CANTIERI CUCCHINI Catalonia in Venice. Following the Fish
San Pietro di Castello 40A
IUAV Climate
Wunderkammer
Palazzo Badoer, Calle de la Laca San Polo 2468
PALAZZO DELLE PRIGIONI Diachronic Apparatuses of Taiwan. Architecture as On-going Details
Within Landscape Castello 4209 (next to Palazzo Ducale)
PALAZZO MORA EUmies Awards. Young Talent 2023. The Laboratory of Education
Cannaregio 3659
IUAV Radical yet Possible Future Space Solutions
25 maggio May (Ca’ Tron)
26 maggio May (Aula Magna, Tolentini) Ca’ Tron, Santa Croce 1957 Tolentini, Santa Croce 19
PALAZZO ZENOBIO
DEGLI ARMENI Students as Researchers. Creative Practice and University Education
Centro Studi e Documentazione della Cultura Armena, Dorsoduro 1602
CAMPO DELLA TANA
Transformative Hong Kong Castello 2126 (in front of the Arsenale entrance)
CA’ ASI
Tracé Bleu. Que faire en ce lieu, à moins que l’on y songe?
Campiello Santa Maria Nova Cannaregio 6024
www.labiennale.org
ACP | PALAZZO FRANCHETTI/1
Building a Creative Nation
ELEMENTAL, Herzog & de Meuron, OMA, Philippe Starck, UNStudio
Fino Until 26 novembre November
Campo Santo Stefano, San Marco 2842 www.acp-palazzofranchetti.com
ACP | PALAZZO FRANCHETTI/2
KENGO KUMA
Onomatopeia Architecture
Fino Until 26 novembre November
Campo Santo Stefano, San Marco 2842 www.acp-palazzofranchetti.com
AEROPORTO MARCO POLO
BAGLIONI HOTEL LUNA
Frank&Frank
flying city leather maps
Grand Tour
Fino Until 26 novembre November
Aeroporto Zona Arrivi (ground floor); Baglioni Hotel Luna, San Marco 1243 www.frank-frank.com
AKKA PROJECT
ALLAN KIOKO
Mangbetu People
Fino Until 25 agosto August
Ca’ del Duca, Corte del Duca Sforza San Marco 3052 www.akkaproject.com
BERENGO STUDIO
SAM BARON
Sacrum Unguentum
Fino Until 1 ottobre October
Ex Farmacia, San Marco 412 www.berengo.com
CA’ PESARO/1
La donazione
Gemma De Angelis Testa
Fino Until 17 settembre September
Galleria Internazionale d’Arte Moderna (second floor), Santa Croce 2076 capesaro.visitmuve.it
CA’ PESARO/2
AFRICA 1:1
Cinque artisti africani a Ca’ Pesaro
Fino Until 1 ottobre October
Galleria Internazionale d’Arte Moderna (ground floor and Project Room) Santa Croce 2076 capesaro.visitmuve.it
COLLEZIONE PEGGY GUGGENHEIM
EDMONDO BACCI
L’energia della luce
Fino Until 18 settembre September
Palazzo Venier dei Leoni, Dorsoduro 701 www.guggenheim-venice.it
COMPLESSO DELL’OSPEDALETTO
Venezia Fabrica Futura
Fino Until 17 luglio July 30 agosto August-30 settembre September
Barbaria de le Tole, Castello 6691 www.fabrica.it
EUROPEAN CULTURAL CENTRE (ECC)
PALAZZO BEMBO, PALAZZO MORA, GIARDINI DELLA MARINARESSA
Time Space Existence
Fino Until 26 novembre November
Palazzo Bembo, Riva del Carbon San Marco 4793
Palazzo Mora, Strada Nuova
Cannaregio 3659
Giardini della Marinaressa
Riva dei Sette Martiri, Castello www.ecc-italy.eu www. timespaceexistence.com
FONDACO DEI TEDESCHI
RADIALS
Fino Until 10 novembre November
Calle del Fontego dei Tedeschi, Rialto www.sbagliato.net
FONDATION VALMONT
EGO
Fino Until 25 febbraio February, 2024
Palazzo Bonvicini, Calle Agnello Santa Croce 2161/A www.fondationvalmont.com
FONDATION WILMOTTE
Prix W 2023
Un toît pour tous
Fino Until 27 novembre November
Fondaco degli Angeli, Fondamenta dell’Abbazia, Cannaregio 3560 www.fondationwilmotte.com www.prixw.com
FONDAZIONE GIORGIO CINI
LUCIANO BALDESSARI
Architetture per la scena
Fino Until 26 novembre November
Biblioteca Nuova Manica Lunga Isola di San Giorgio Maggiore www.cini.it
FONDAZIONE DELL’ALBERO
D’ORO
Nicolò Manucci, il Marco Polo dell’India
Un veneziano alla corte Moghul nel XVII secolo
Fino Until 26 novembre November
Palazzo Vendramin Grimani, San Polo 2033 www.fondazionealberodoro.org
FONDAZIONE PRADA
Everybody Talks About the Weather
Fino Until 26 novembre November
Ca’ Corner della Regina, Santa Croce 2215 www.fondazioneprada.org
FONDAZIONE QUERINI
STAMPALIA
DoorScape. Lo spazio oltre
la soglia
Fino Until 26 novembre November
Area Carlo Scarpa, Campo Santa Maria Formosa, Castello 5252 www.doorscape.eu www.querinistampalia.org
IKONA GALLERY
Mercanti e stracciaioli nel
Ghetto di Venezia
Fino Until 30 agosto August
Campo del Ghetto Nuovo Cannaregio 2909 www.ikonavenezia.com
IN’EI GALLERY
ART STUDIO h220430
The Floating Realm
Fino Until 20 agosto August
Riva del Vin, San Polo 1100 www.in-ei.it
LE STANZE DEL VETRO
Vetro boemo: i grandi maestri
Fino Until 26 novembre November
Isola di San Giorgio Maggiore www.lestanzedelvetro.org www.cini.it
LE STANZE DELLA FOTOGRAFIA
UGO MULAS
L’operazione fotografica
Fino Ultil 6 agosto August
Isola di San Giorgio Maggiore www.lestanzedellafotografia.it
M9 – MUSEO del ‘900
Rivoluzione Vedova
Fino Until 26 novembre November
Via Giovanni Pascoli 11, Mestre www.m9museum.it www.fondazionevedova.org
MUSEO CORRER
L’arte della Giustizia.
La Giustizia nell’arte
Fino Until 3 settembre September
Piazza San Marco 52 correr.visitmuve.it
MUSEO DEL VETRO
Cento anni di NasonMoretti
Storia di una famiglia del vetro muranese
Fino Until 6 gennaio January, 2024
Fondamenta Marco Giustinian 8 Murano www.museovetro.visitmuve.it
NEGOZIO OLIVETTI
Massimo Micheluzzi al Negozio Olivetti
Fino Until 24 settembre September
FAI – Fondo per l’Ambiente Italiano Piazza San Marco 101 www.fondoambiente.it
OCEAN SPACE SIMONE FATTAL
PETRIT HALILAJ & ÁLVARO URBANO
Thus Waves Come in Pairs
Fino Until 5 novembre November Ex Chiesa di San Lorenzo Castello 5069 www.ocean-space.org
PALAZZO CONTARINI POLIGNAC 100 progetti x 100 identità
Fino Until 26 novembre November Magazzino Gallery, Dorsoduro 874 www.venicedesignweek.com
PALAZZO GRASSI CHRONORAMA
Tesori fotografici del 20° secolo
Fino Until 7 gennaio Junuary, 2024 Campo San Samuele San Marco 3231 www.pinaultcollection.com
PROCURATIE VECCHIE/1
THE HUMAN SAFETY NET A World of Potential Piazza San Marco 105 www.thehumansafetynet.org
PROCURATIE VECCHIE/2
THE ART STUDIO
The Hungriest Eye.
The Blossoming of Potential by Arthur Duff
Fino Until 10 marzo March, 2024 Piazza San Marco 105 www.thehumansafetynet.org
PUNTA DELLA DOGANA ICÔNES
Fino Until 26 novembre November Dorsoduro 2 www.pinaultcollection.com
SALONE VERDE
UMBAU. Nonstop Transformation by gmp · von Gerkan, Marg and Partners Architects
Fino Until 26 novembre November Calle della Regina, Santa Croce 2258 umbau.gmp.de
SCALA DEL BOVOLO LUIGI MANCIOCCO
Dal lato dell’immaginario
Fino Until 10 settembre September
Palazzo Contarini del Bovolo San Marco 4303 www.luigimanciocco.it www.gioiellinascostidivenezia.it
VATICAN CHAPELS
Sacred Landscapes
Fino Until 26 novembre November
Fondazione Giorgio Cini Bosco dell’Isola di San Giorgio Maggiore www.cini.it
Mensile di cultura, spettacolo e tempo libero Numero 277-278 - Anno XXVII
Venezia, 1 luglio 2023
Con il Patrocinio del Comune di Venezia
Autorizzazione del Tribunale di Venezia n. 1245 del 4/12/1996
Direzione editoriale
Massimo Bran
Direzione organizzativa
Paola Marchetti
Relazioni esterne e coordinamento editoriale
Mariachiara Marzari
Redazione
Chiara Sciascia, Davide Carbone
Speciali
Fabio Marzari
Coordinamento Newsletter e progetti digitali
Marisa Santin
Grafica
Luca Zanatta
Hanno collaborato a questo numero
Katia Amoroso, Maria Laura Bidorini, Loris Casadei, Michele Cerruti But, Elisabetta Gardin, Renato Jona, Michela Luce, Franca Lugato, Andrea Oddone Martin, Livia Sartori di Borgoricco, Lucrezia Sillo, Fabio Di Spirito, Camillo Tonini
Si ringraziano
Gloria Levoni, Andrea Peña, Tao Ye, Rachele De Stefano, Alessandro Zoppi, Michele Mele, Giuseppe Mormile, Valentina Piovan e Stefania Randazzo, Silvia Ballestra, Marta Cai, Tommaso Pincio, Benedetta Tobagi, Filippo Tuena, Marina Trivellato, Emanuela Caldirola
Traduzioni
Andrea Falco
Foto di copertina
MÁM, Michael Keegan-Dolan © Matt Grace, 17. Biennale Danza - Courtesy La Biennale di Venezia
lo trovi qui:
Bookshop Gallerie dell’Accademia; Qshop (c/o Querini Stampalia, Santa Maria Formosa); Alef (c/o Museo Ebraico, zona Ghetto); Mare di Carta (Fondamenta dei Tolentini); Studium (zona S. Marco); Toletta, Toletta Cube e Toletta Studio (zona Campo San Barnaba) e in tutte le edicole della città.
Direttore responsabile
Massimo Bran
Guida spirituale
“Il più grande”, Muhammad Alì
Recapito redazionale
Cannaregio 563/E - 30121Venezia tel. +39 041.2377739 redazione@venezianews.it www.venezianews.it

venezianews.magazine
venezia_news venews_magazine
Stampa
Chinchio Industria Grafica Srl
Via Pacinotti, 10/12 - 35030 Rubano (PD) - www.chinchio.it
Redazione Venezianews
La redazione non è responsabile di eventuali variazioni delle programmazioni annunciate
RENDIAMO

A MISURA DI PERSONA. IN TUTTA ITALIA.
Da oltre 30 anni siamo a fianco di enti e istituzioni. Scopri il nostro impegno su corporate.coopculture.it
Working alongside cultural organizations and institutions in Italy for over thirty years, creating places of culture on a human scale.









Discover our commitment on corporate.coopculture.it impresa culturale e cooperativa | cultural and cooperative enterprise

 Venezia | Torino| Firenze | Roma | Napoli | Palermo
Venezia | Torino| Firenze | Roma | Napoli | Palermo